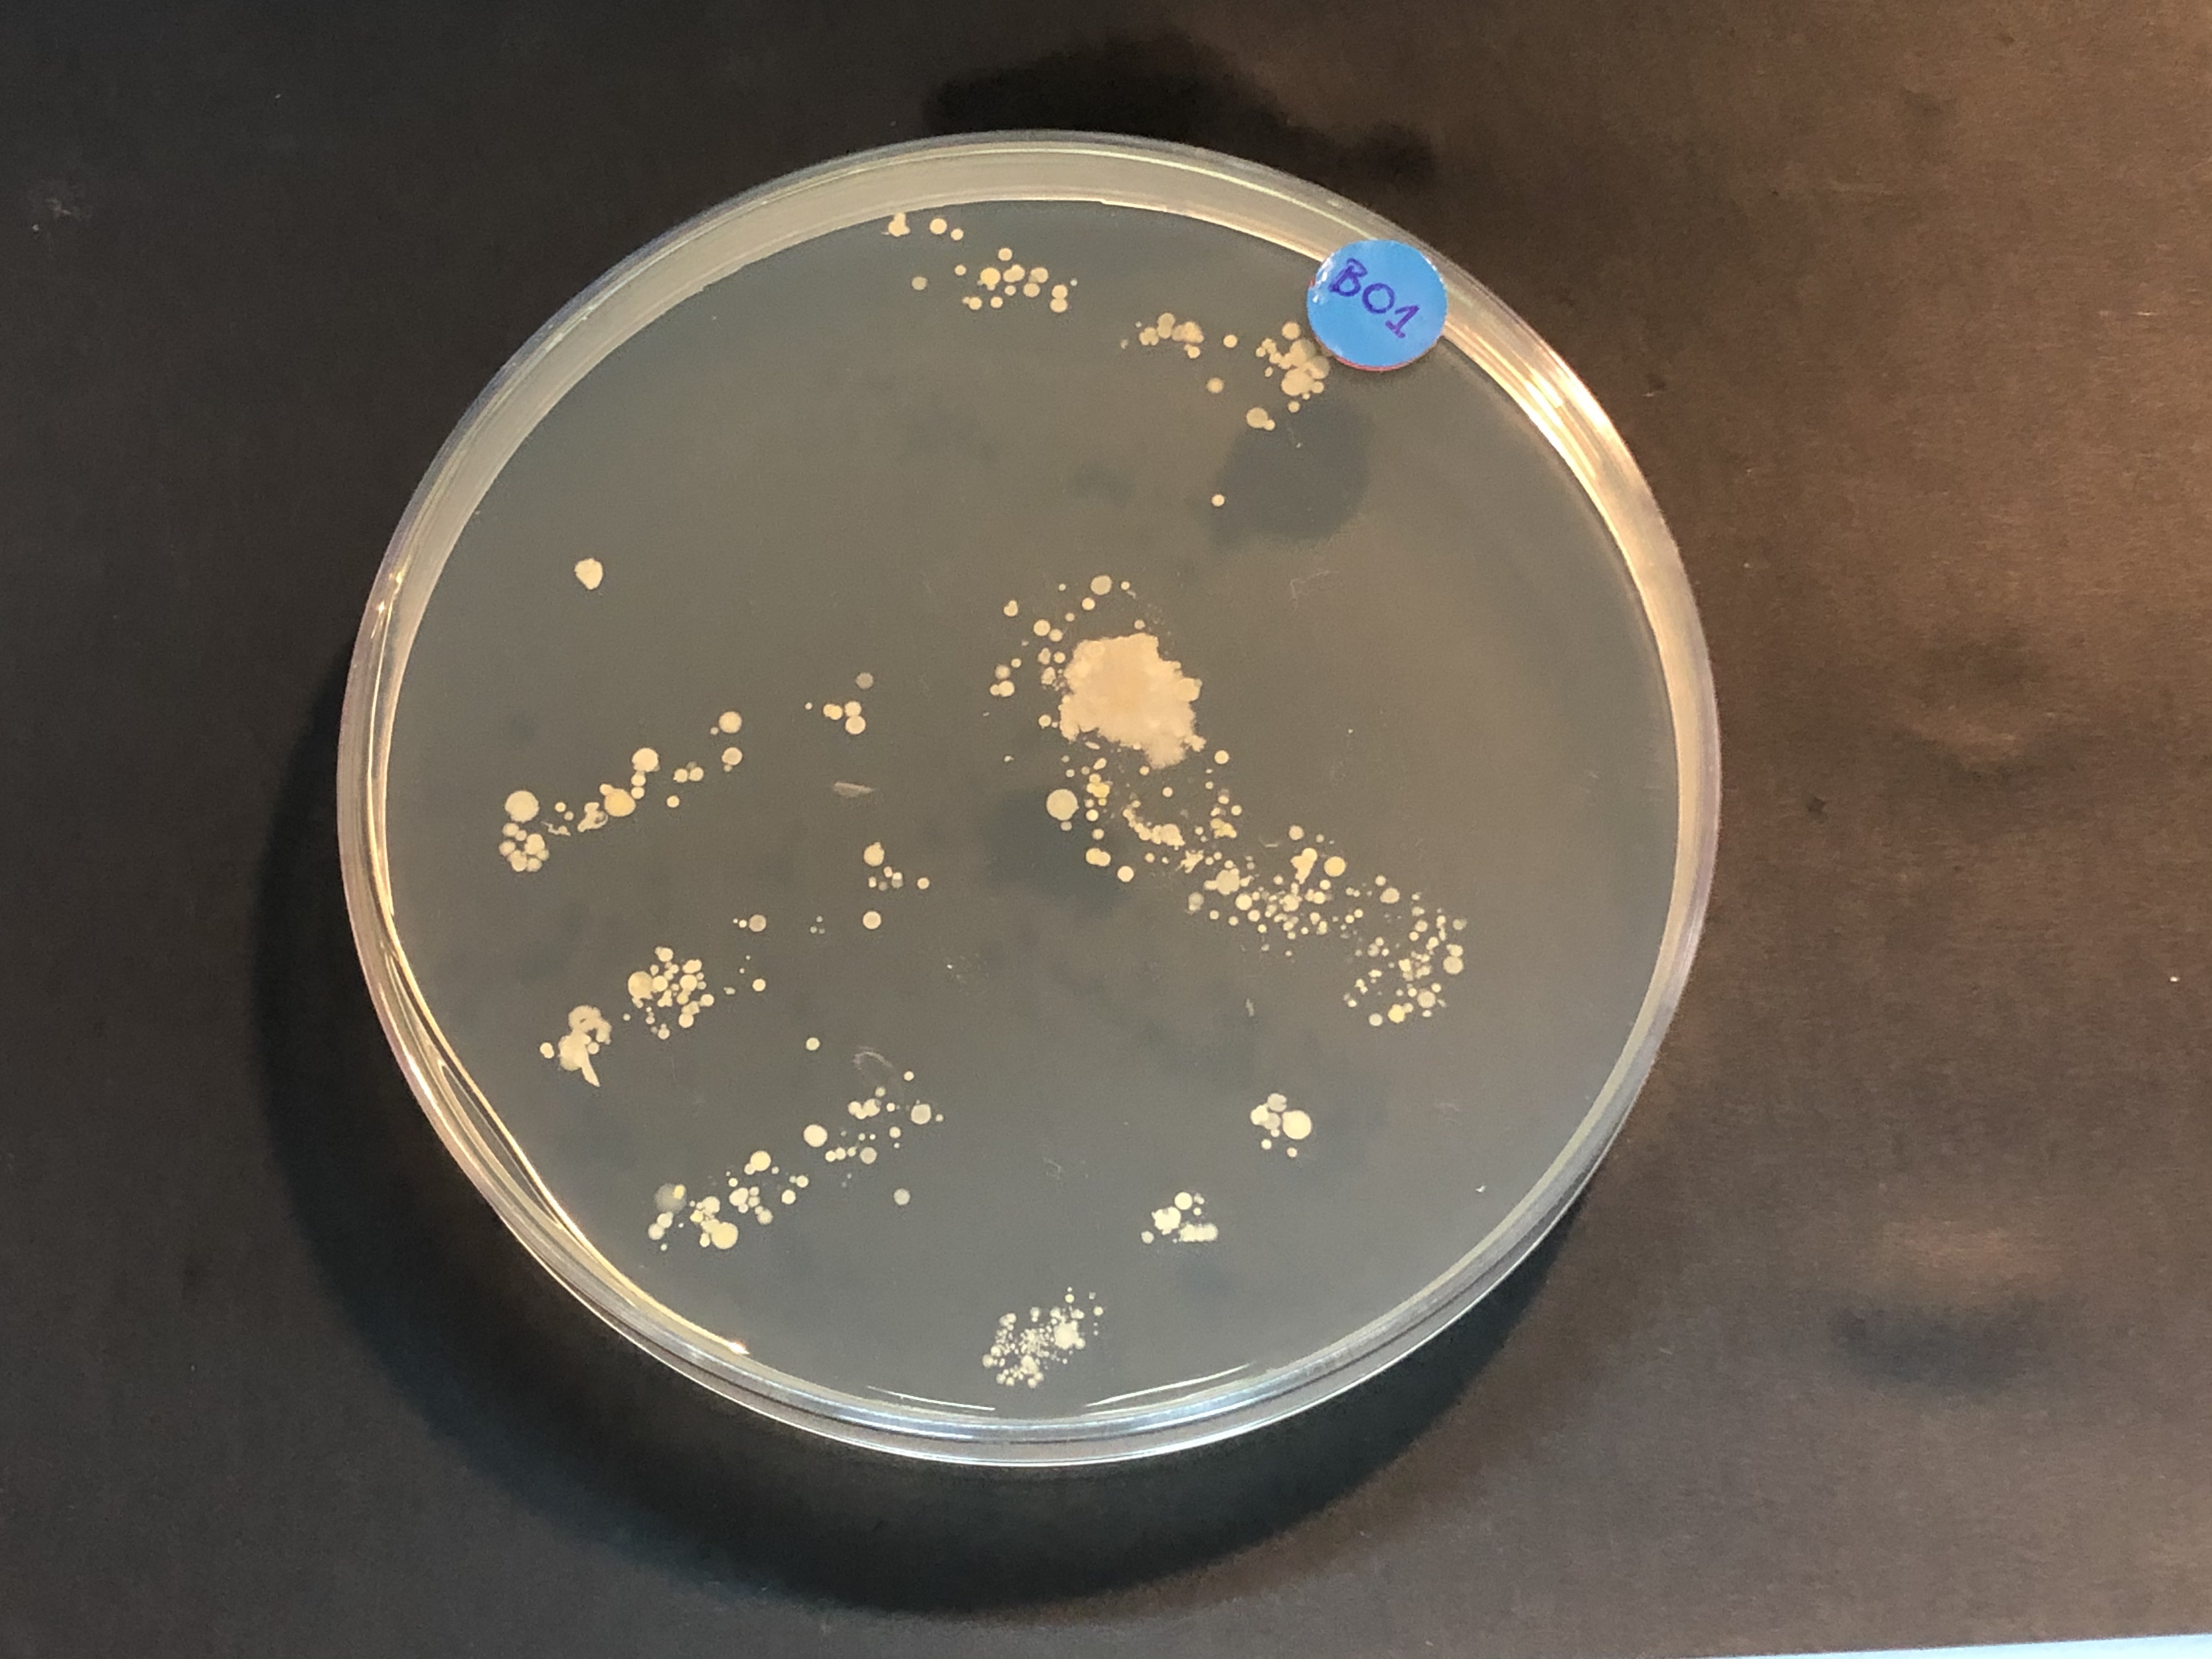
Unijunior_B01
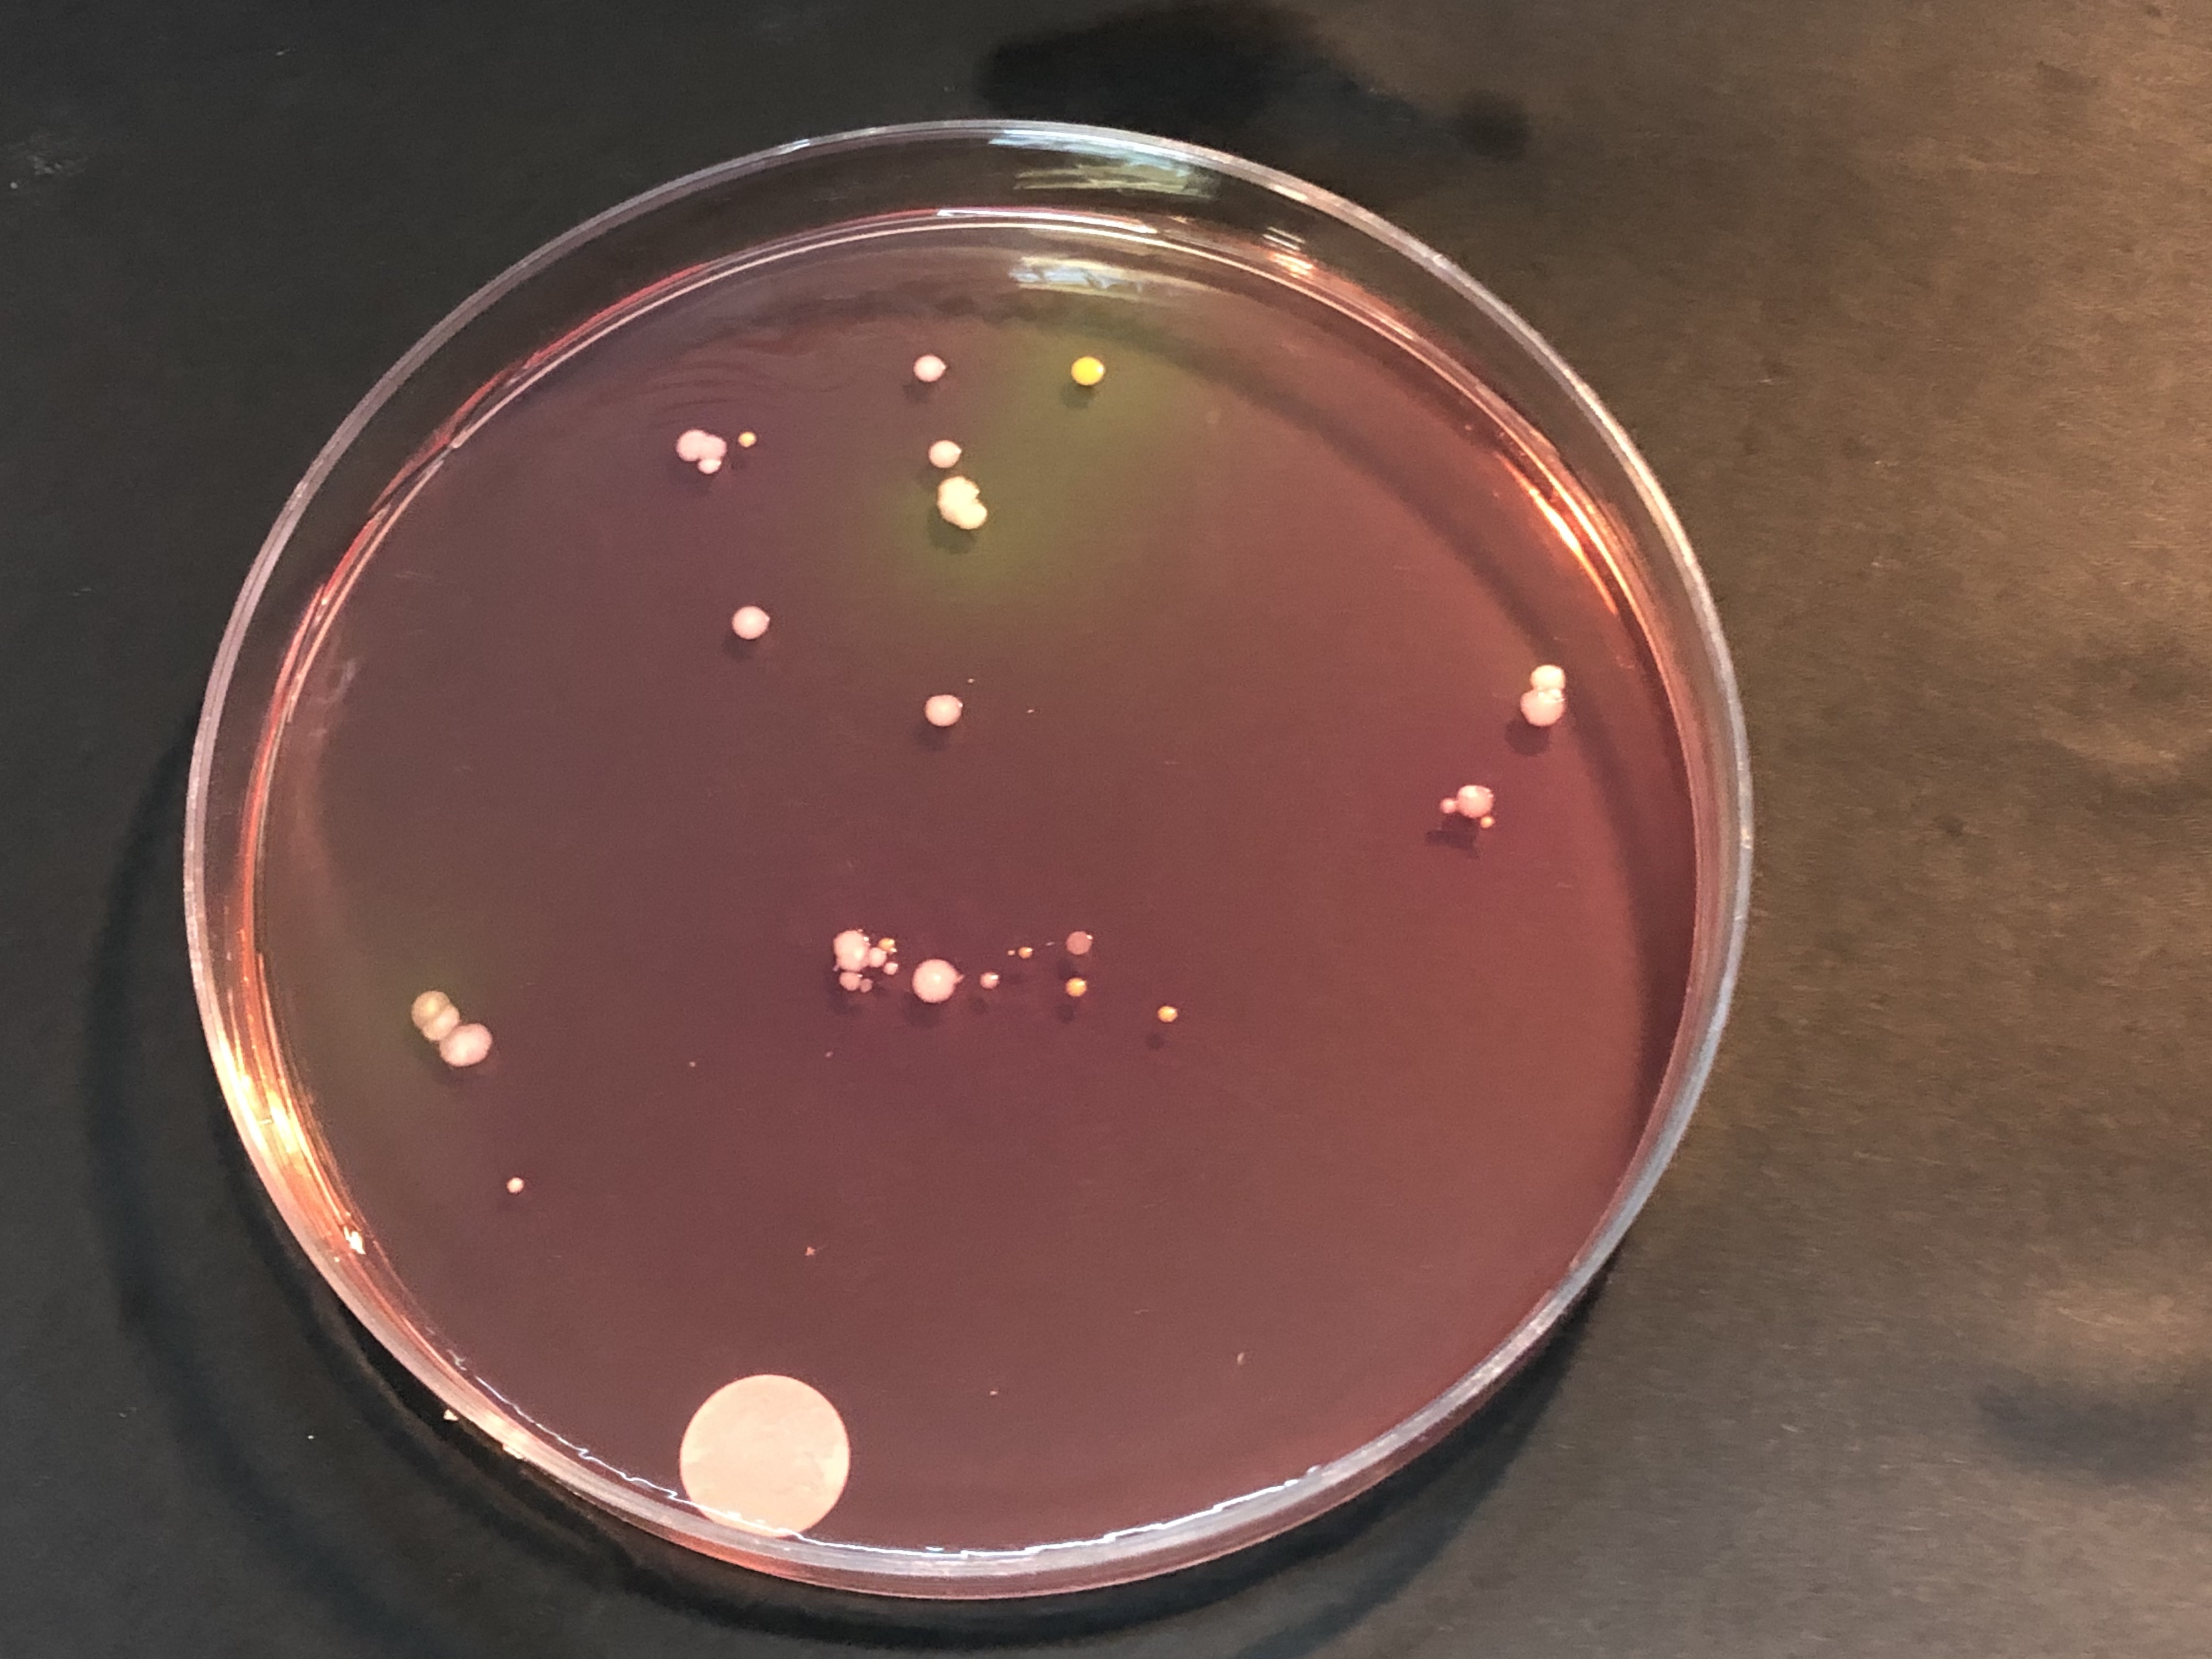
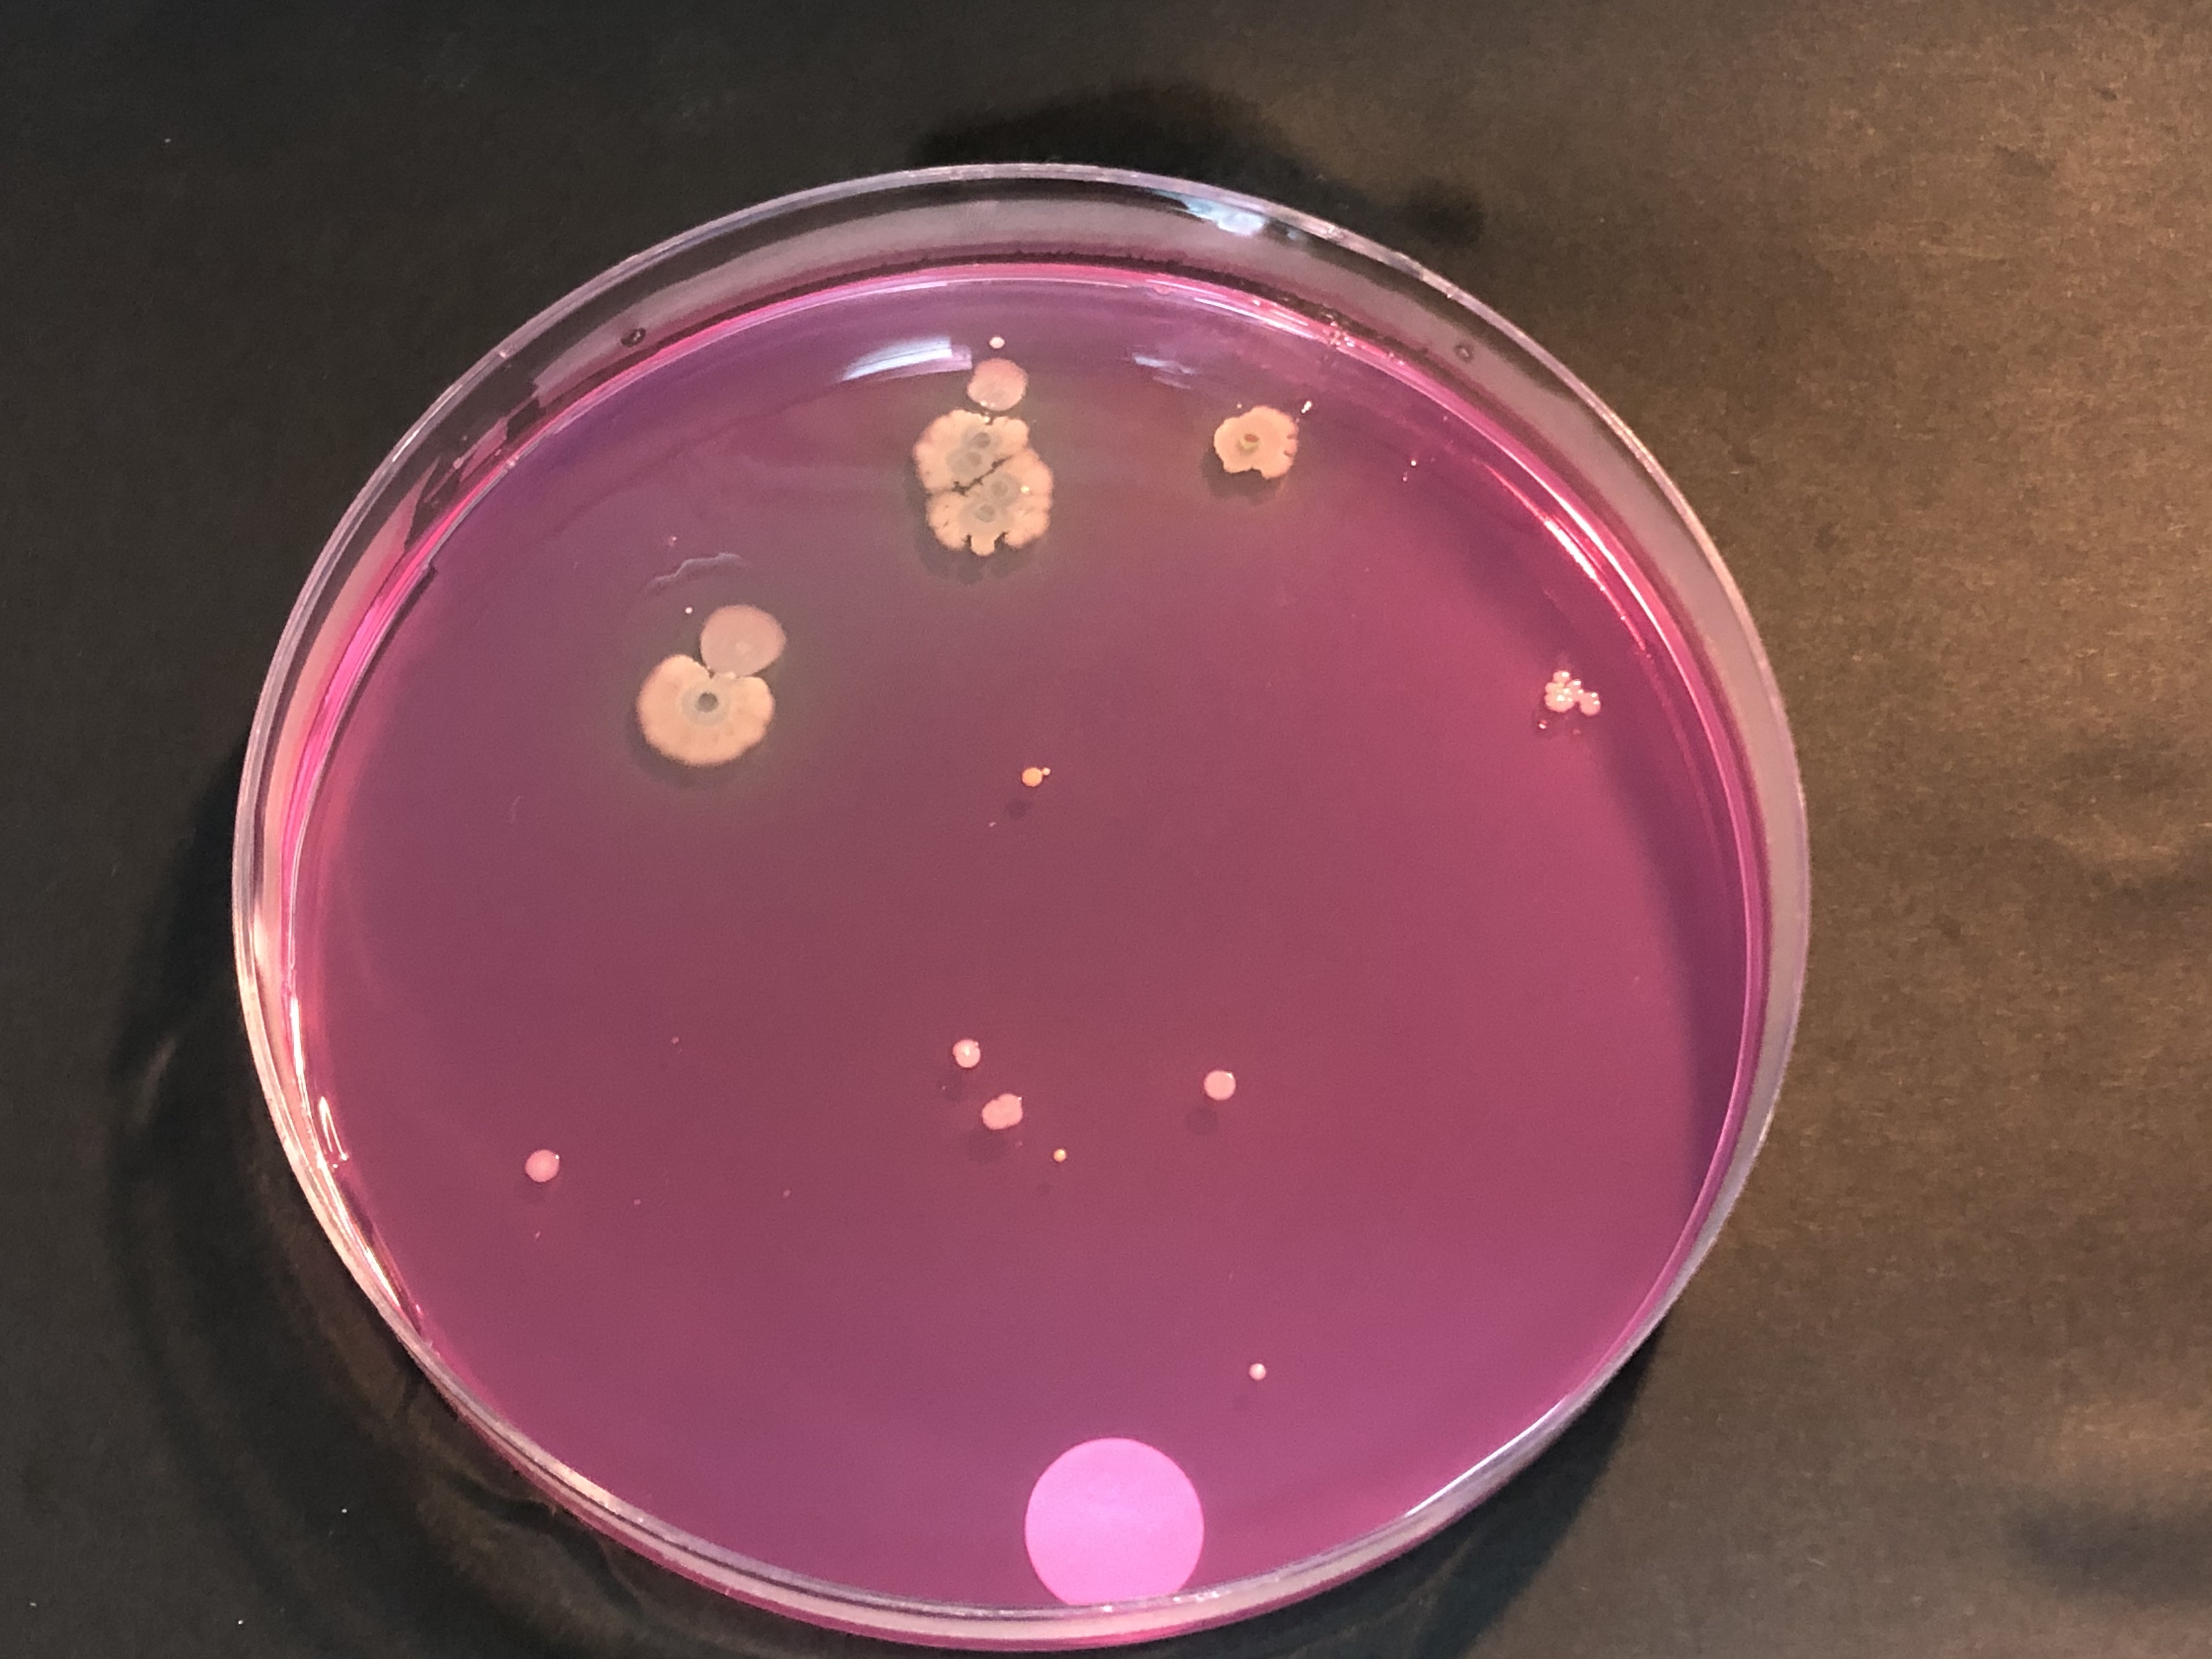
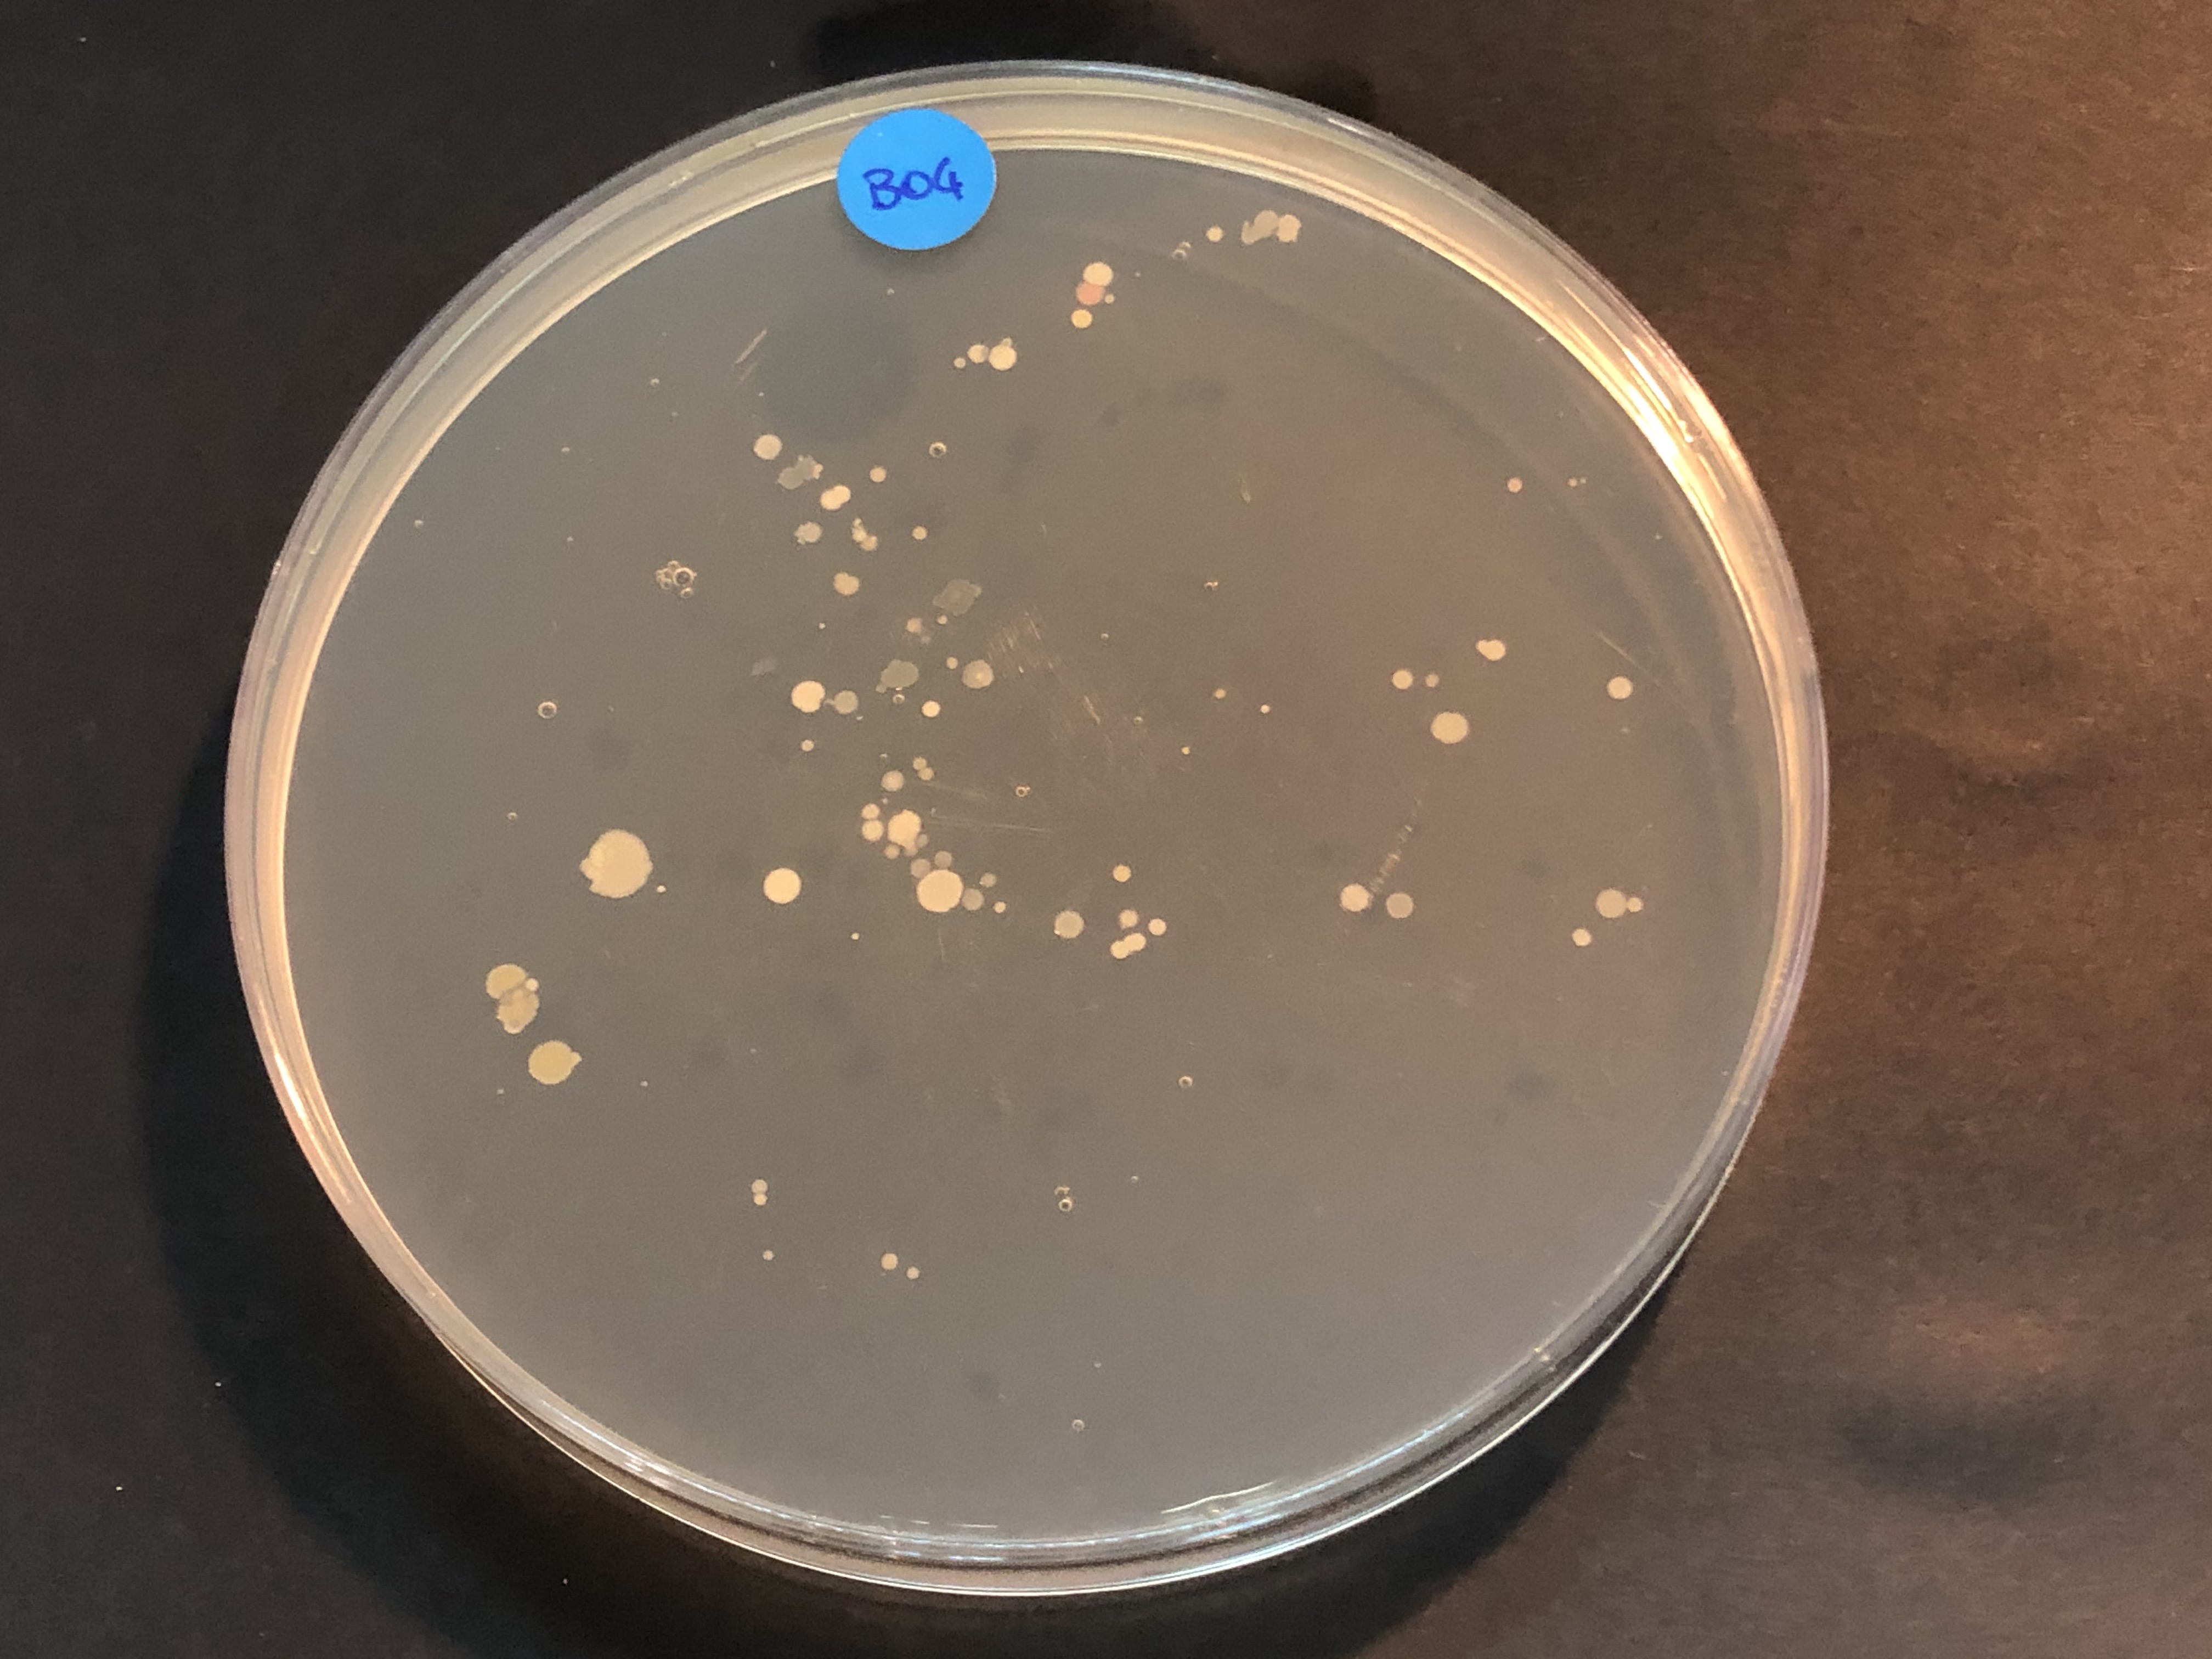
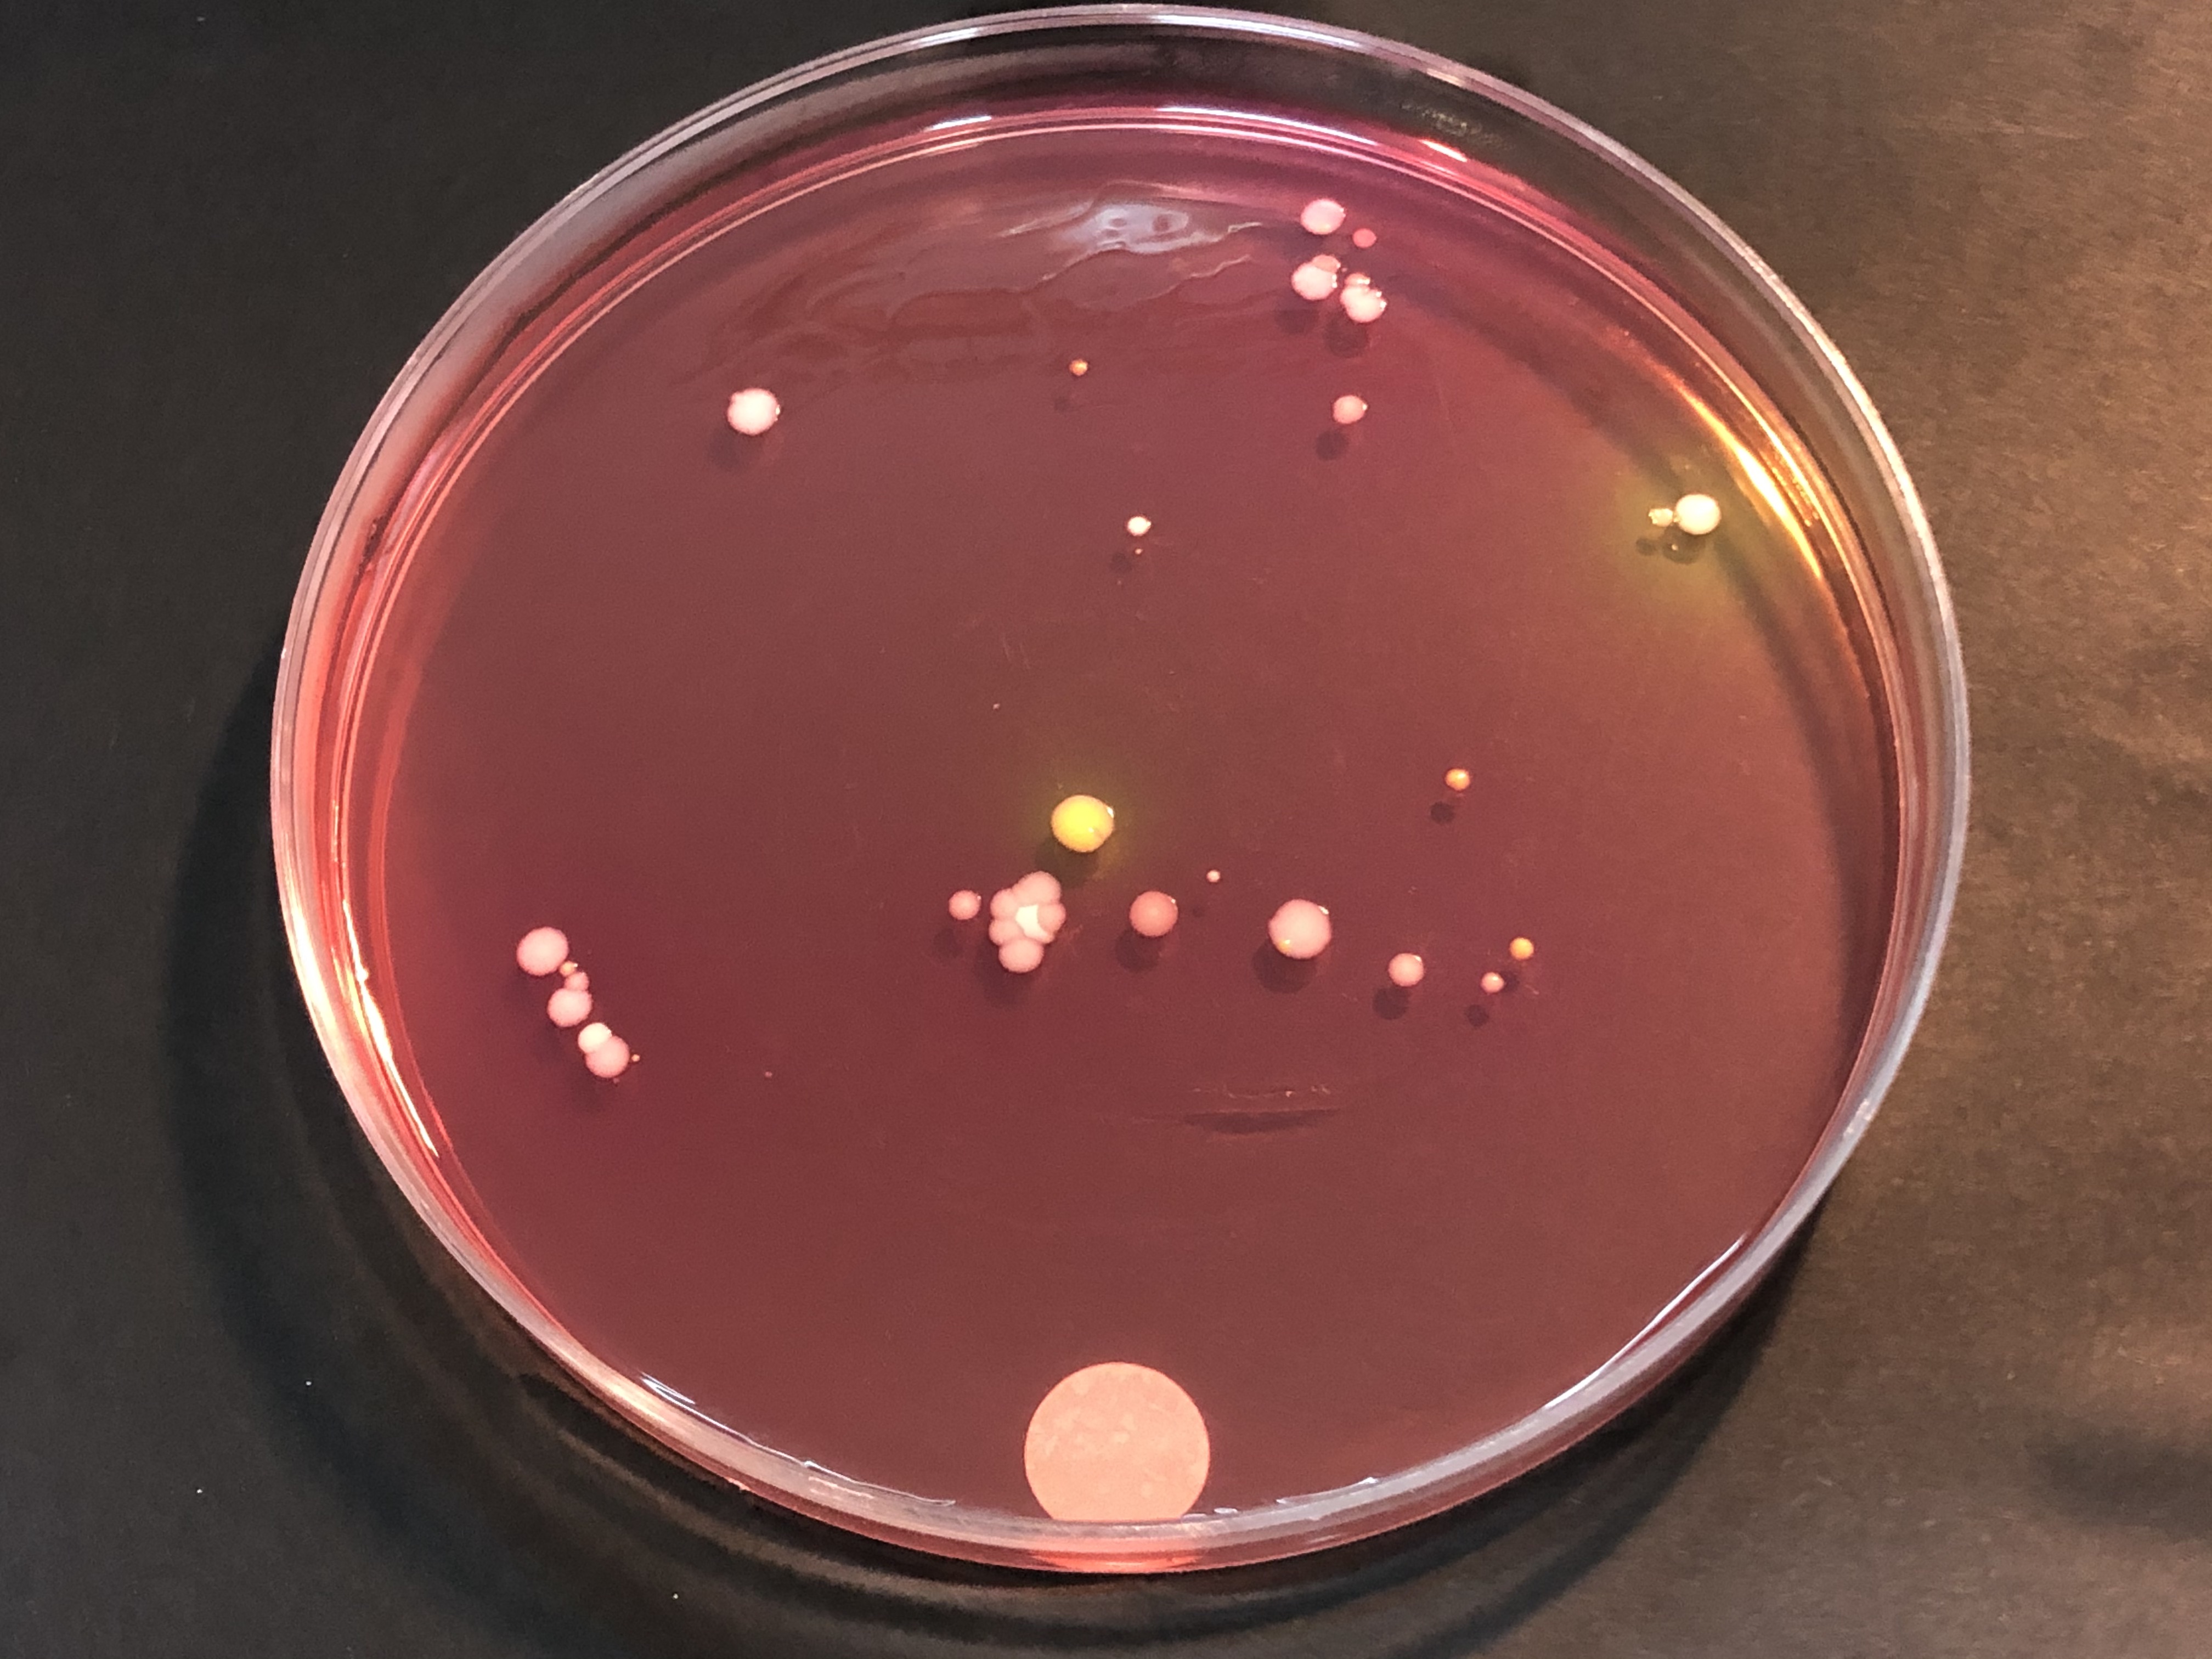
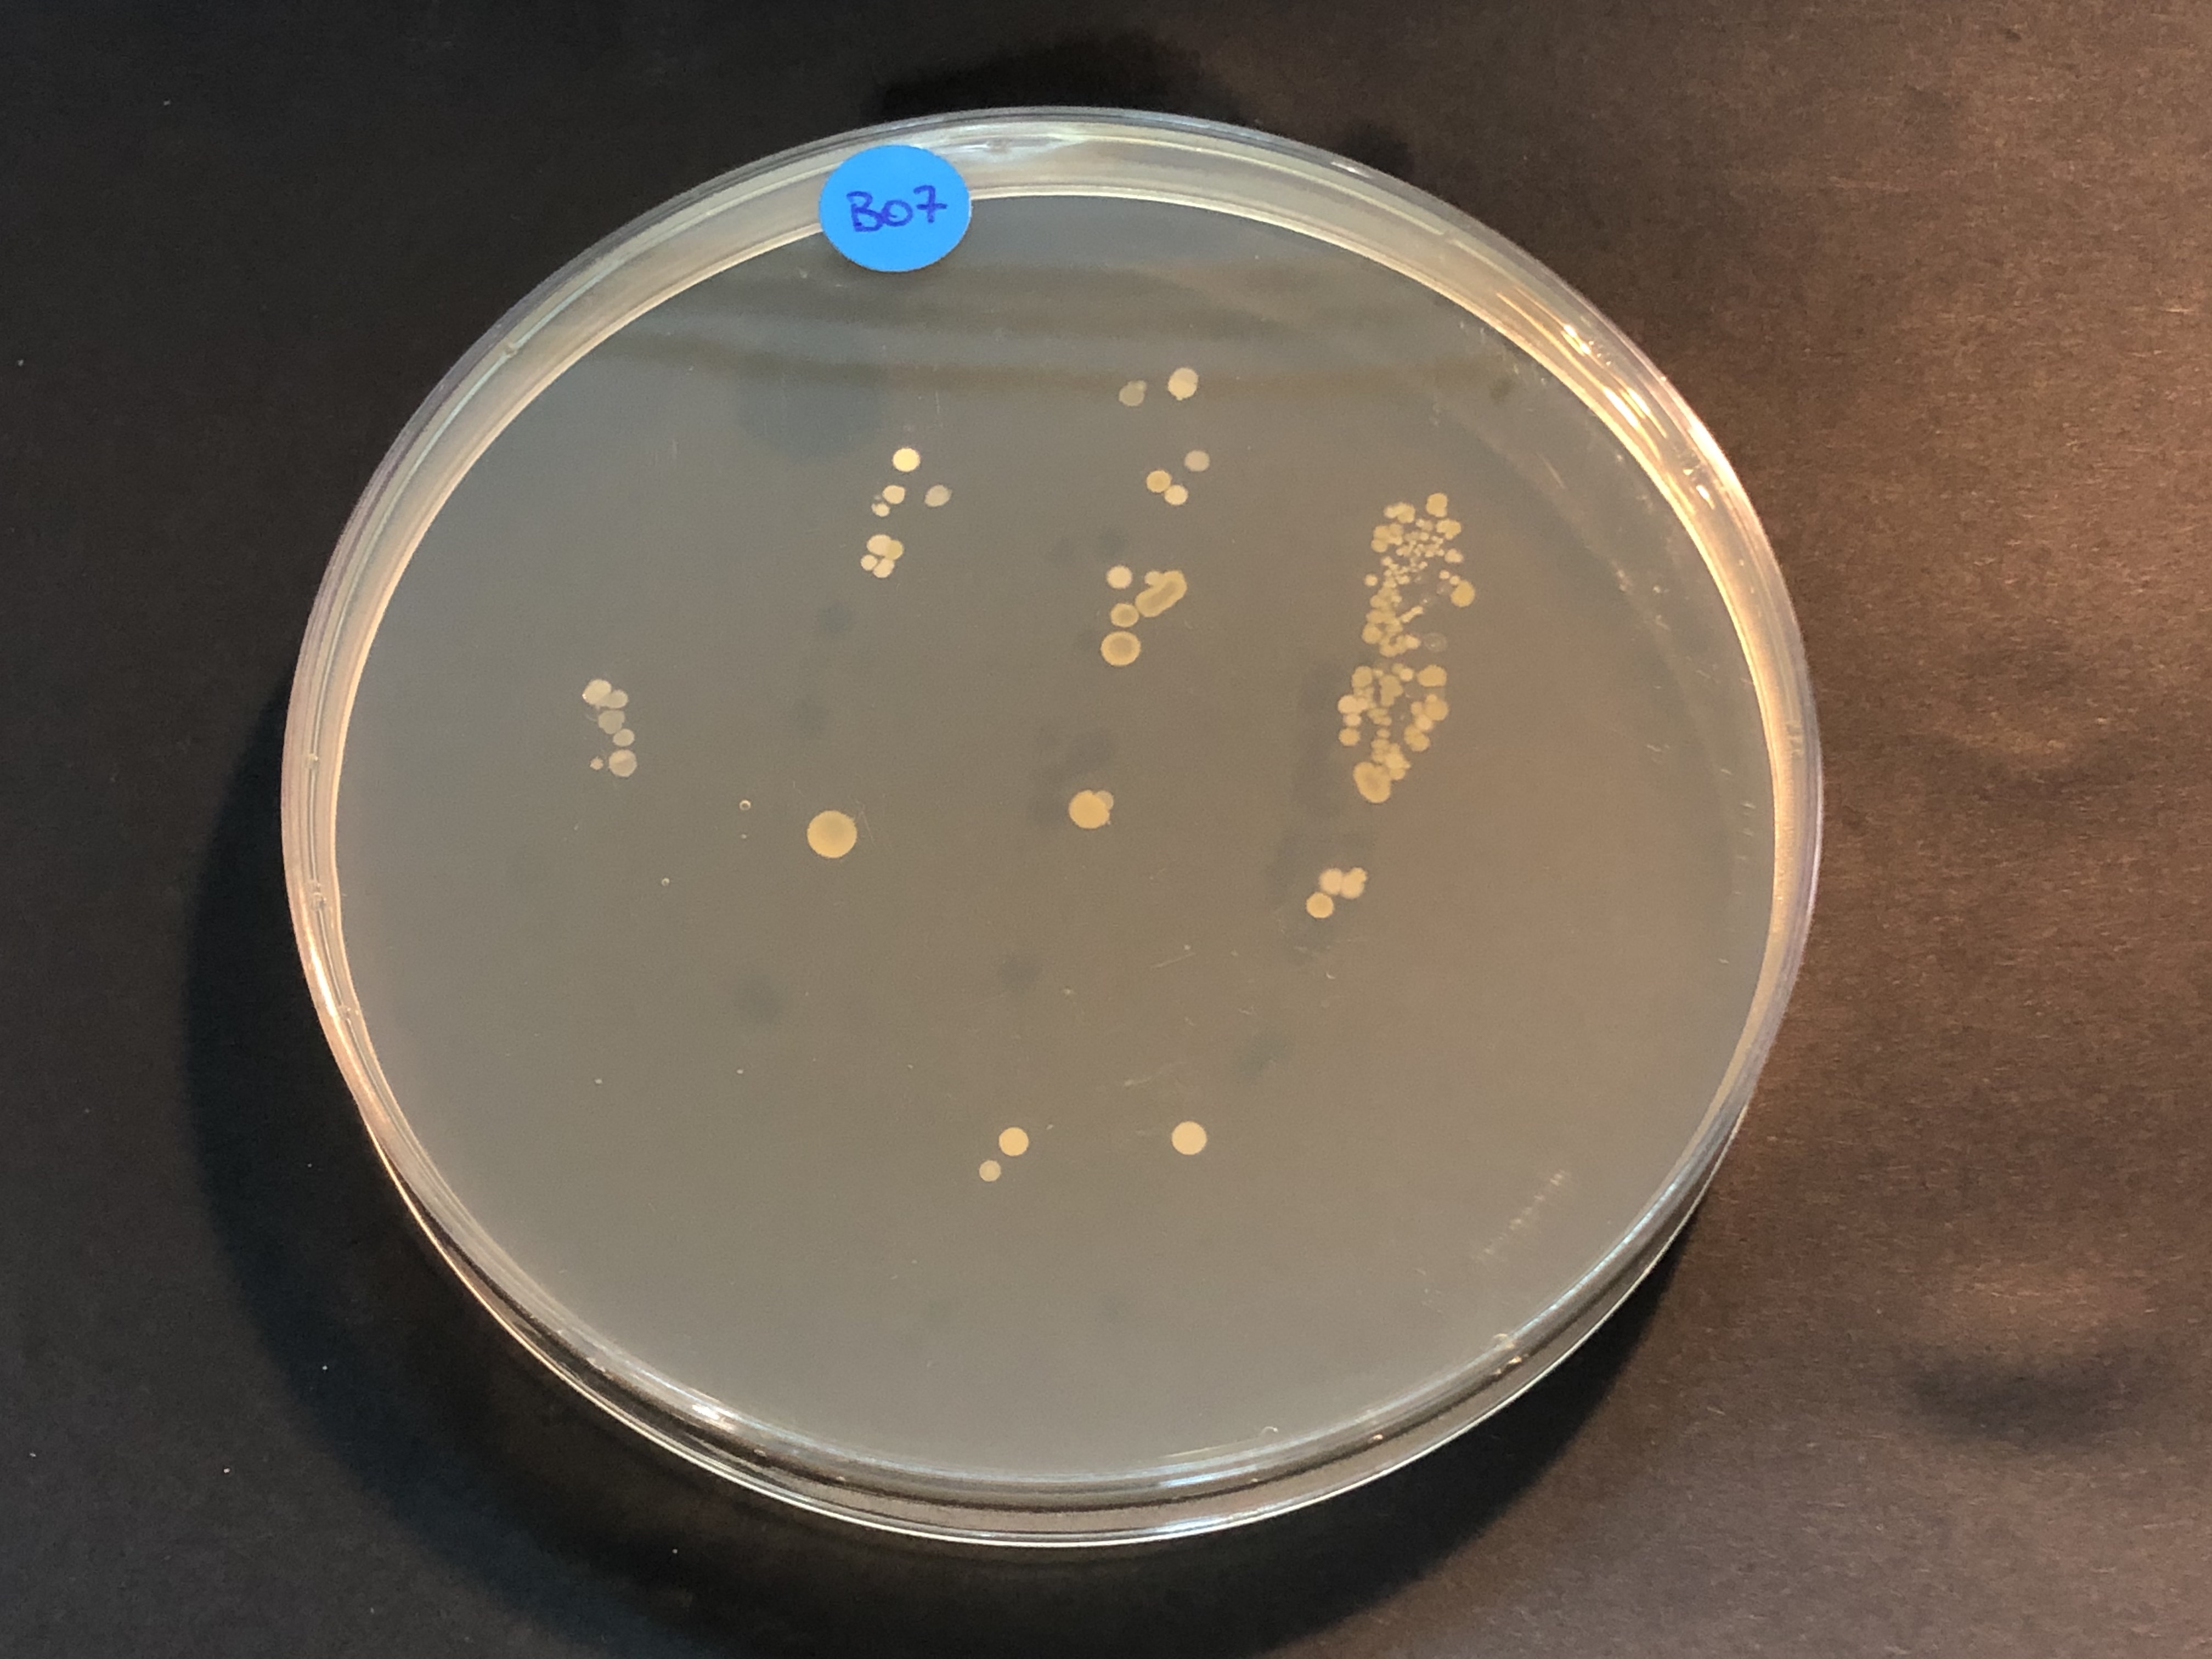
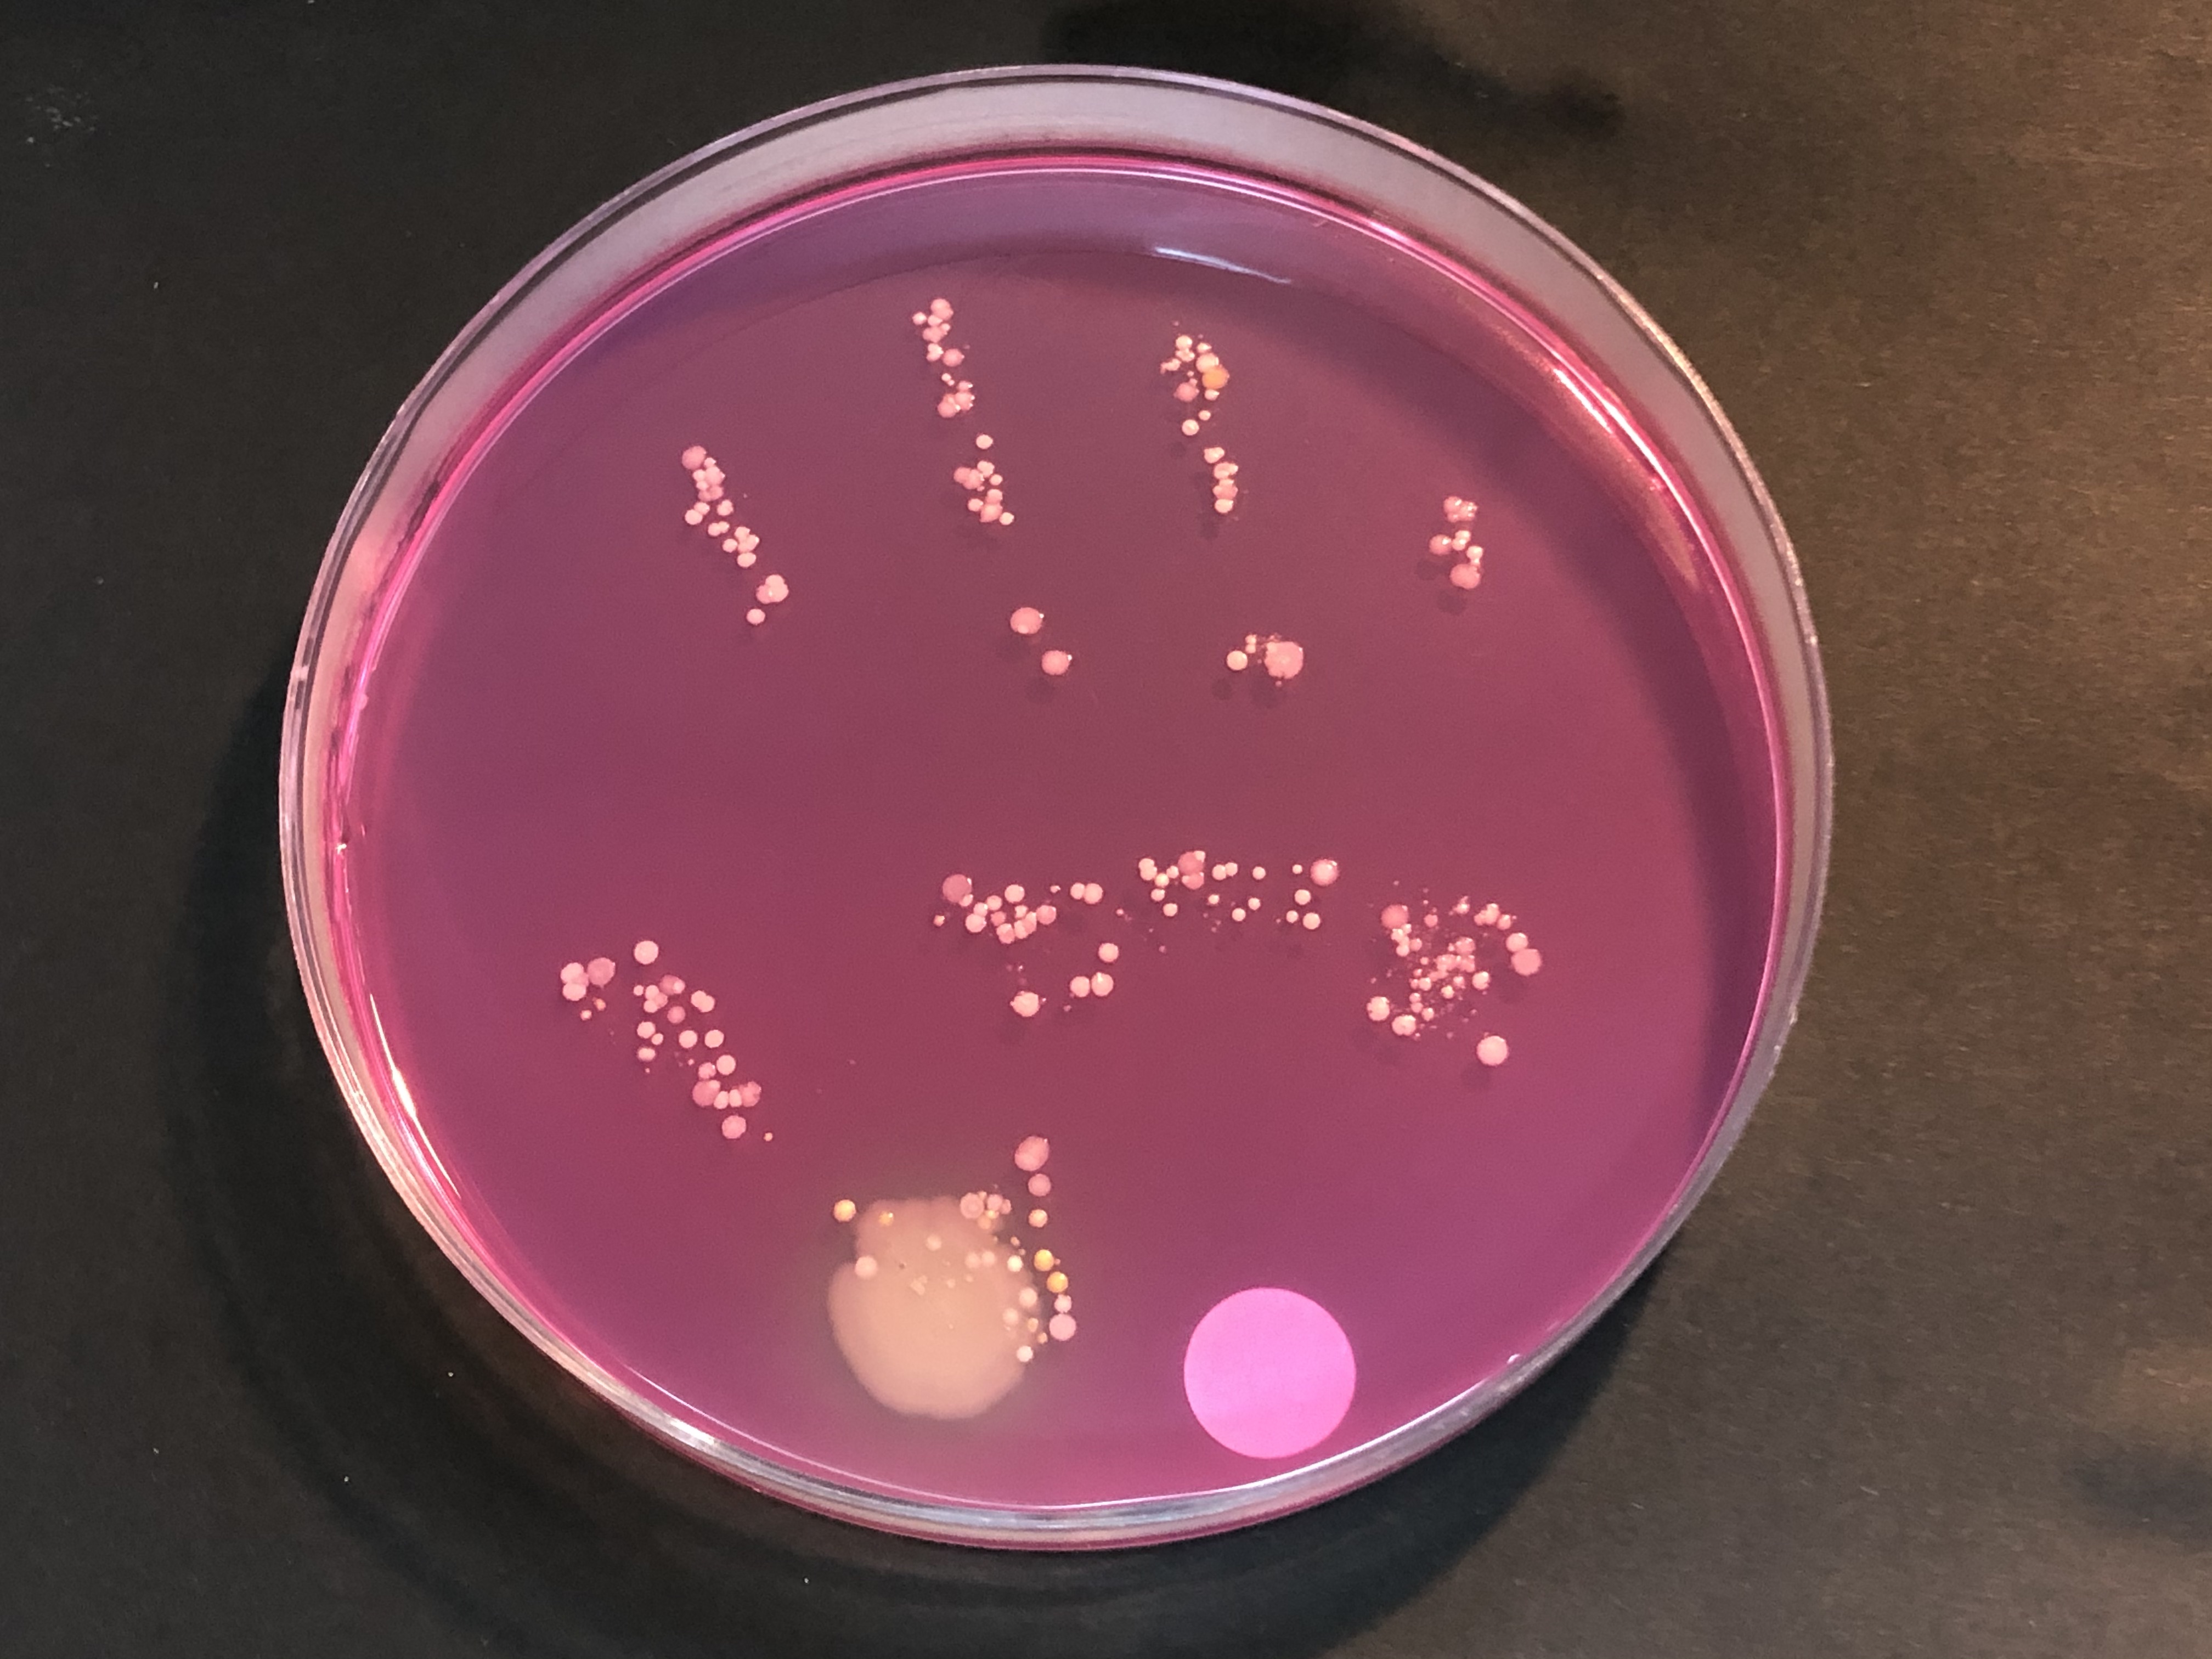
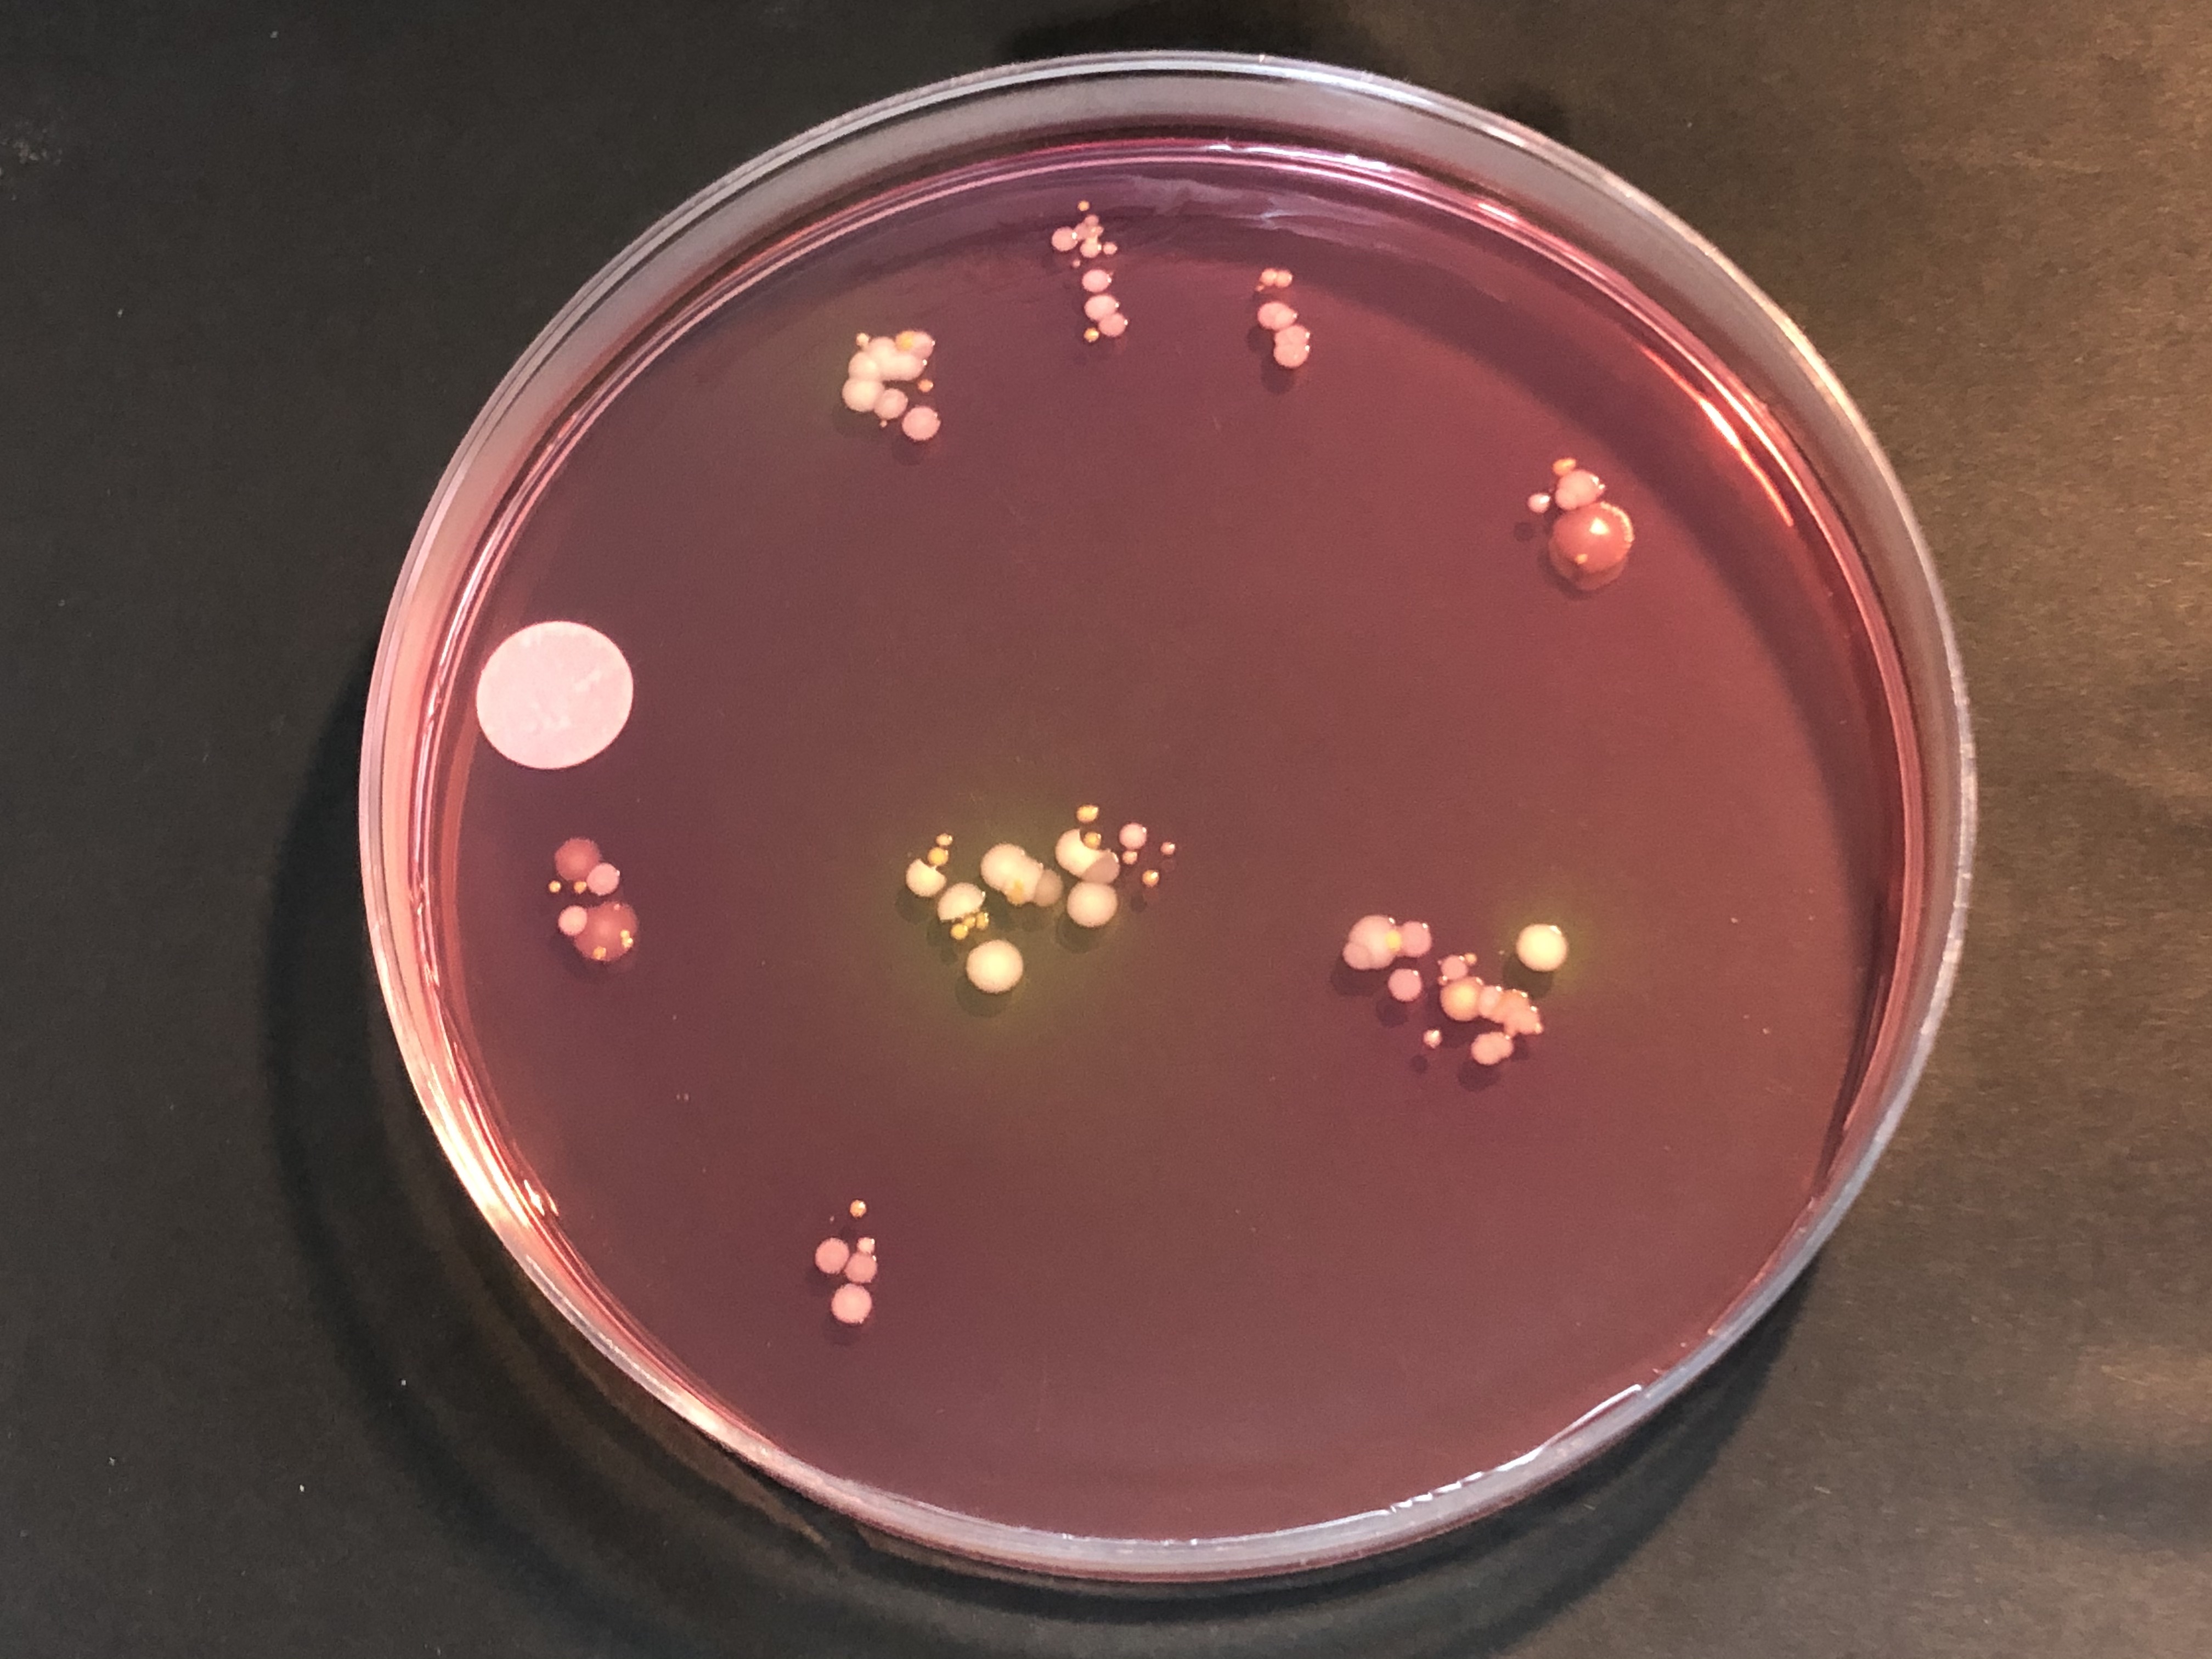
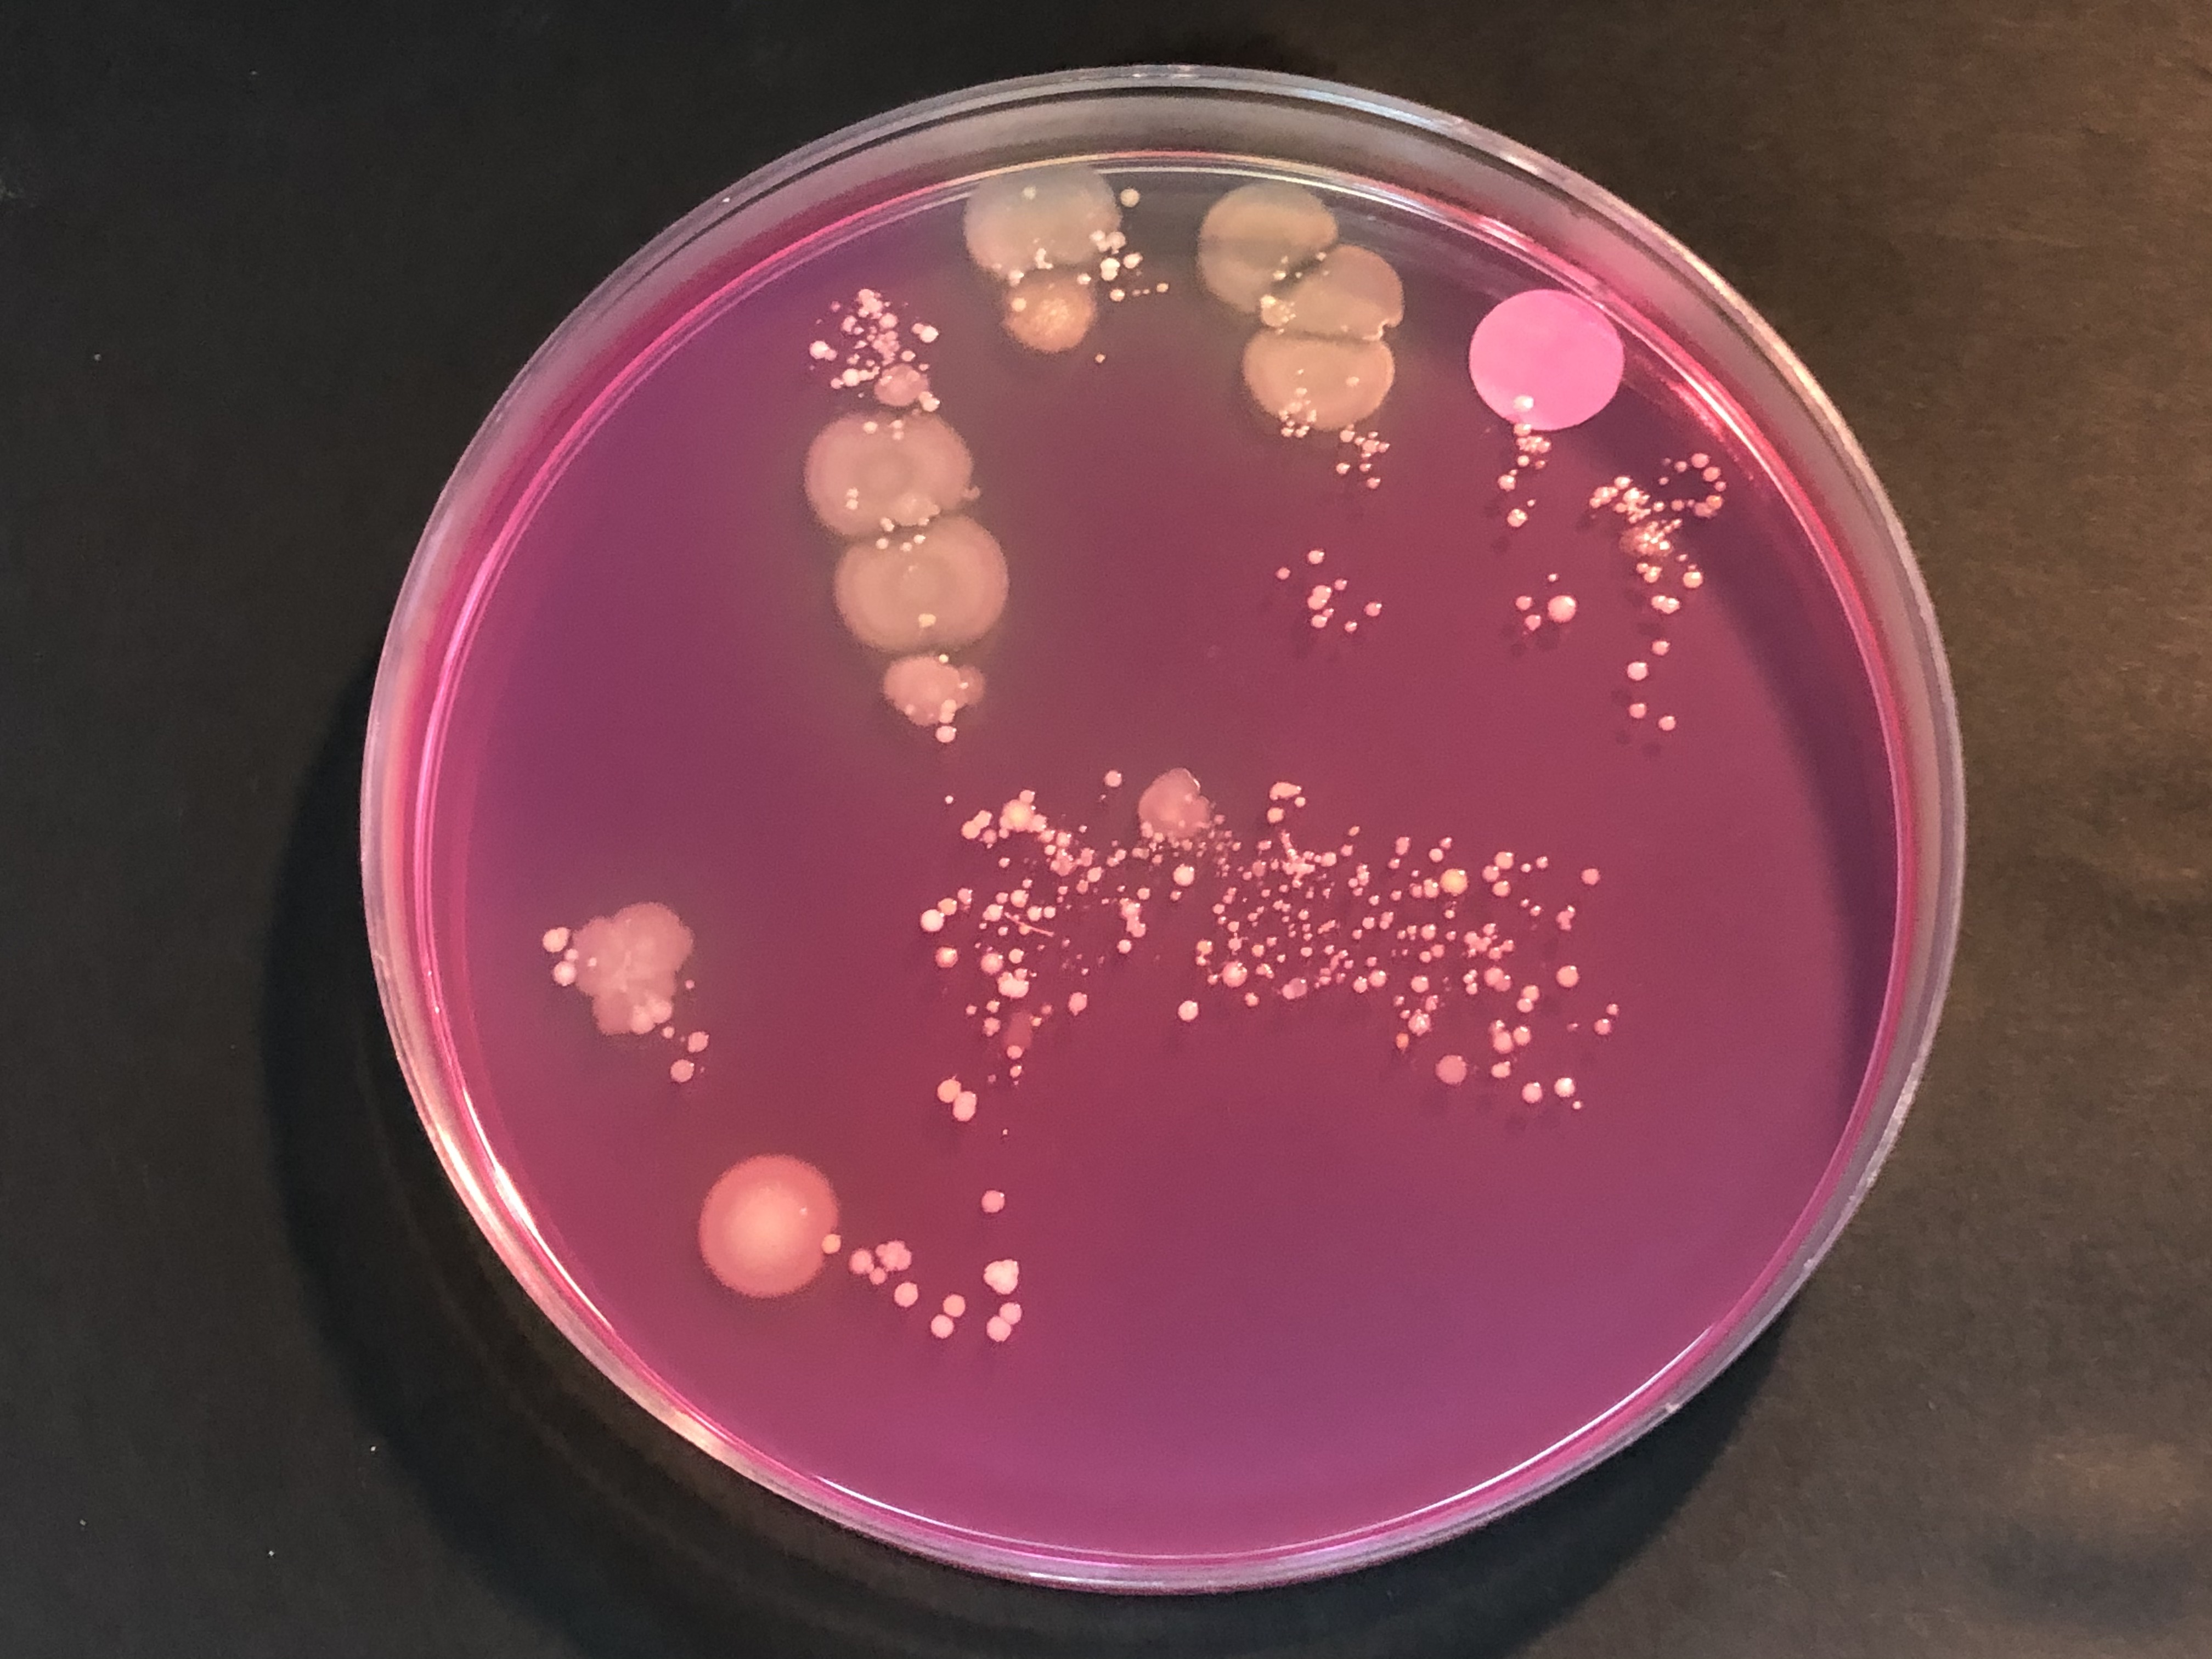
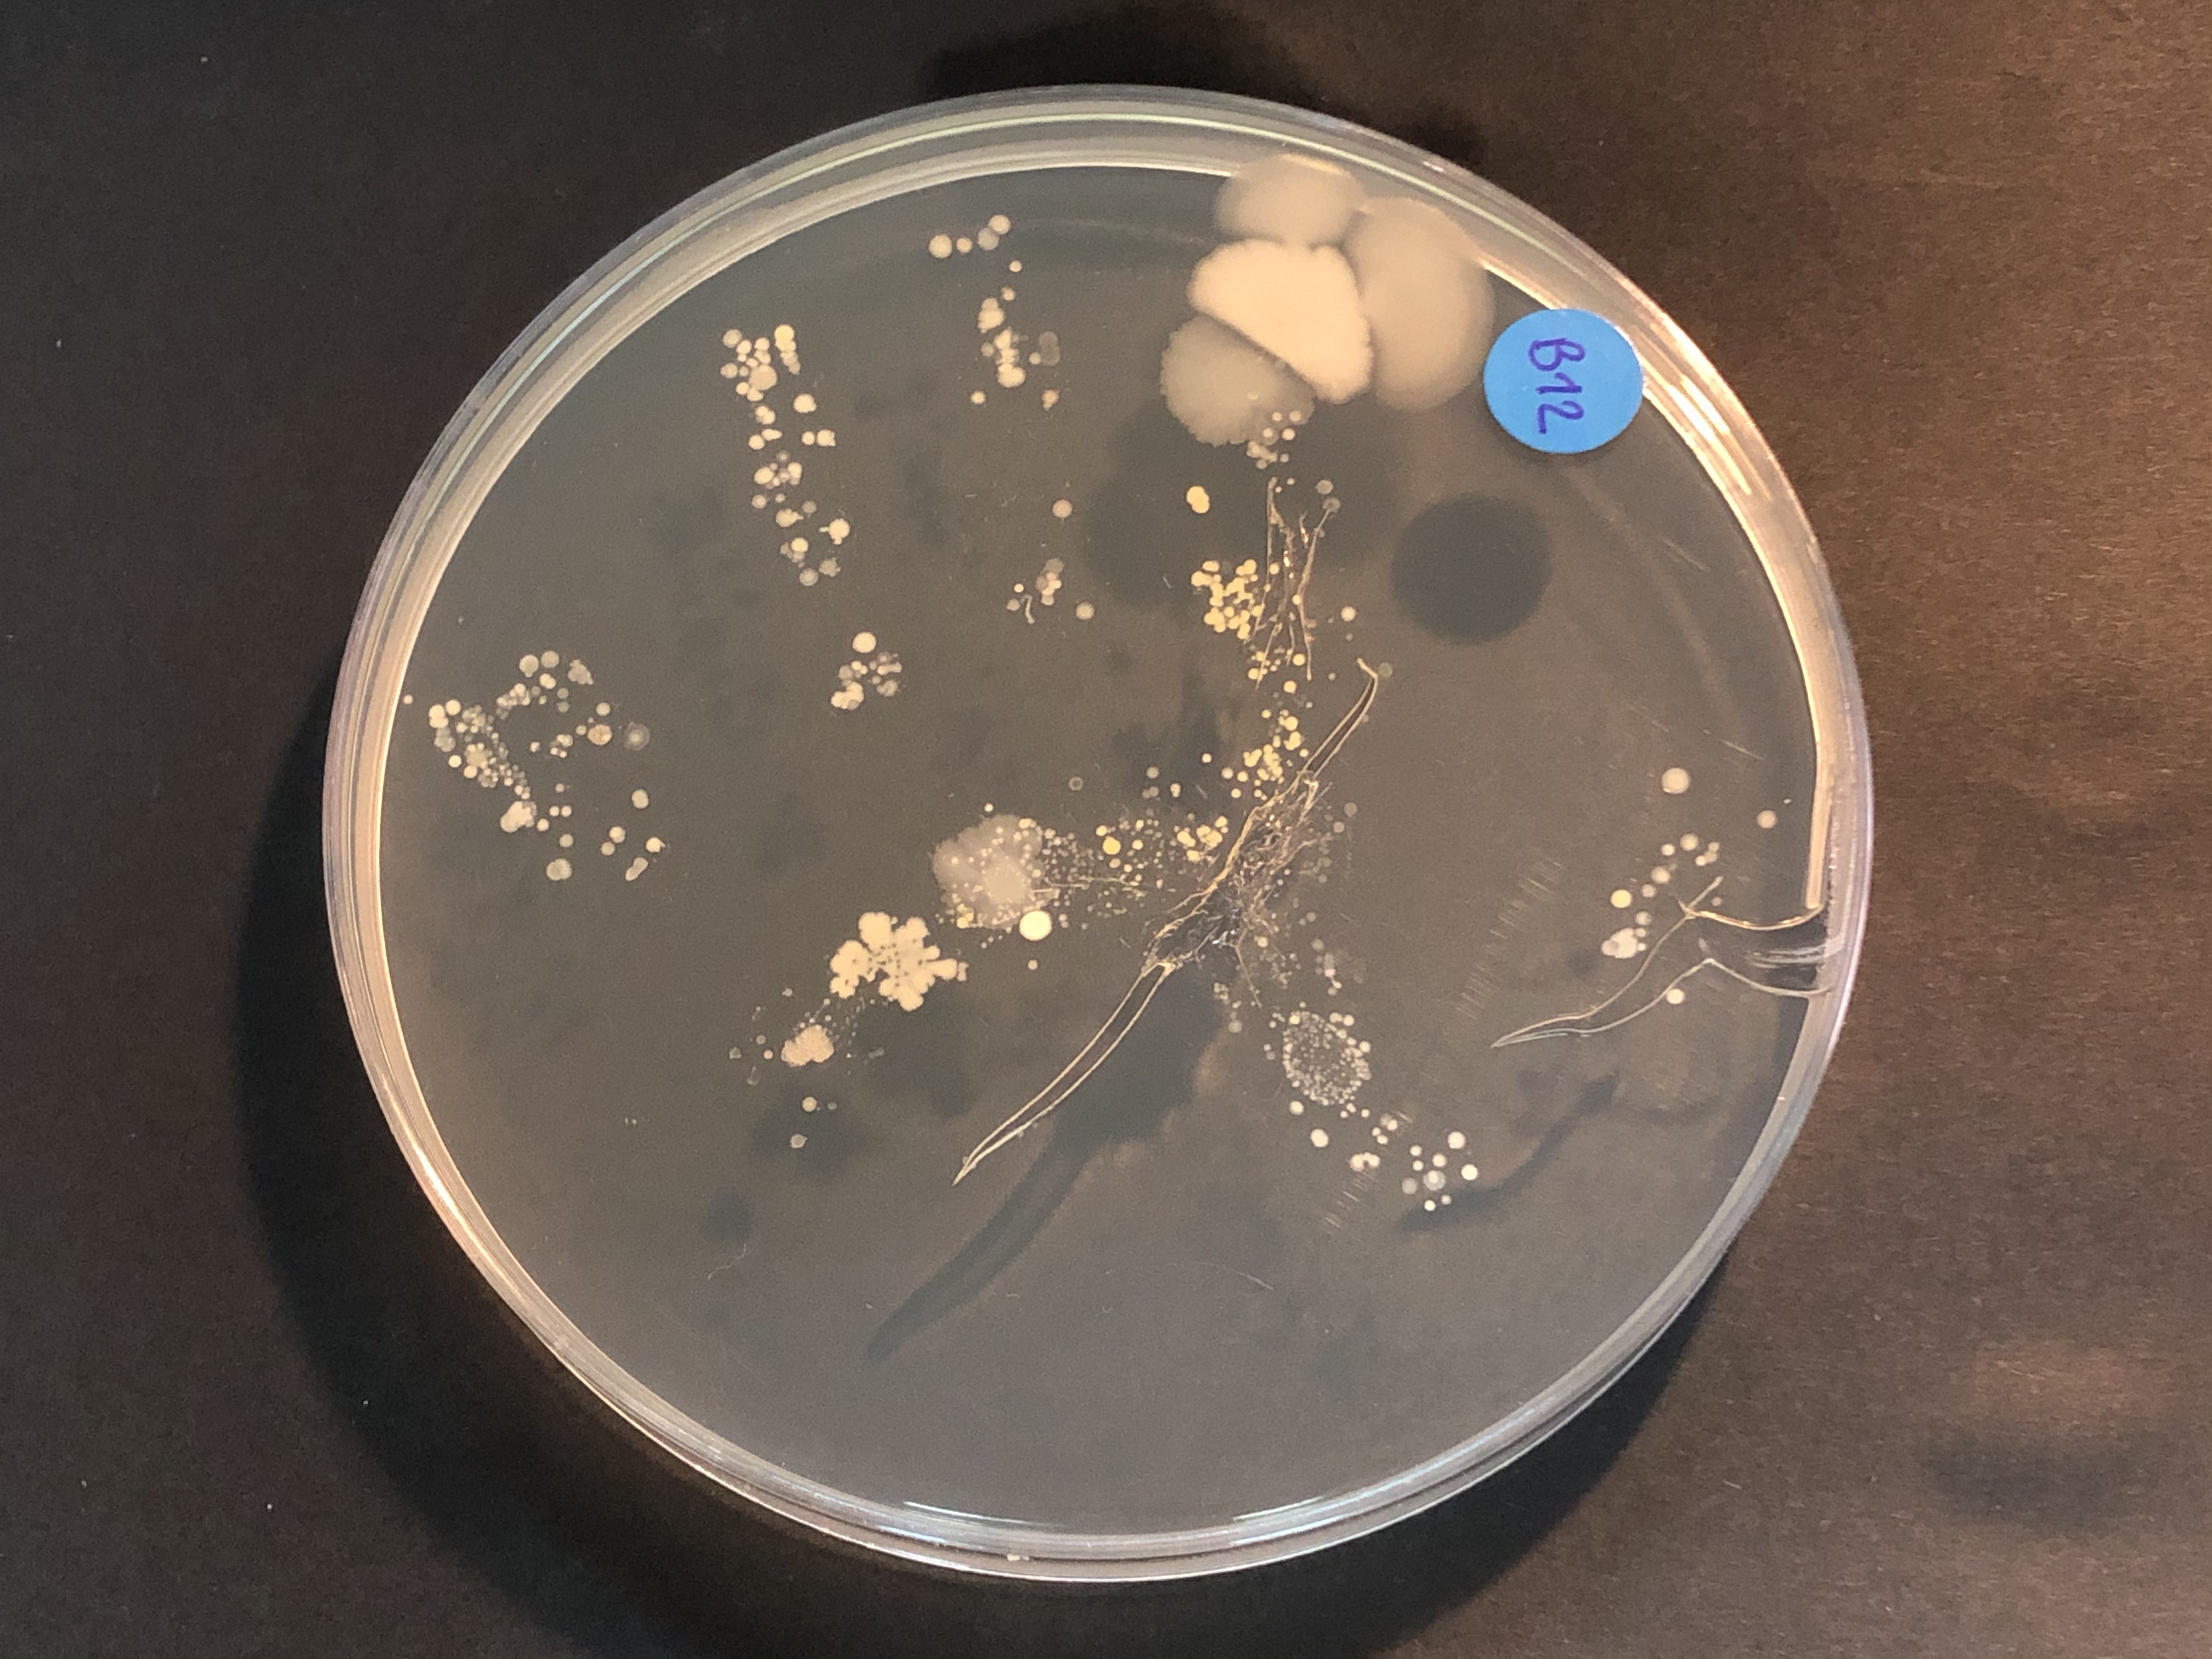
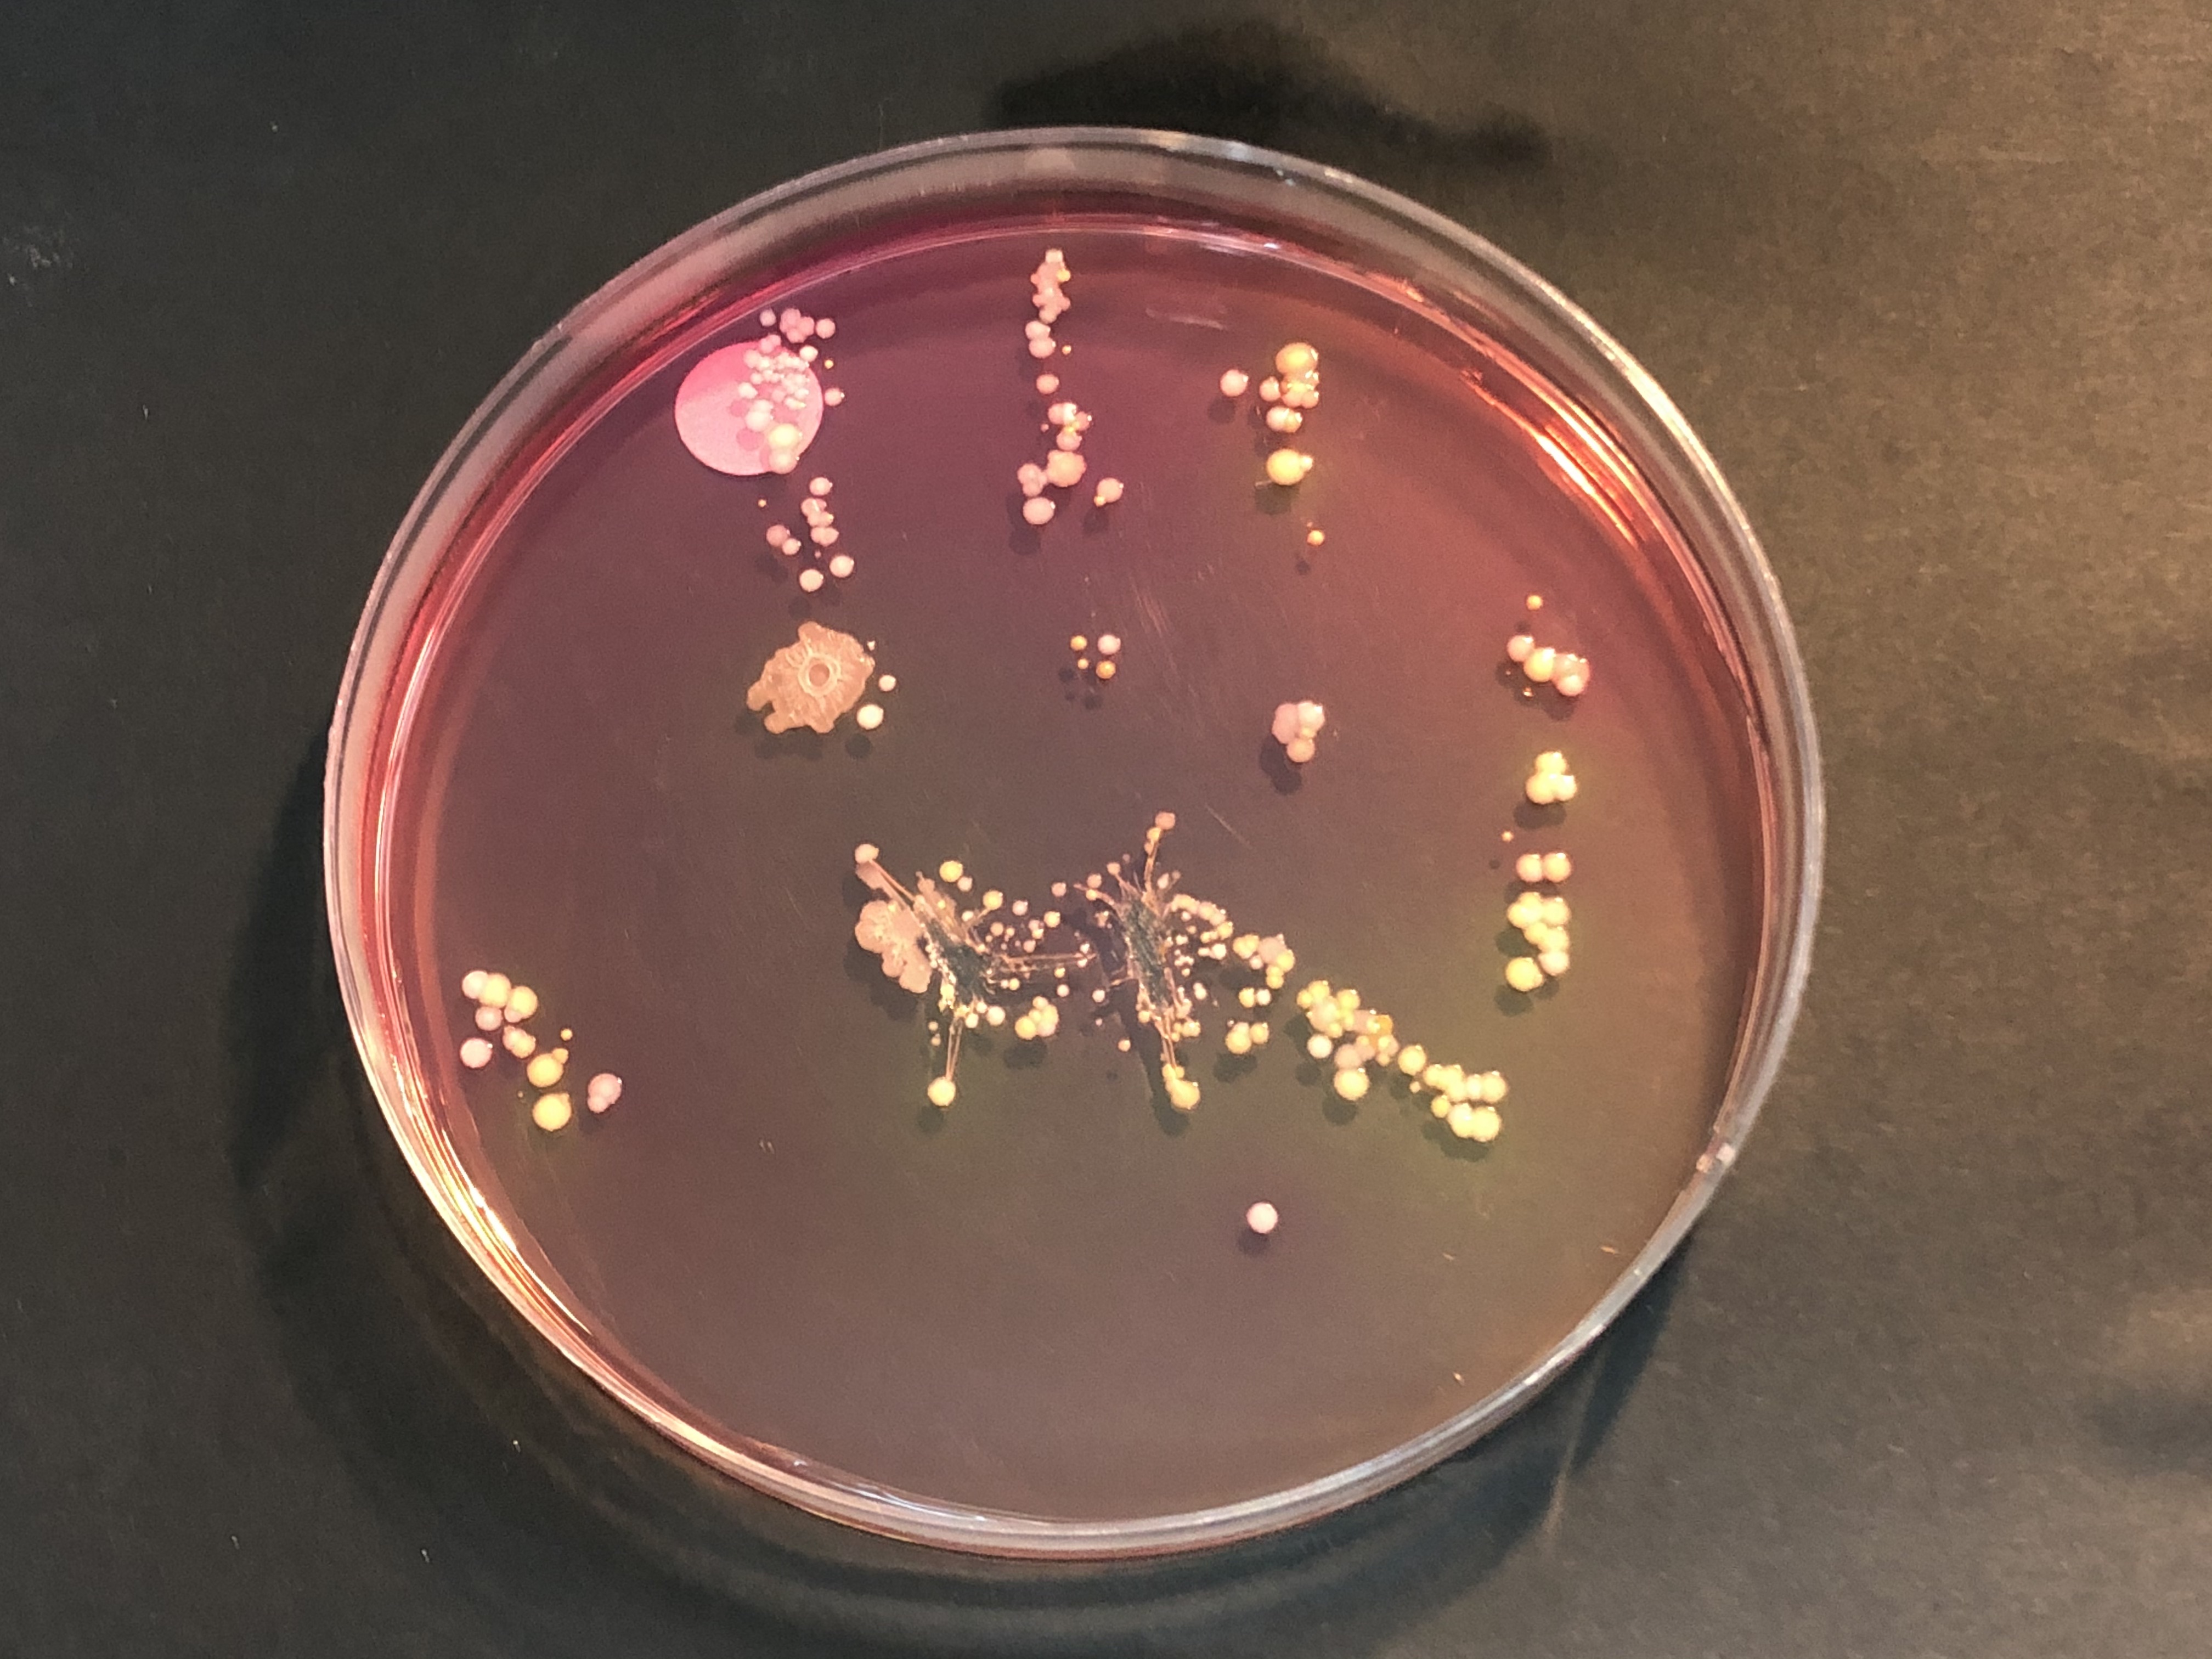
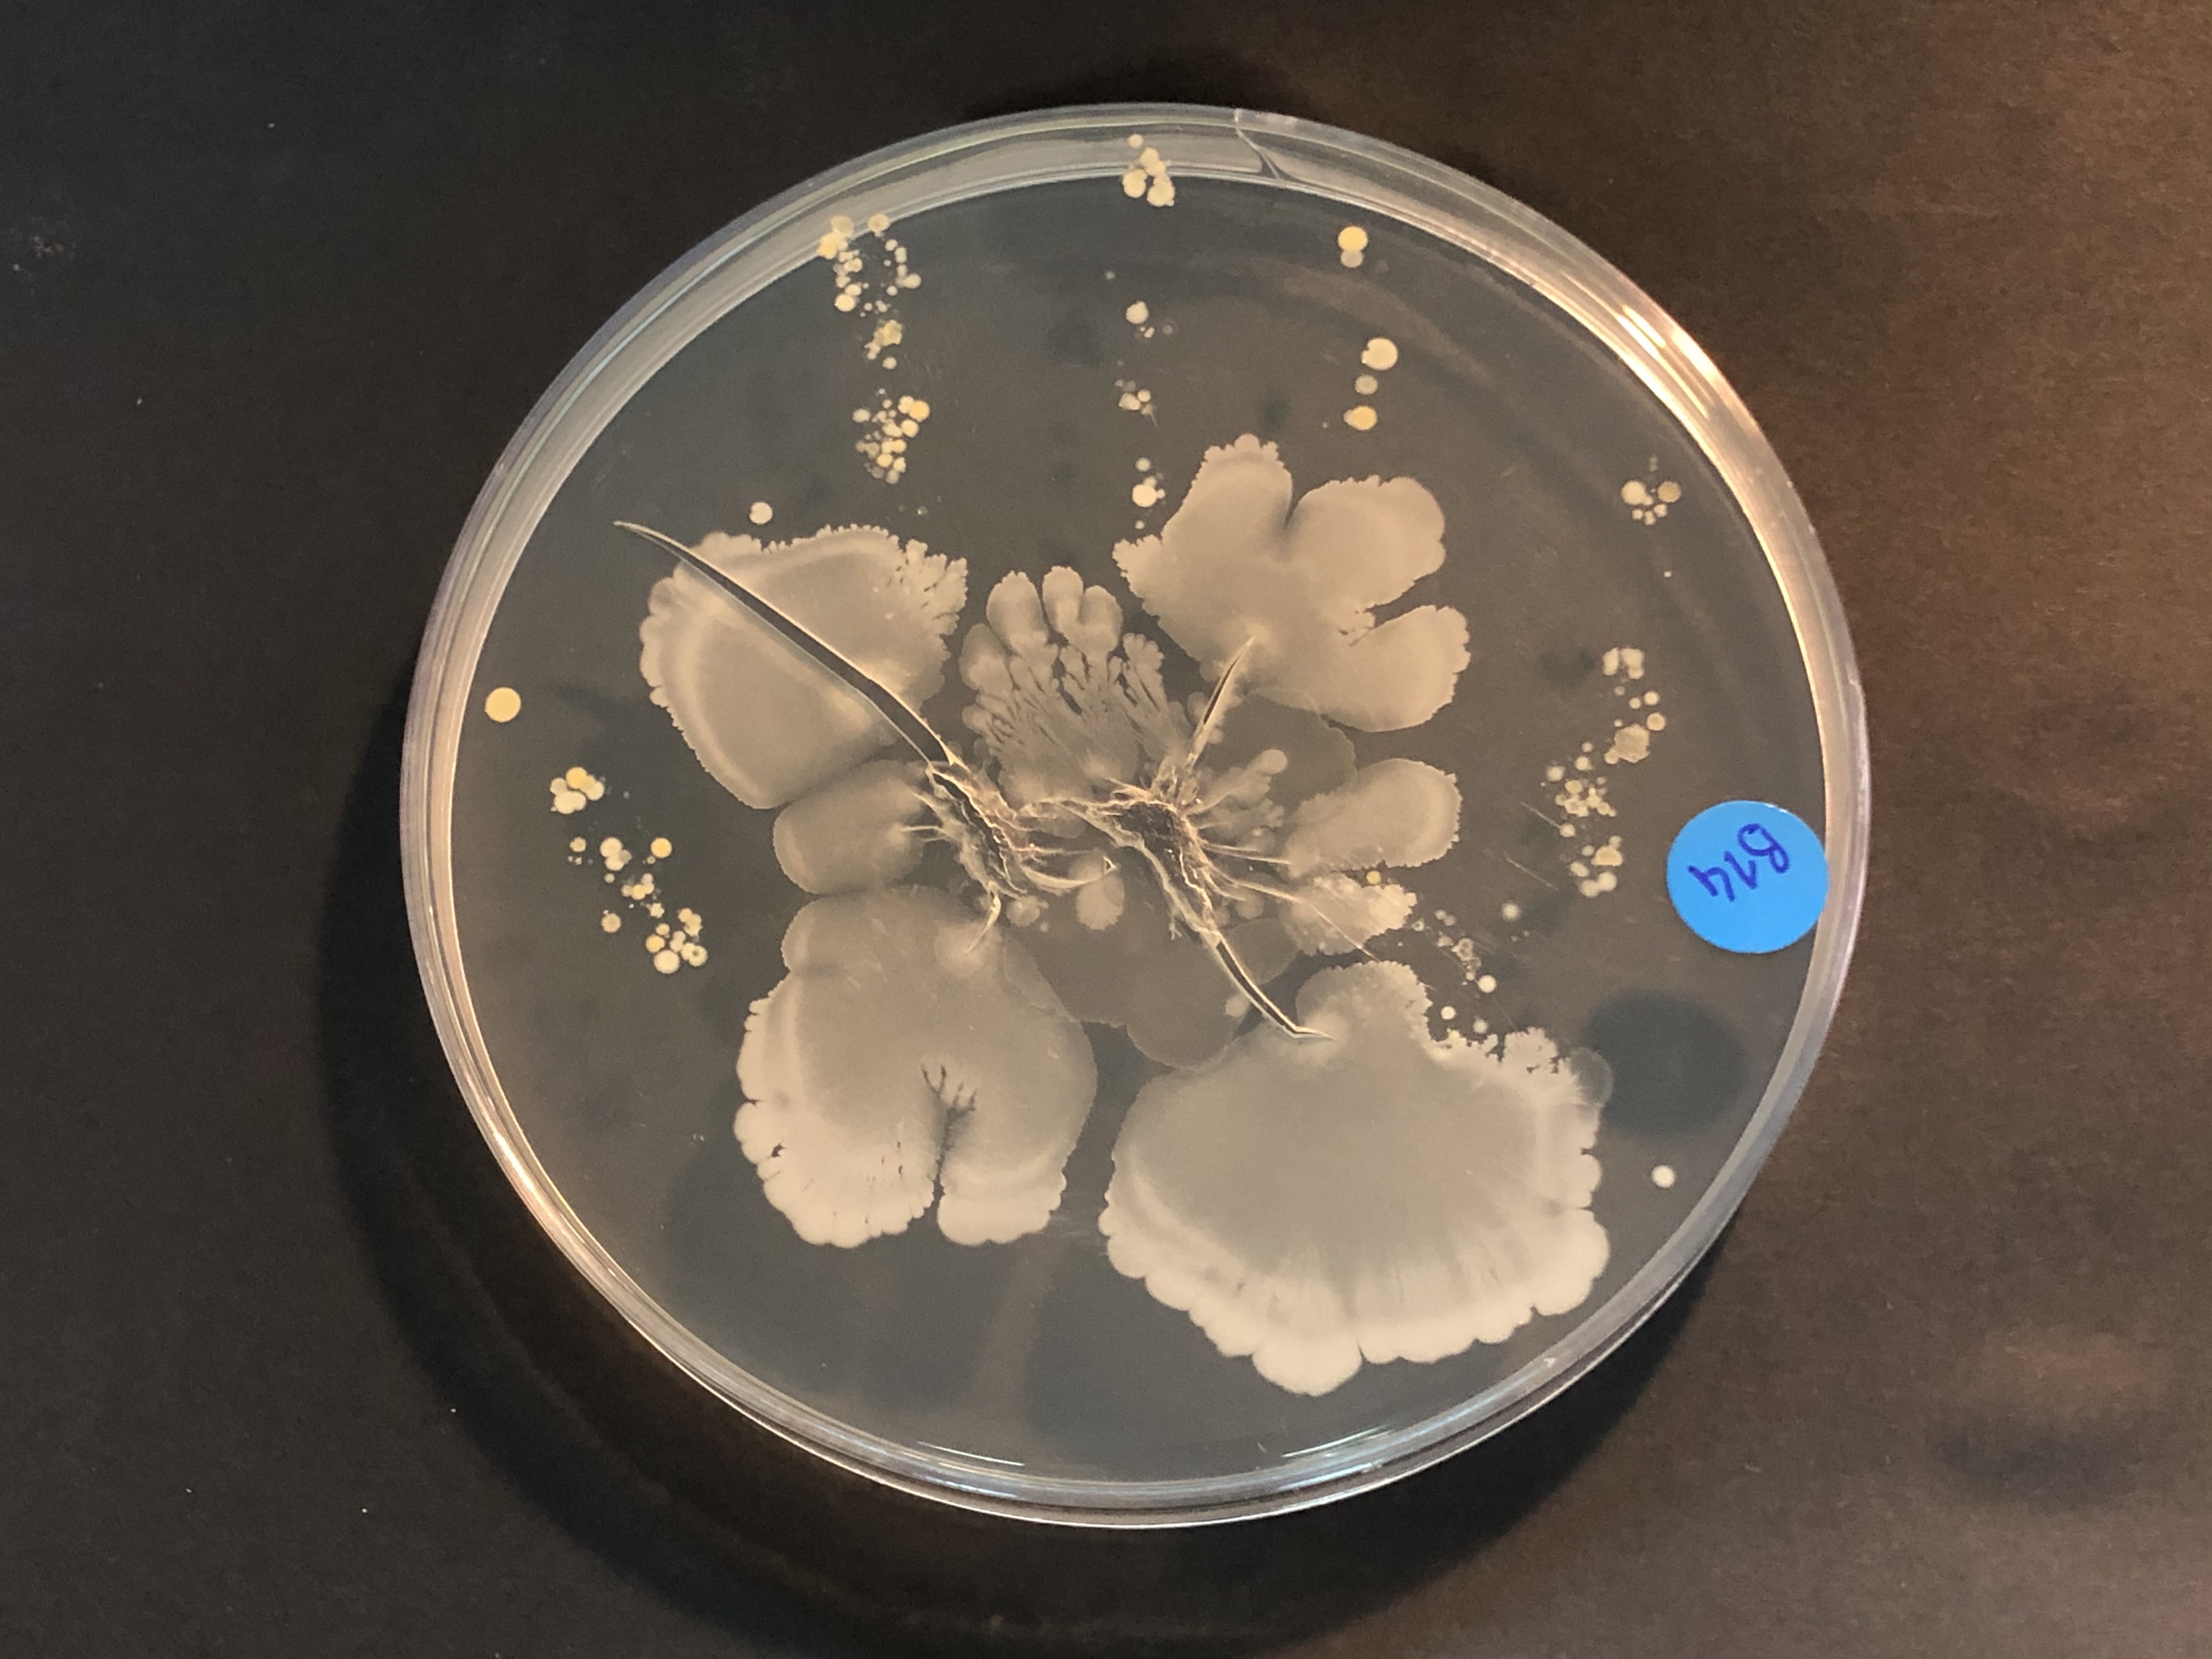
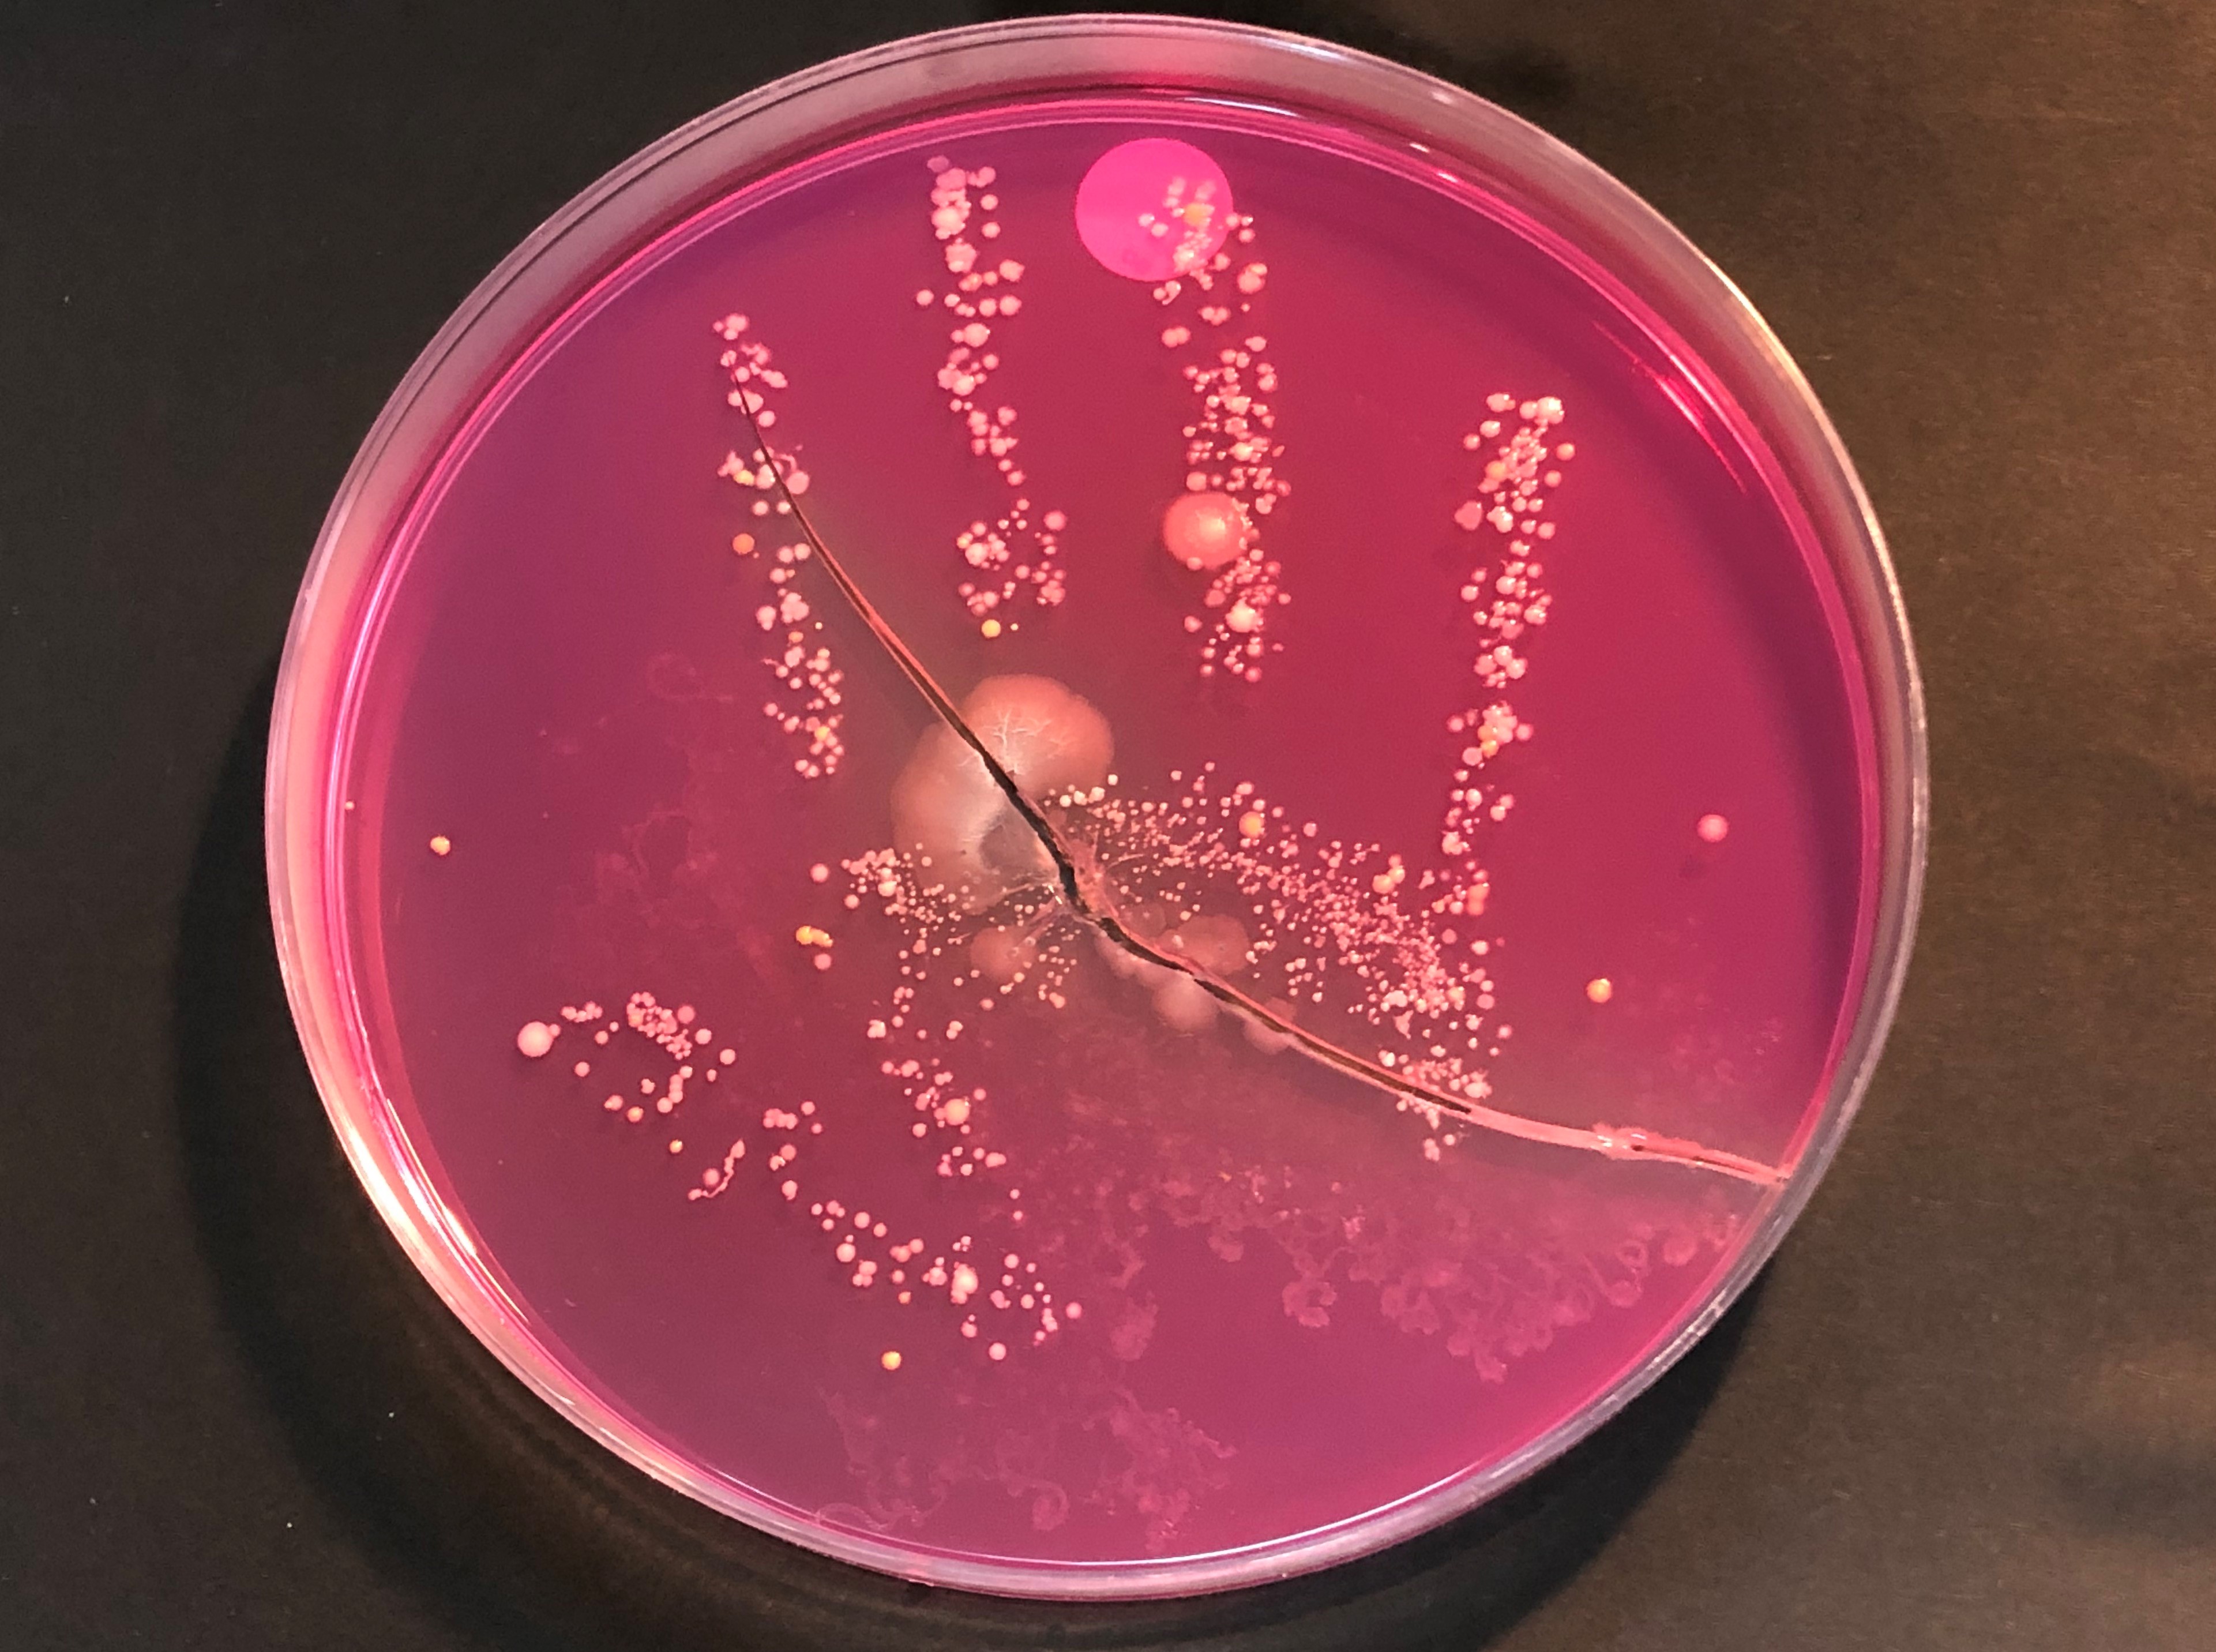
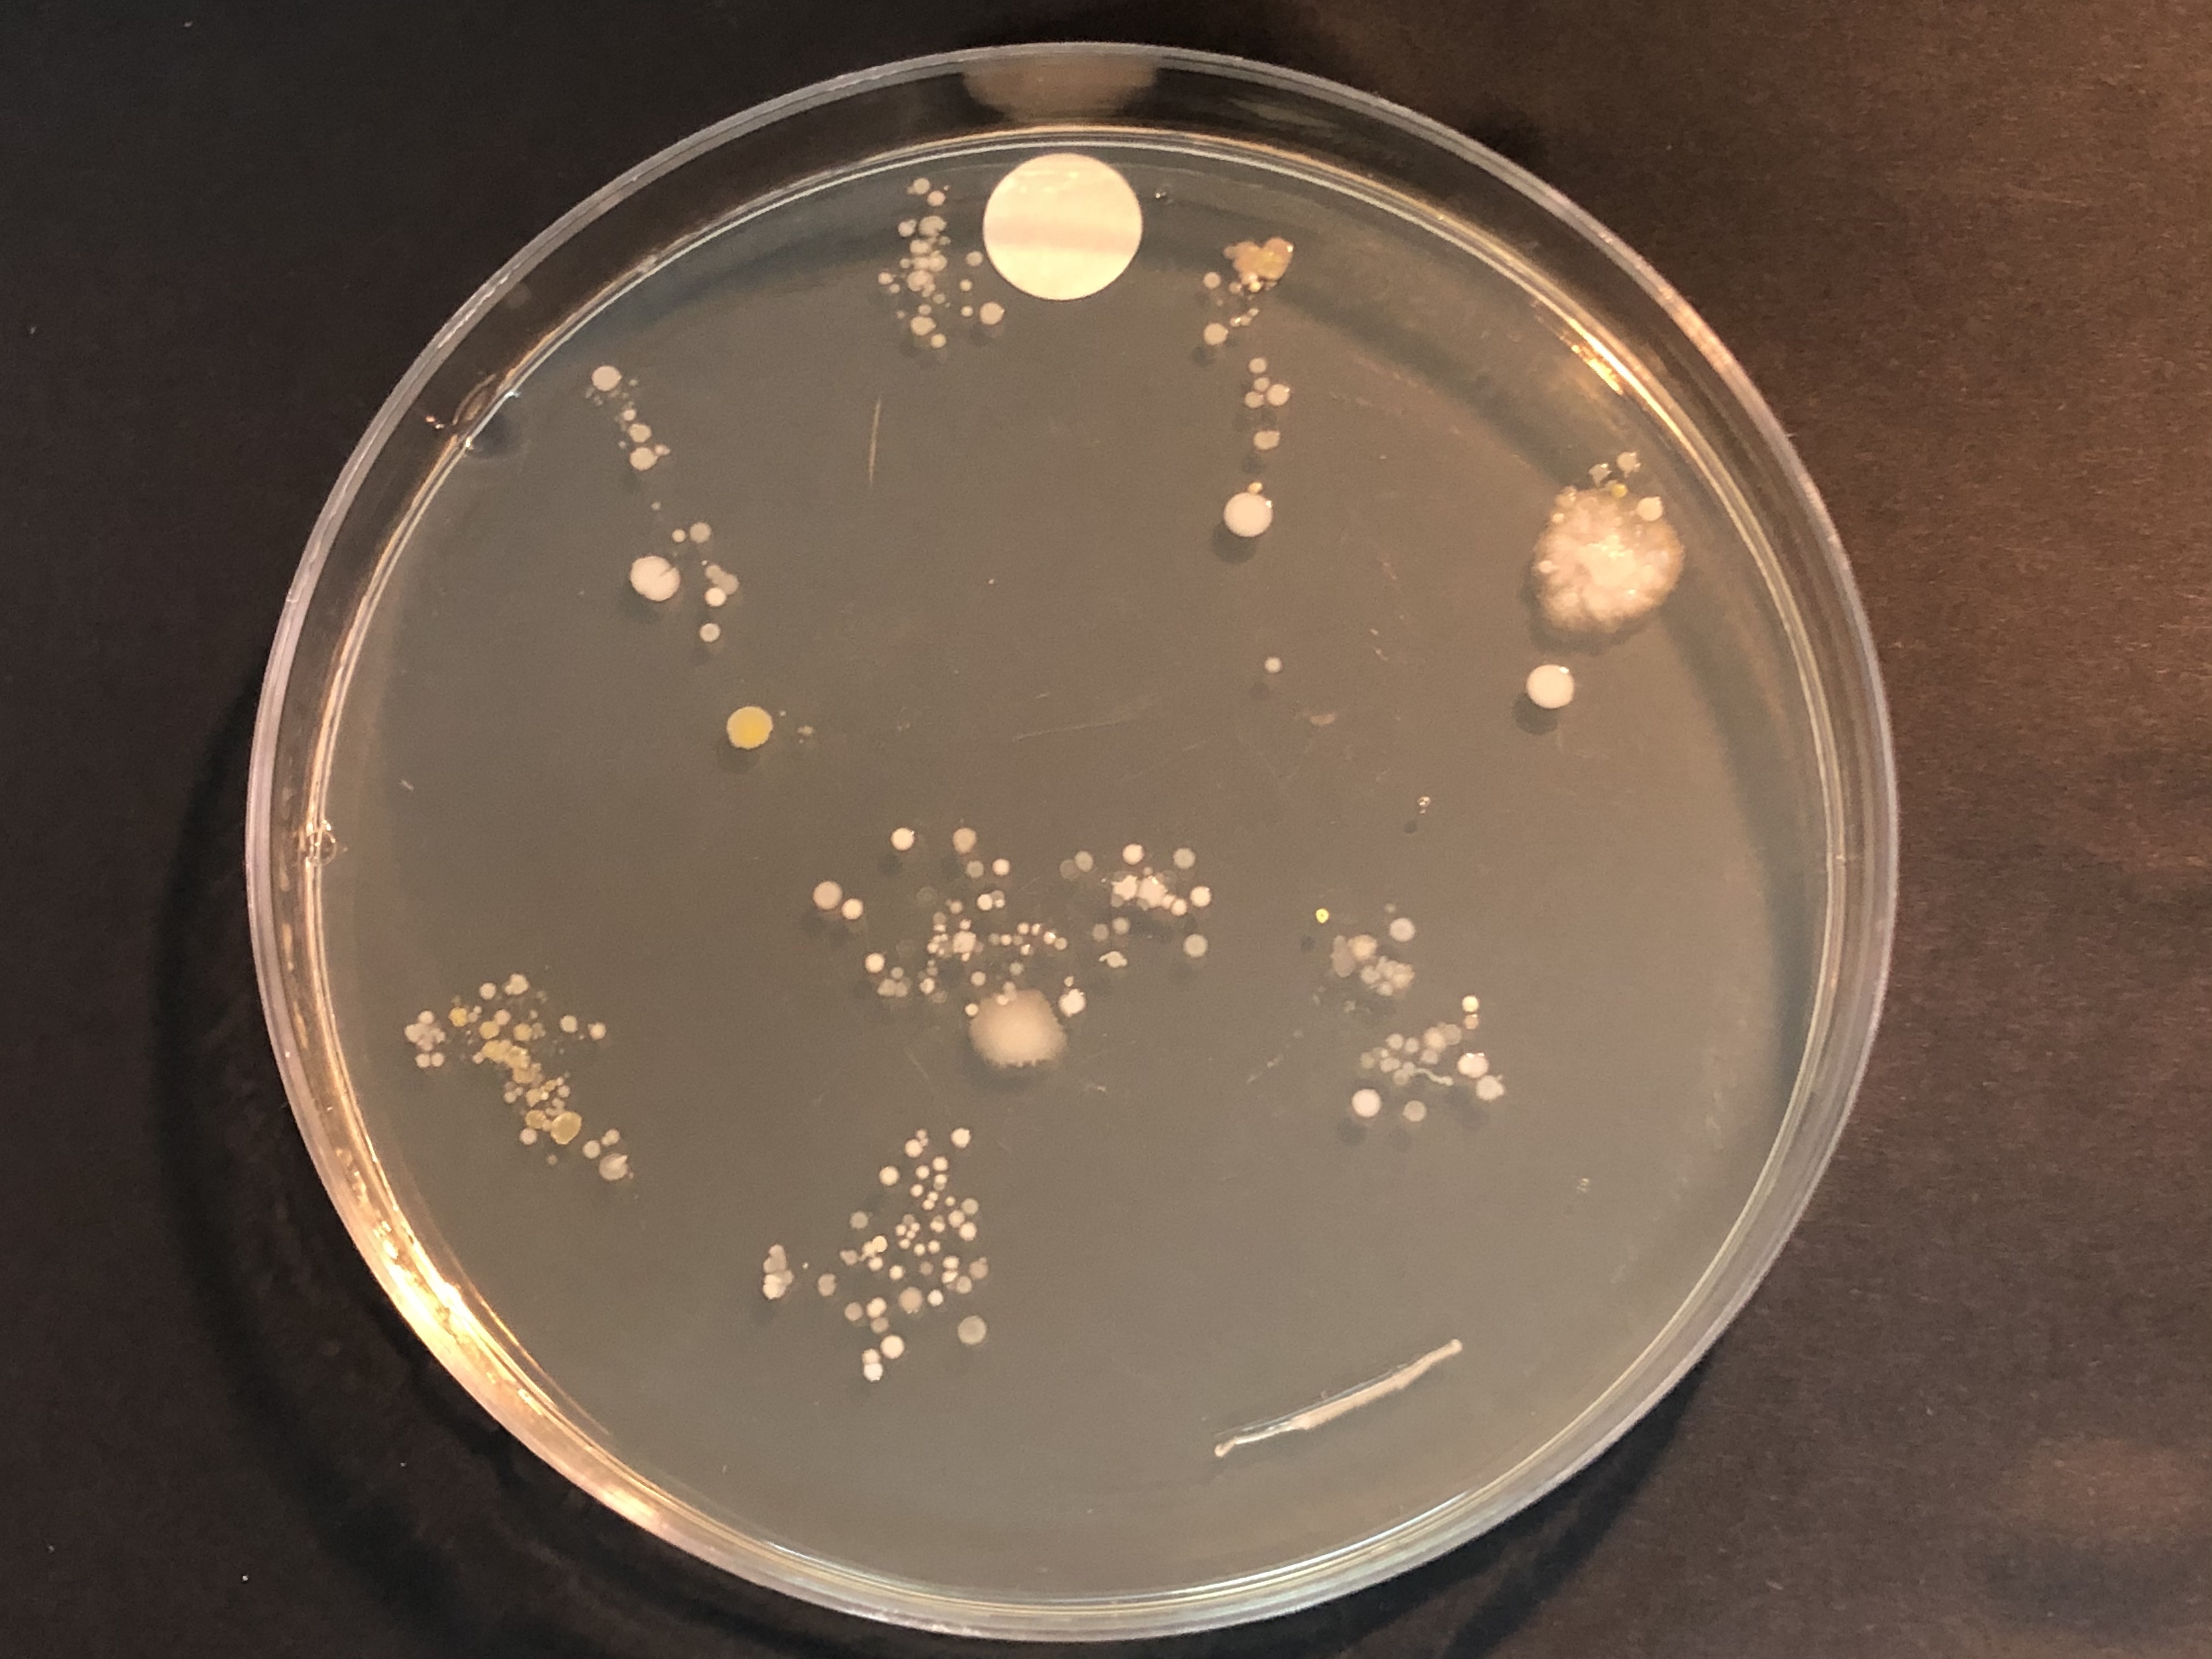
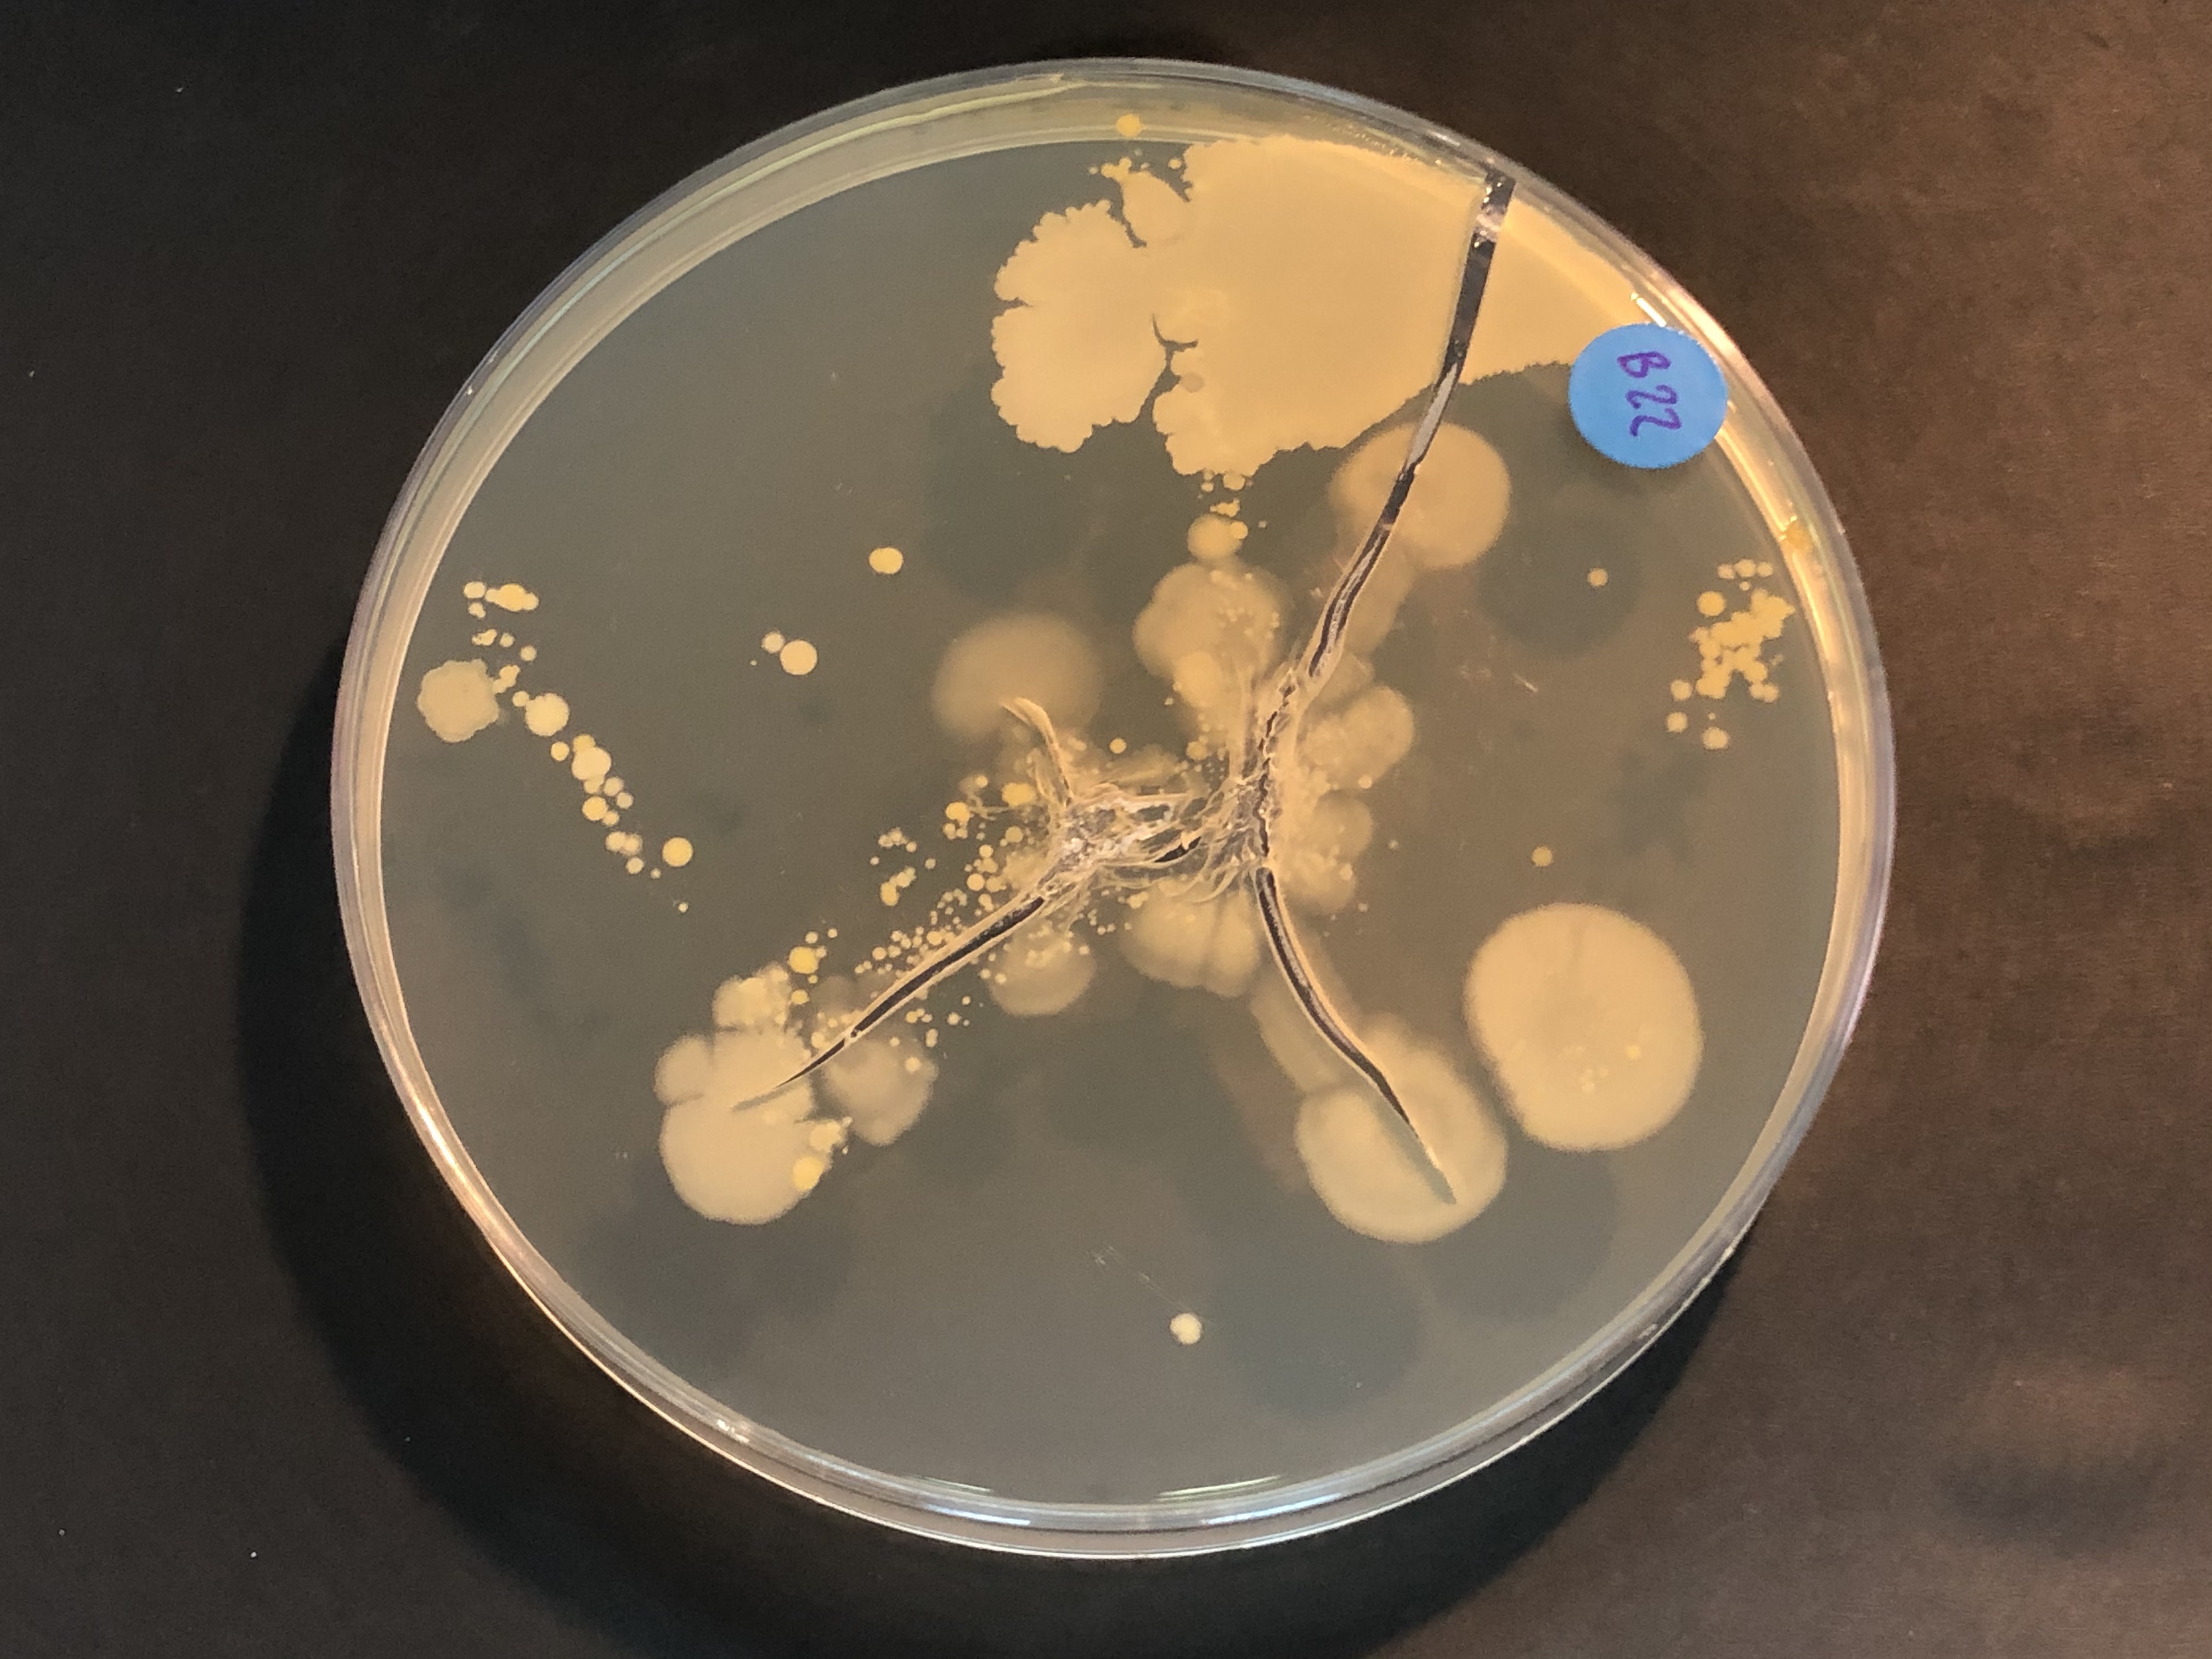
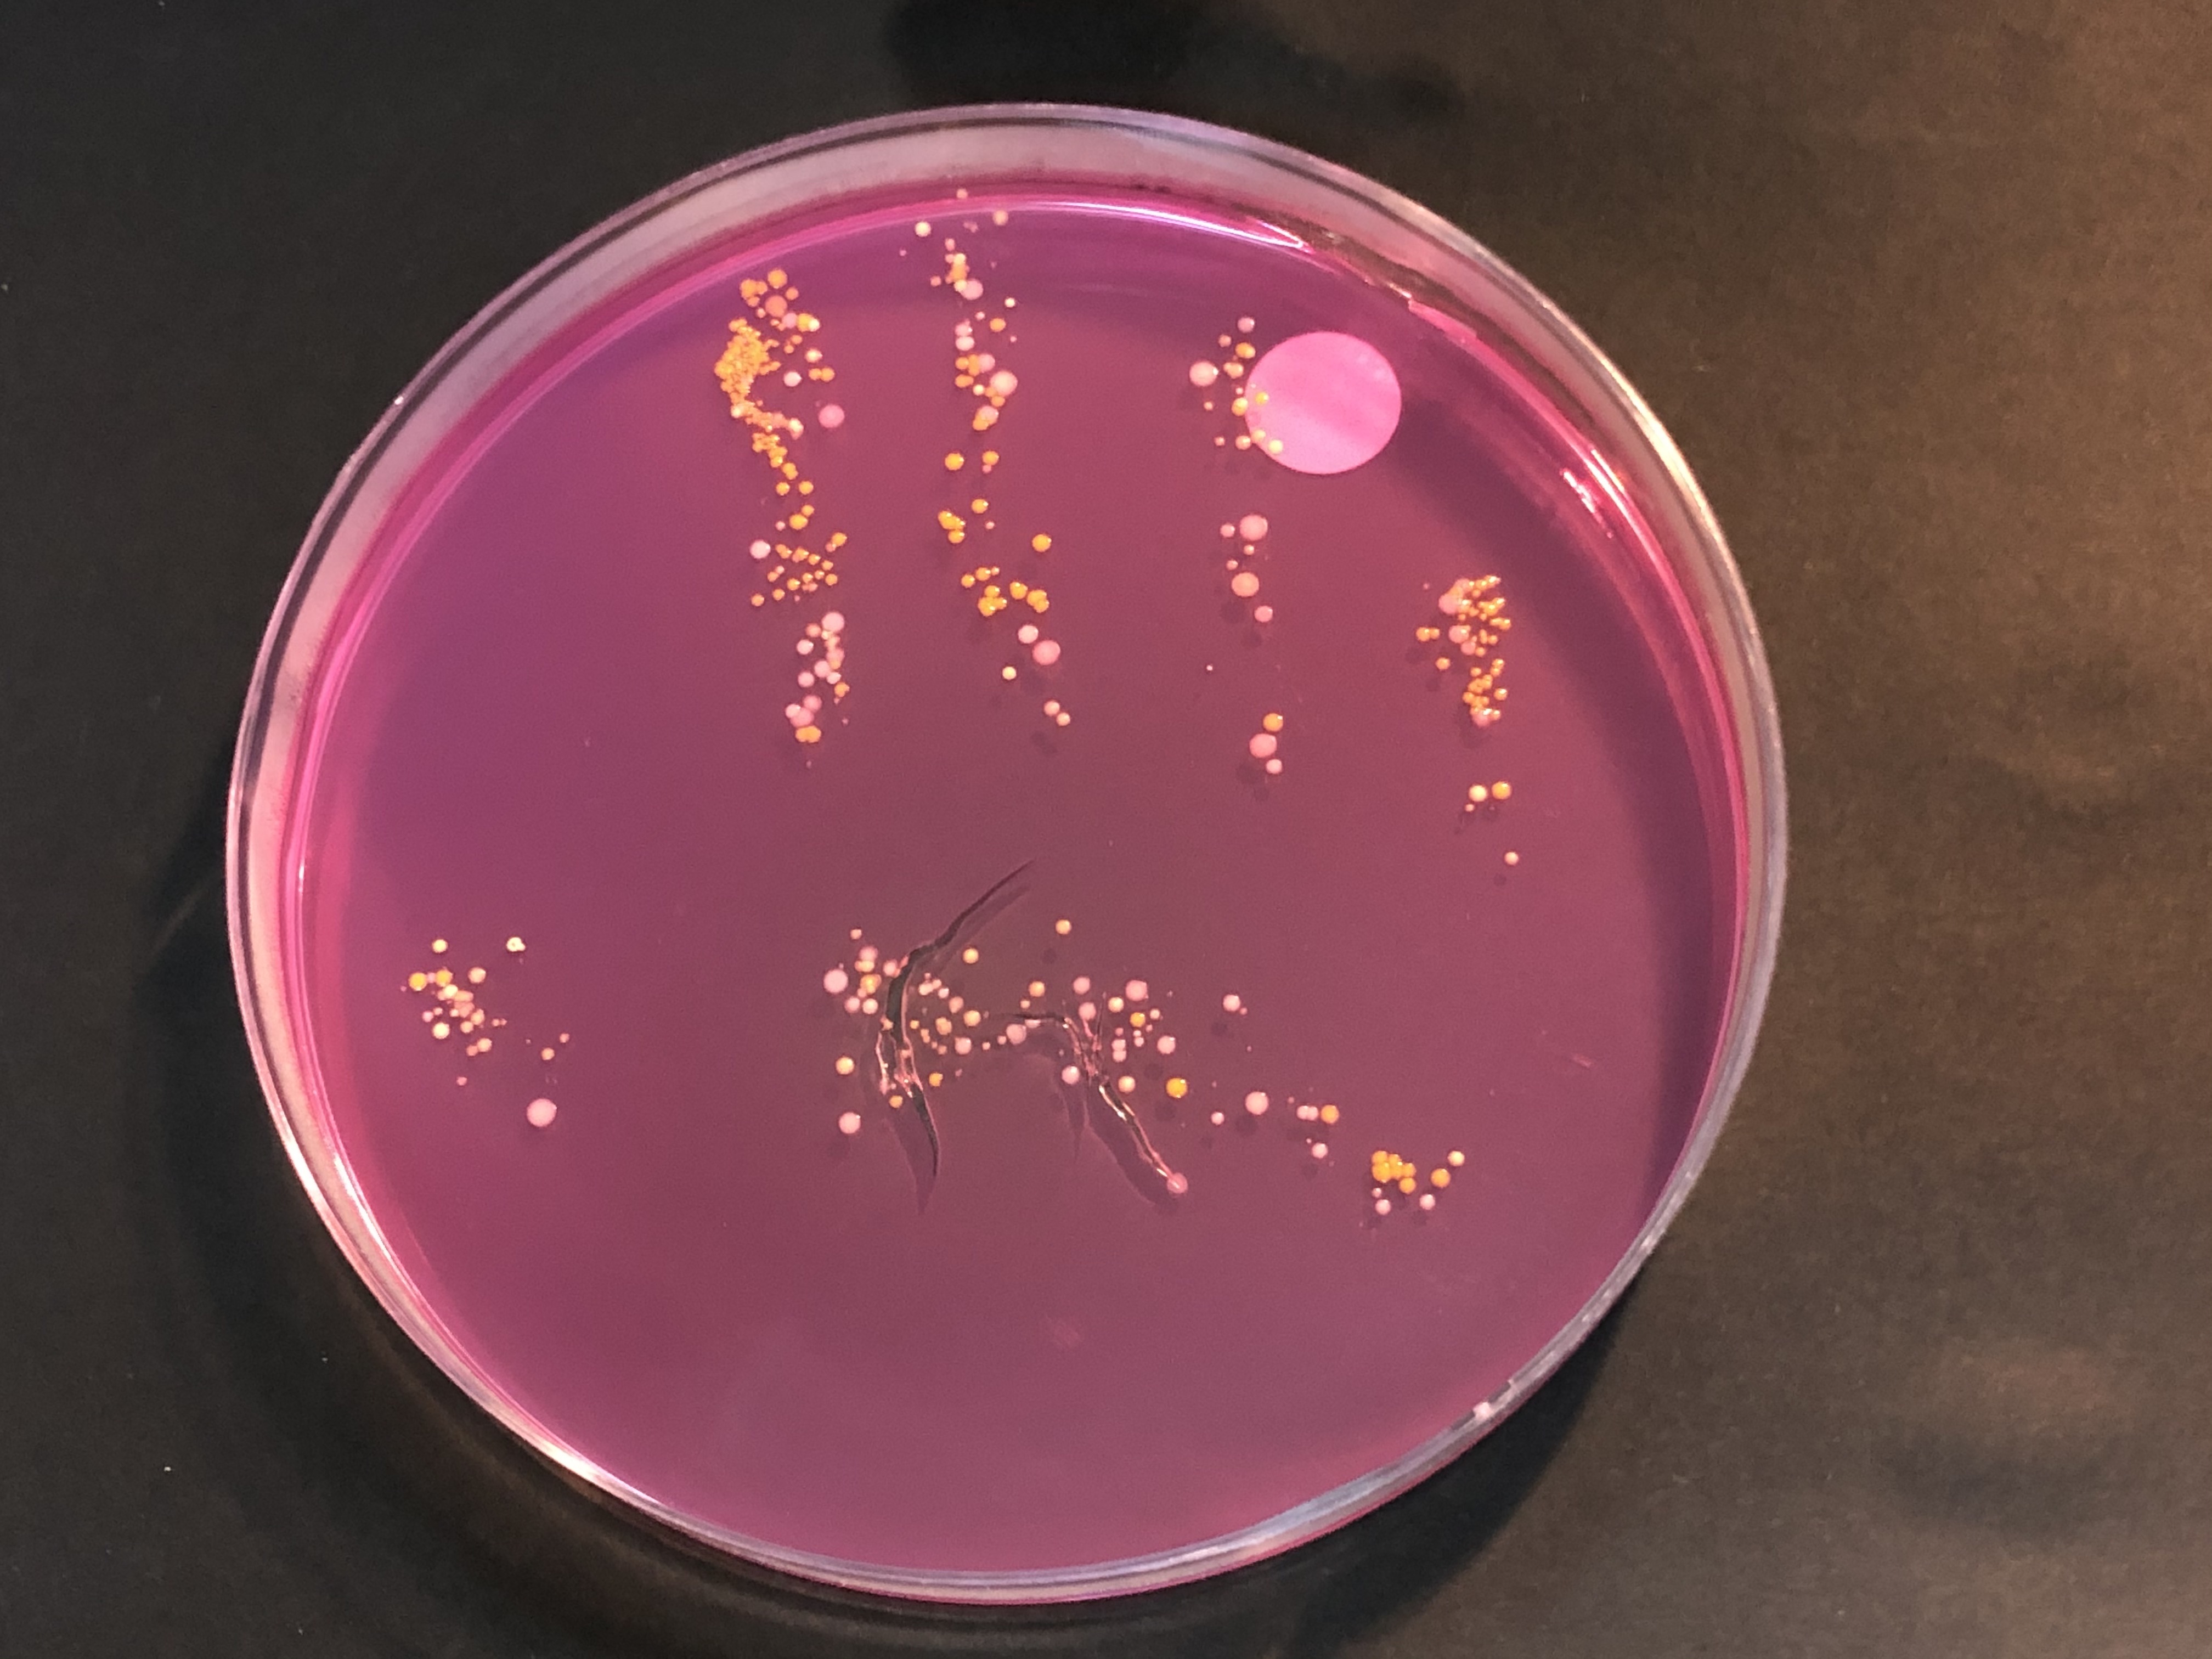
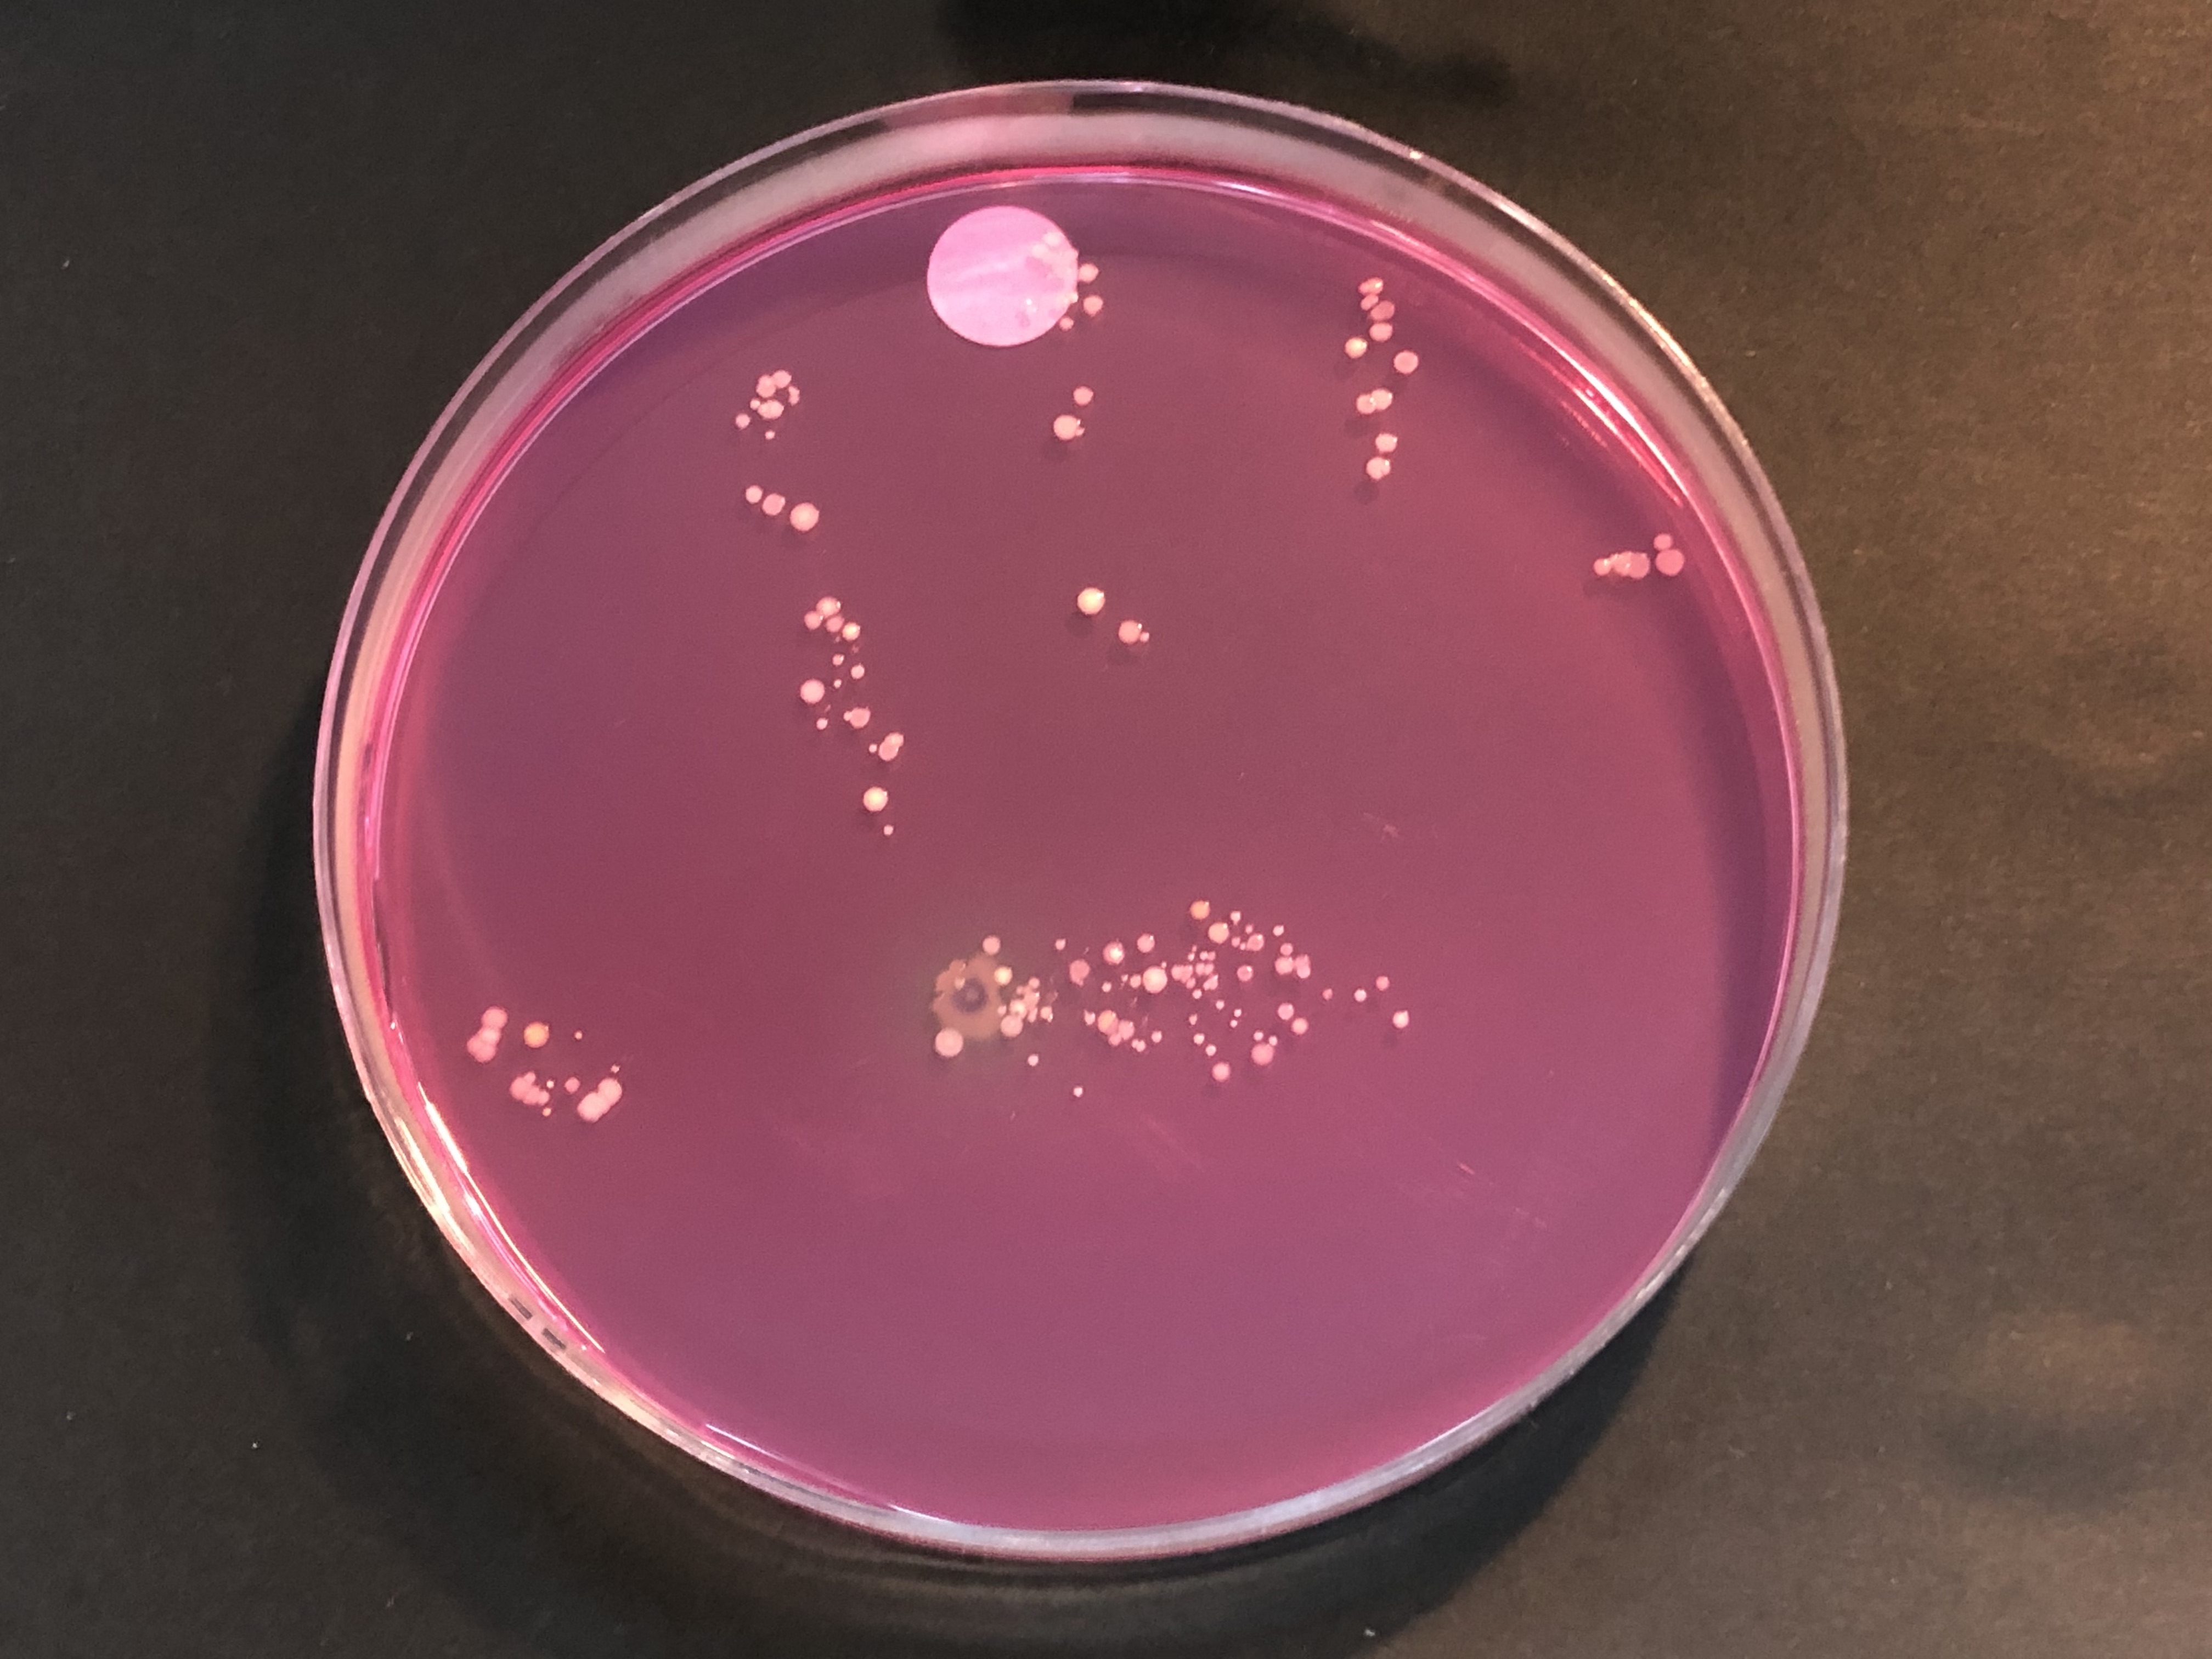
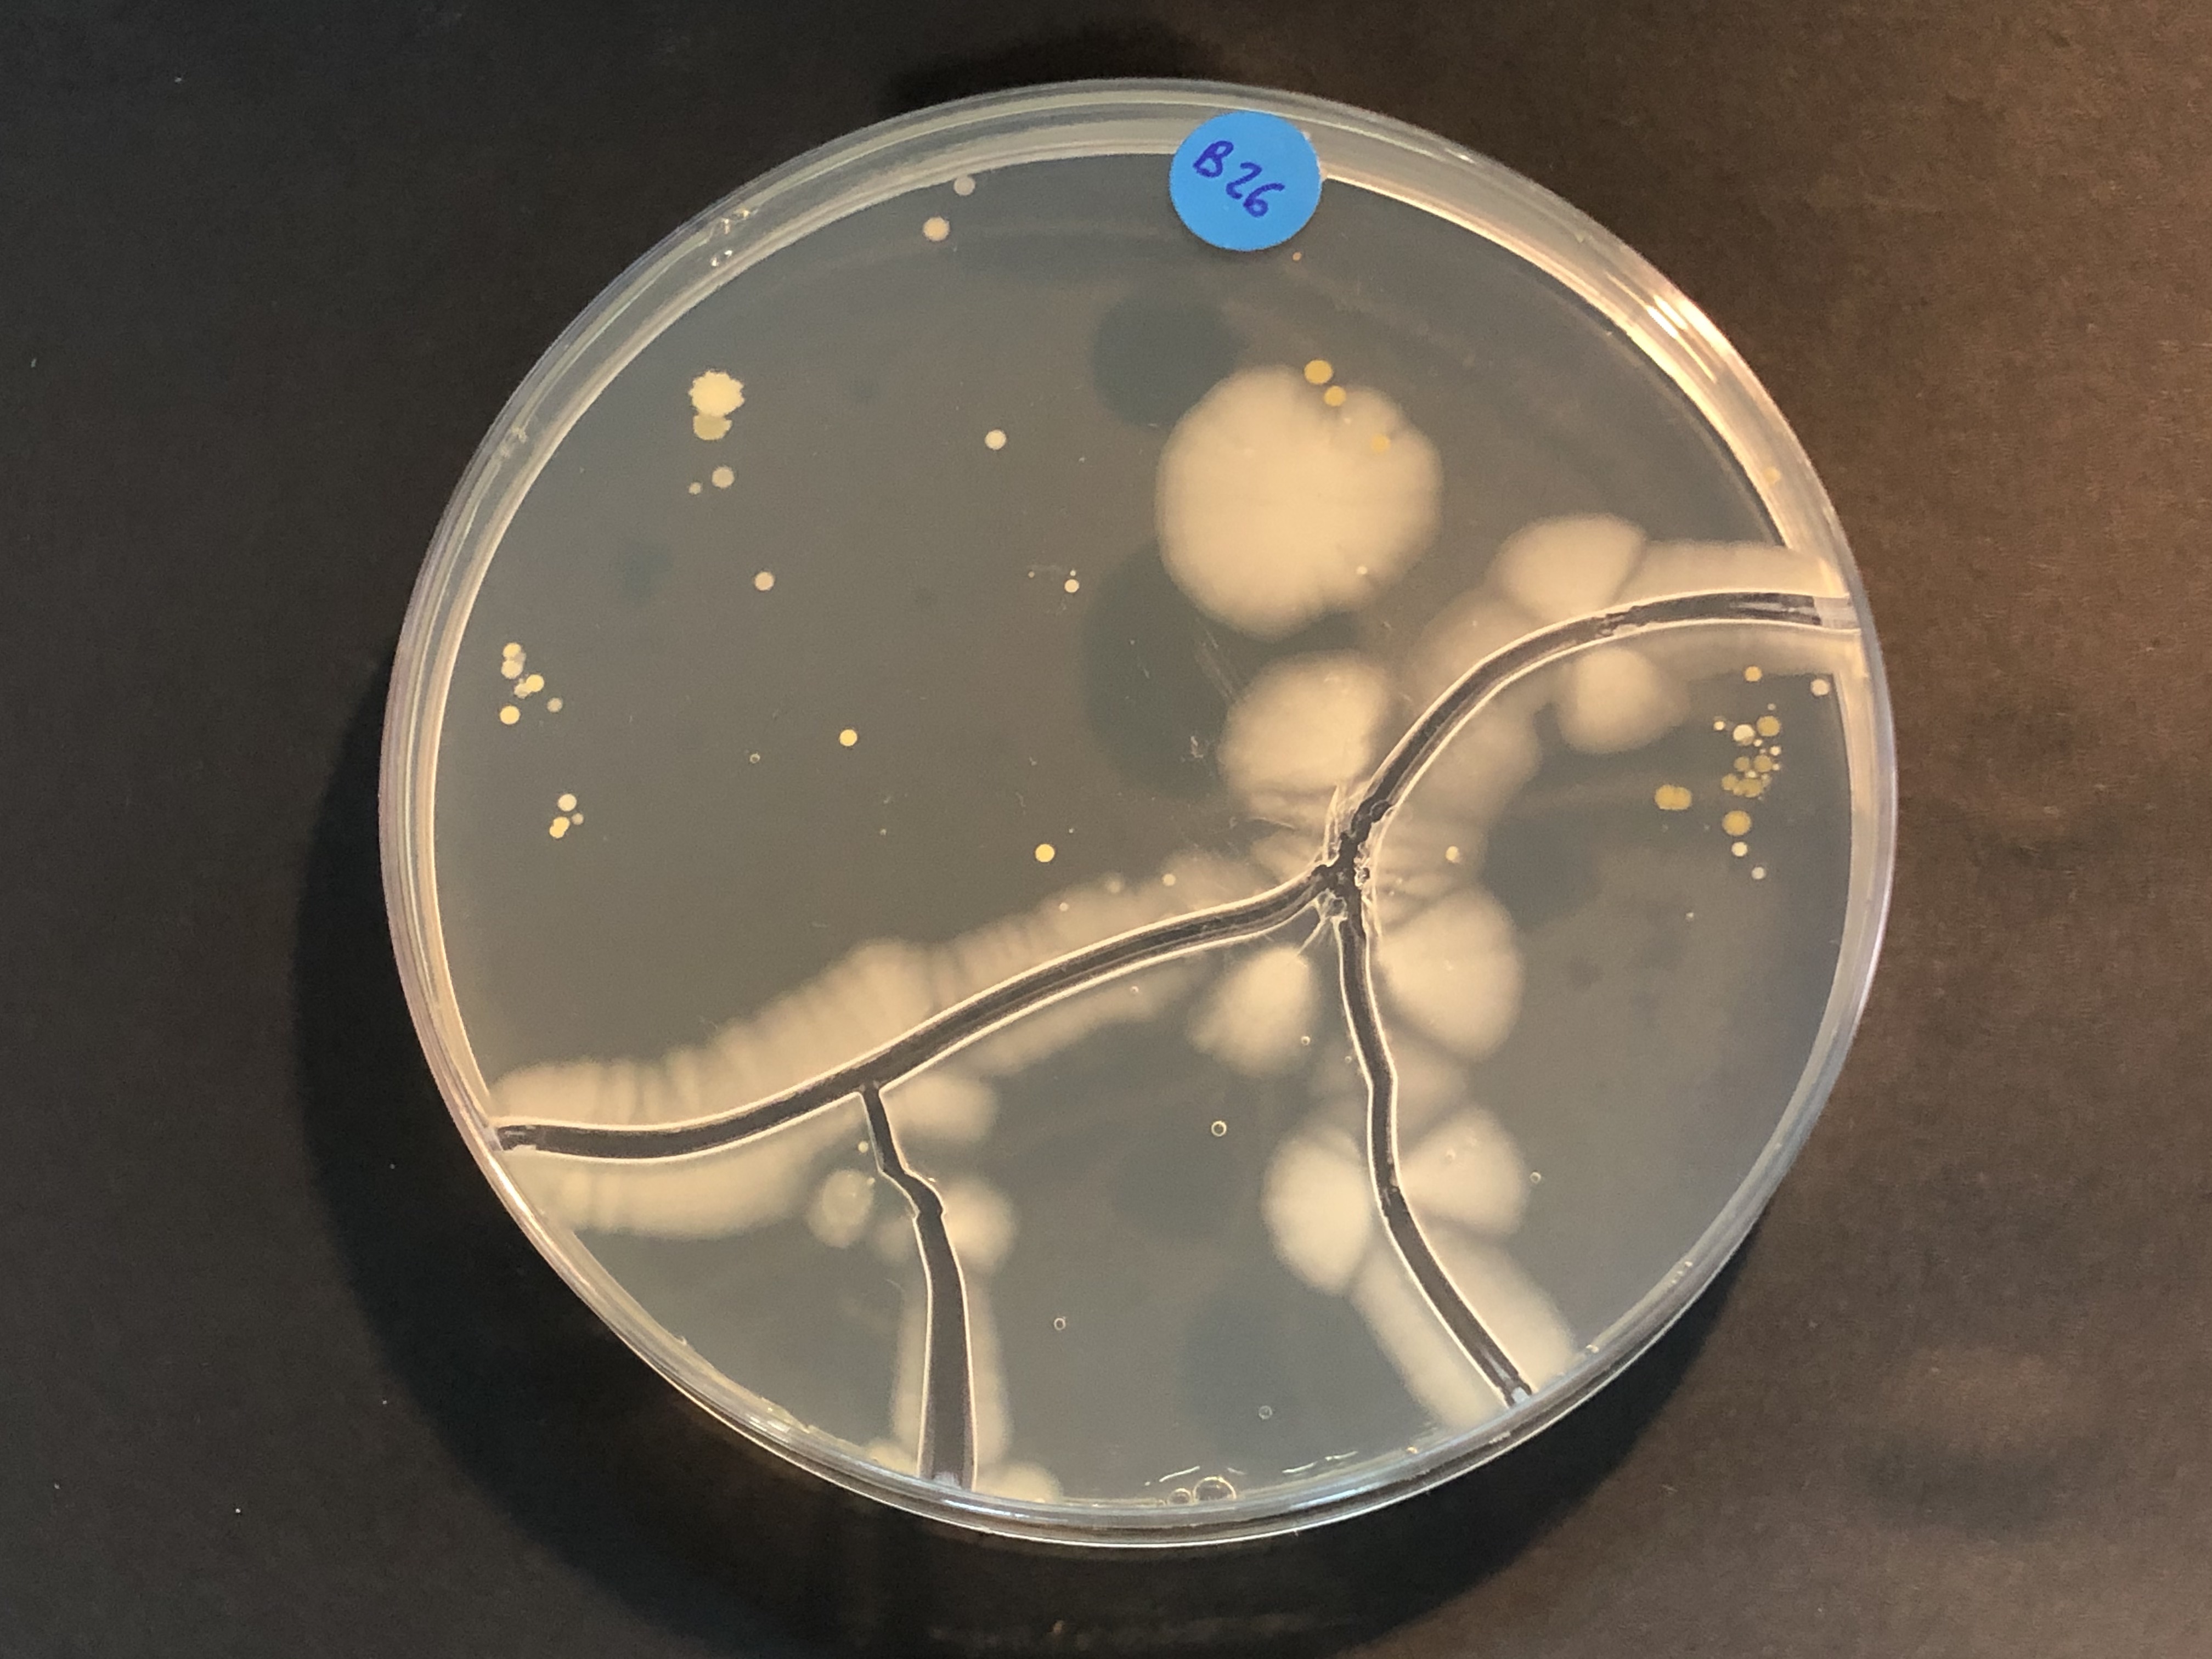
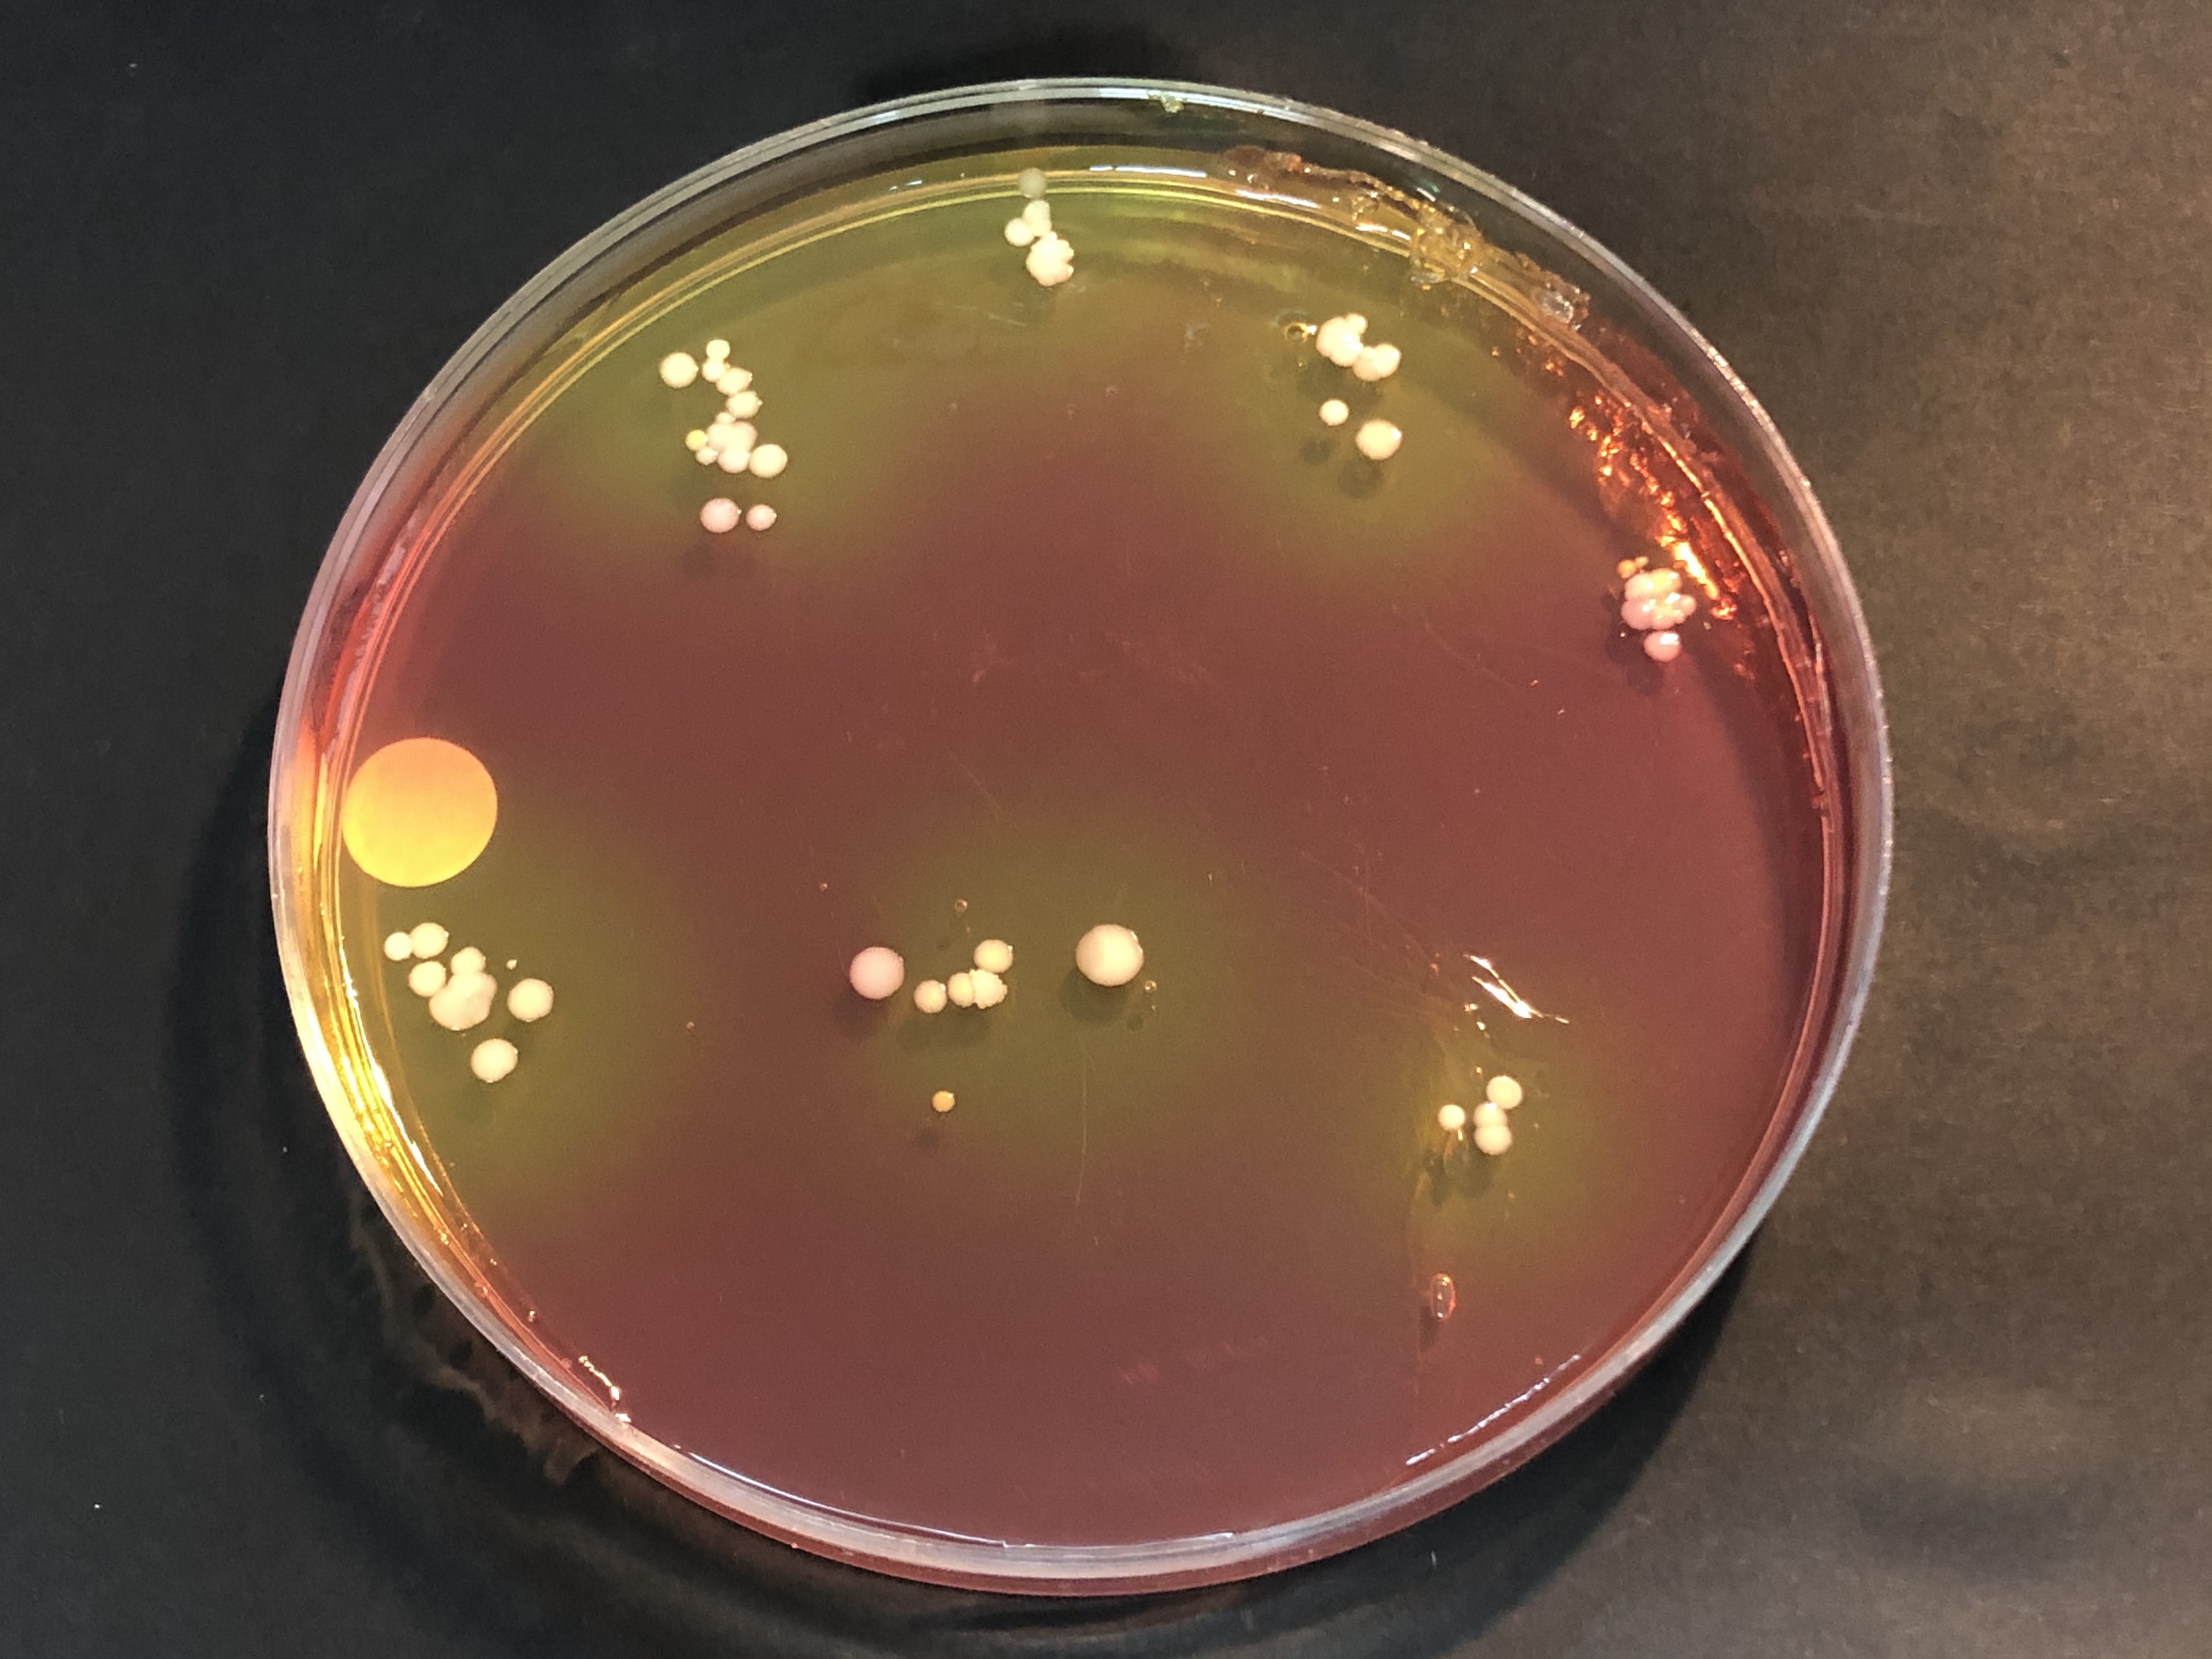
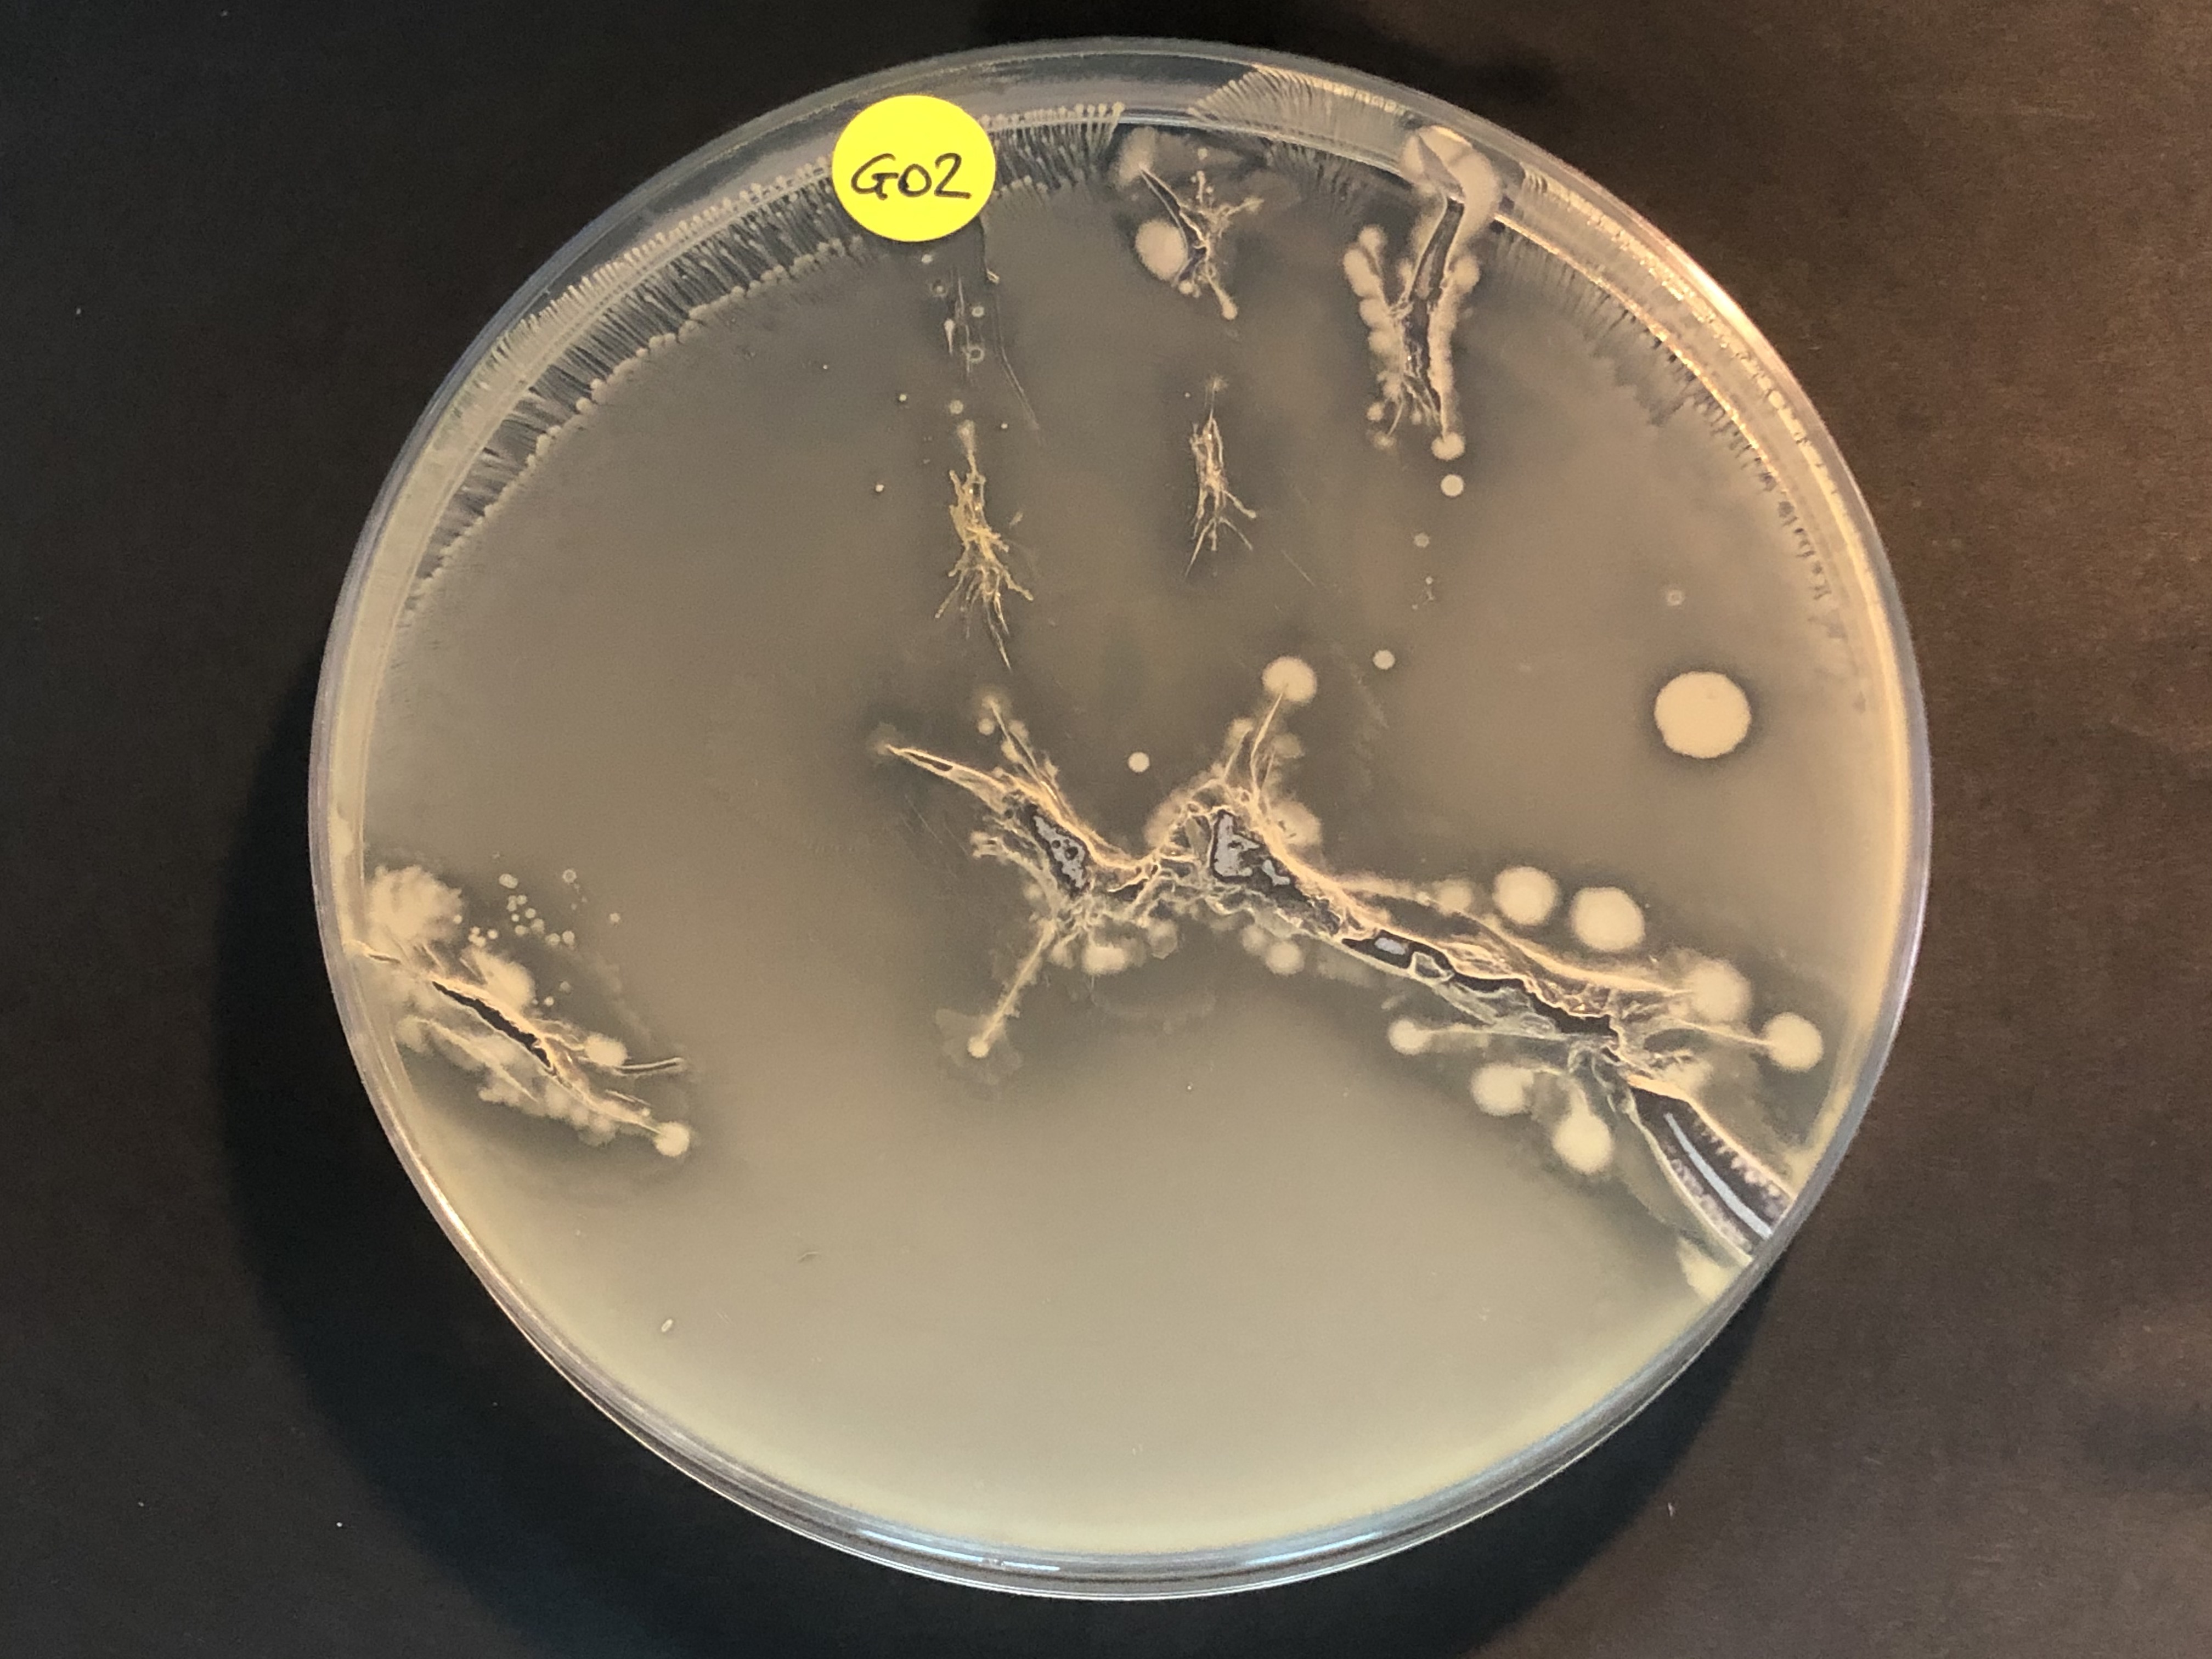
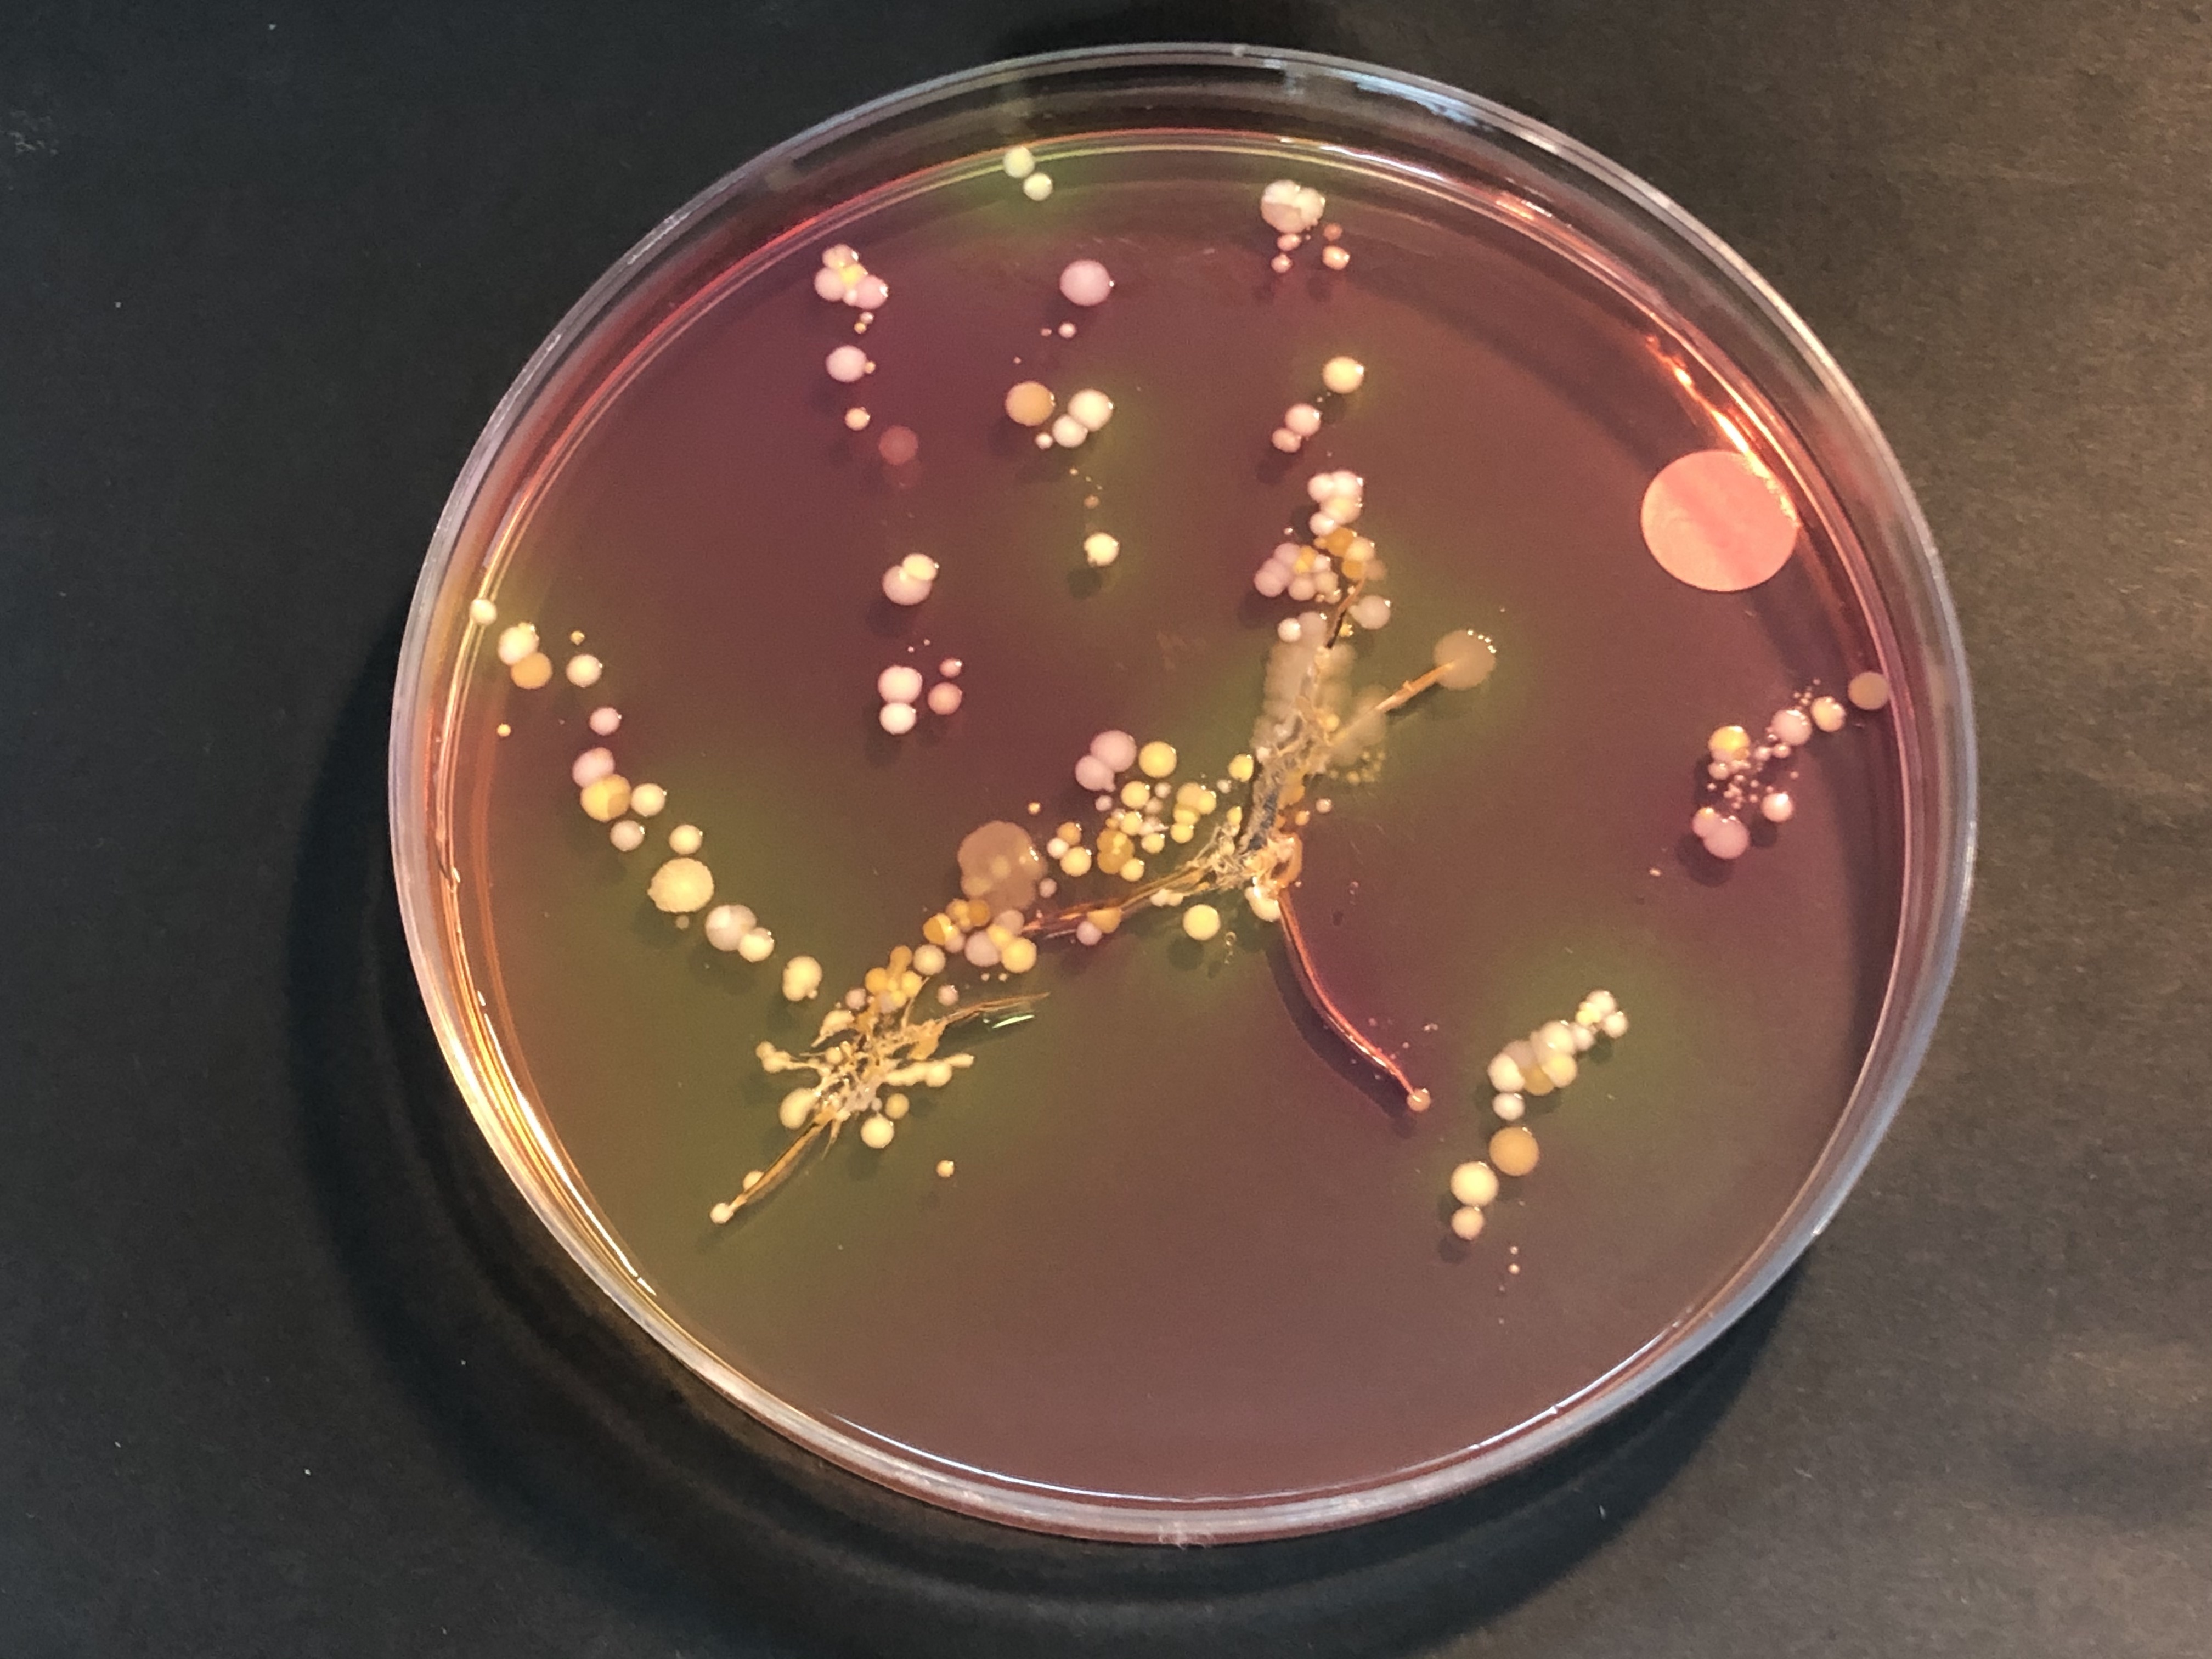
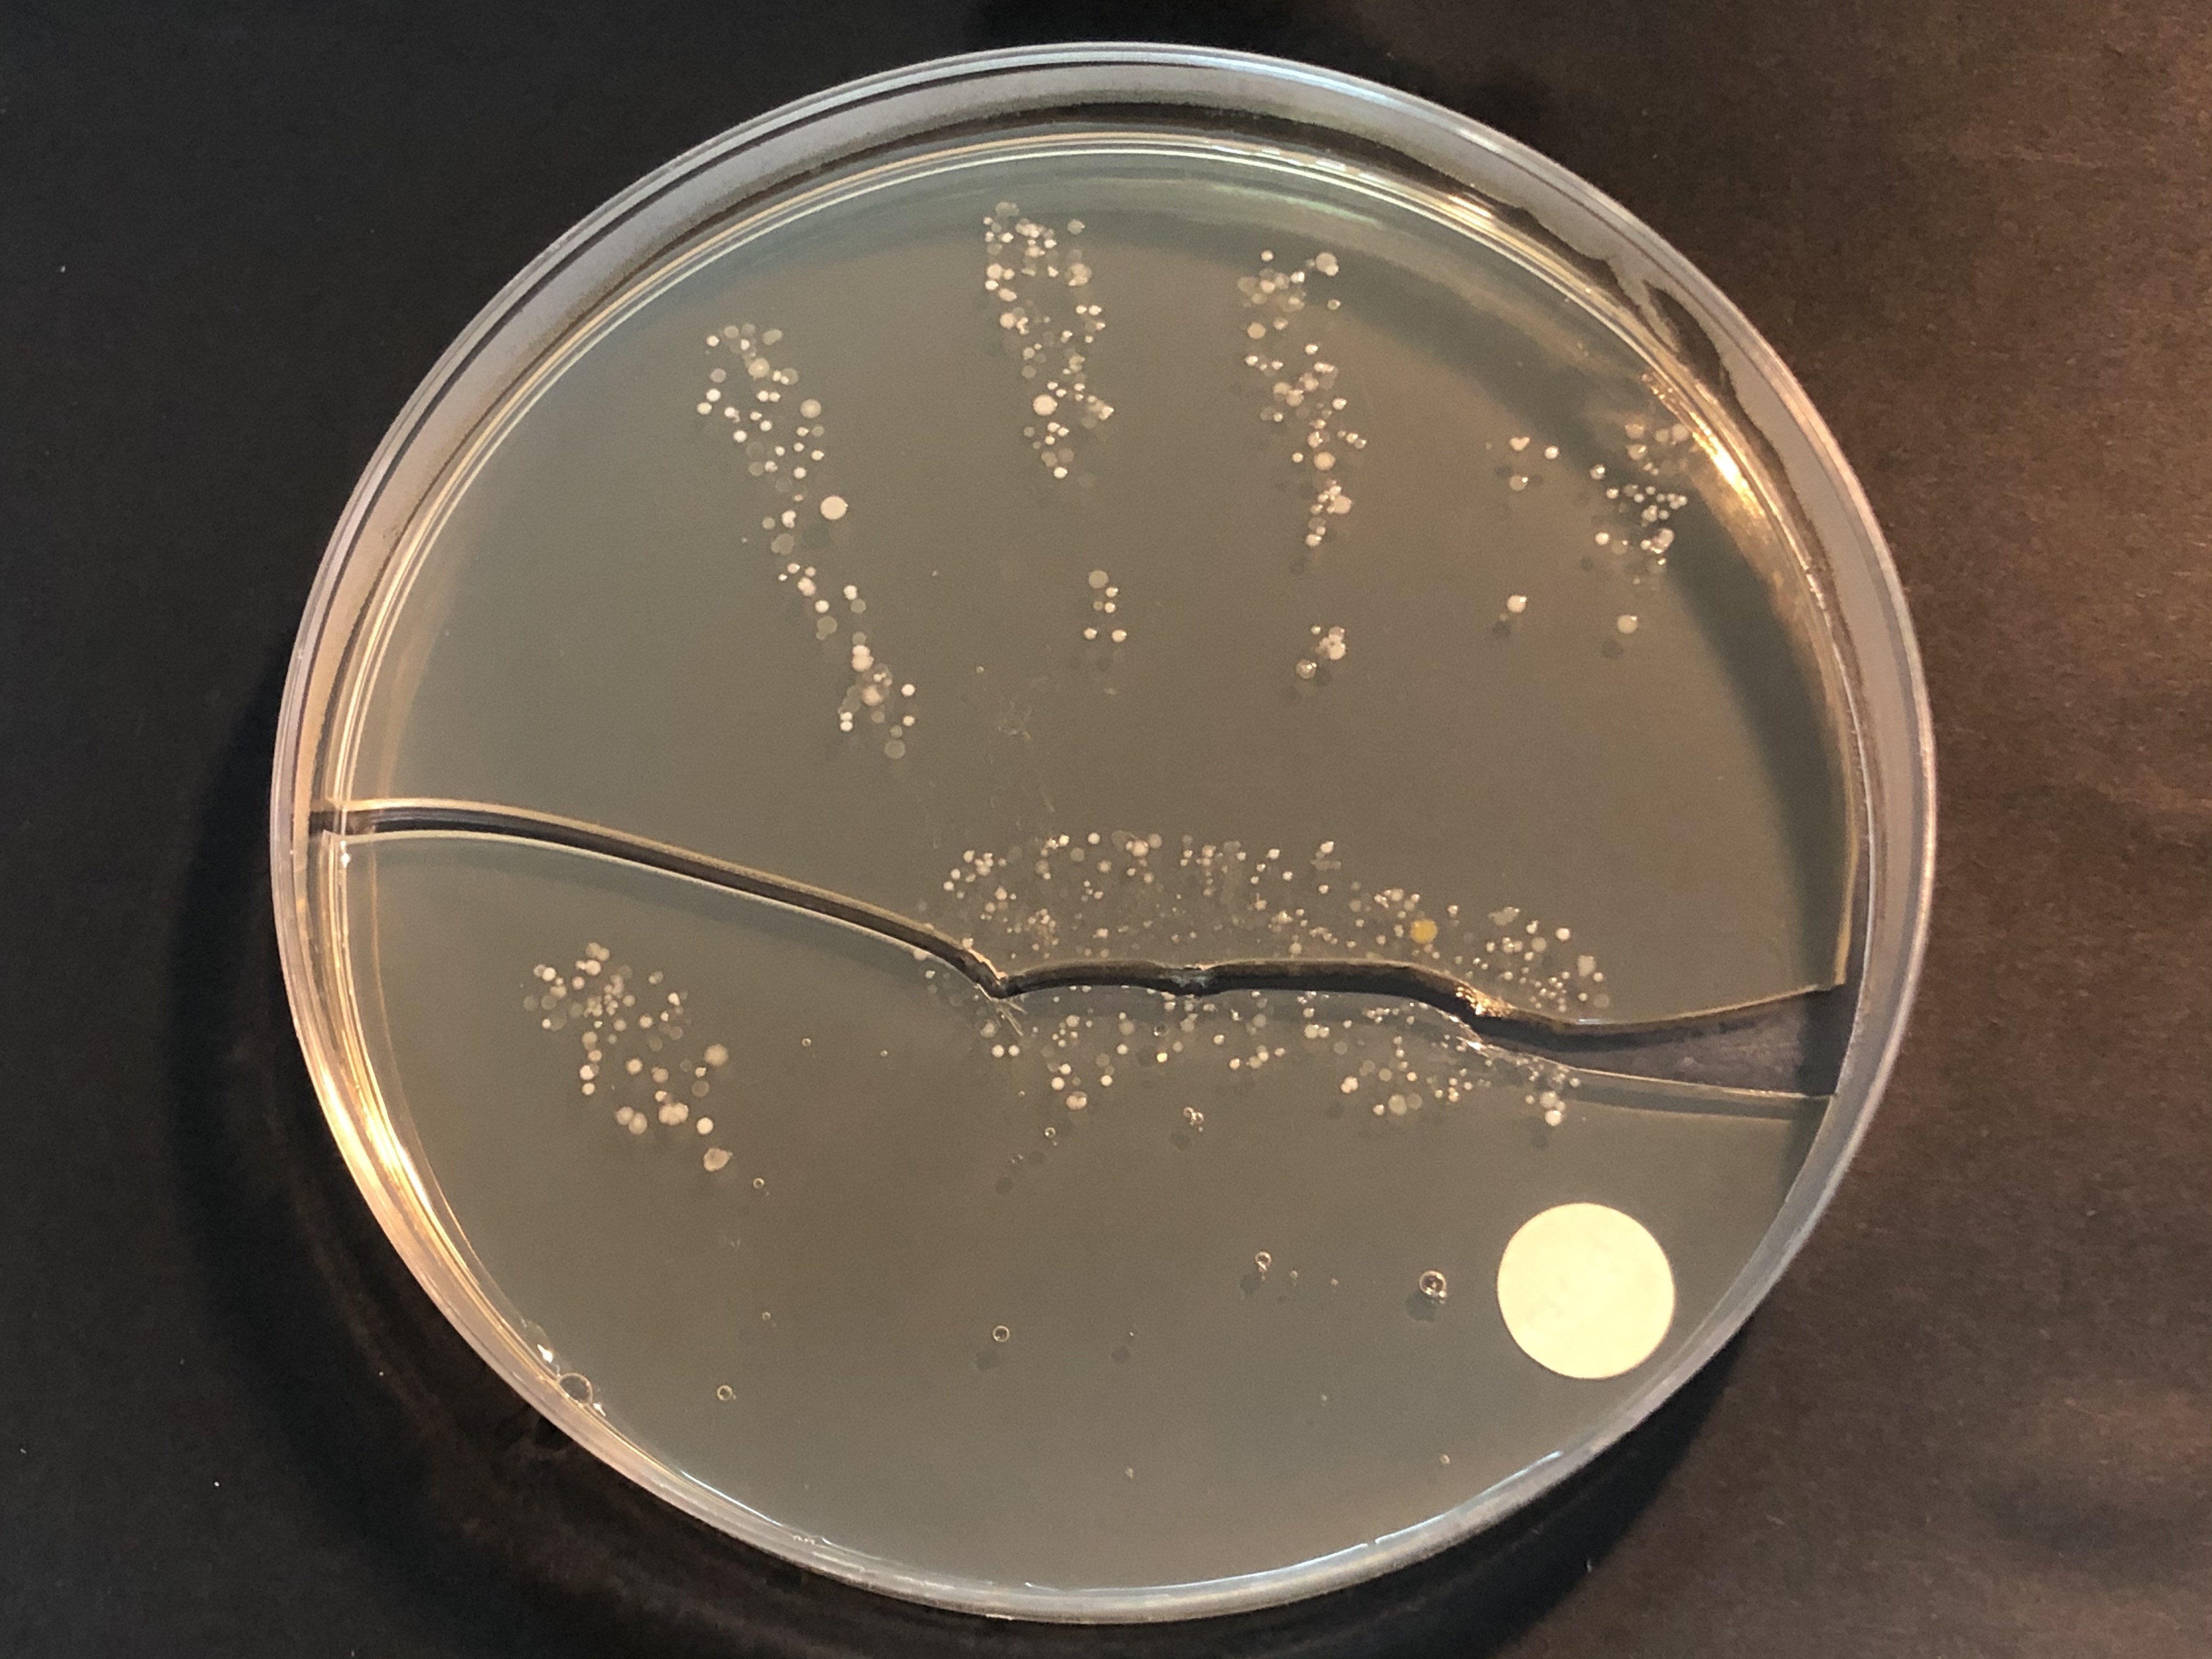
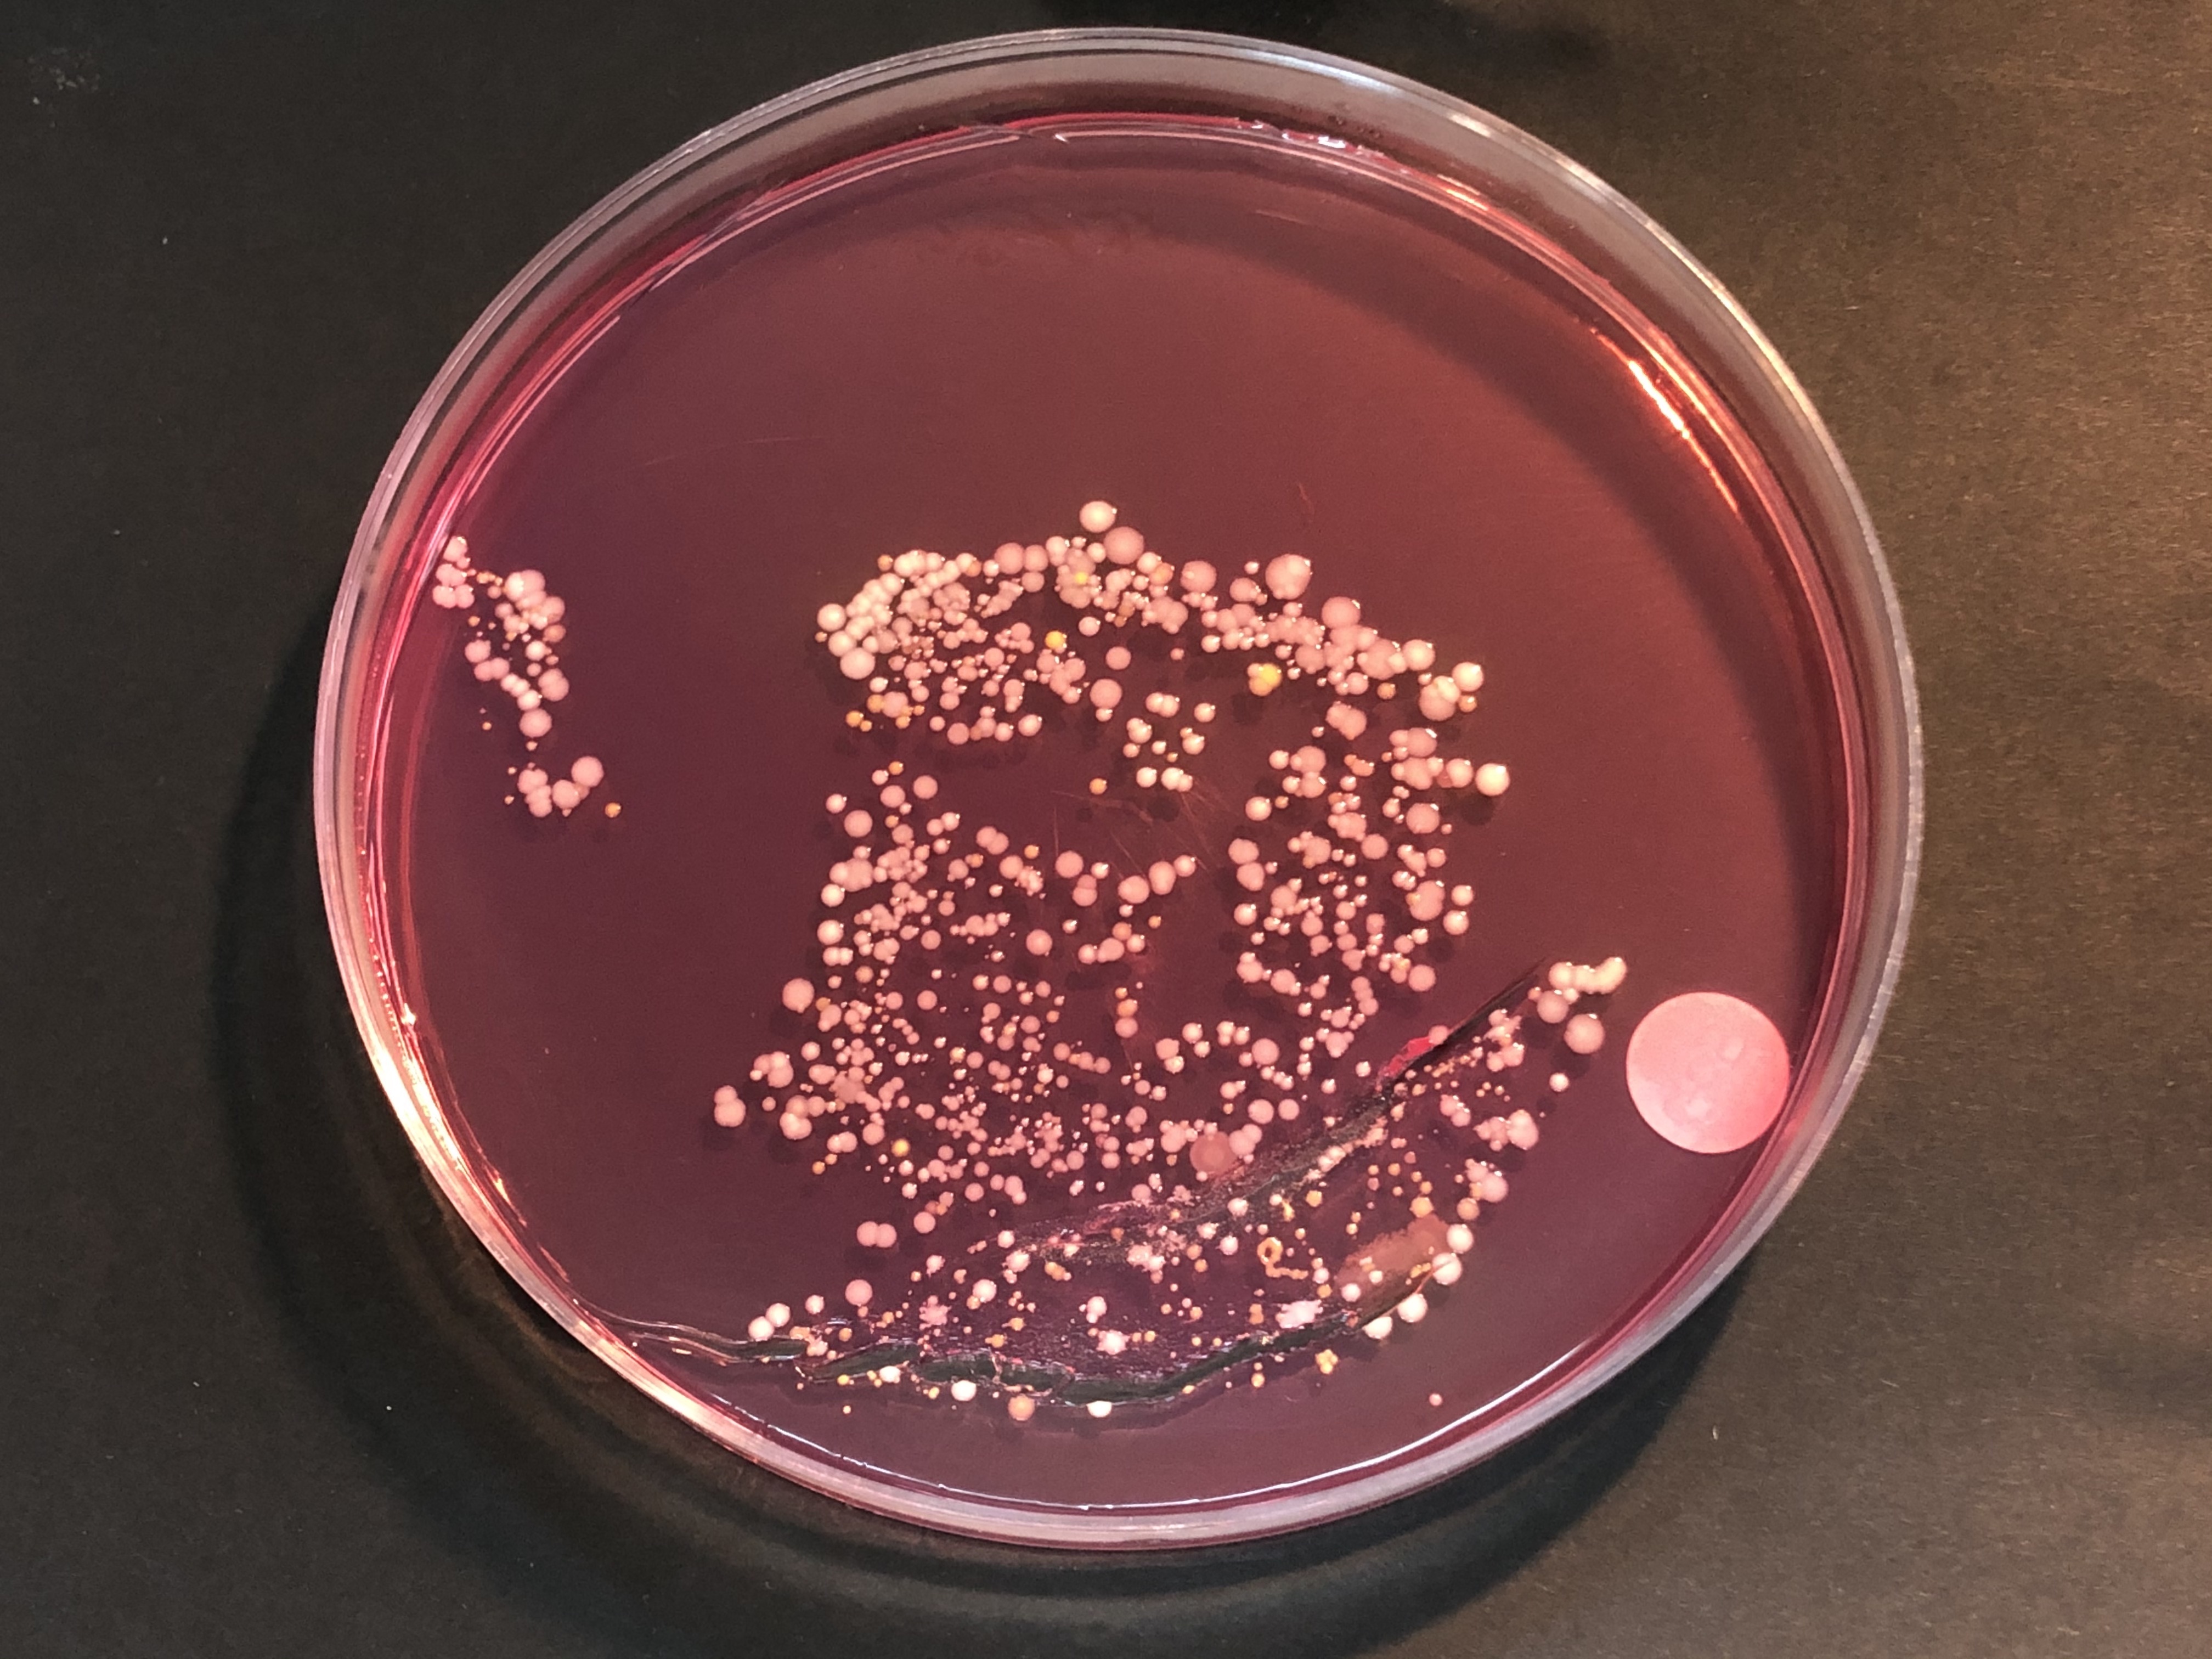
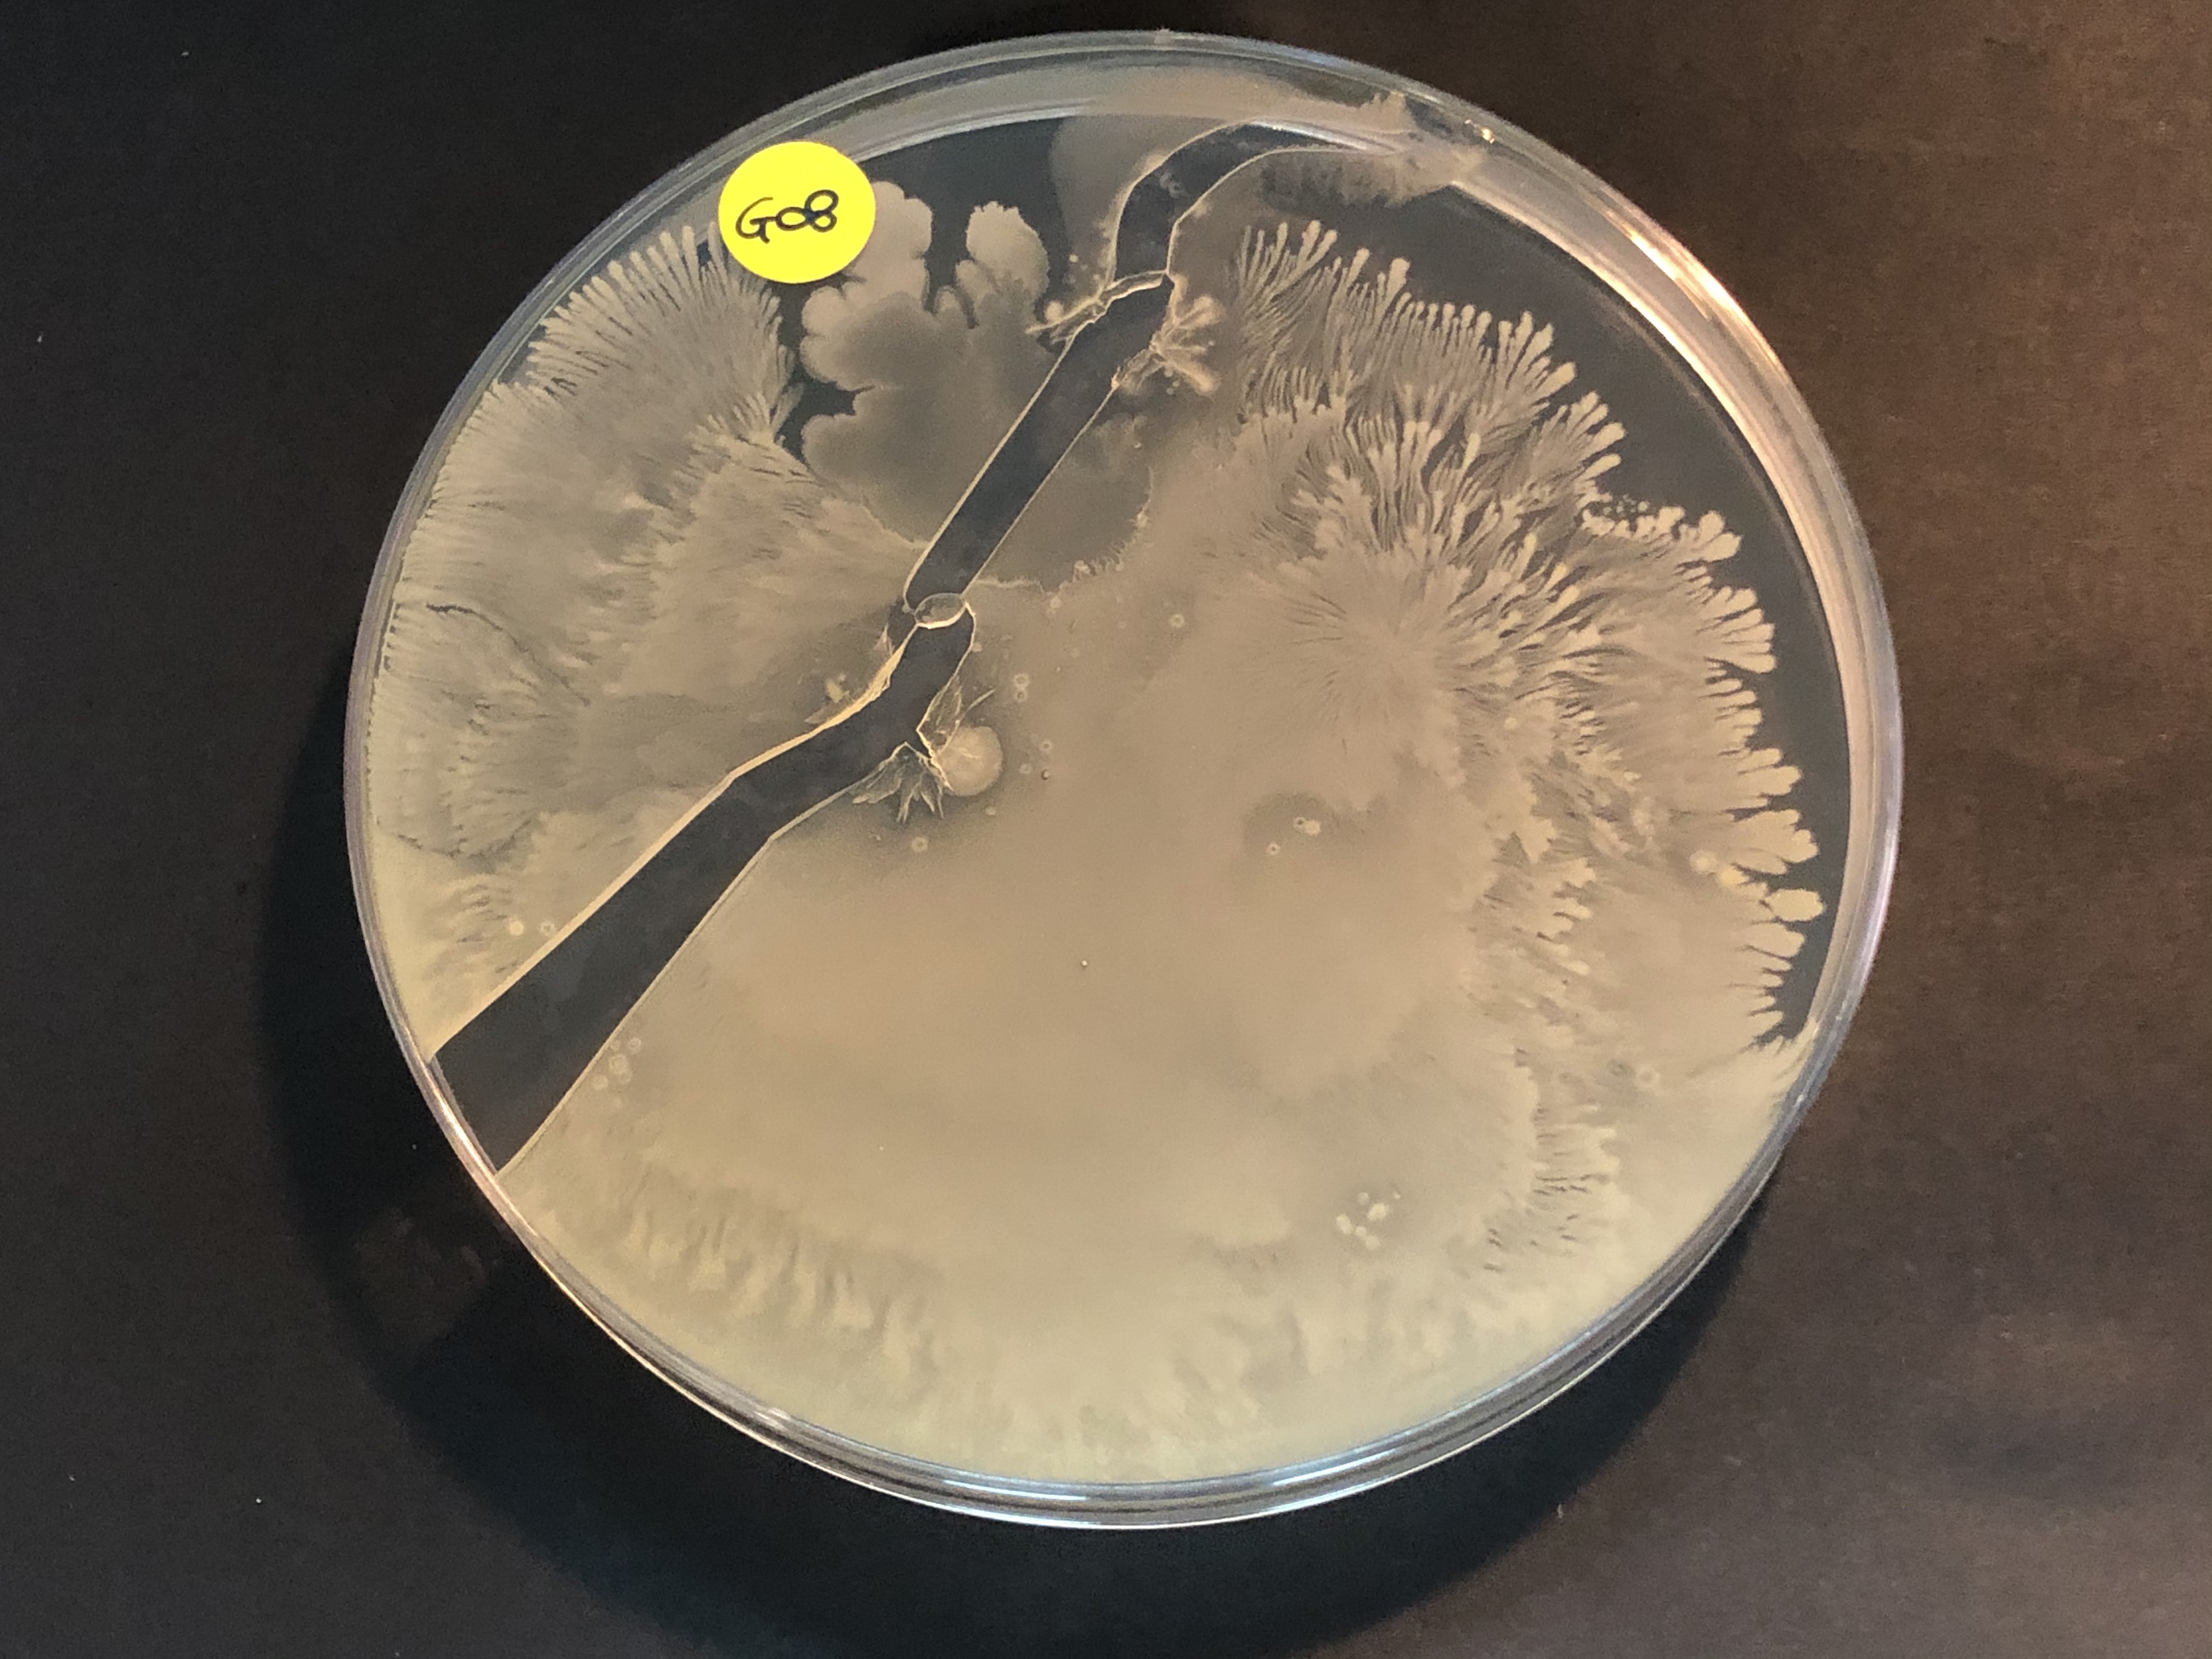
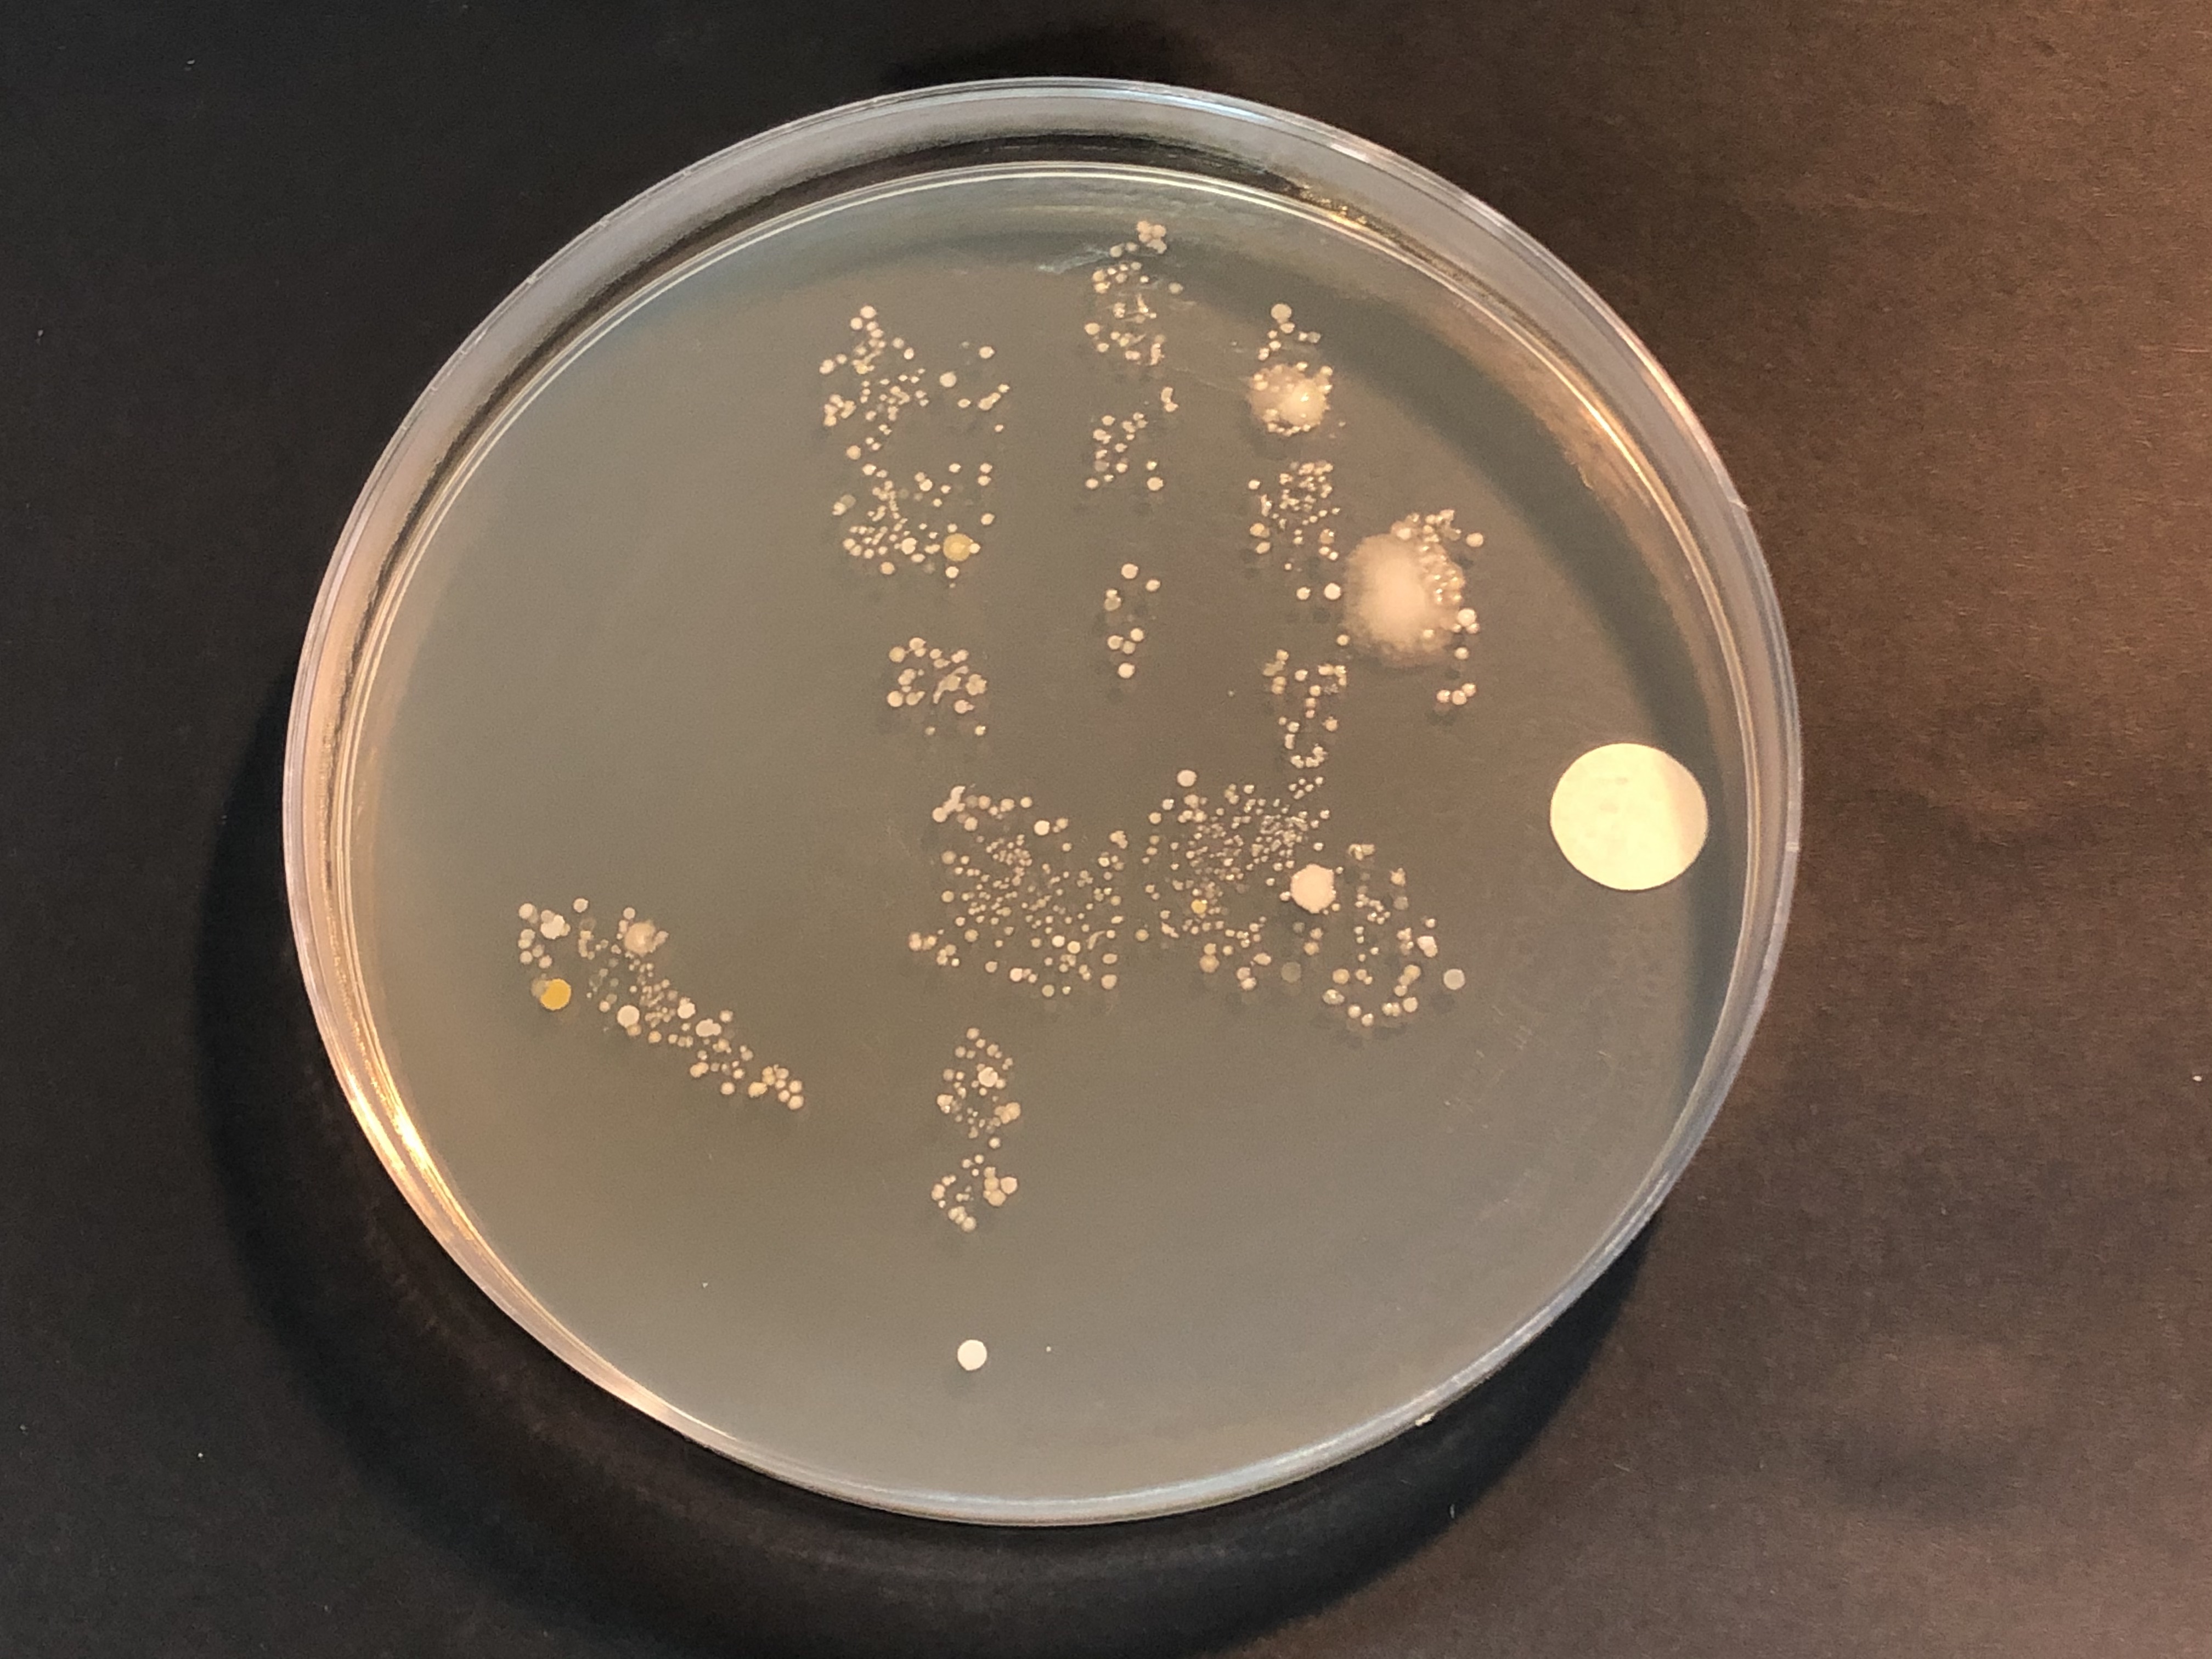
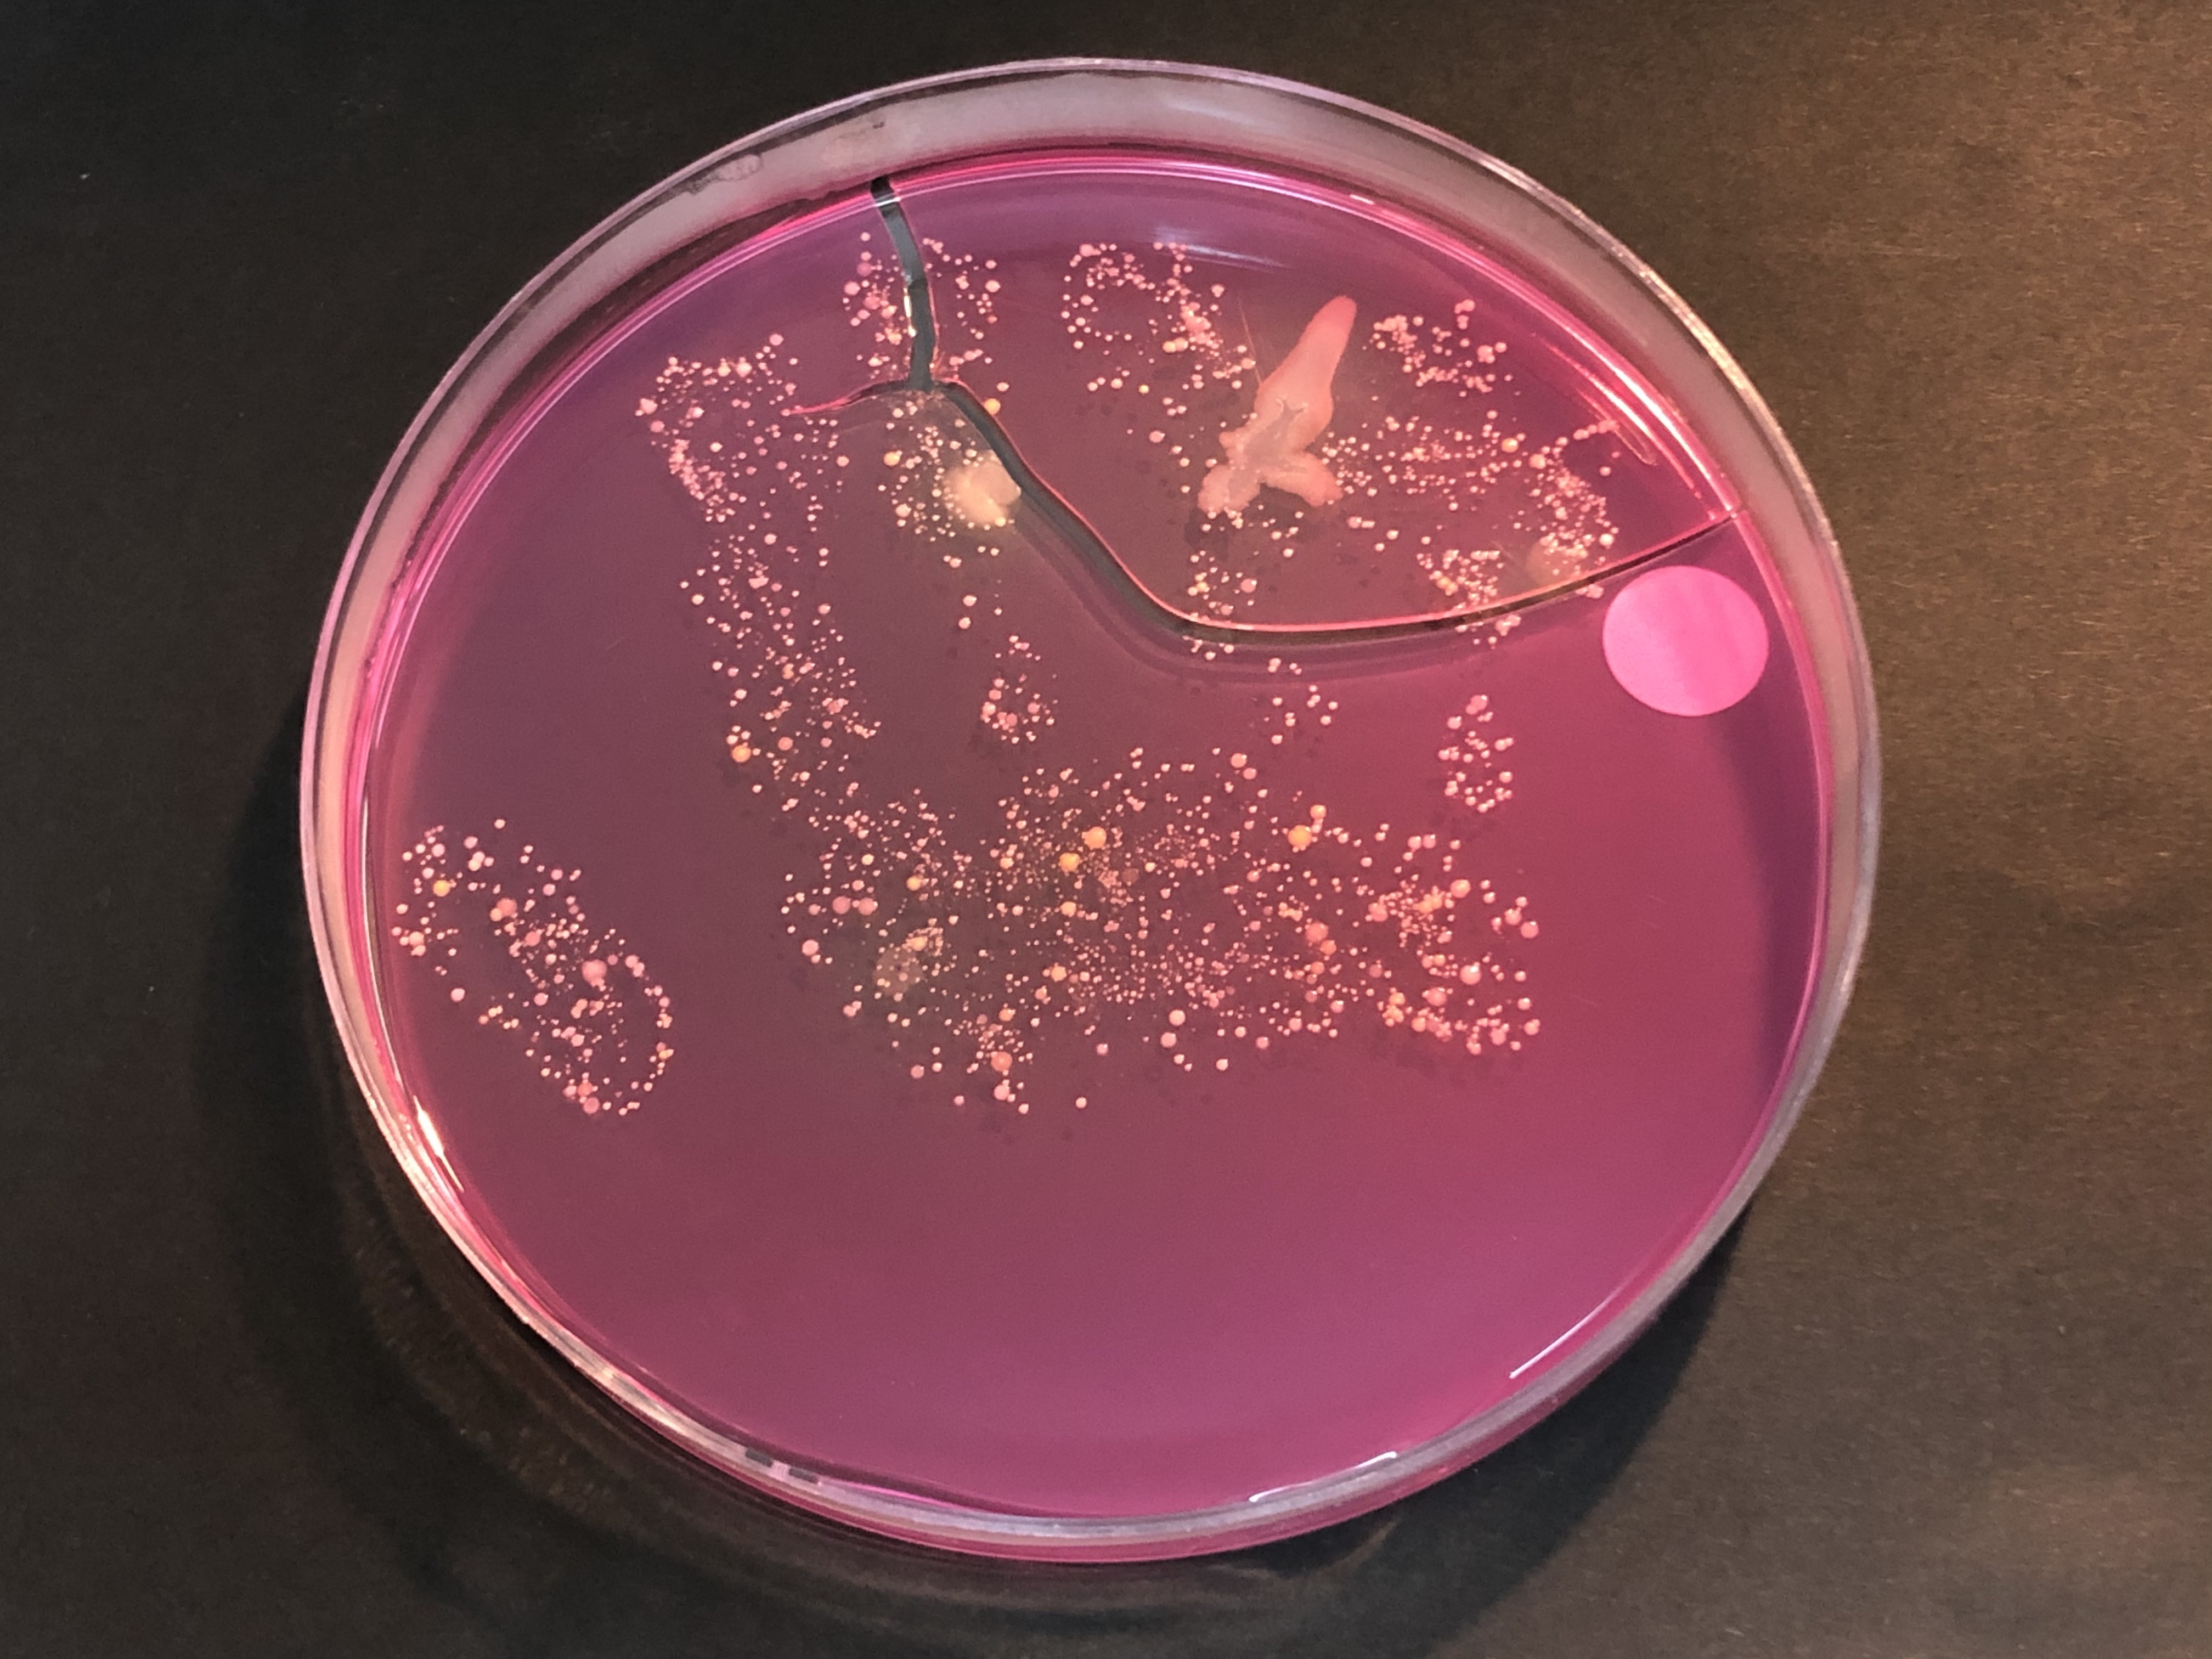
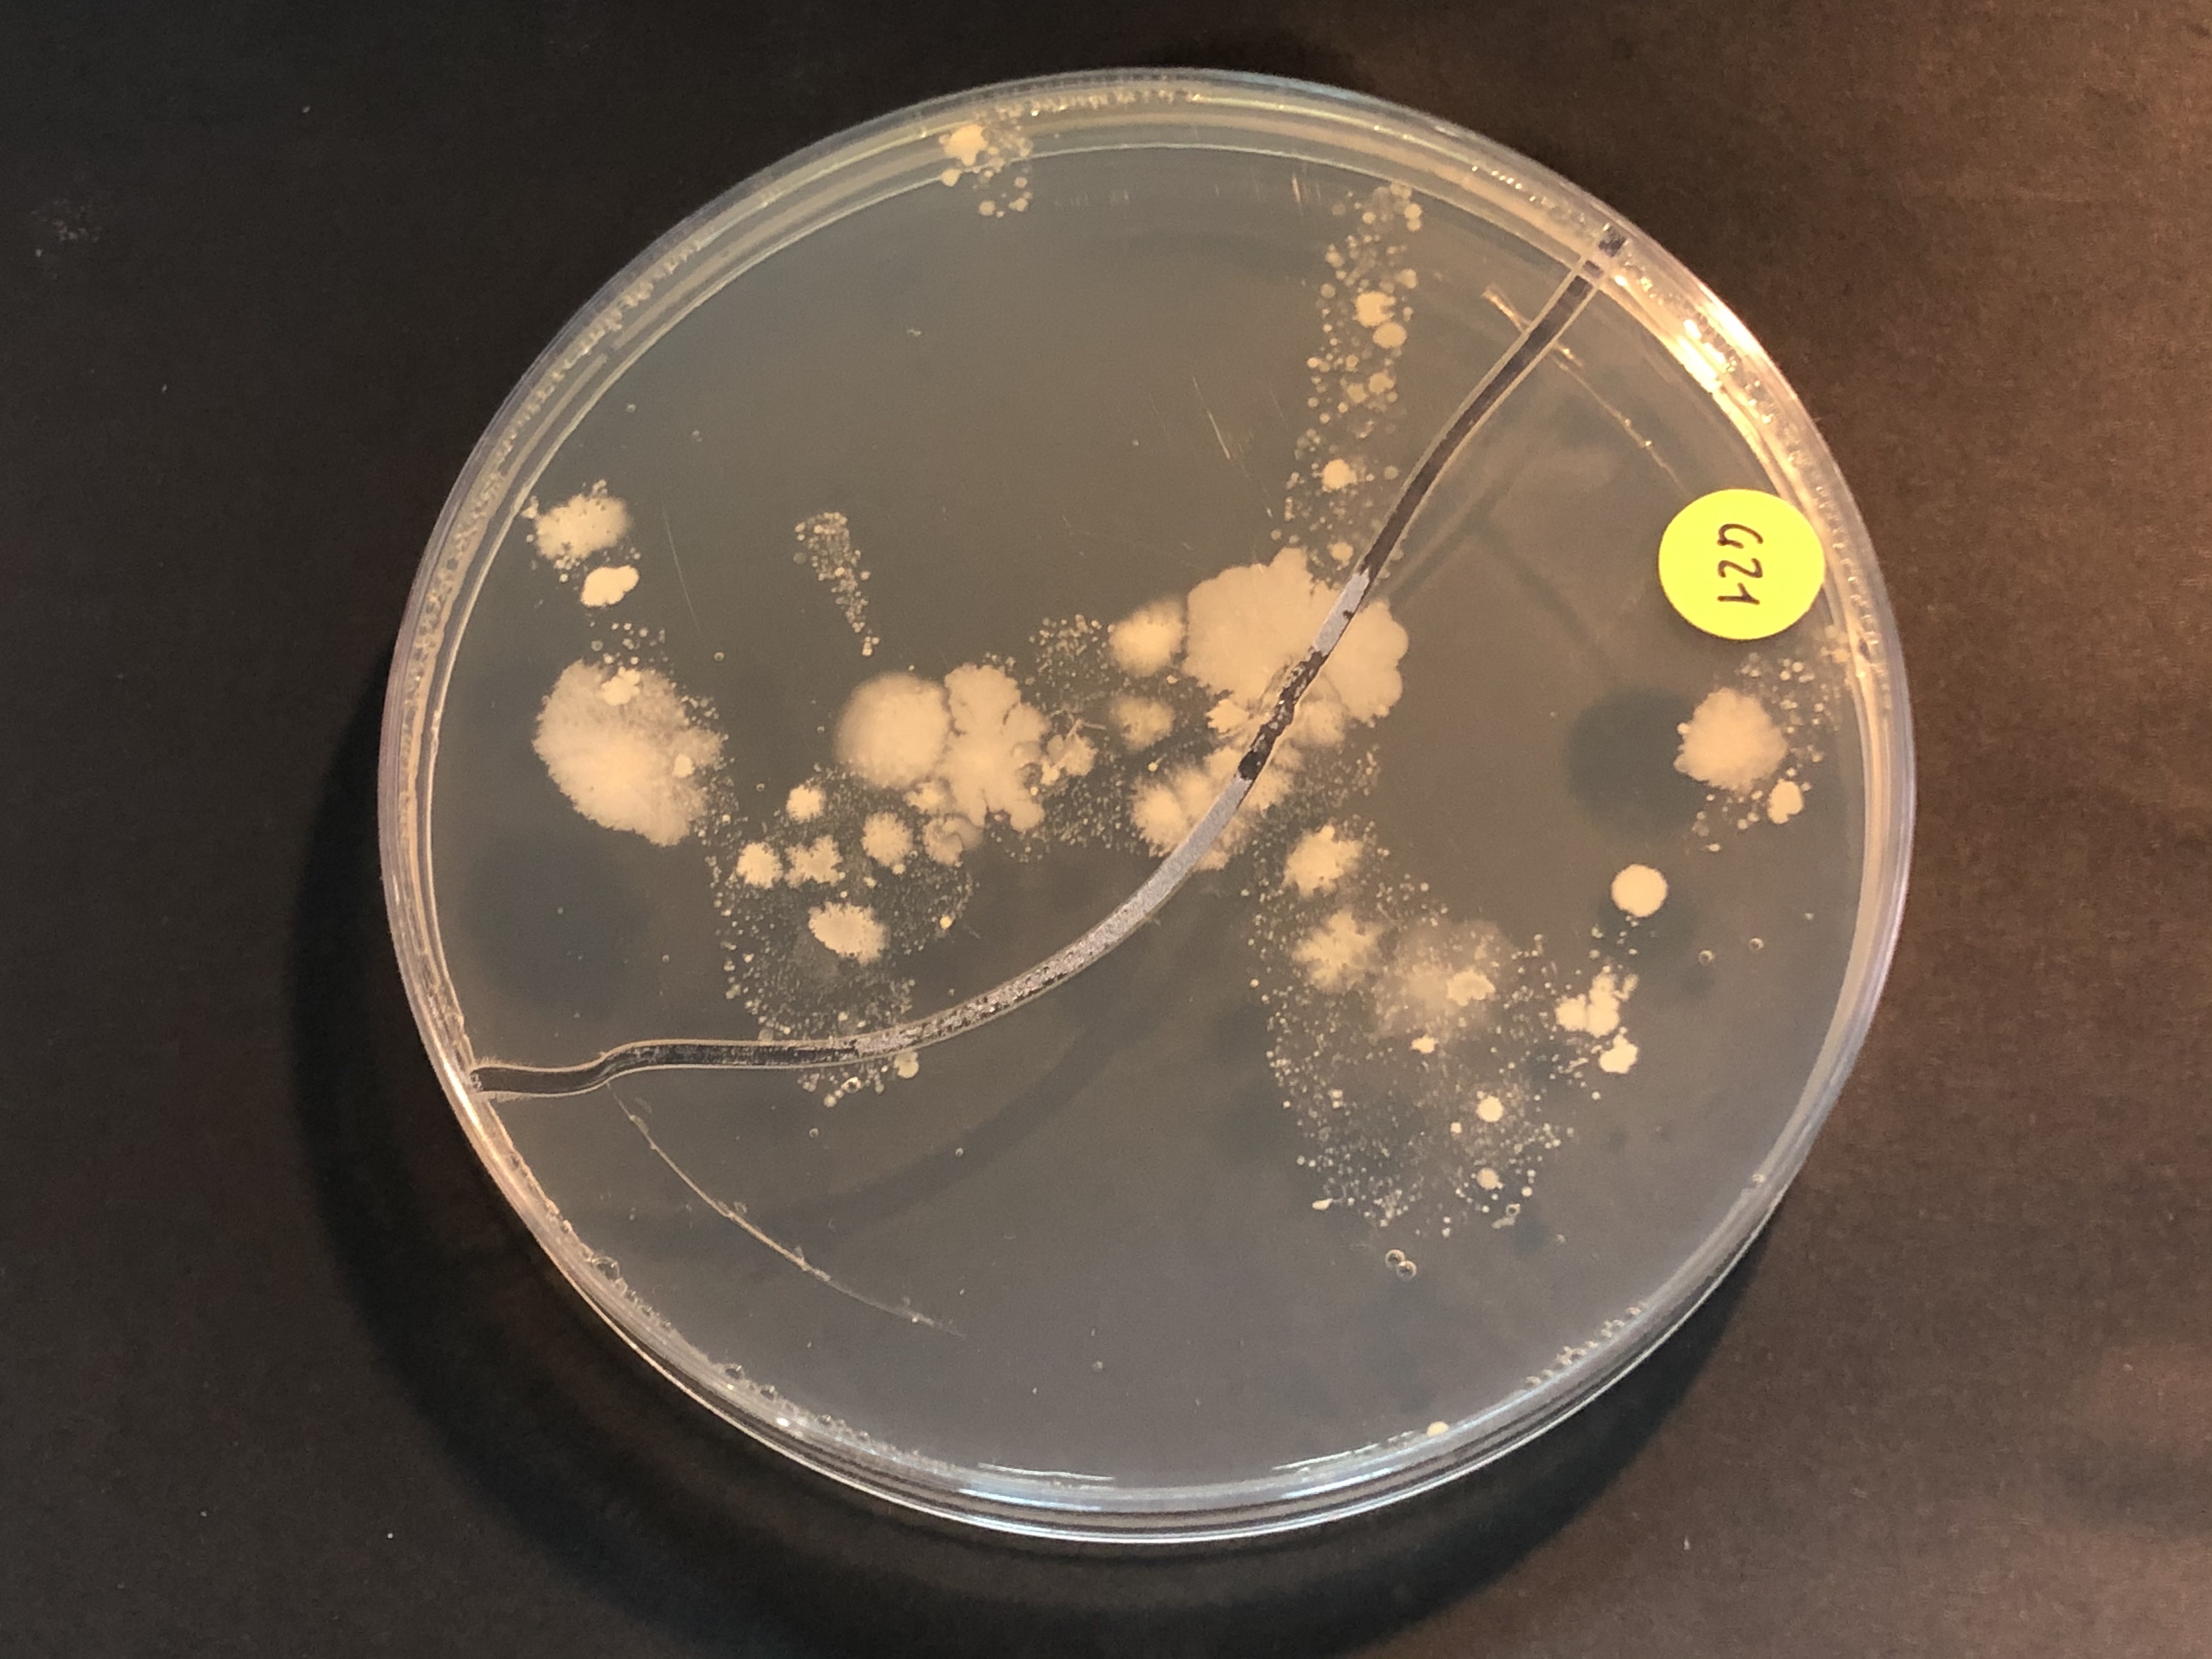
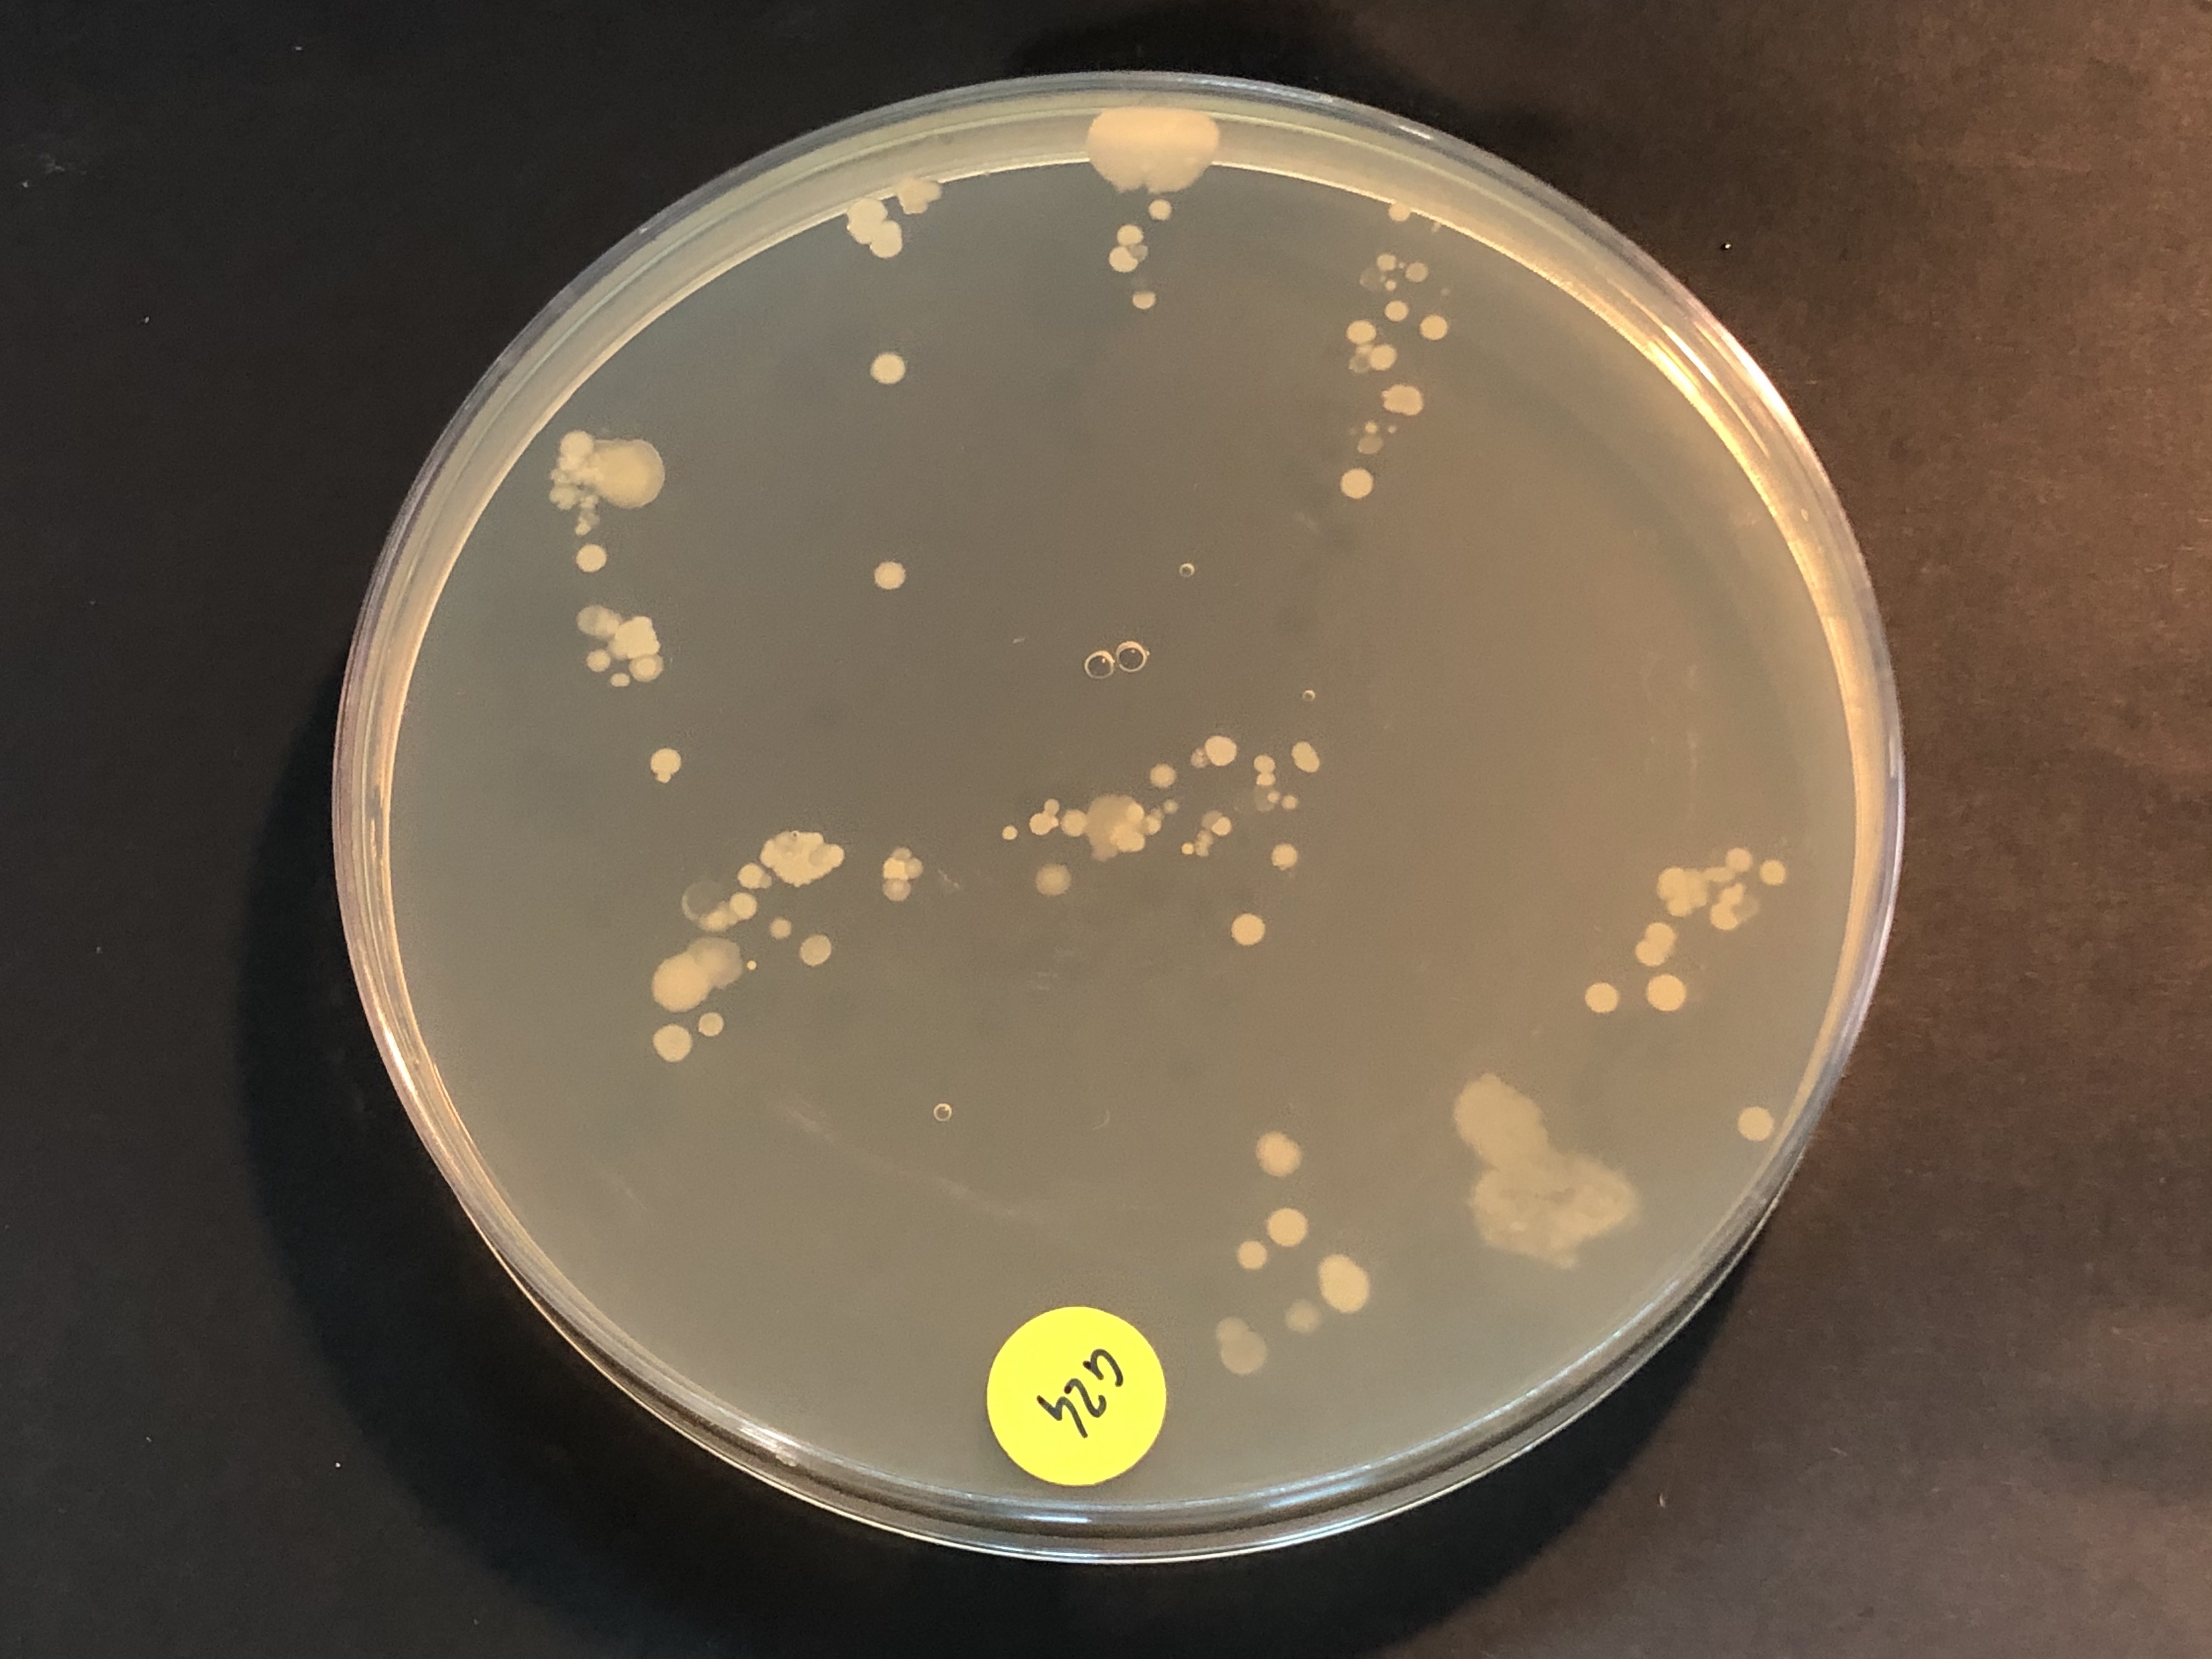
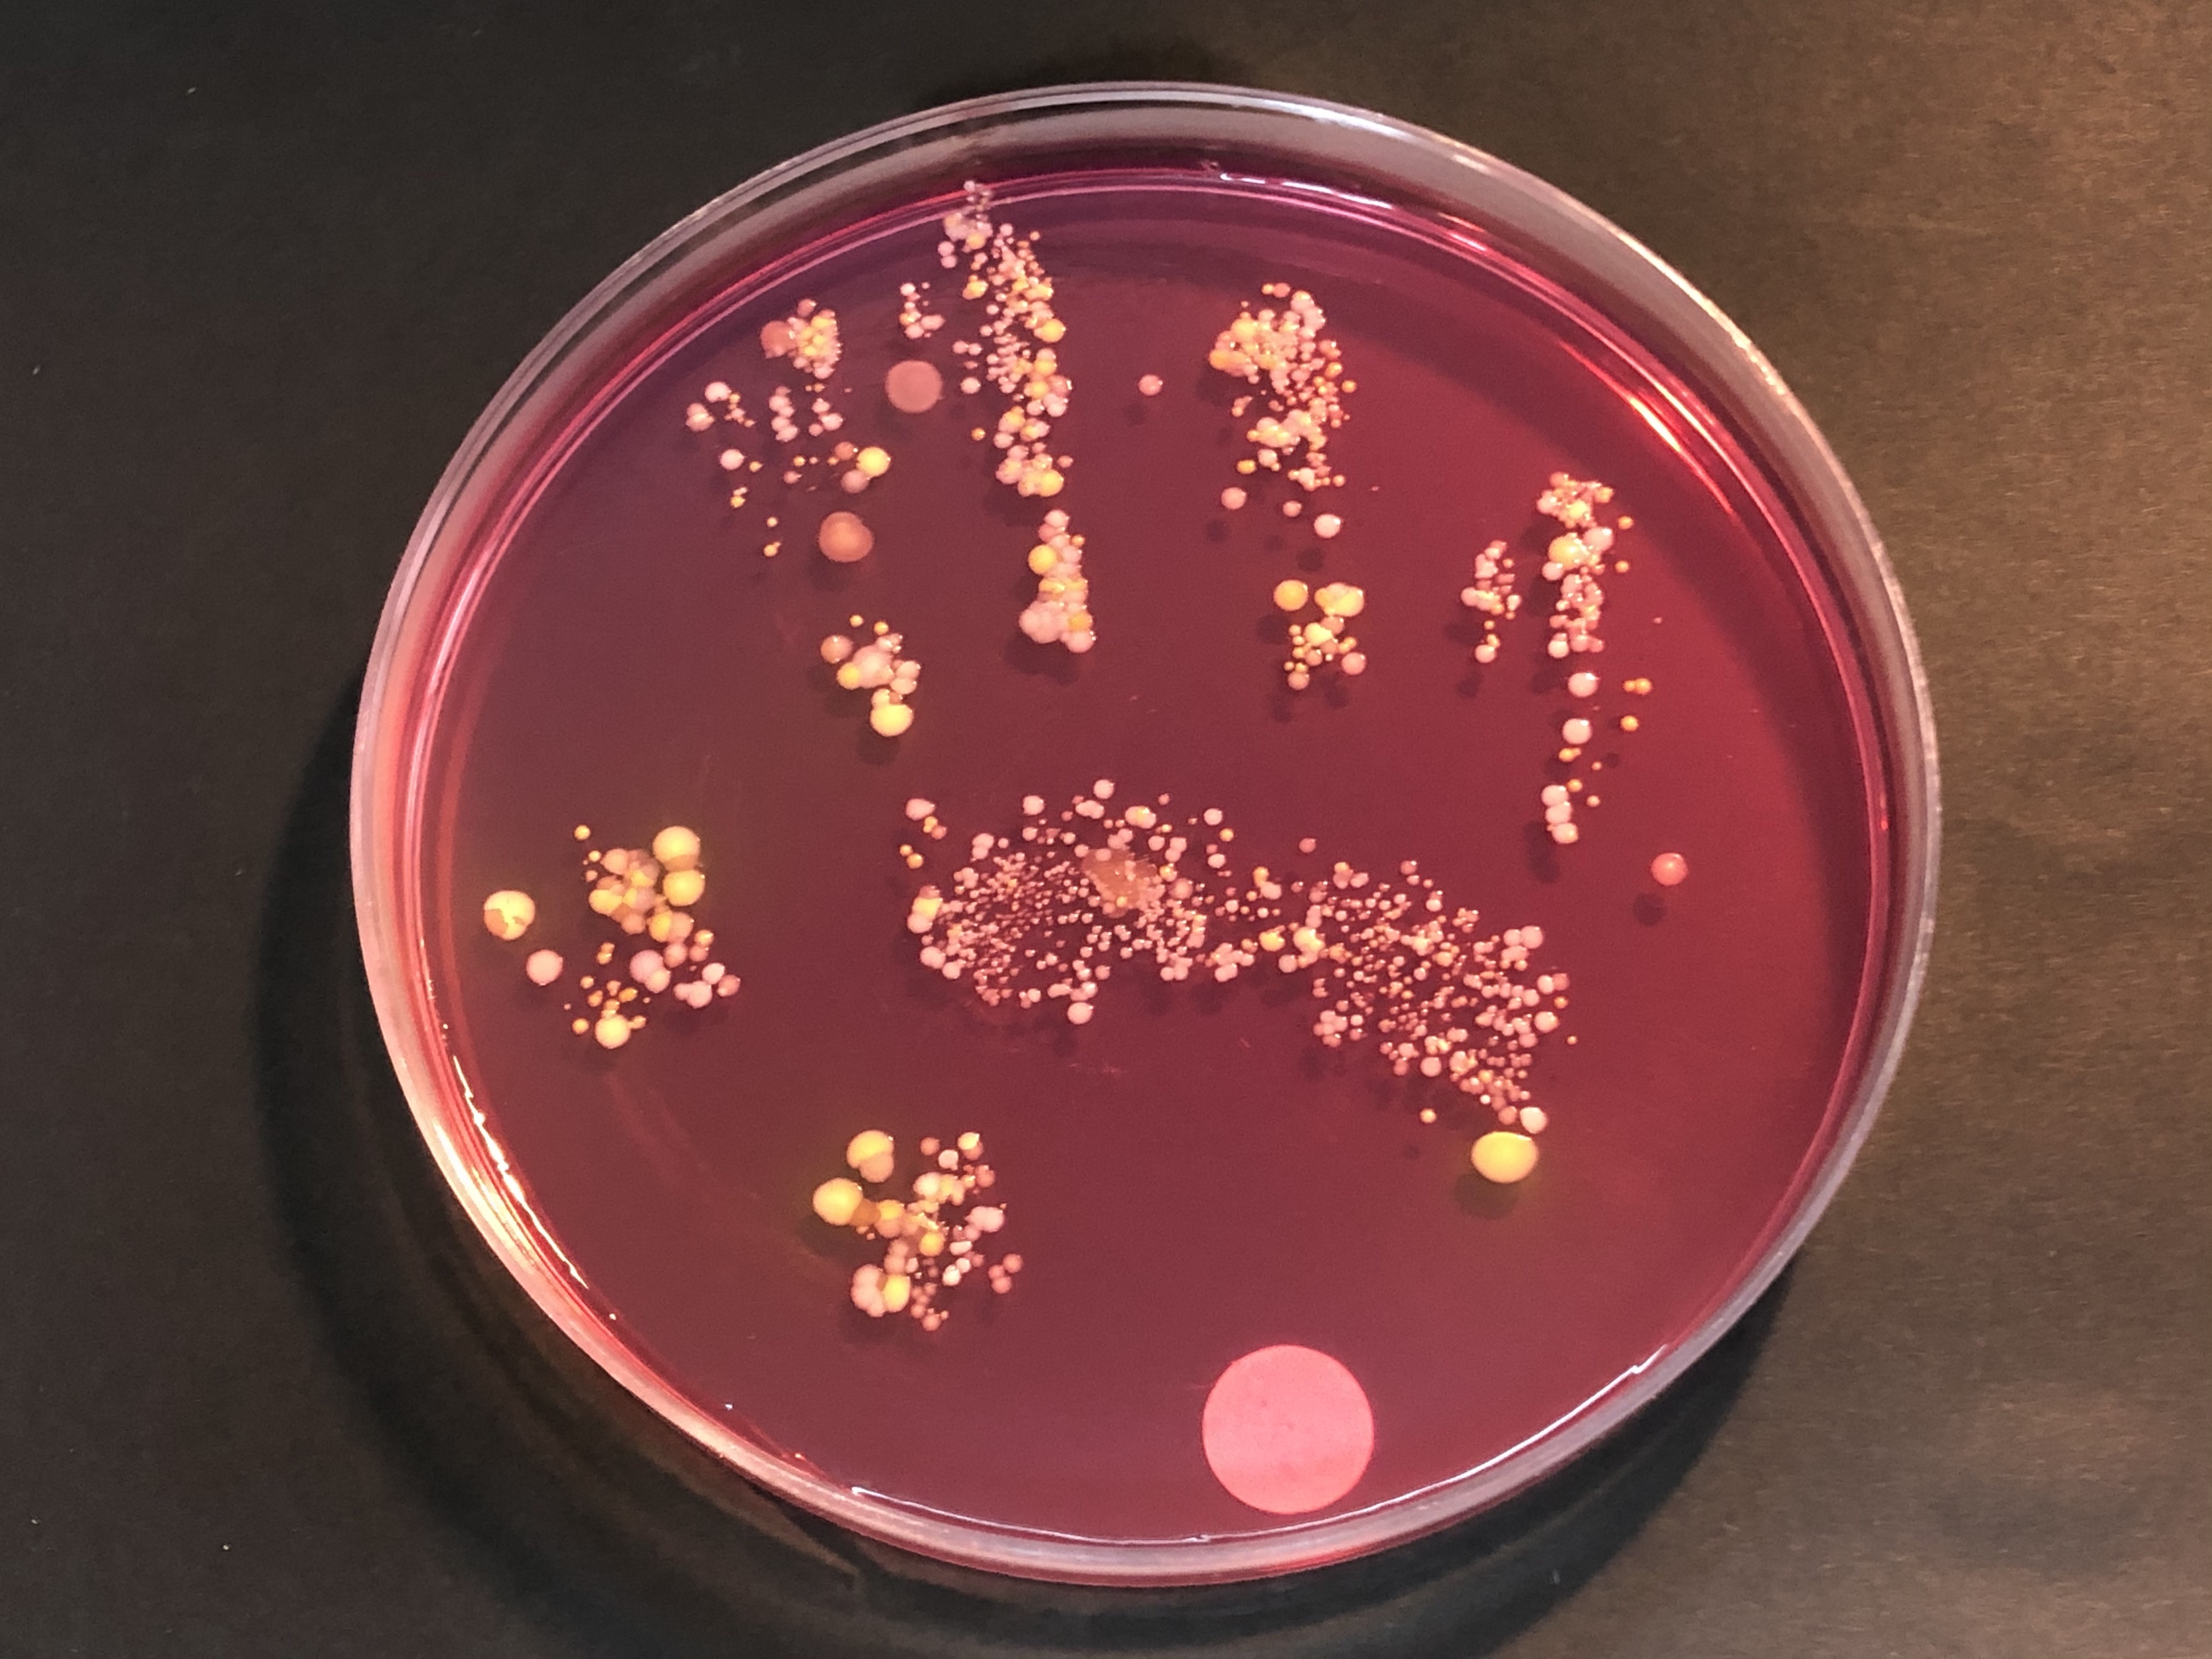
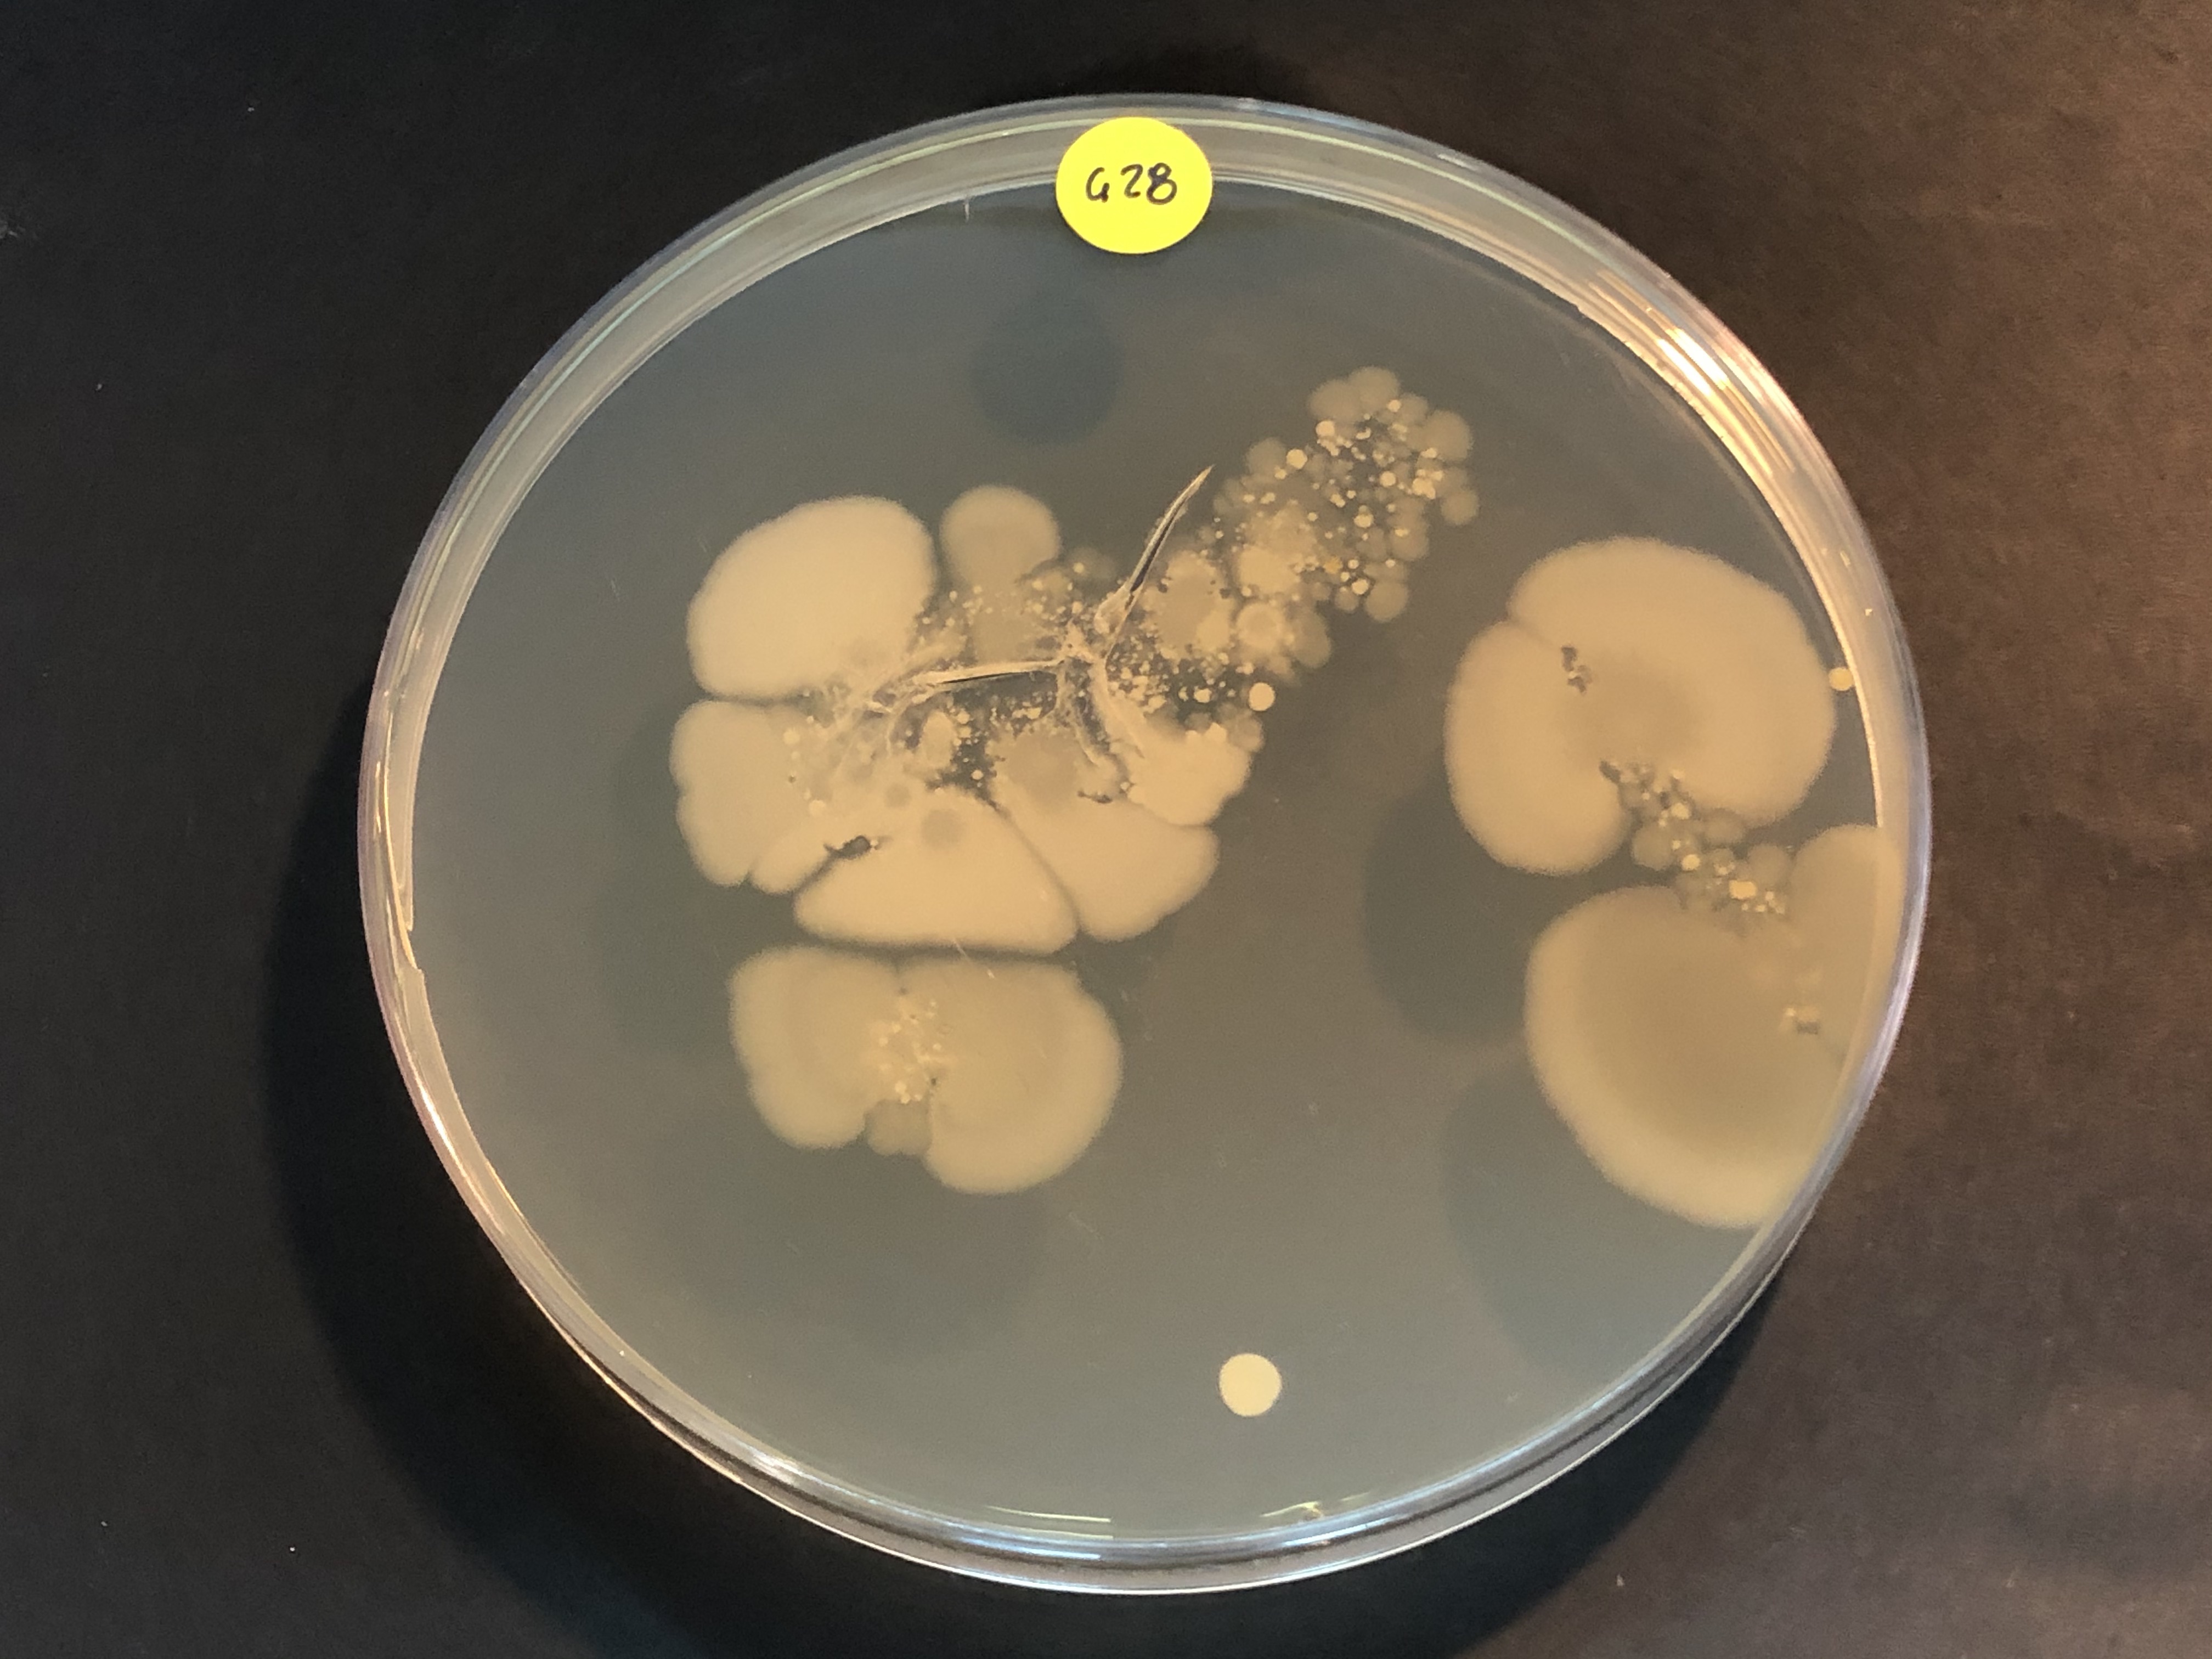
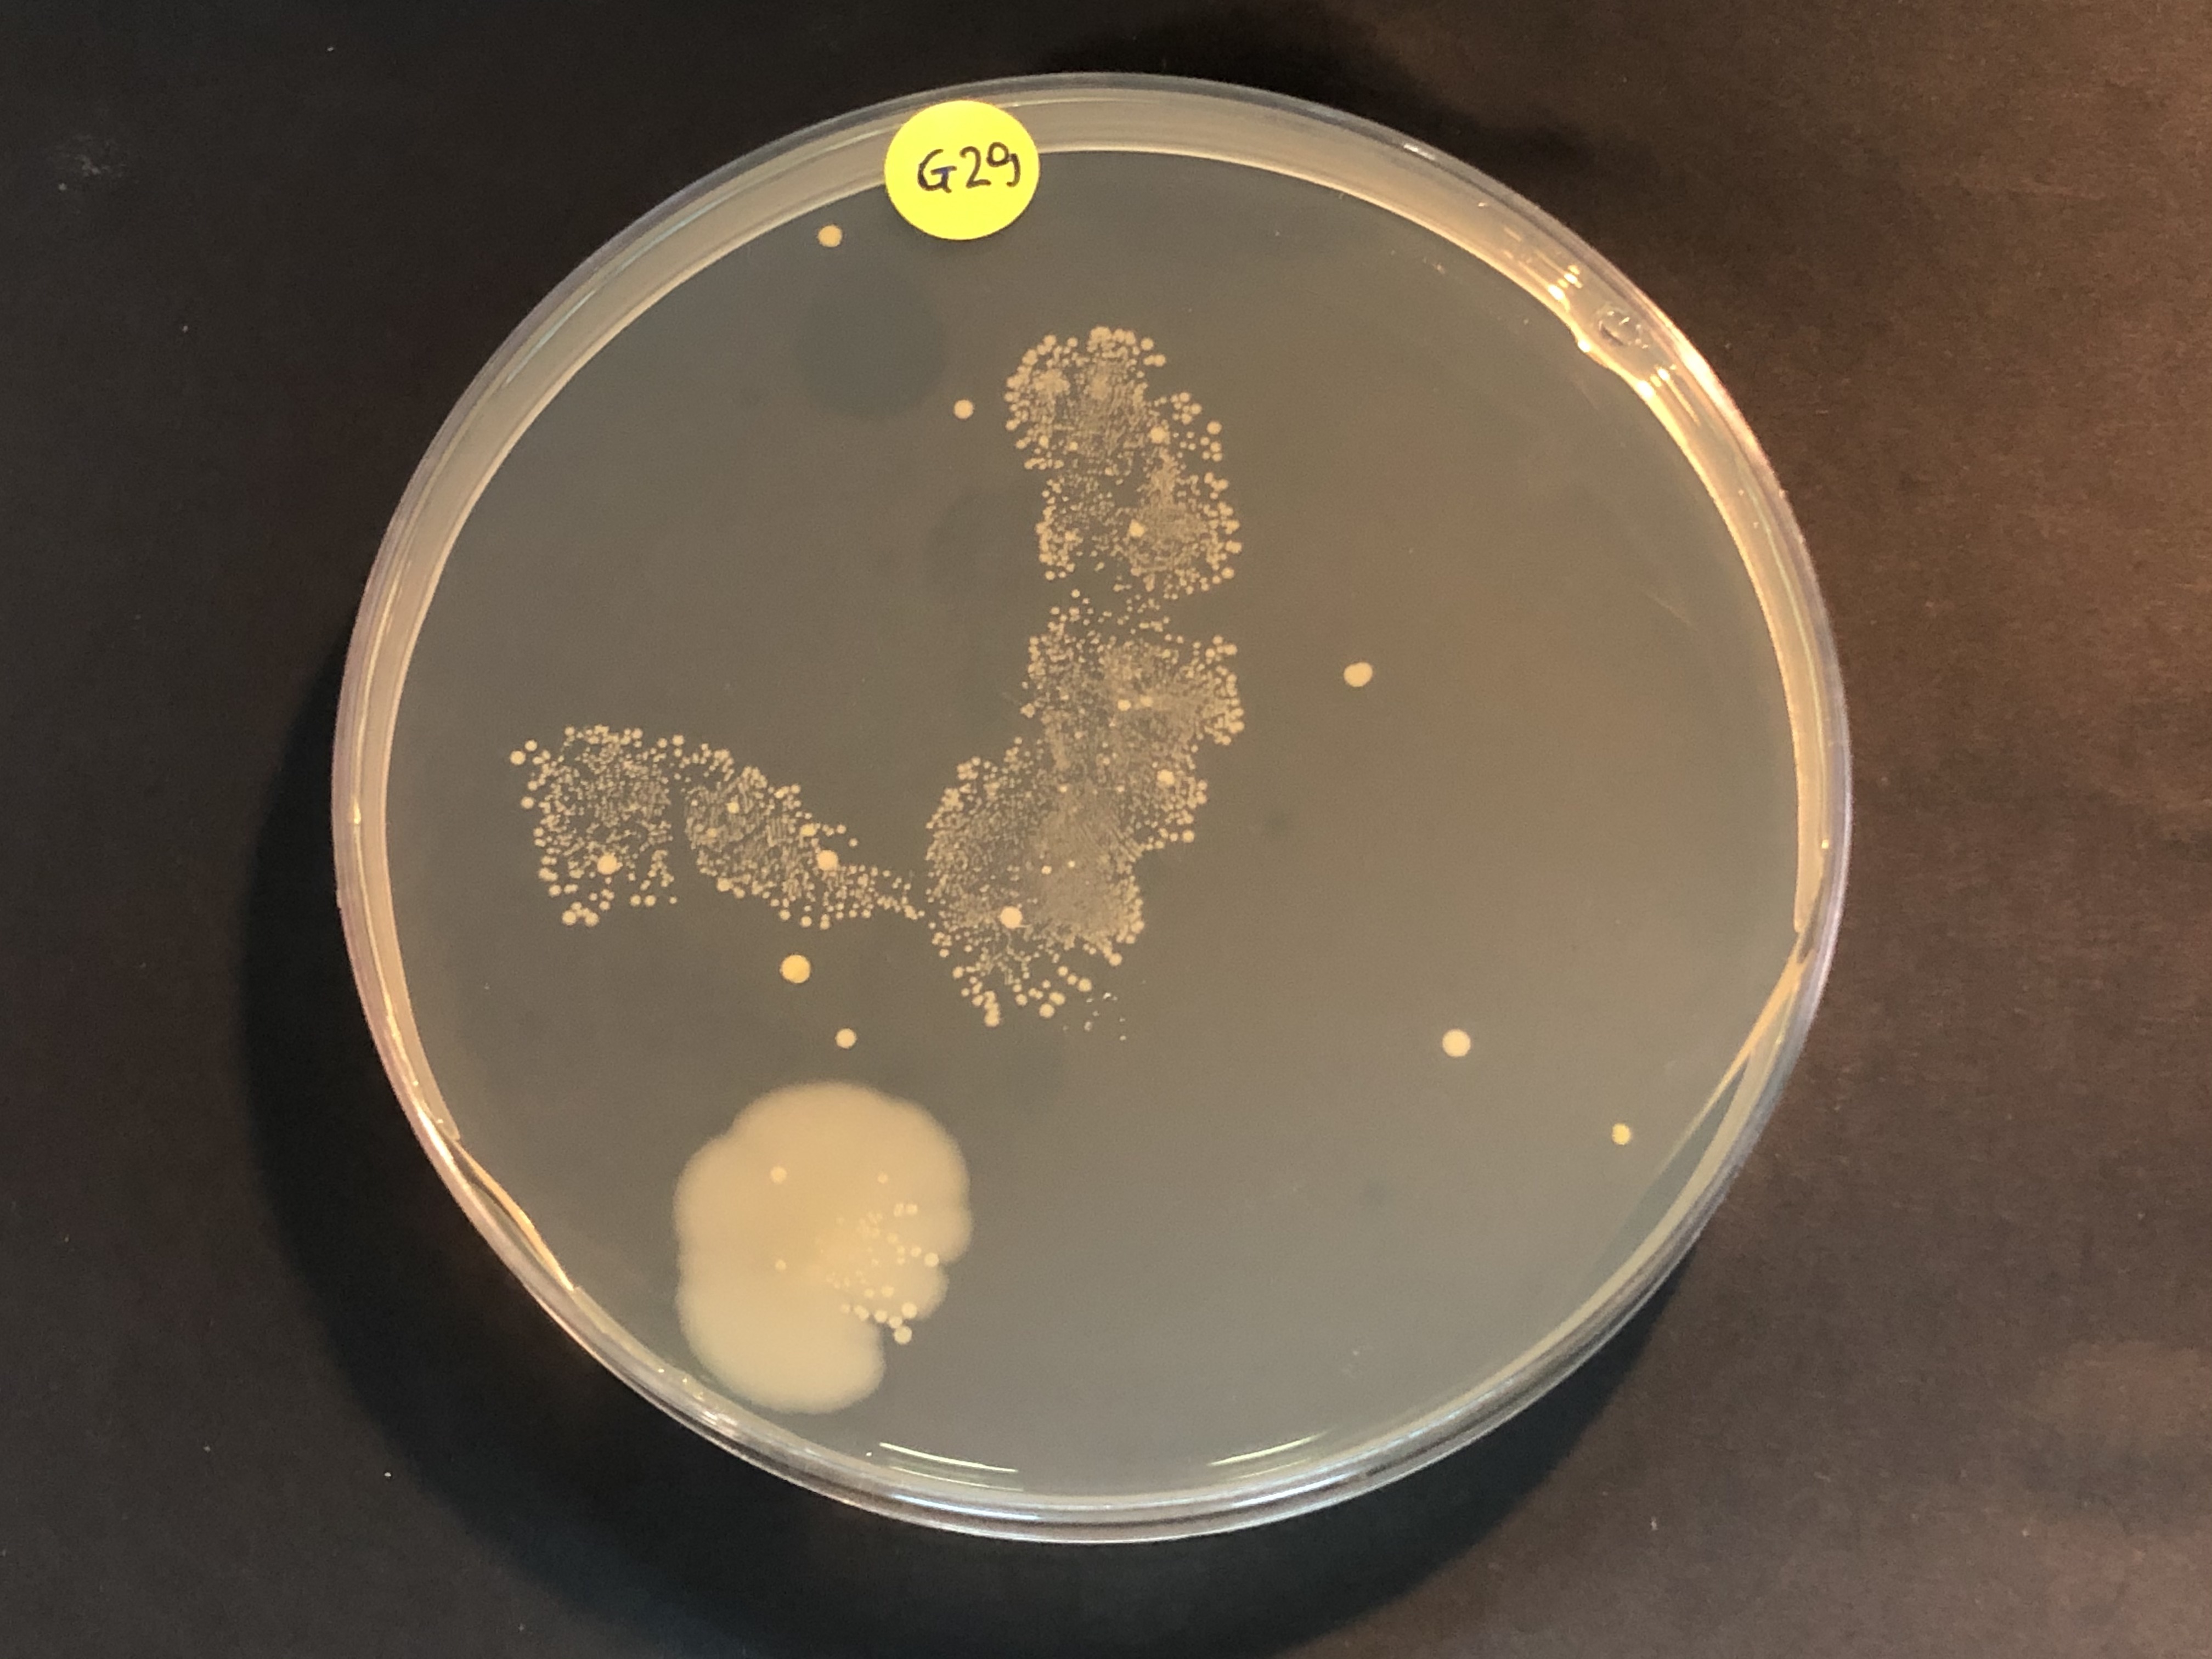
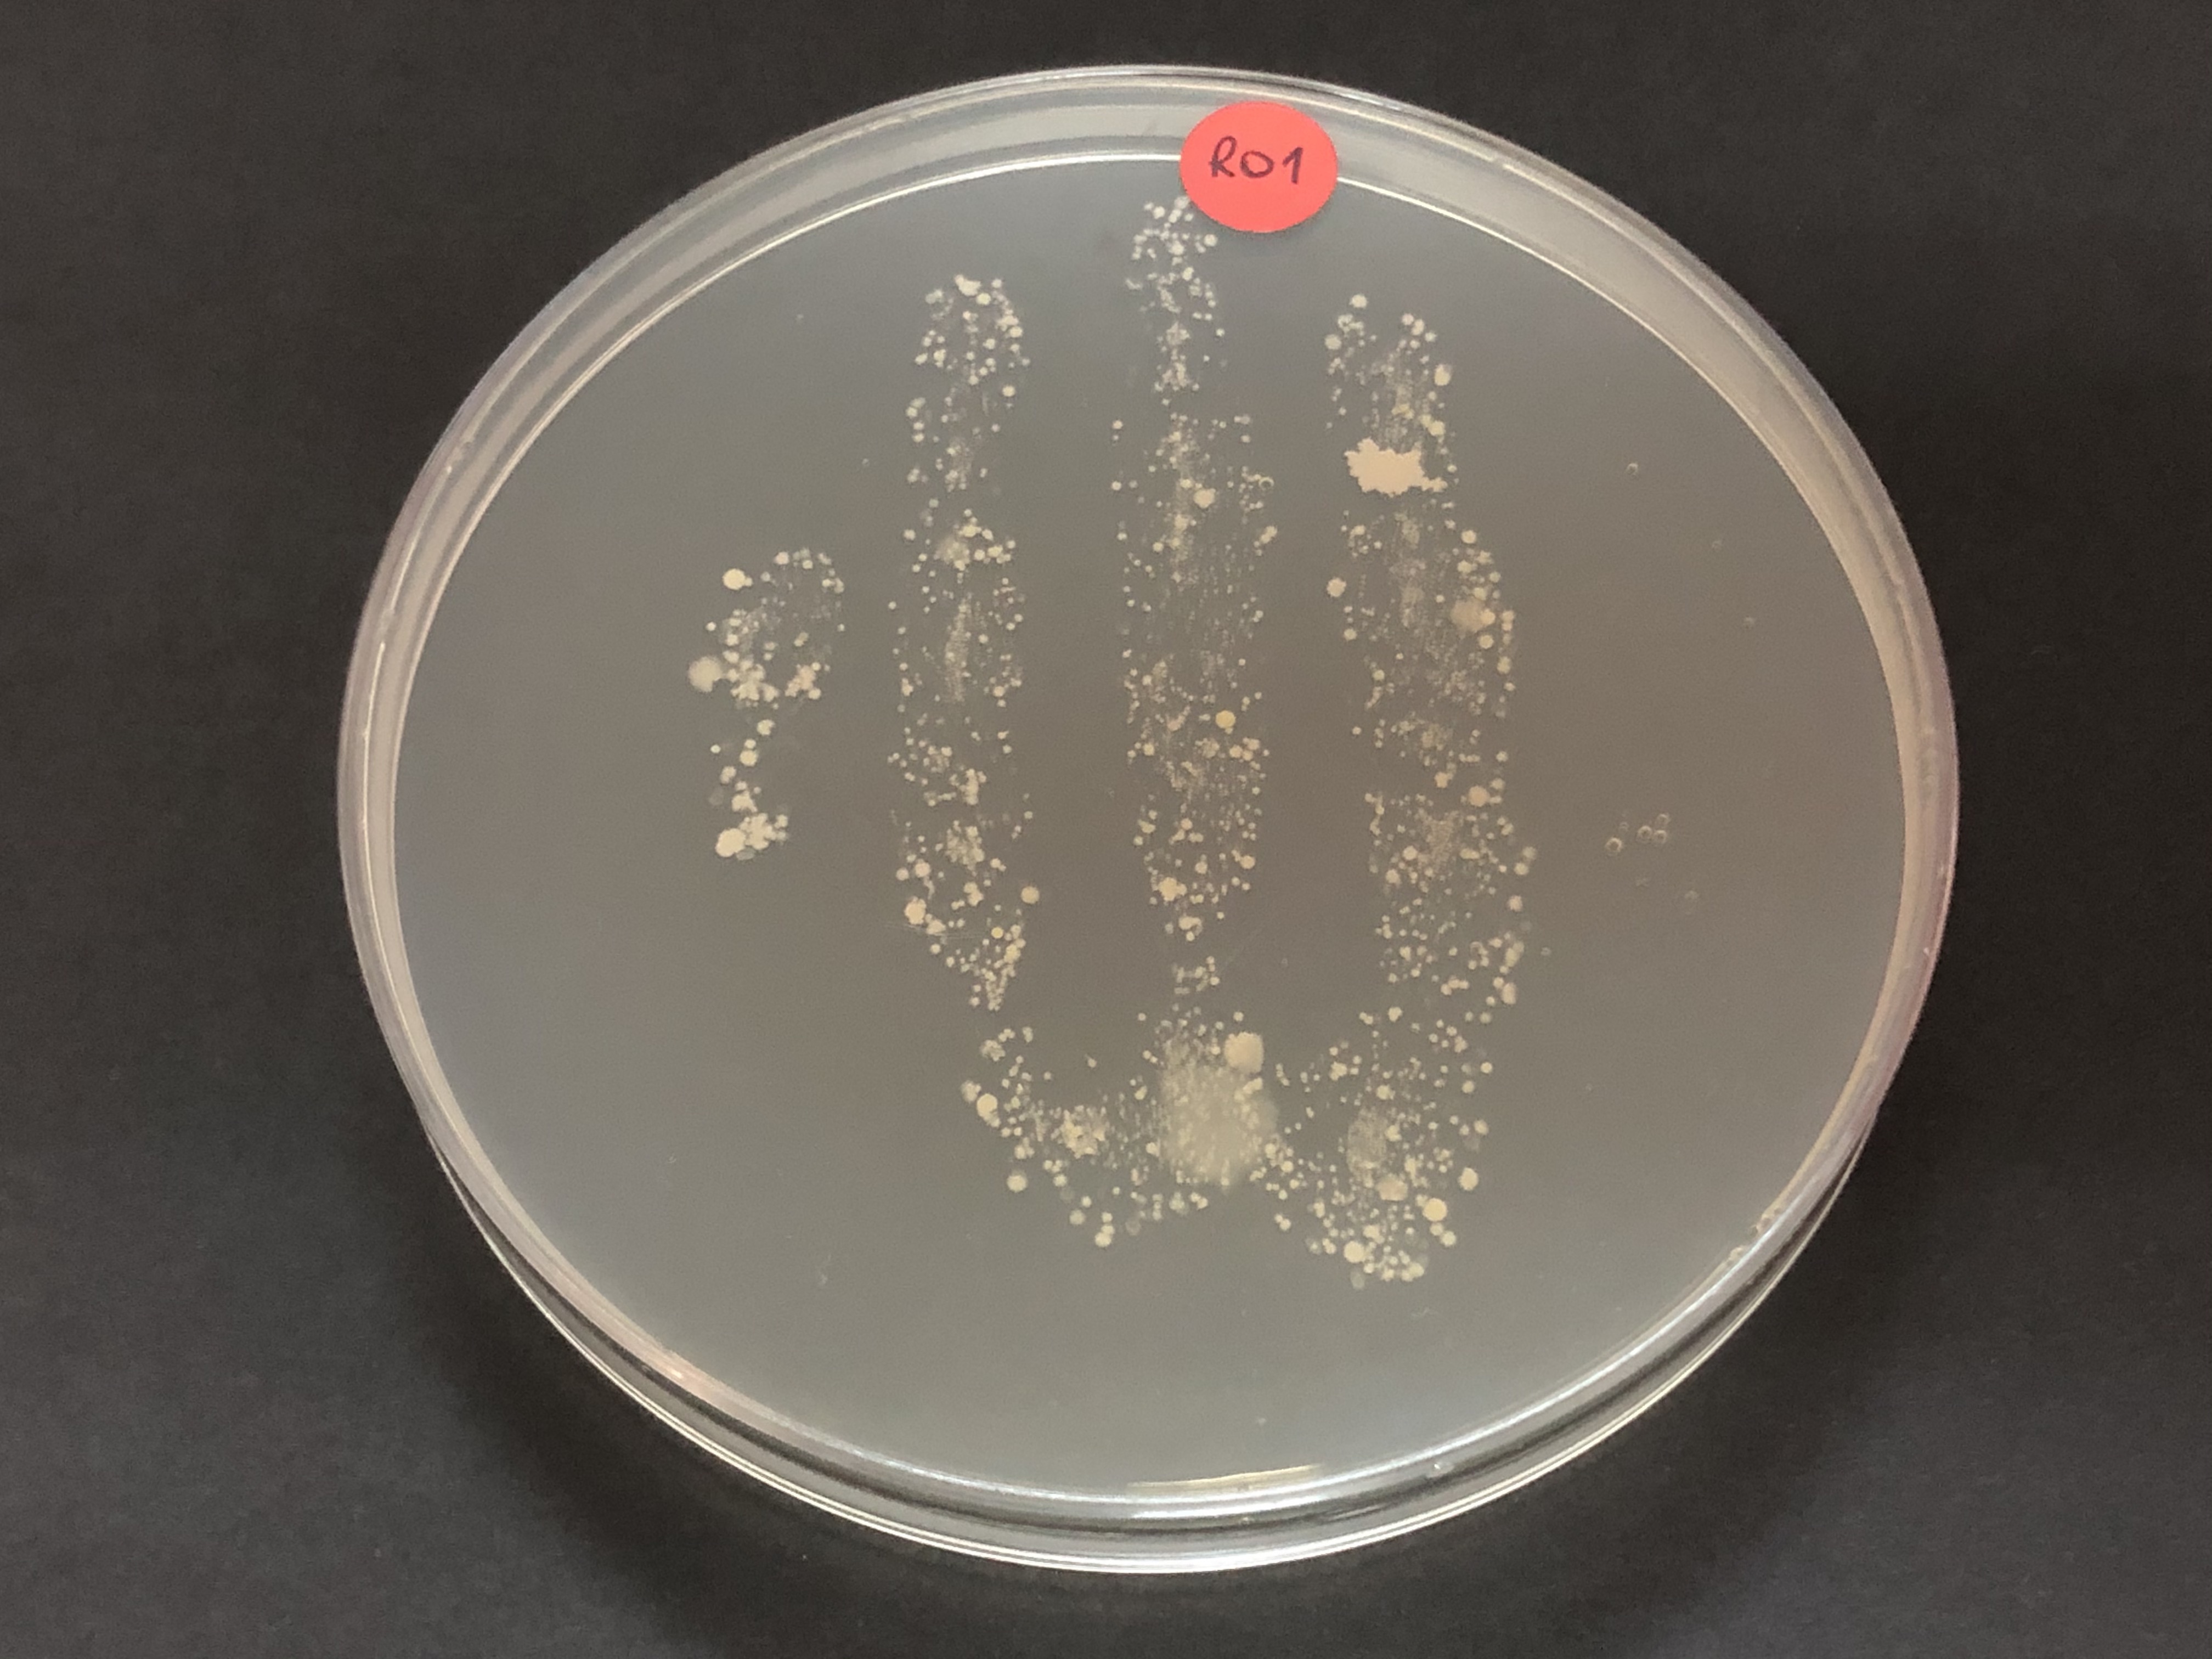
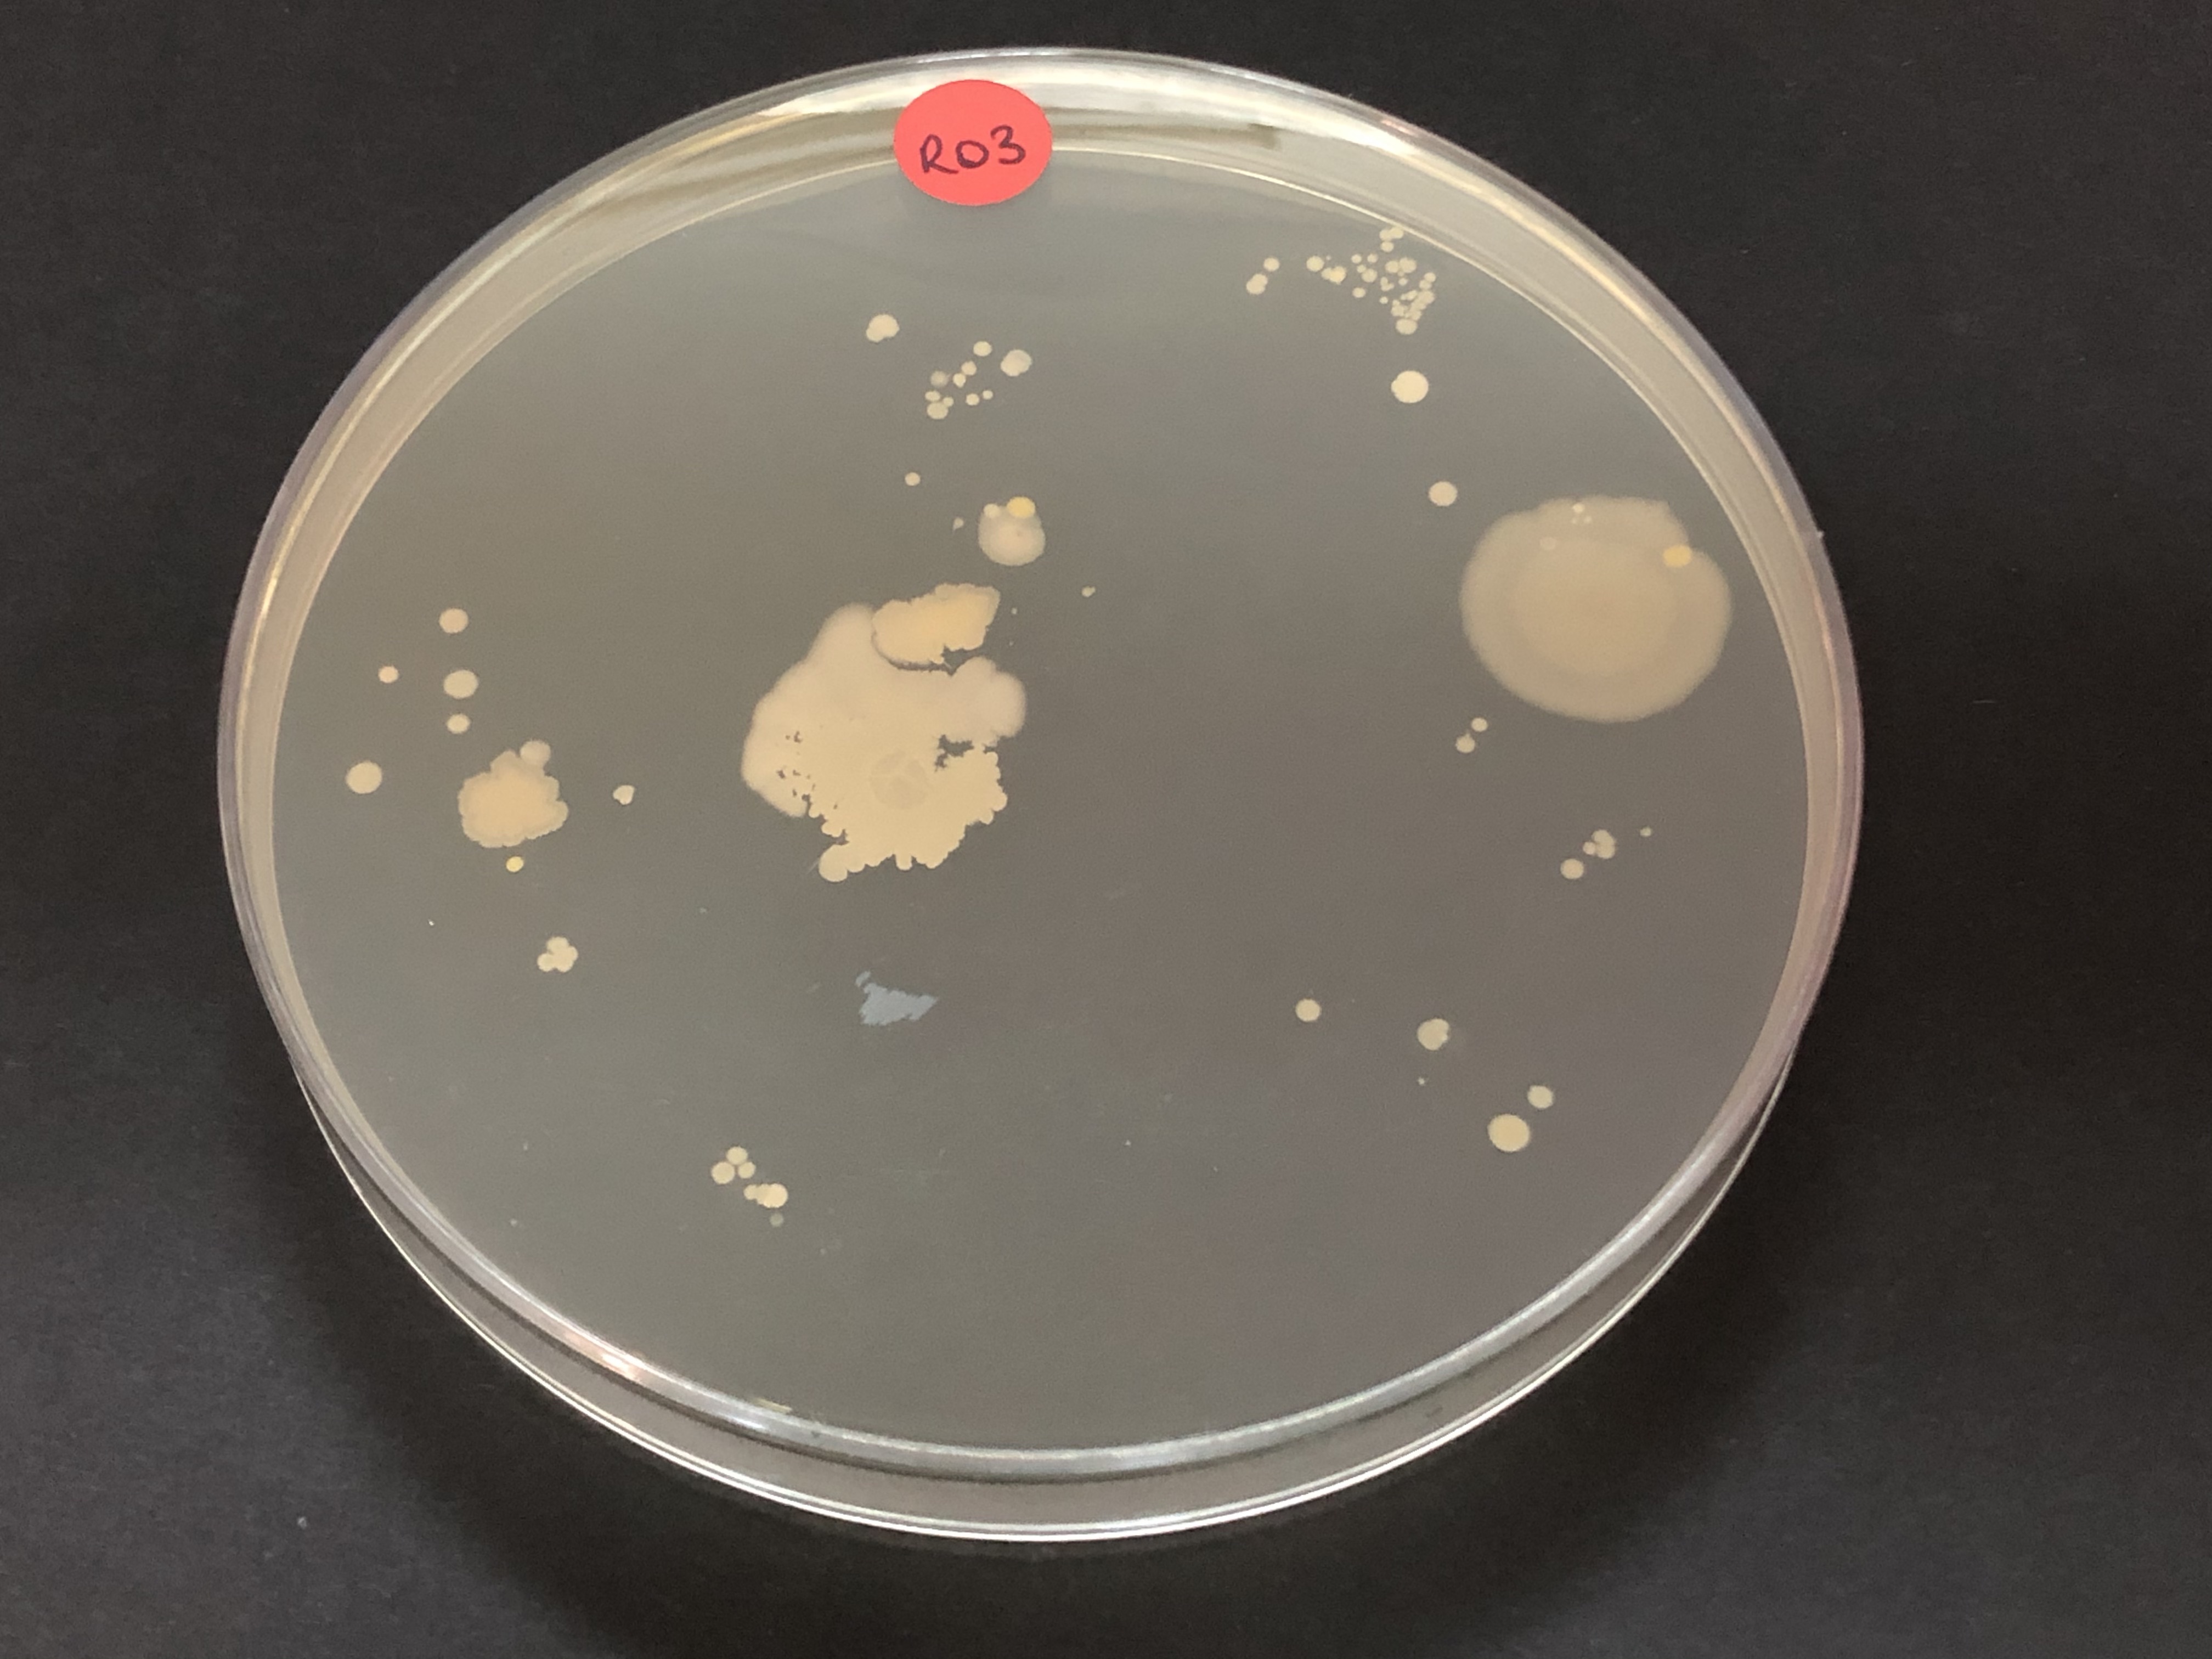
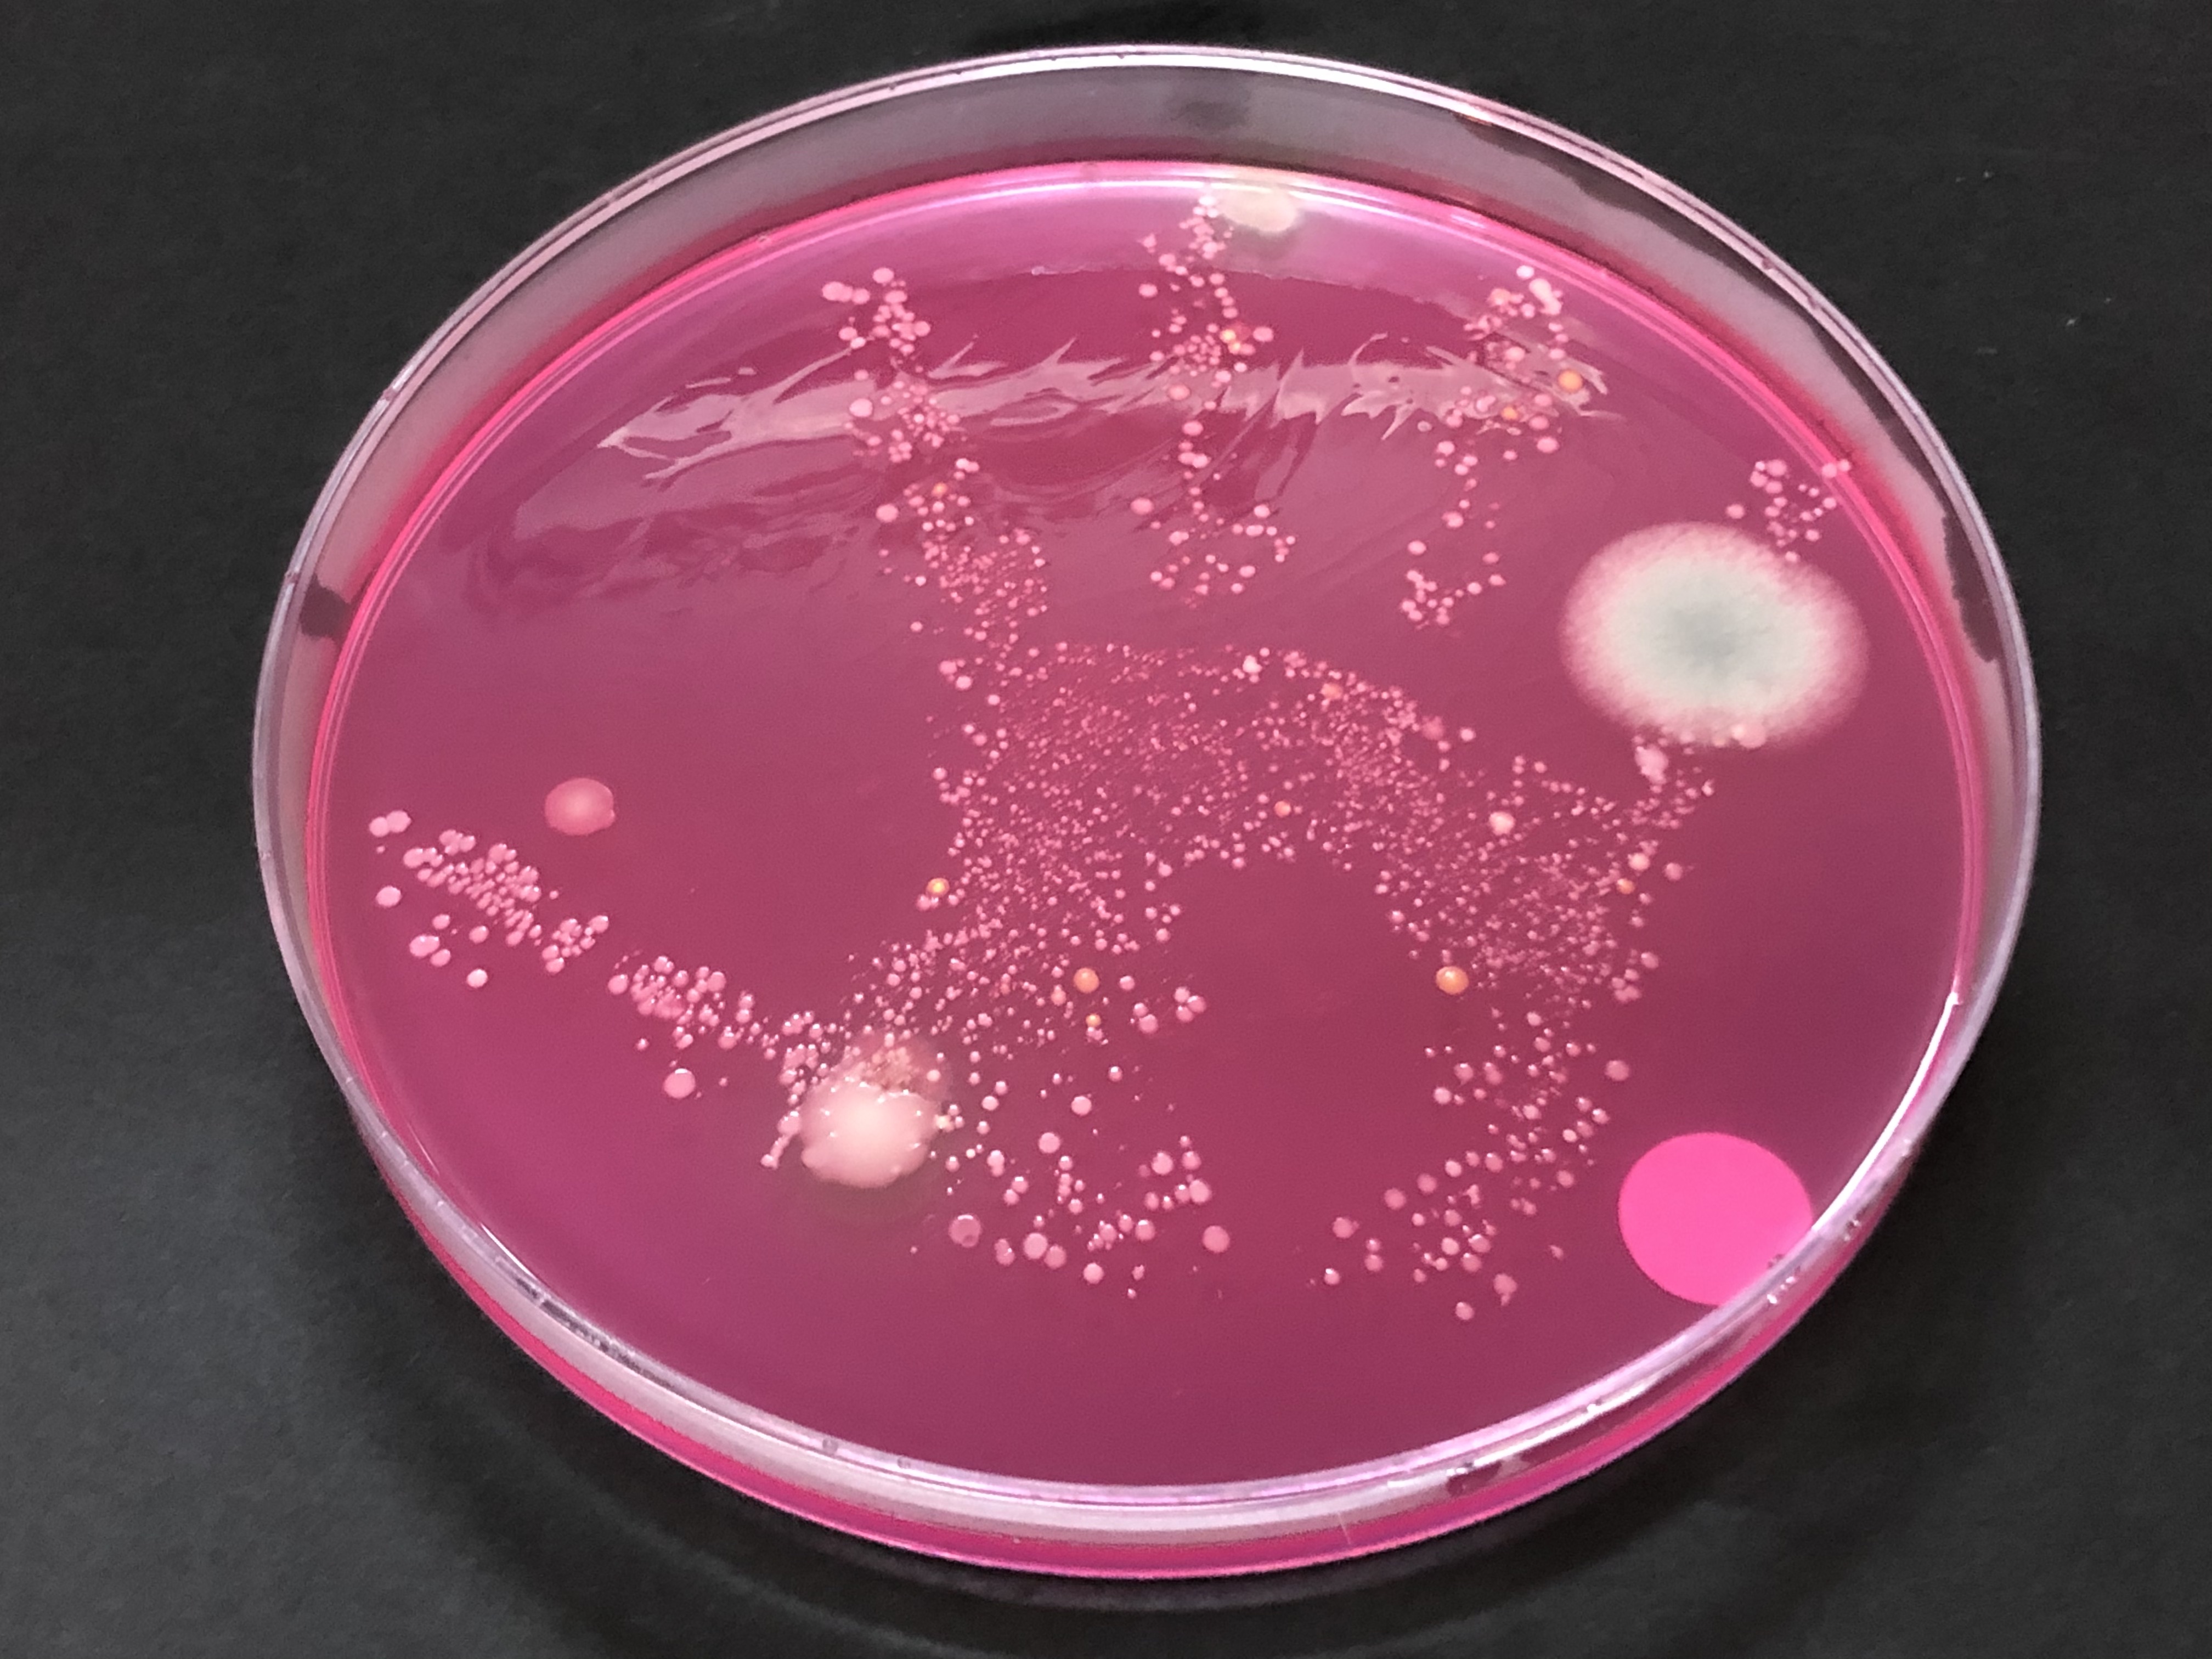
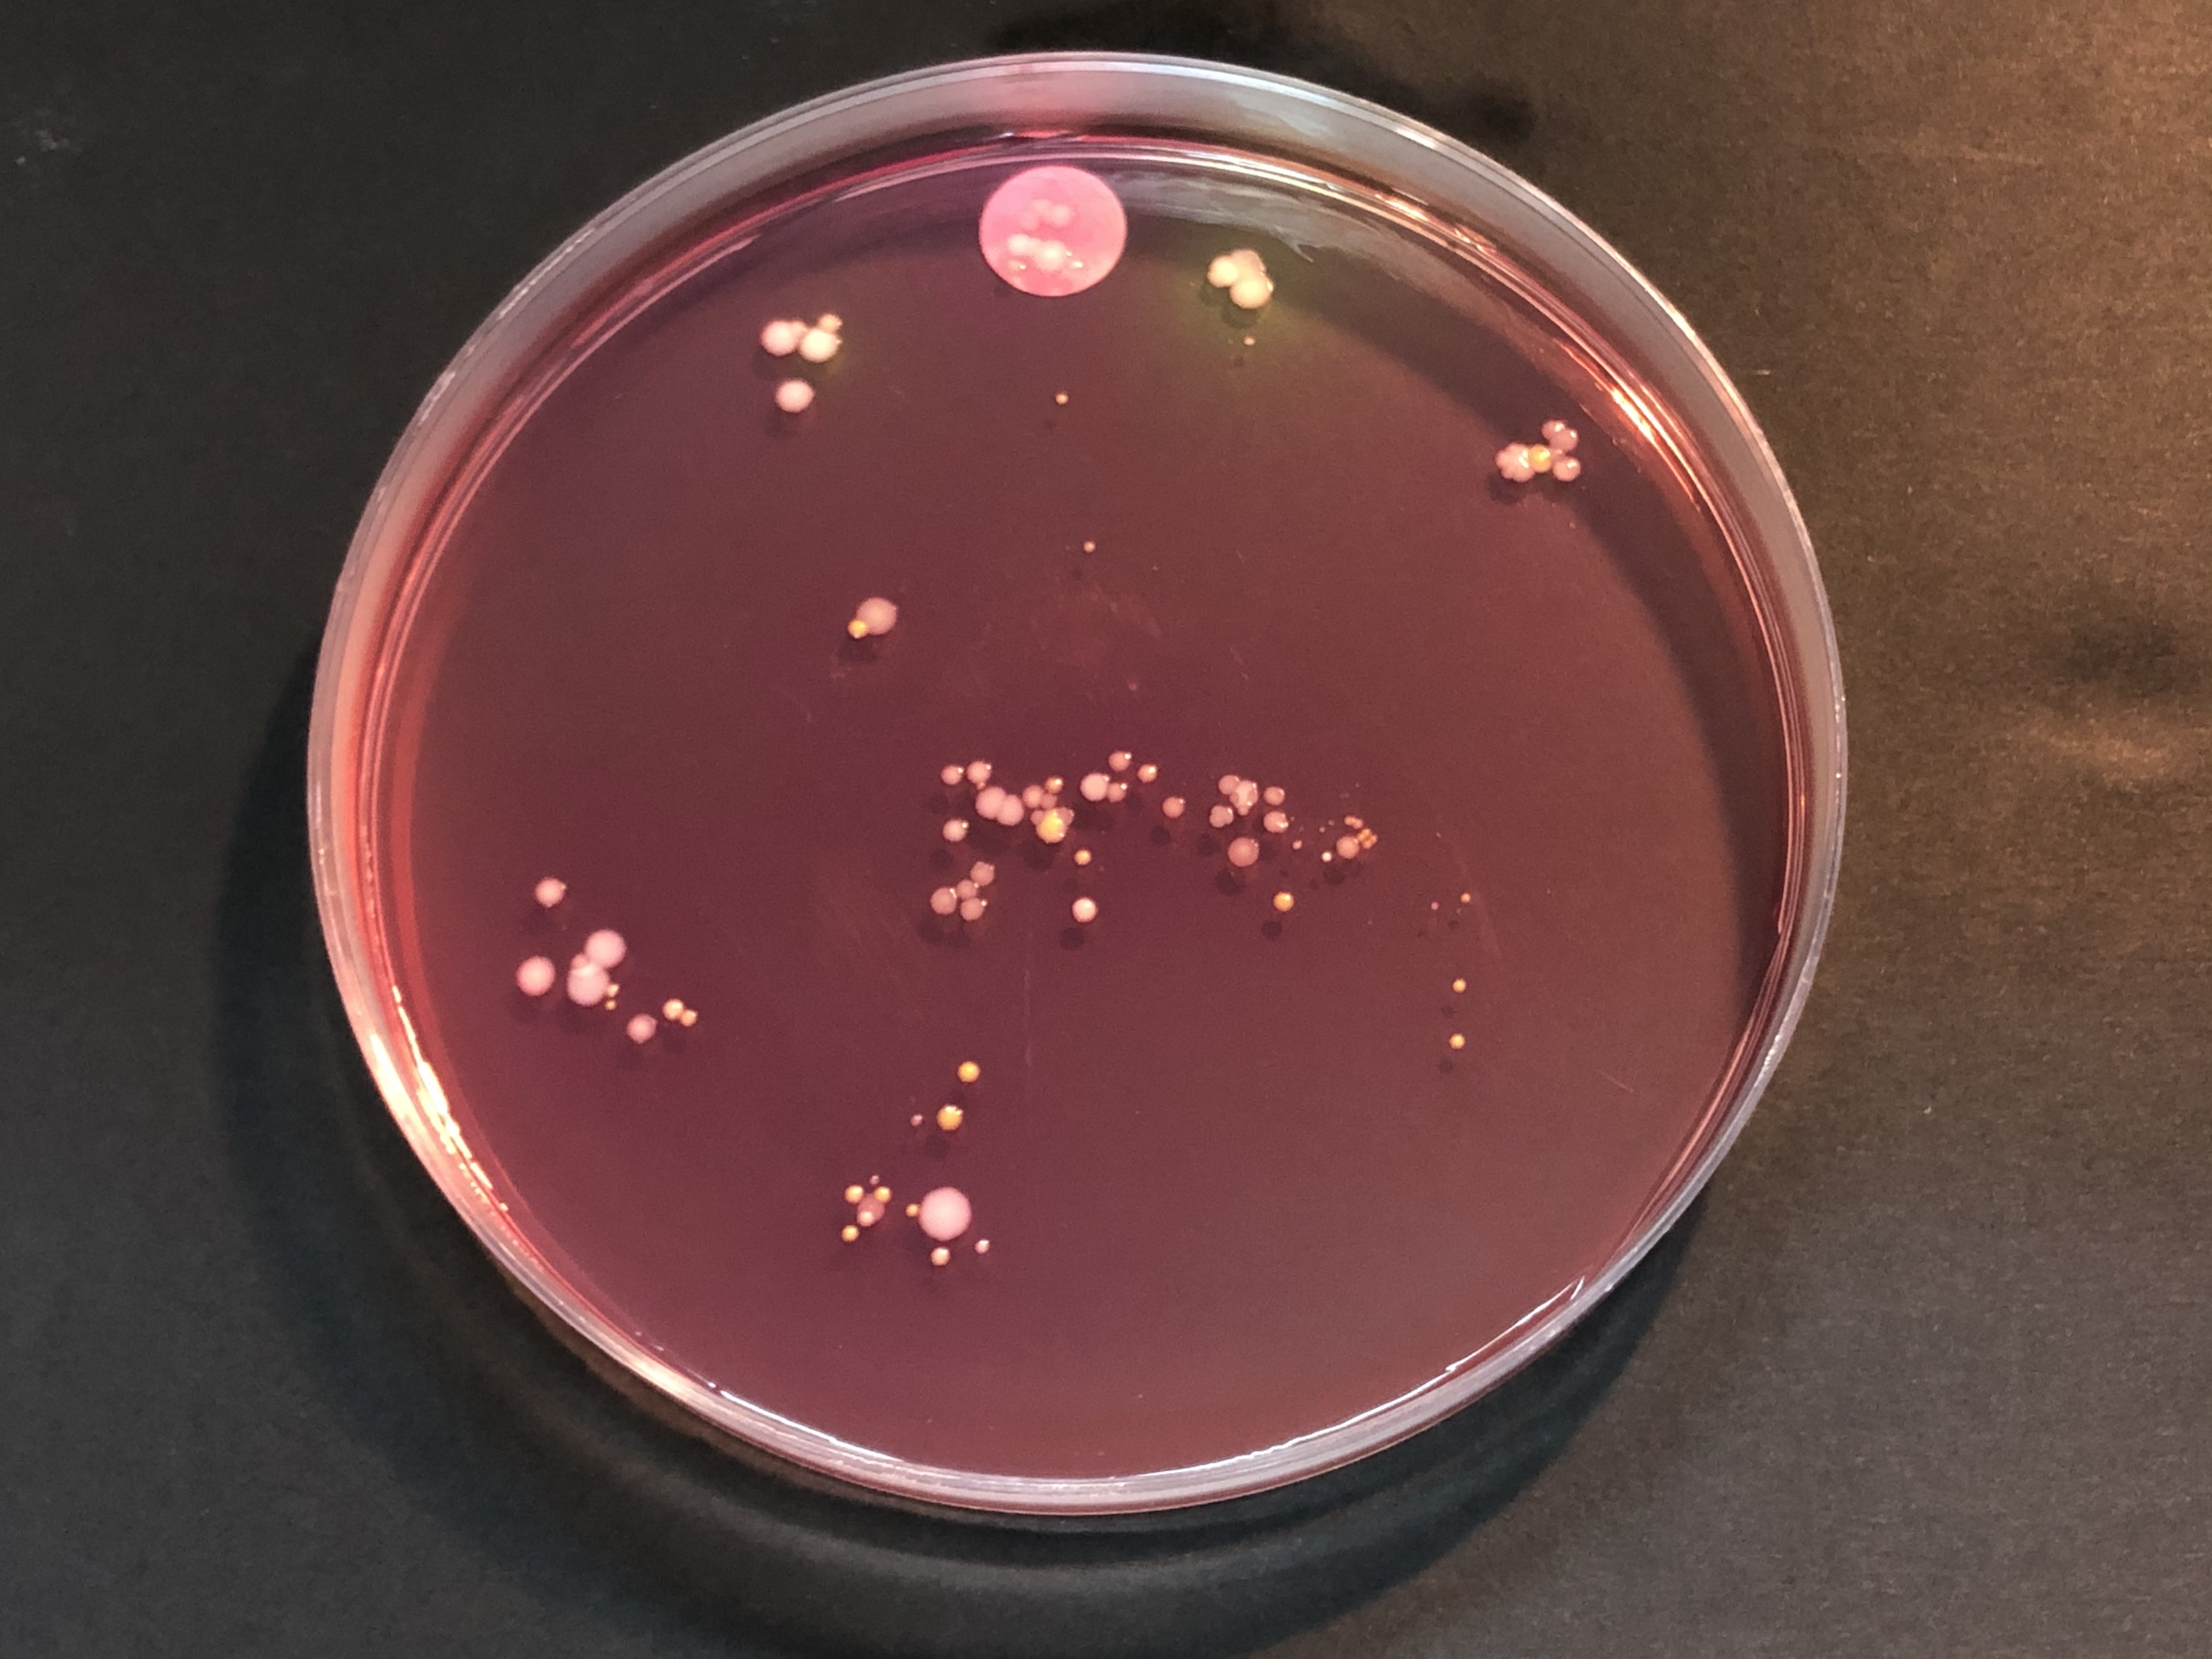
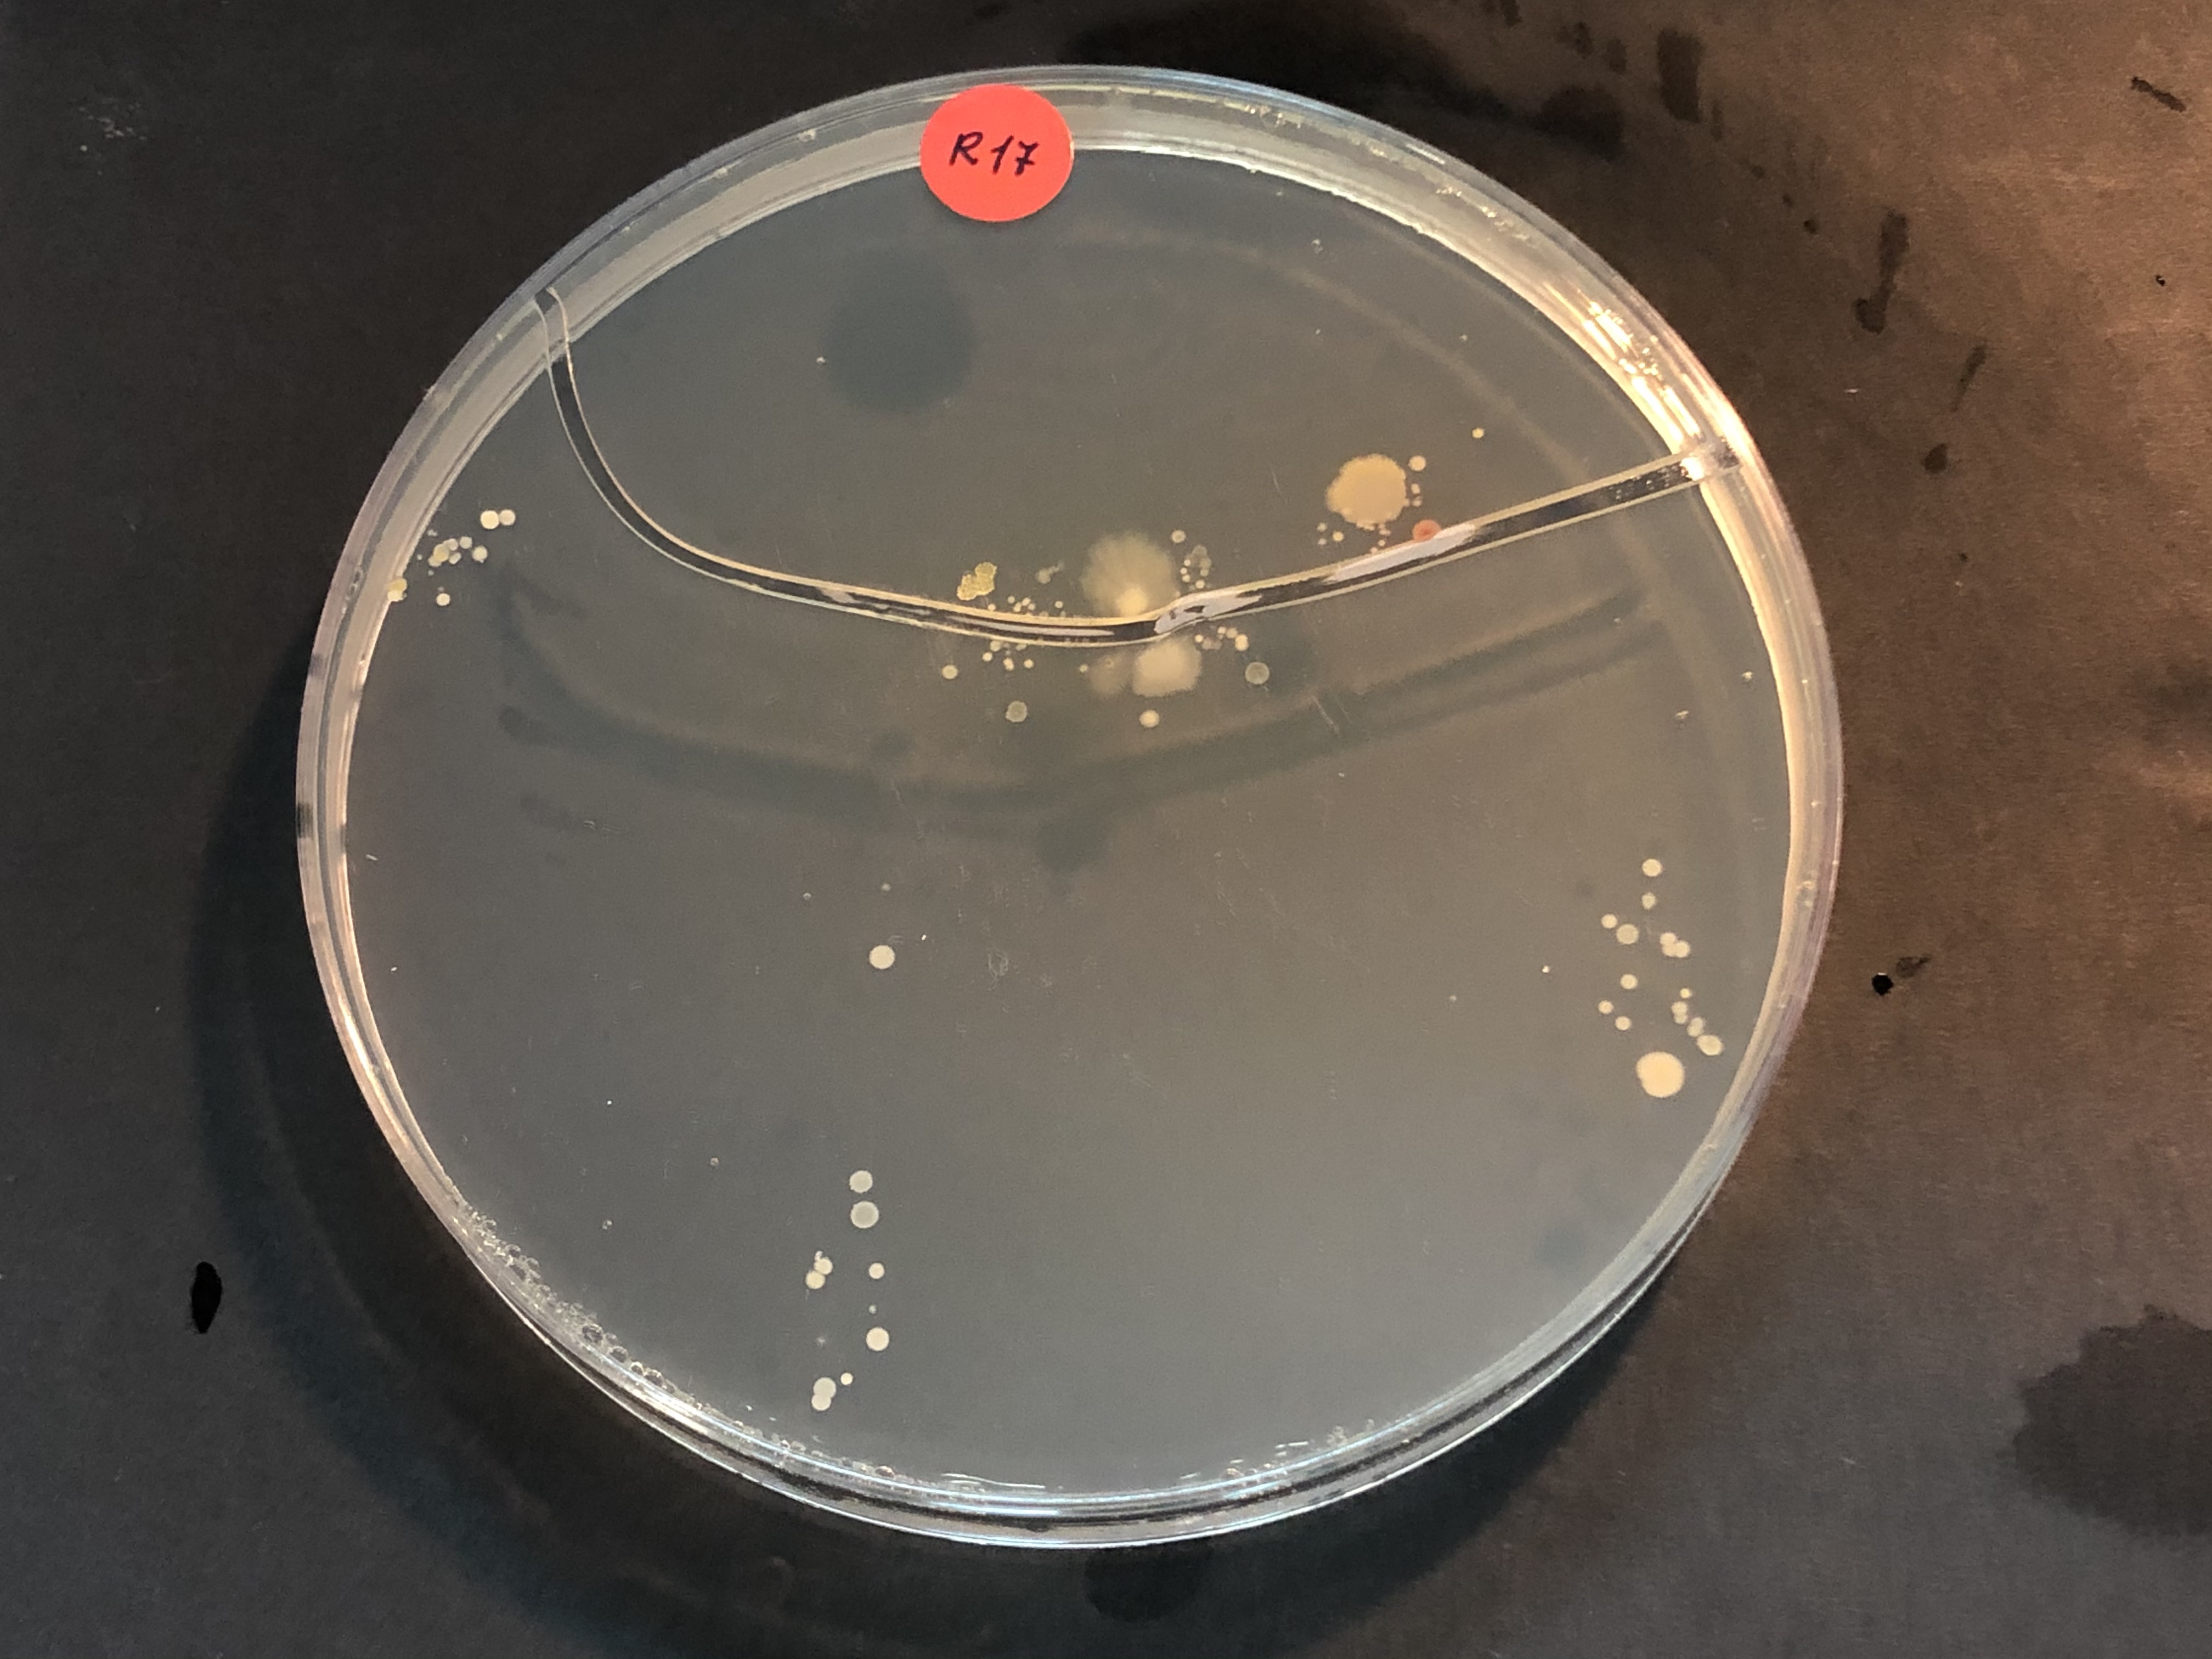
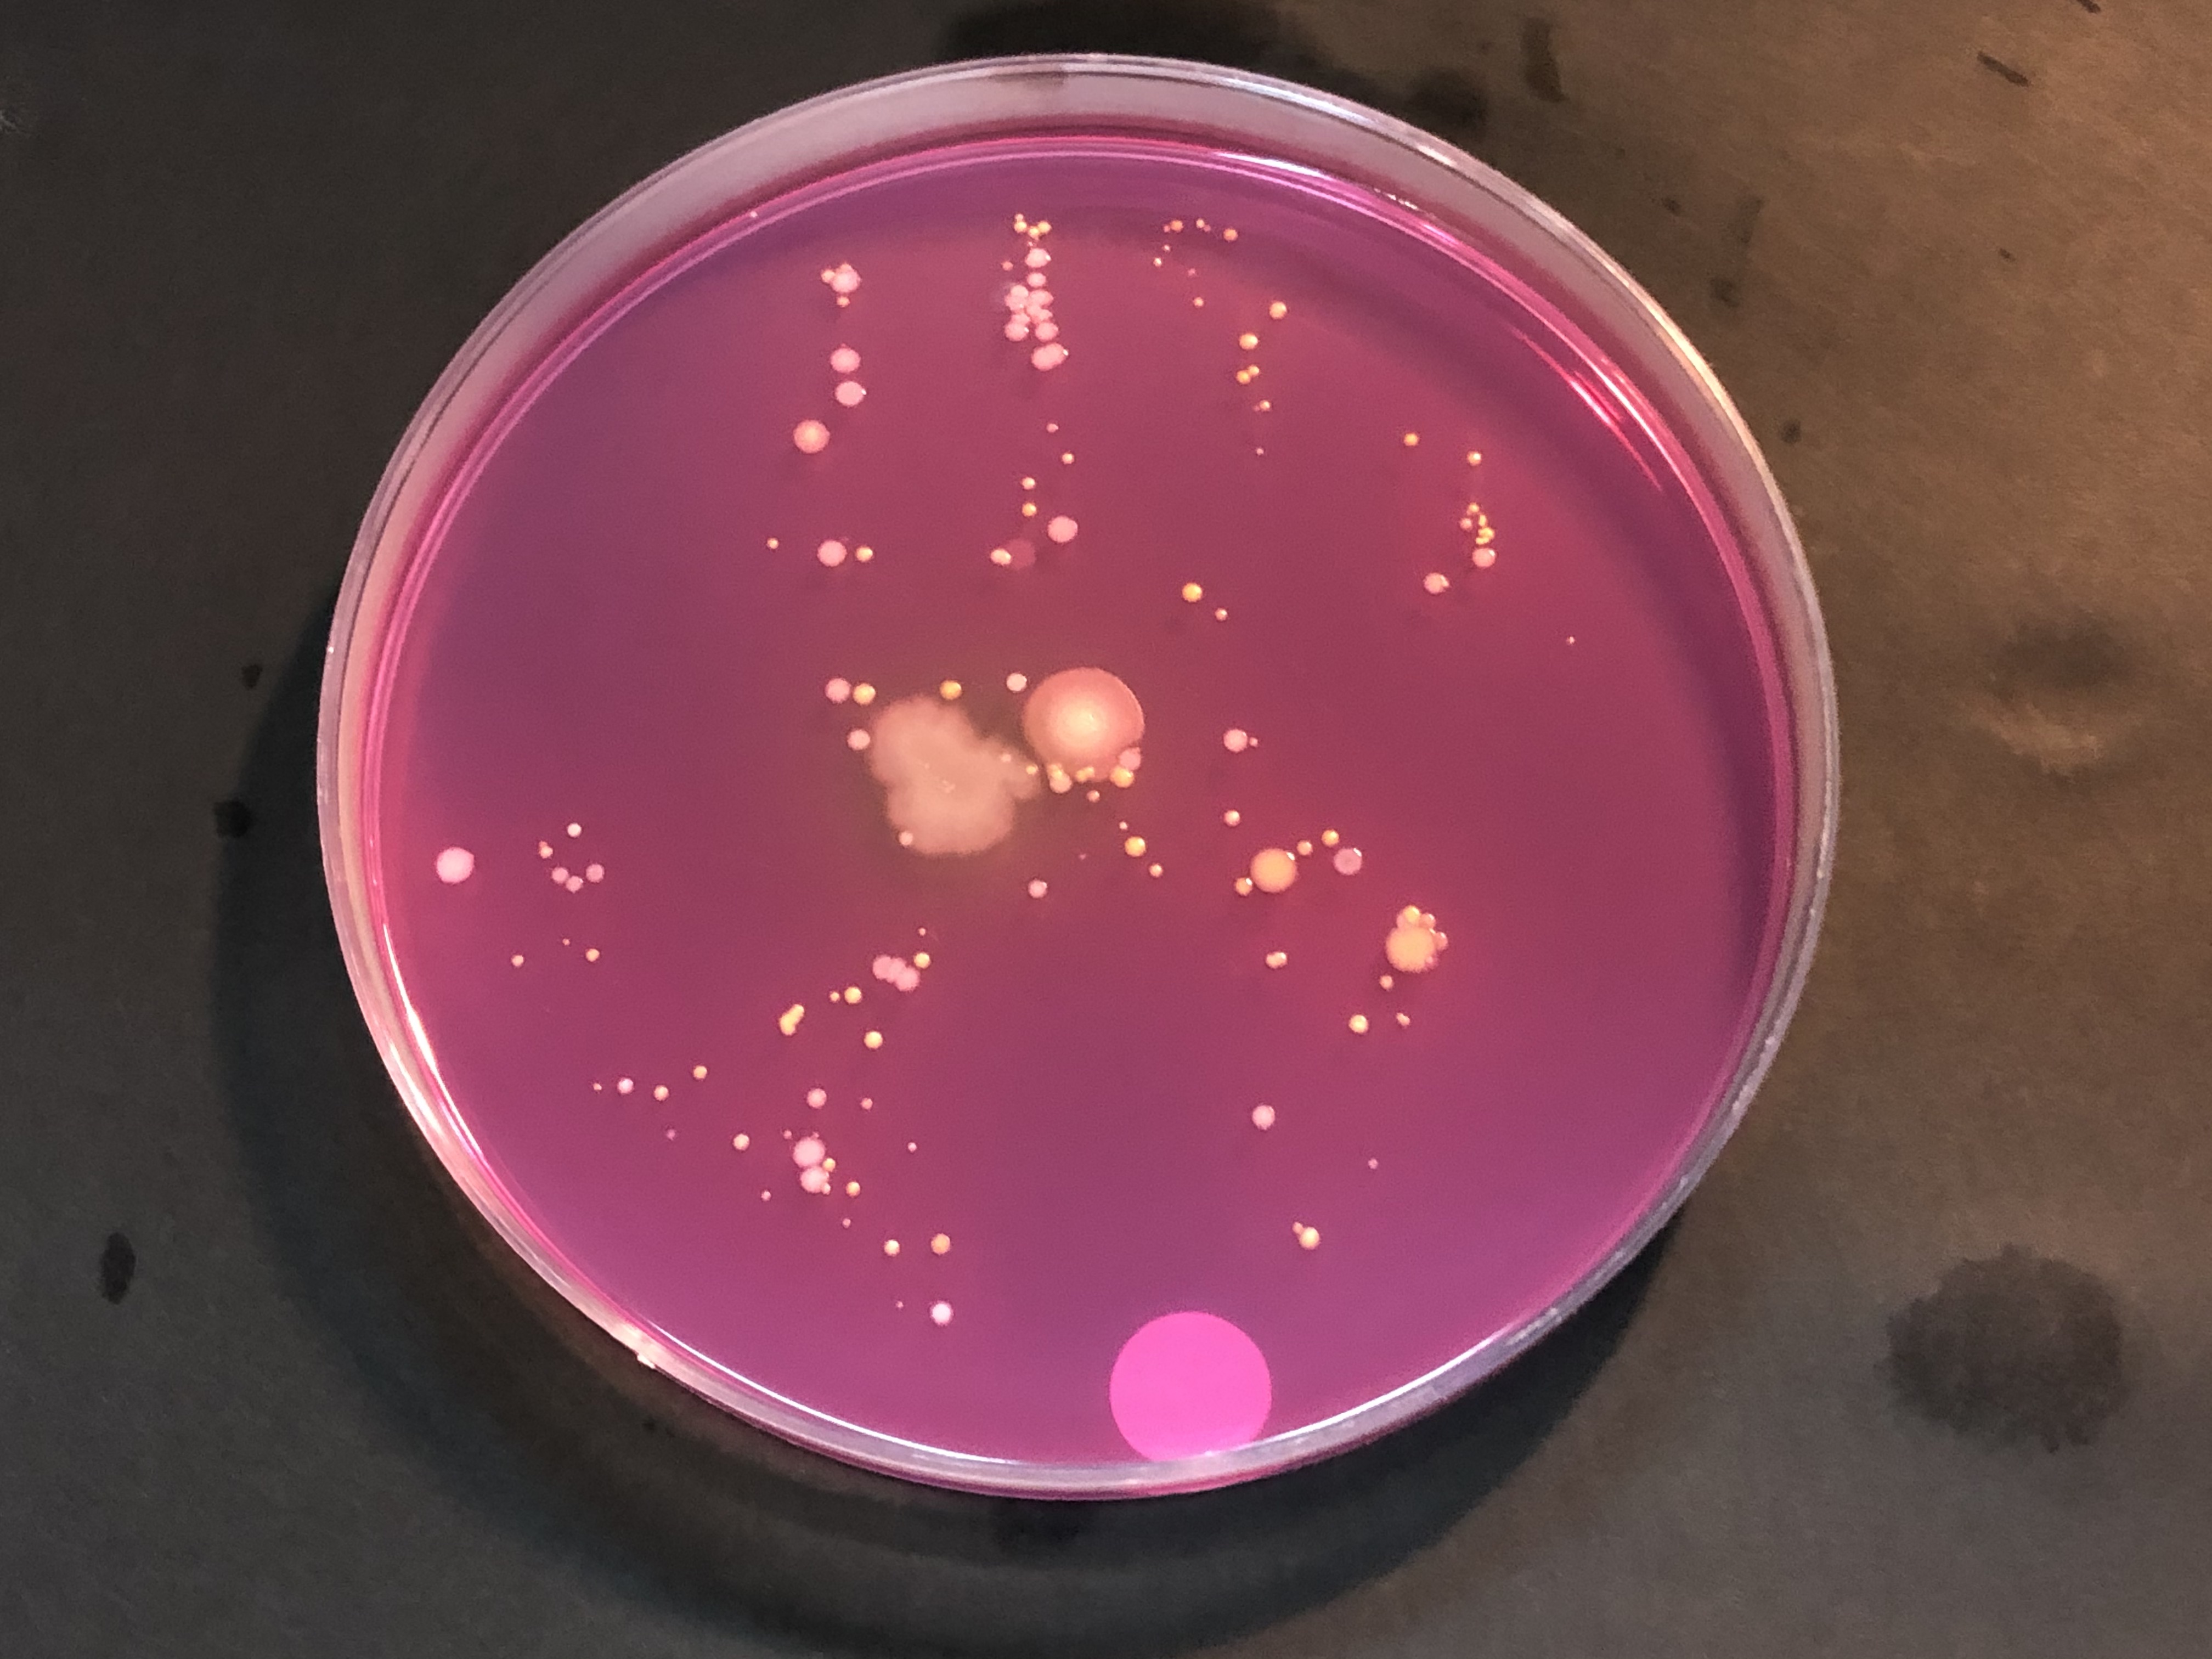
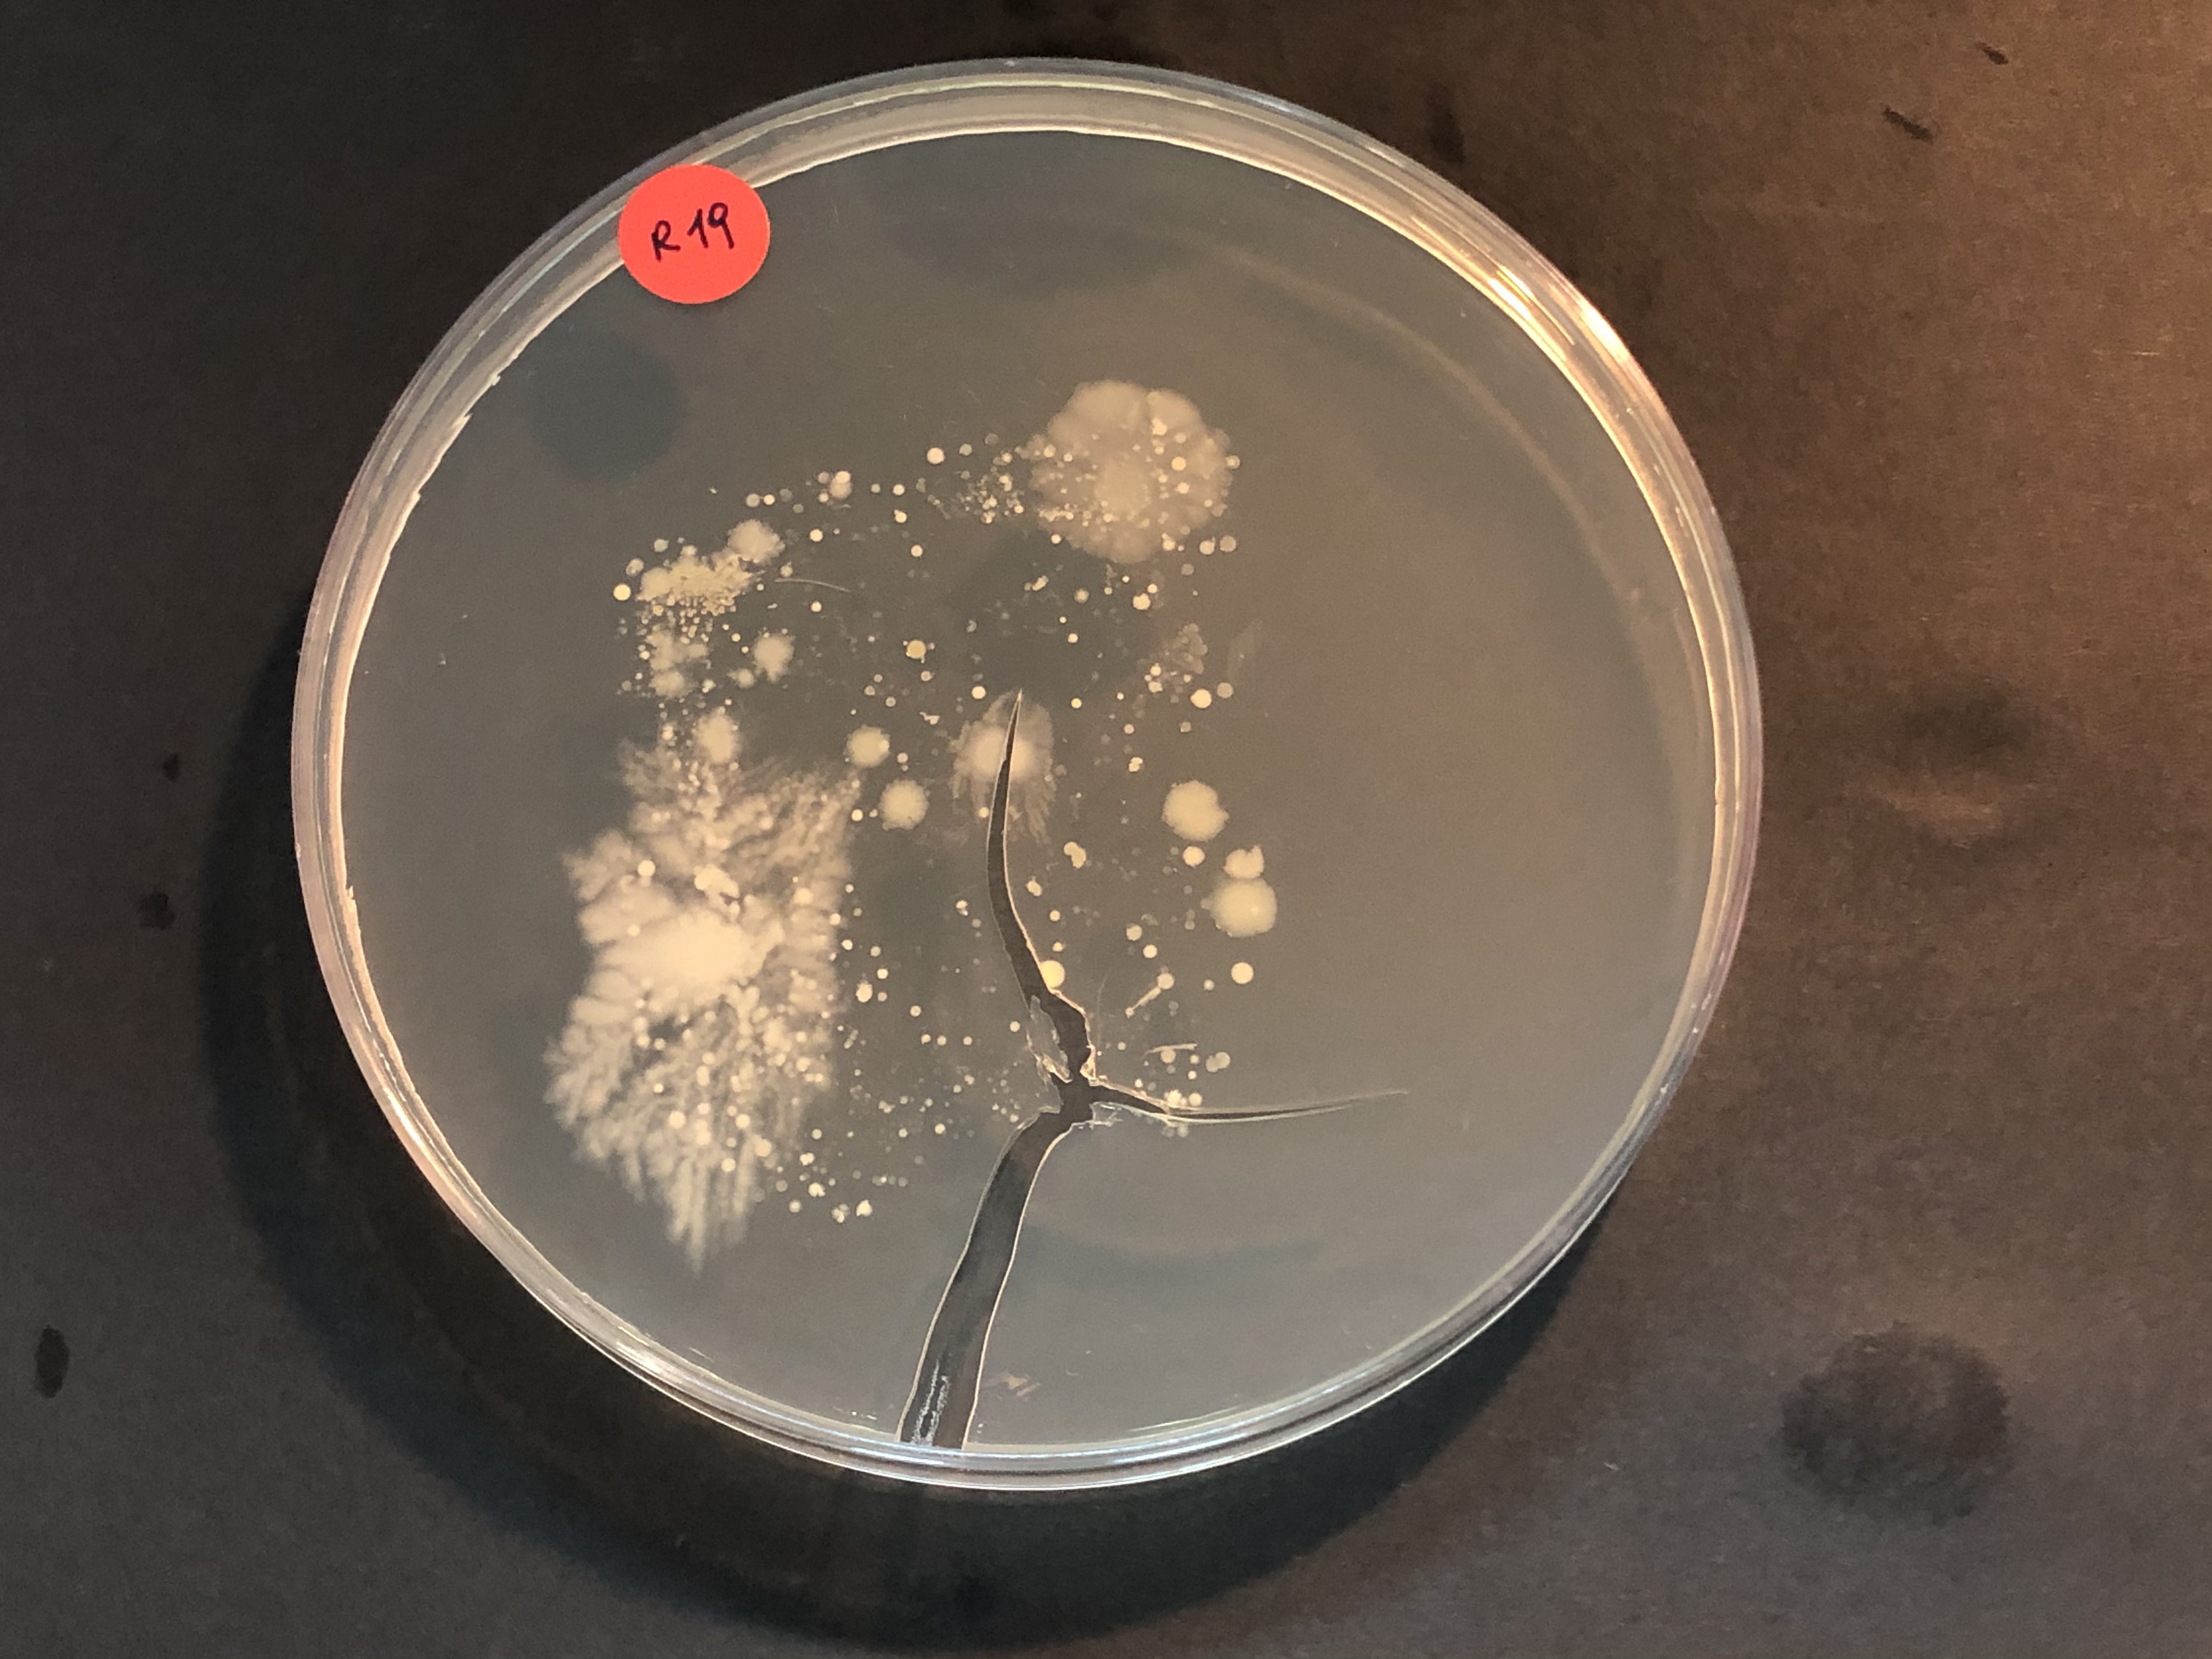
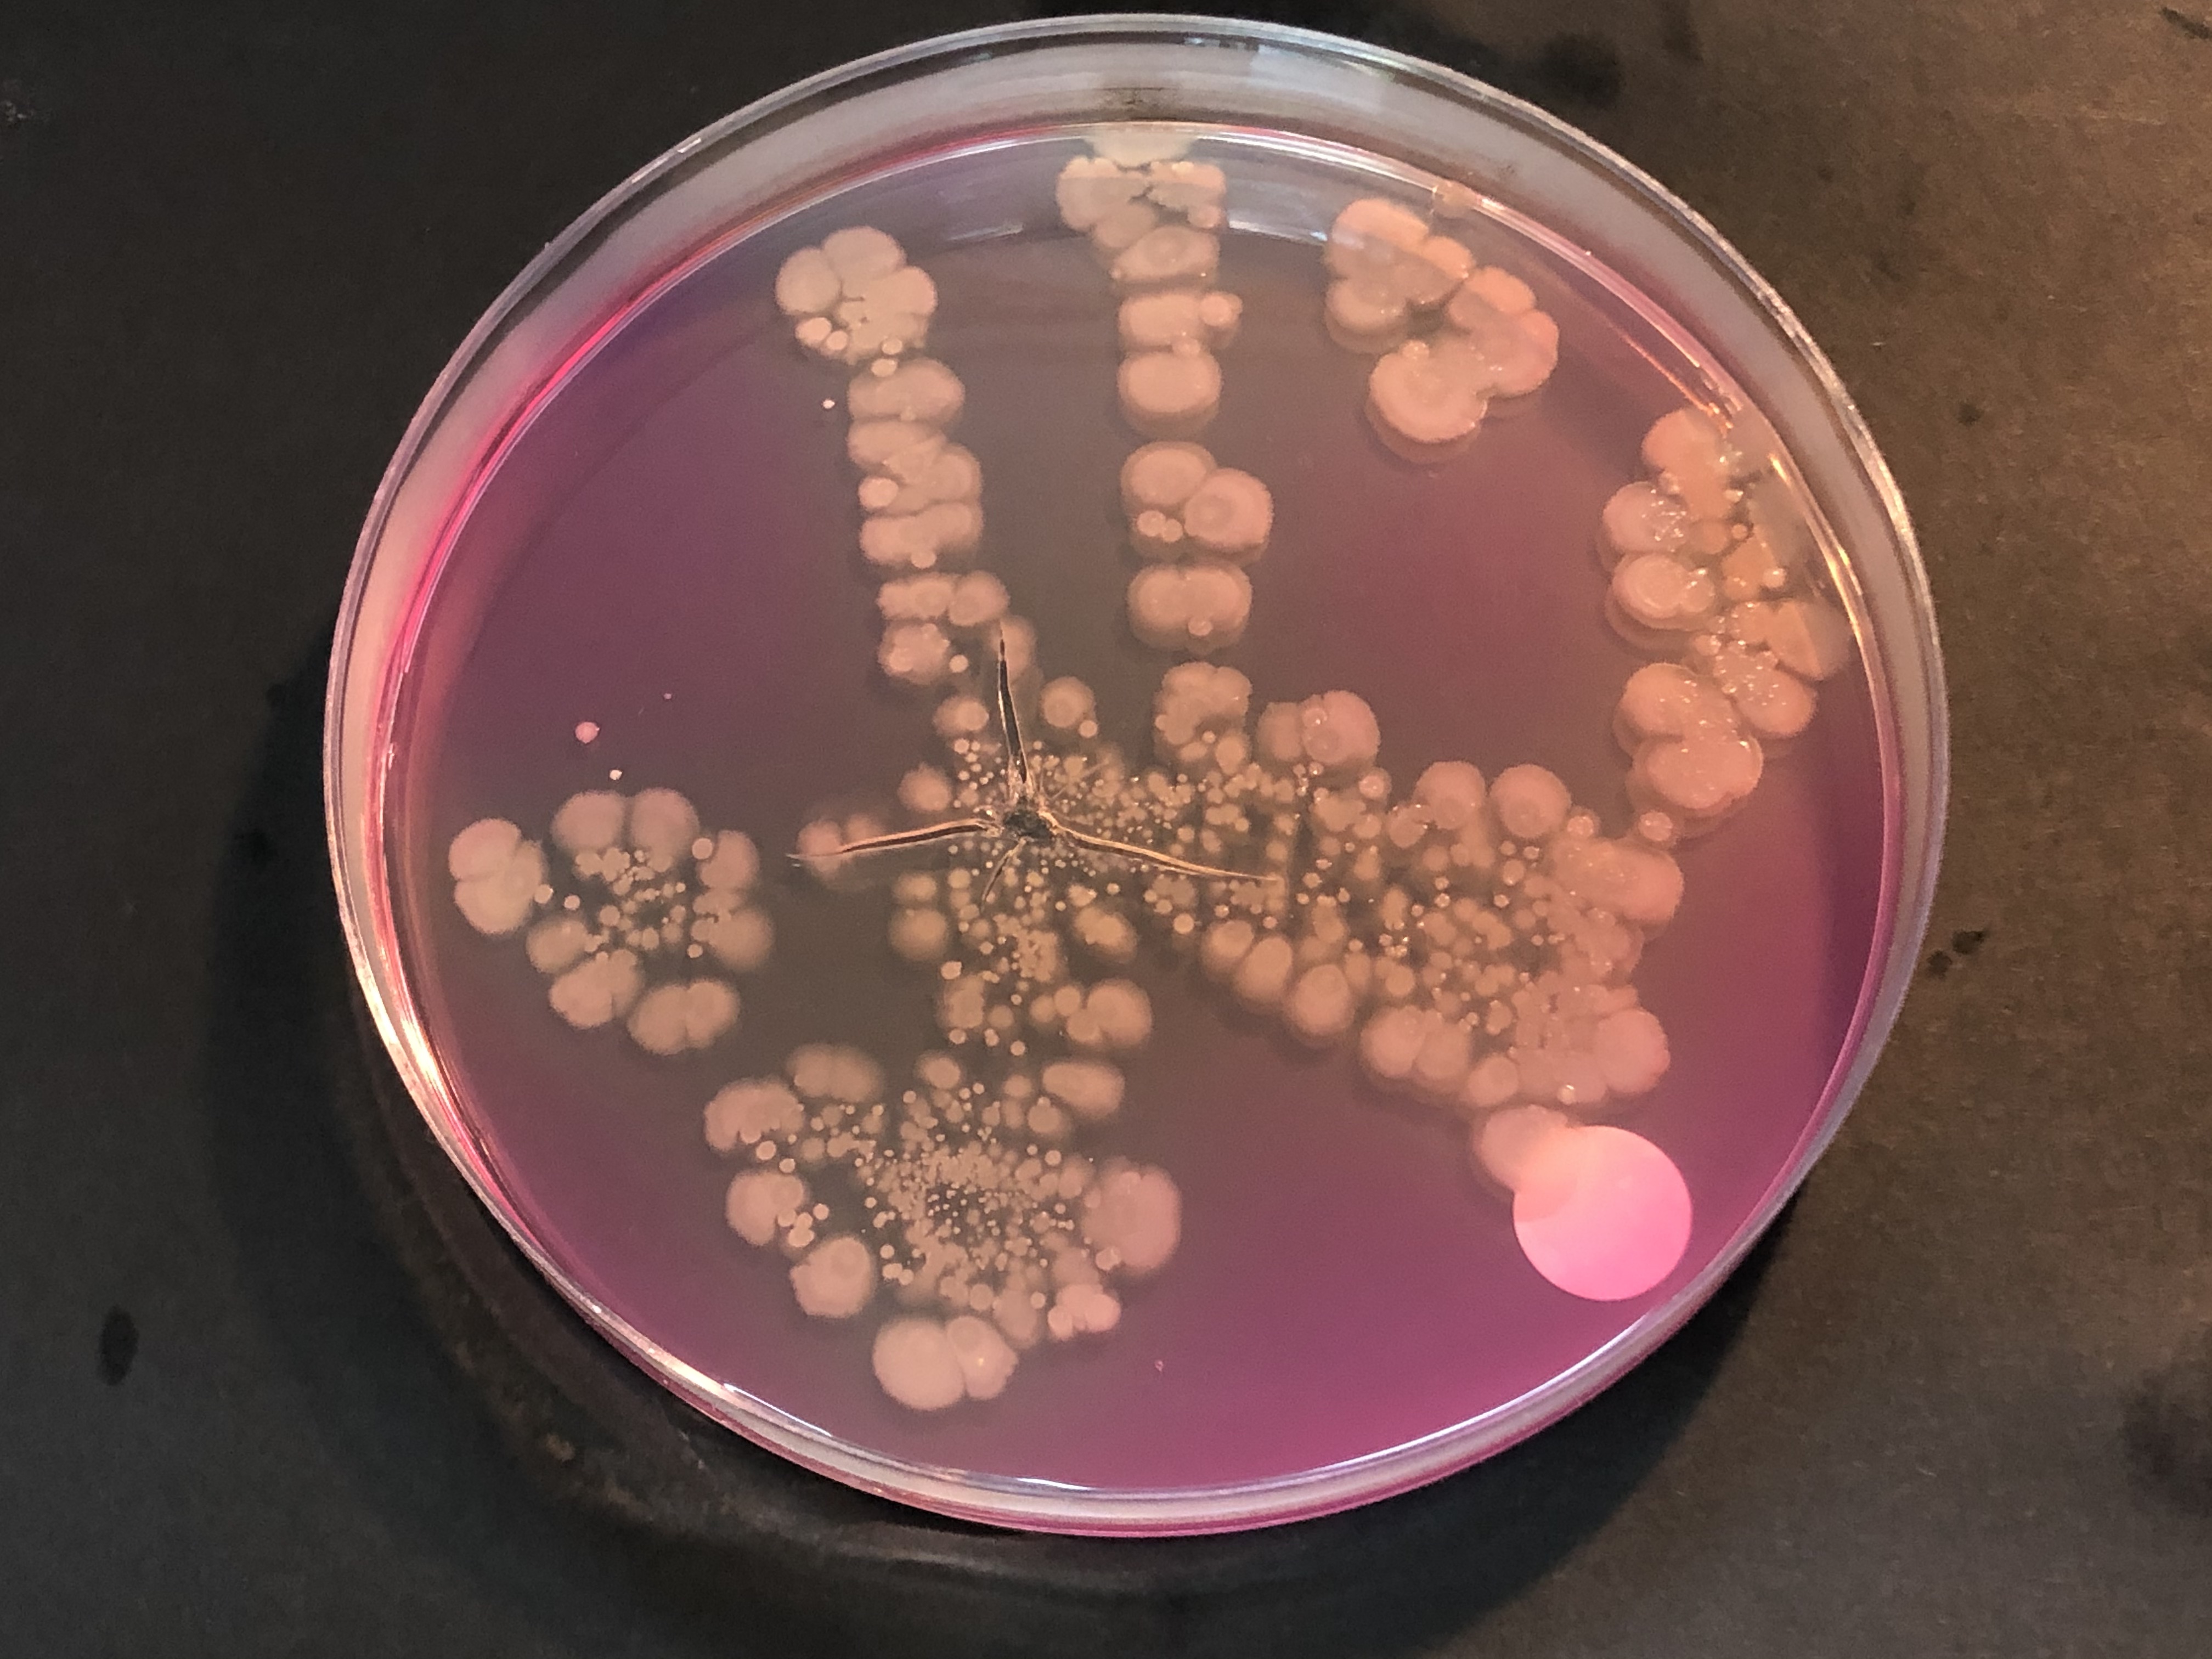
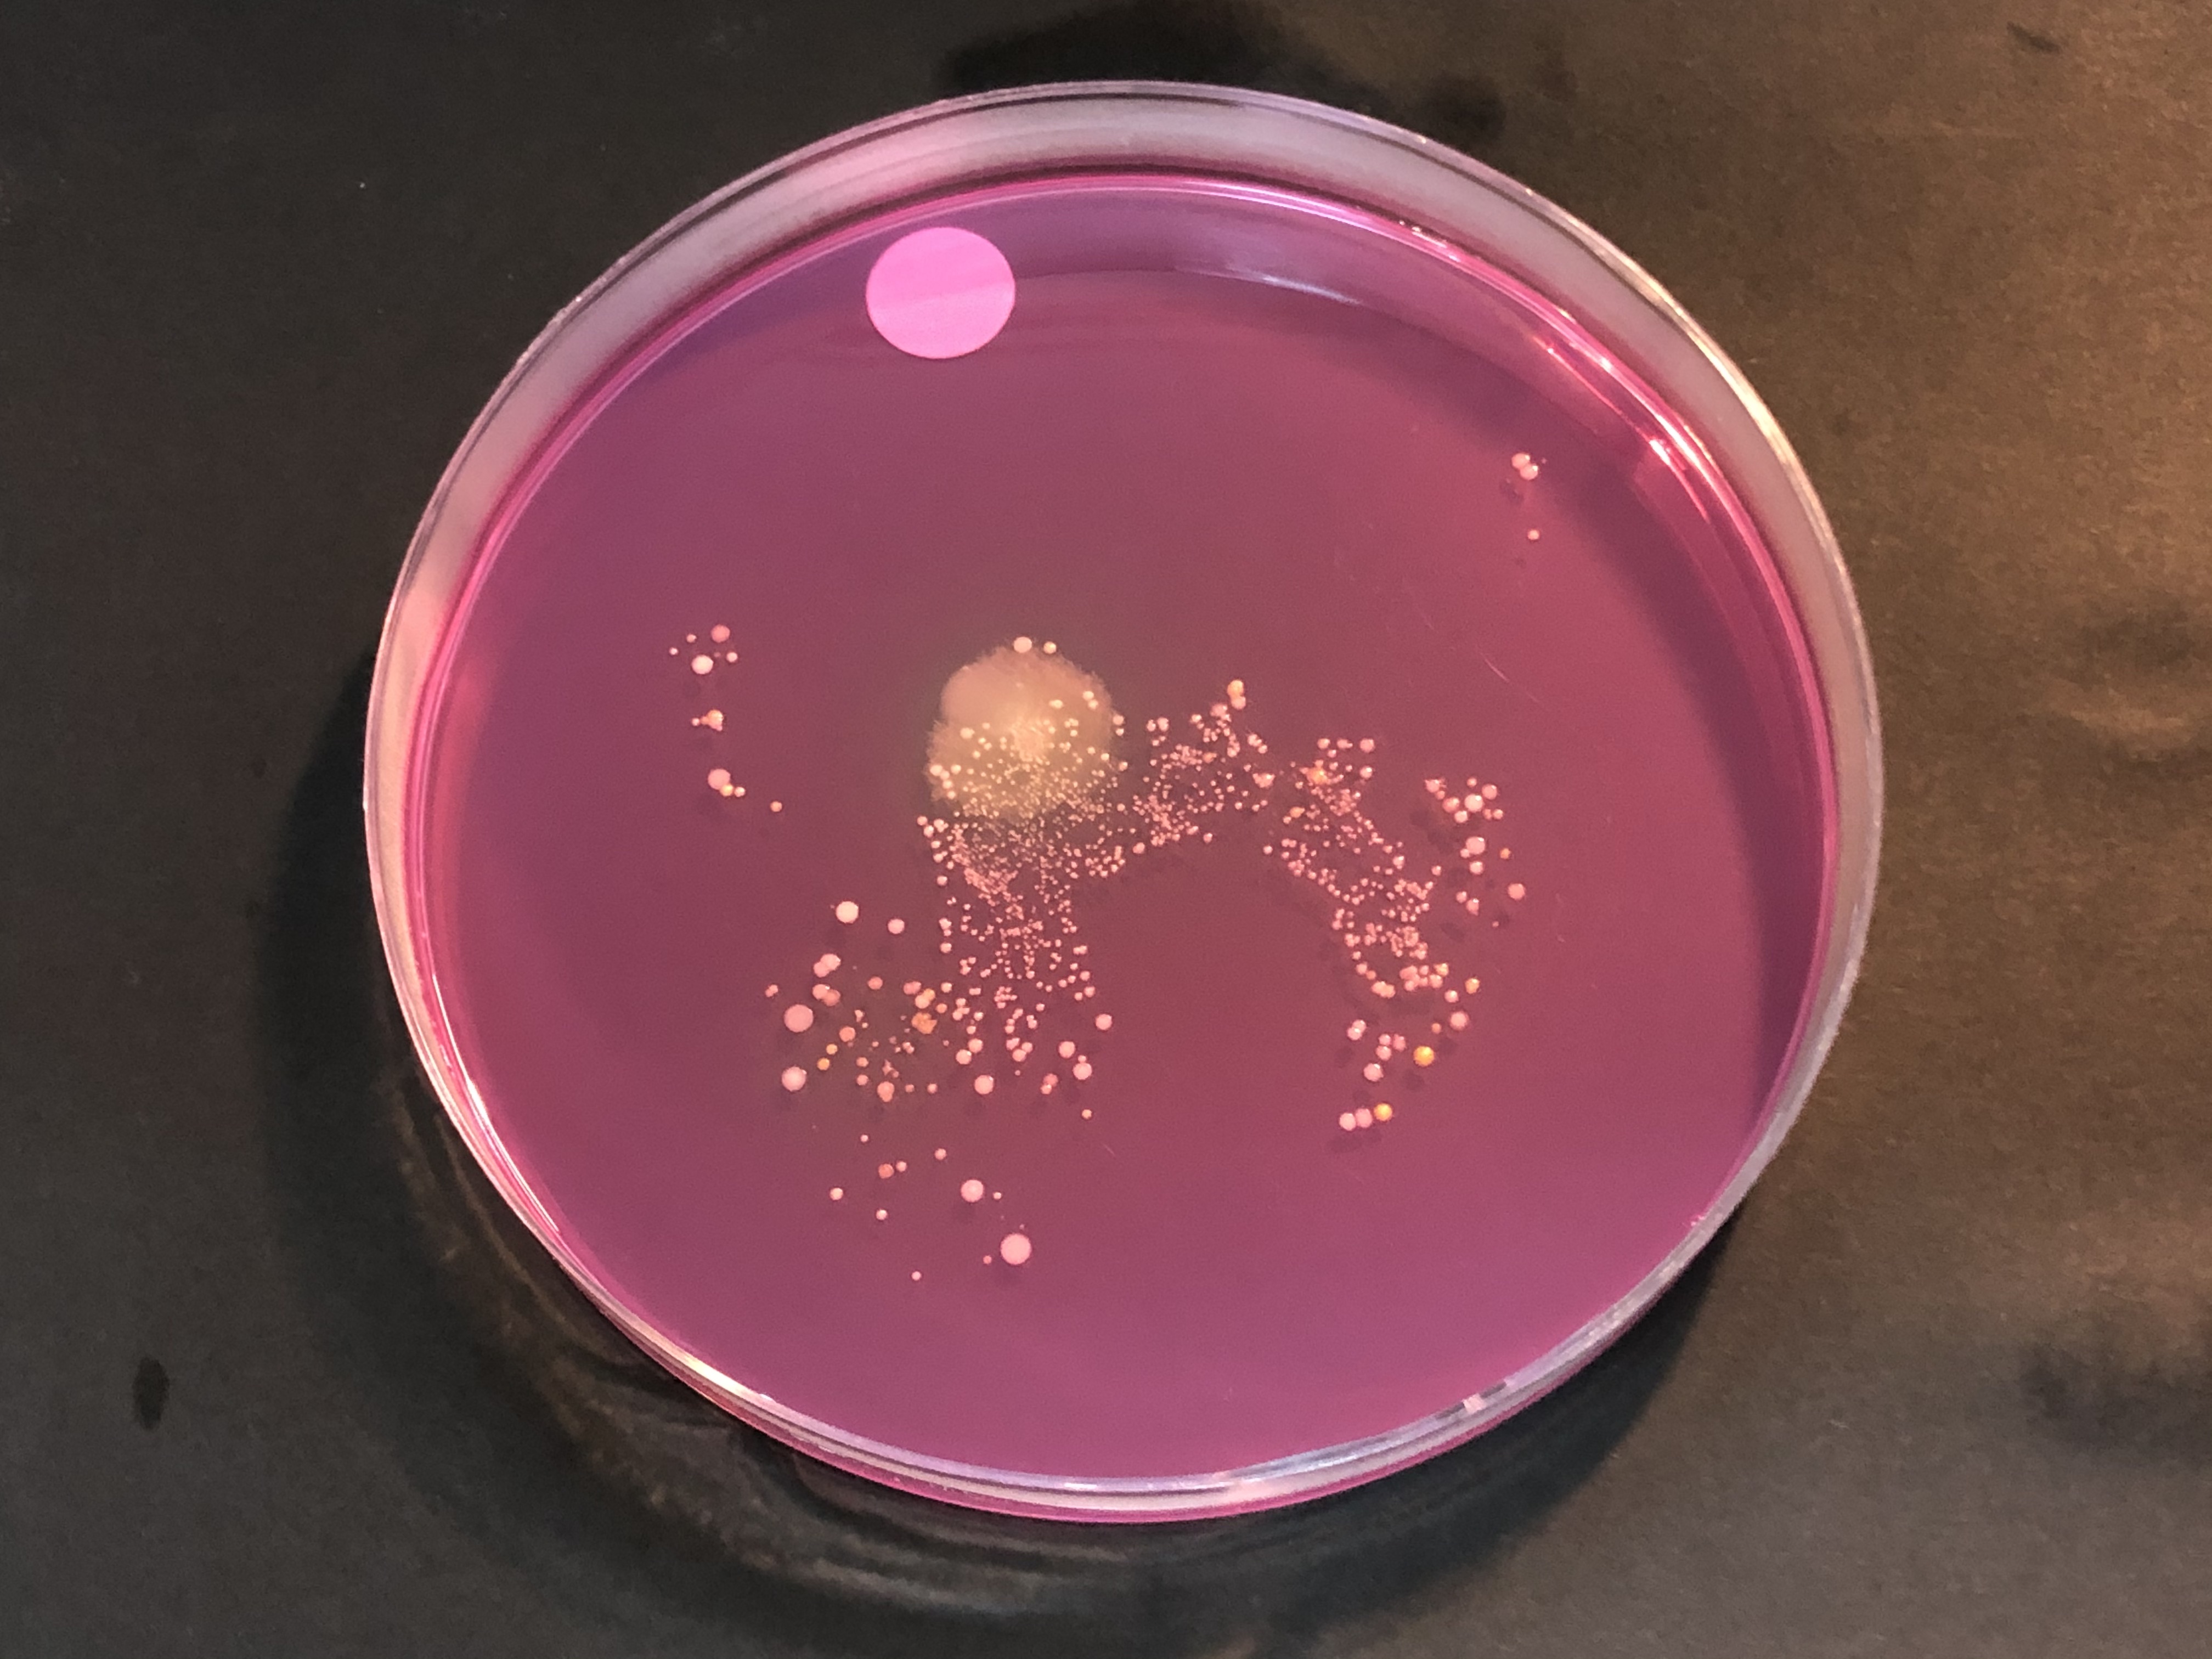
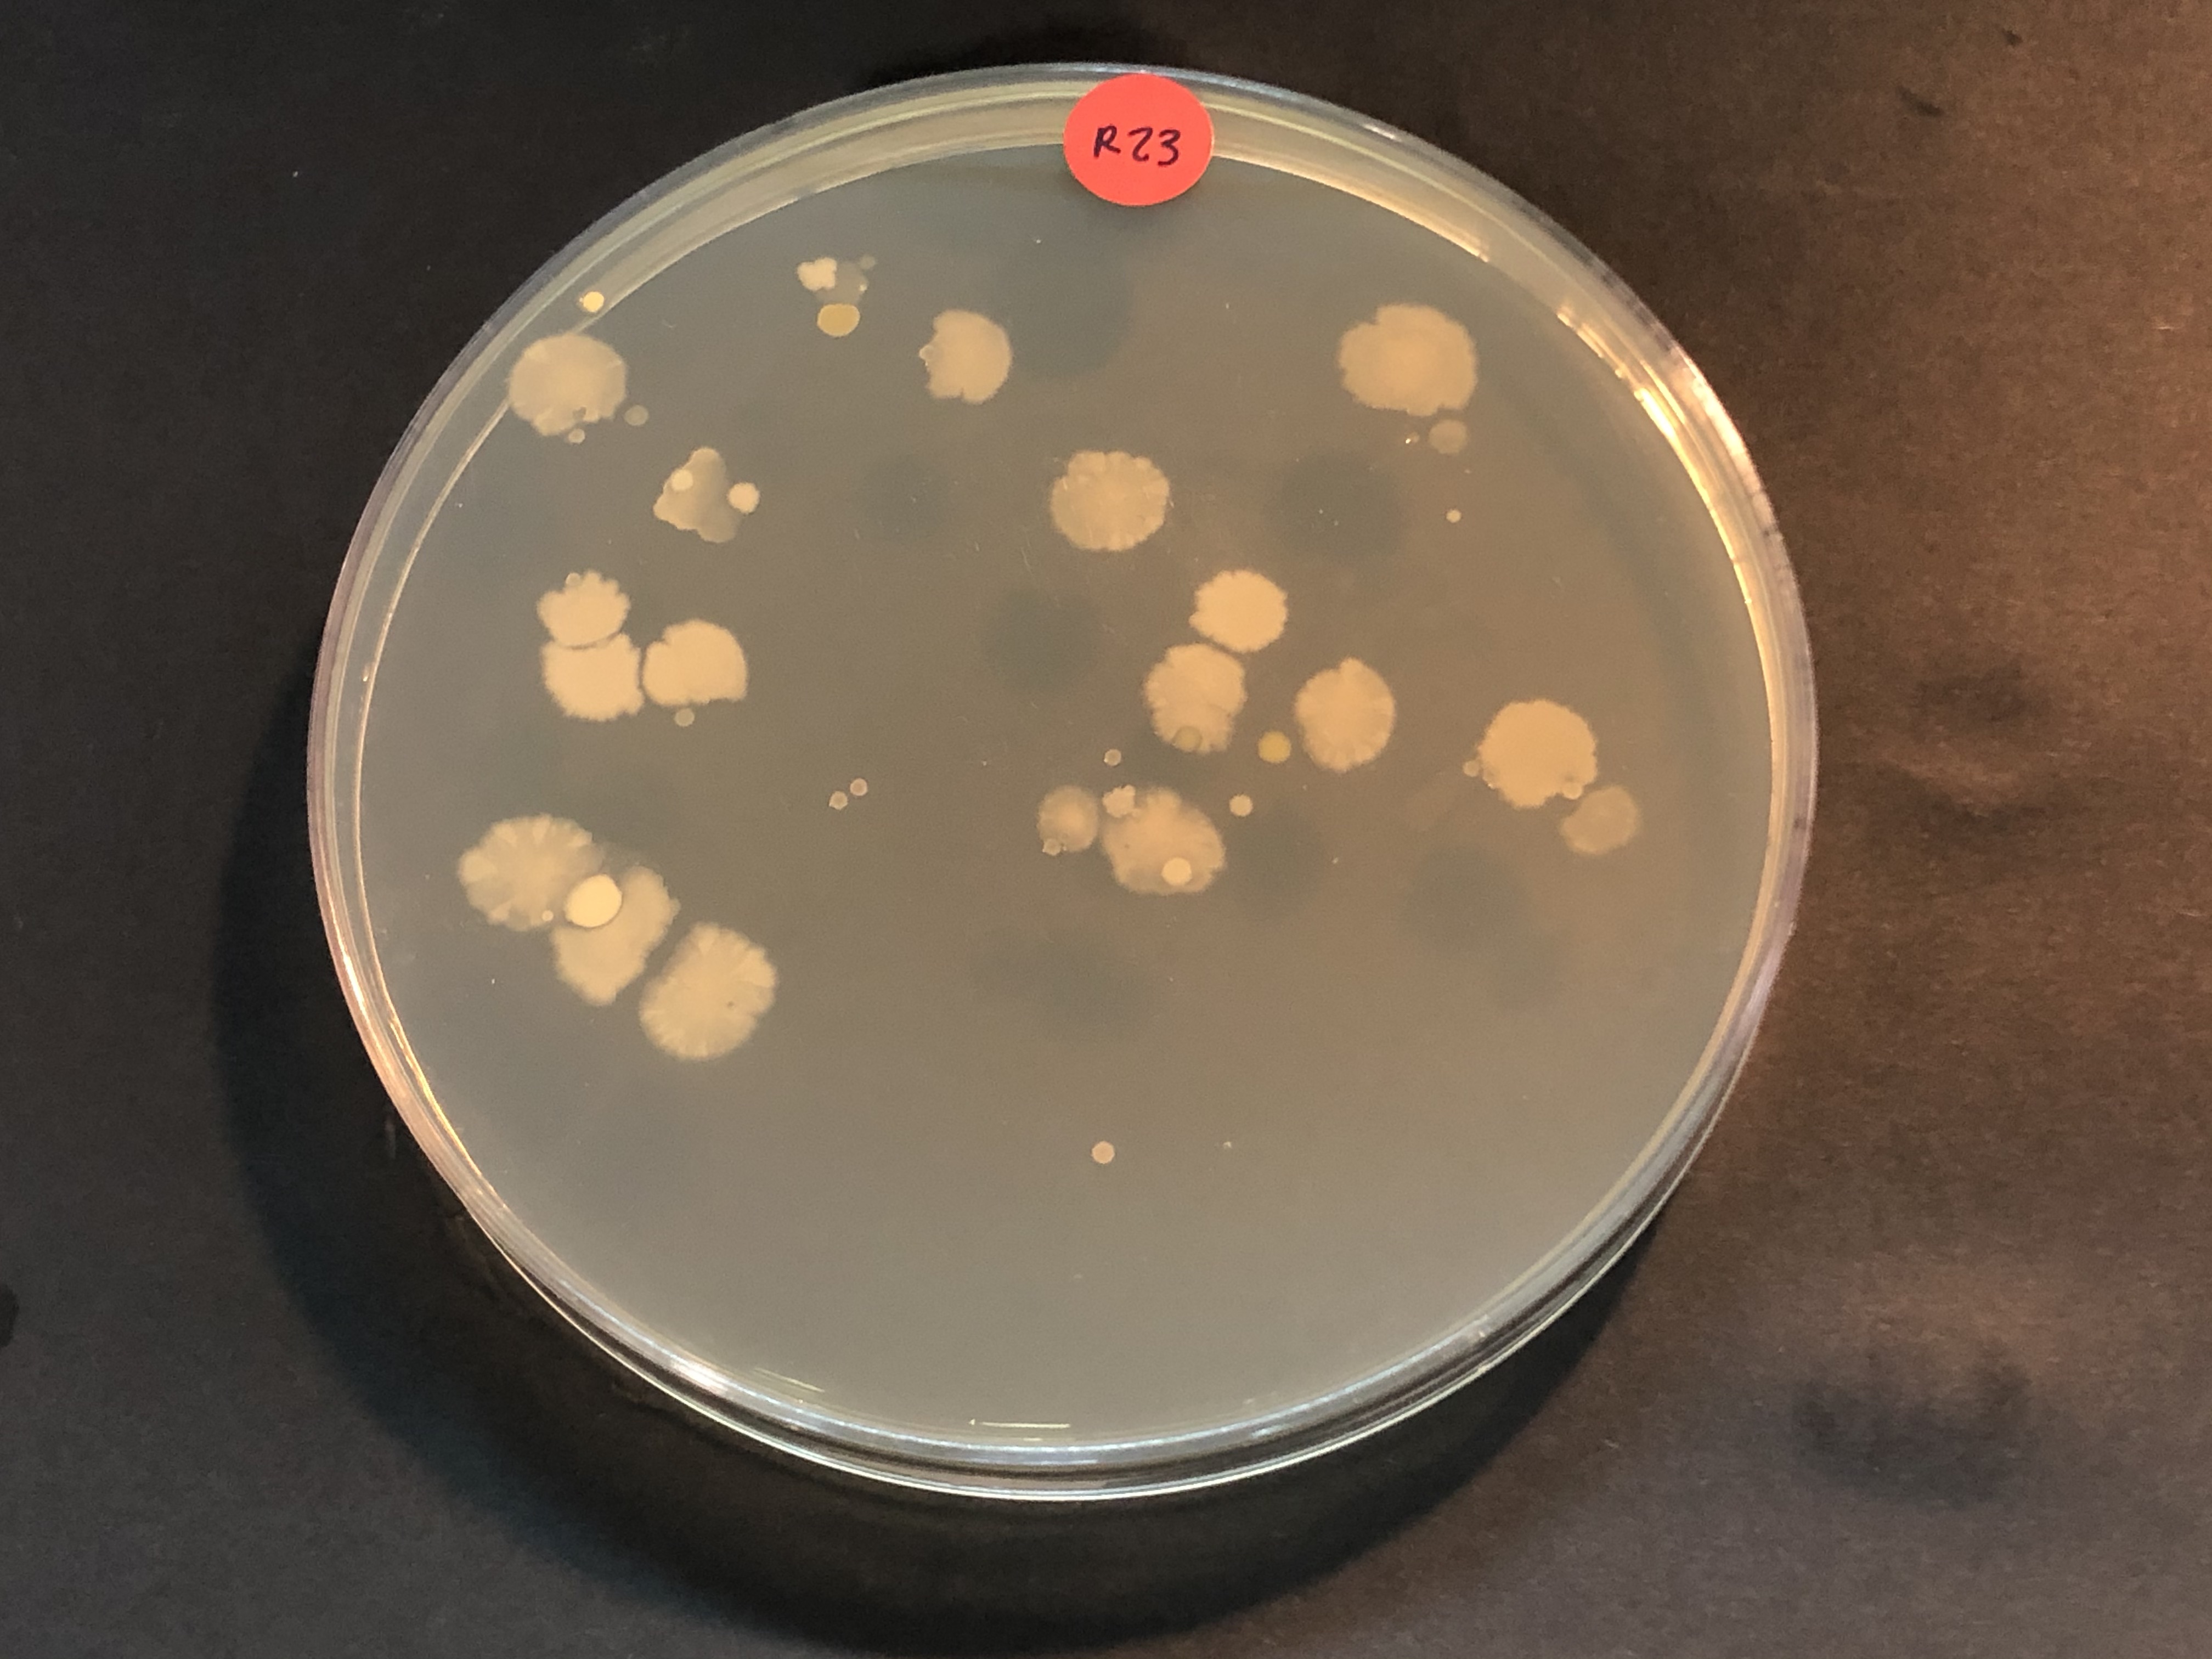
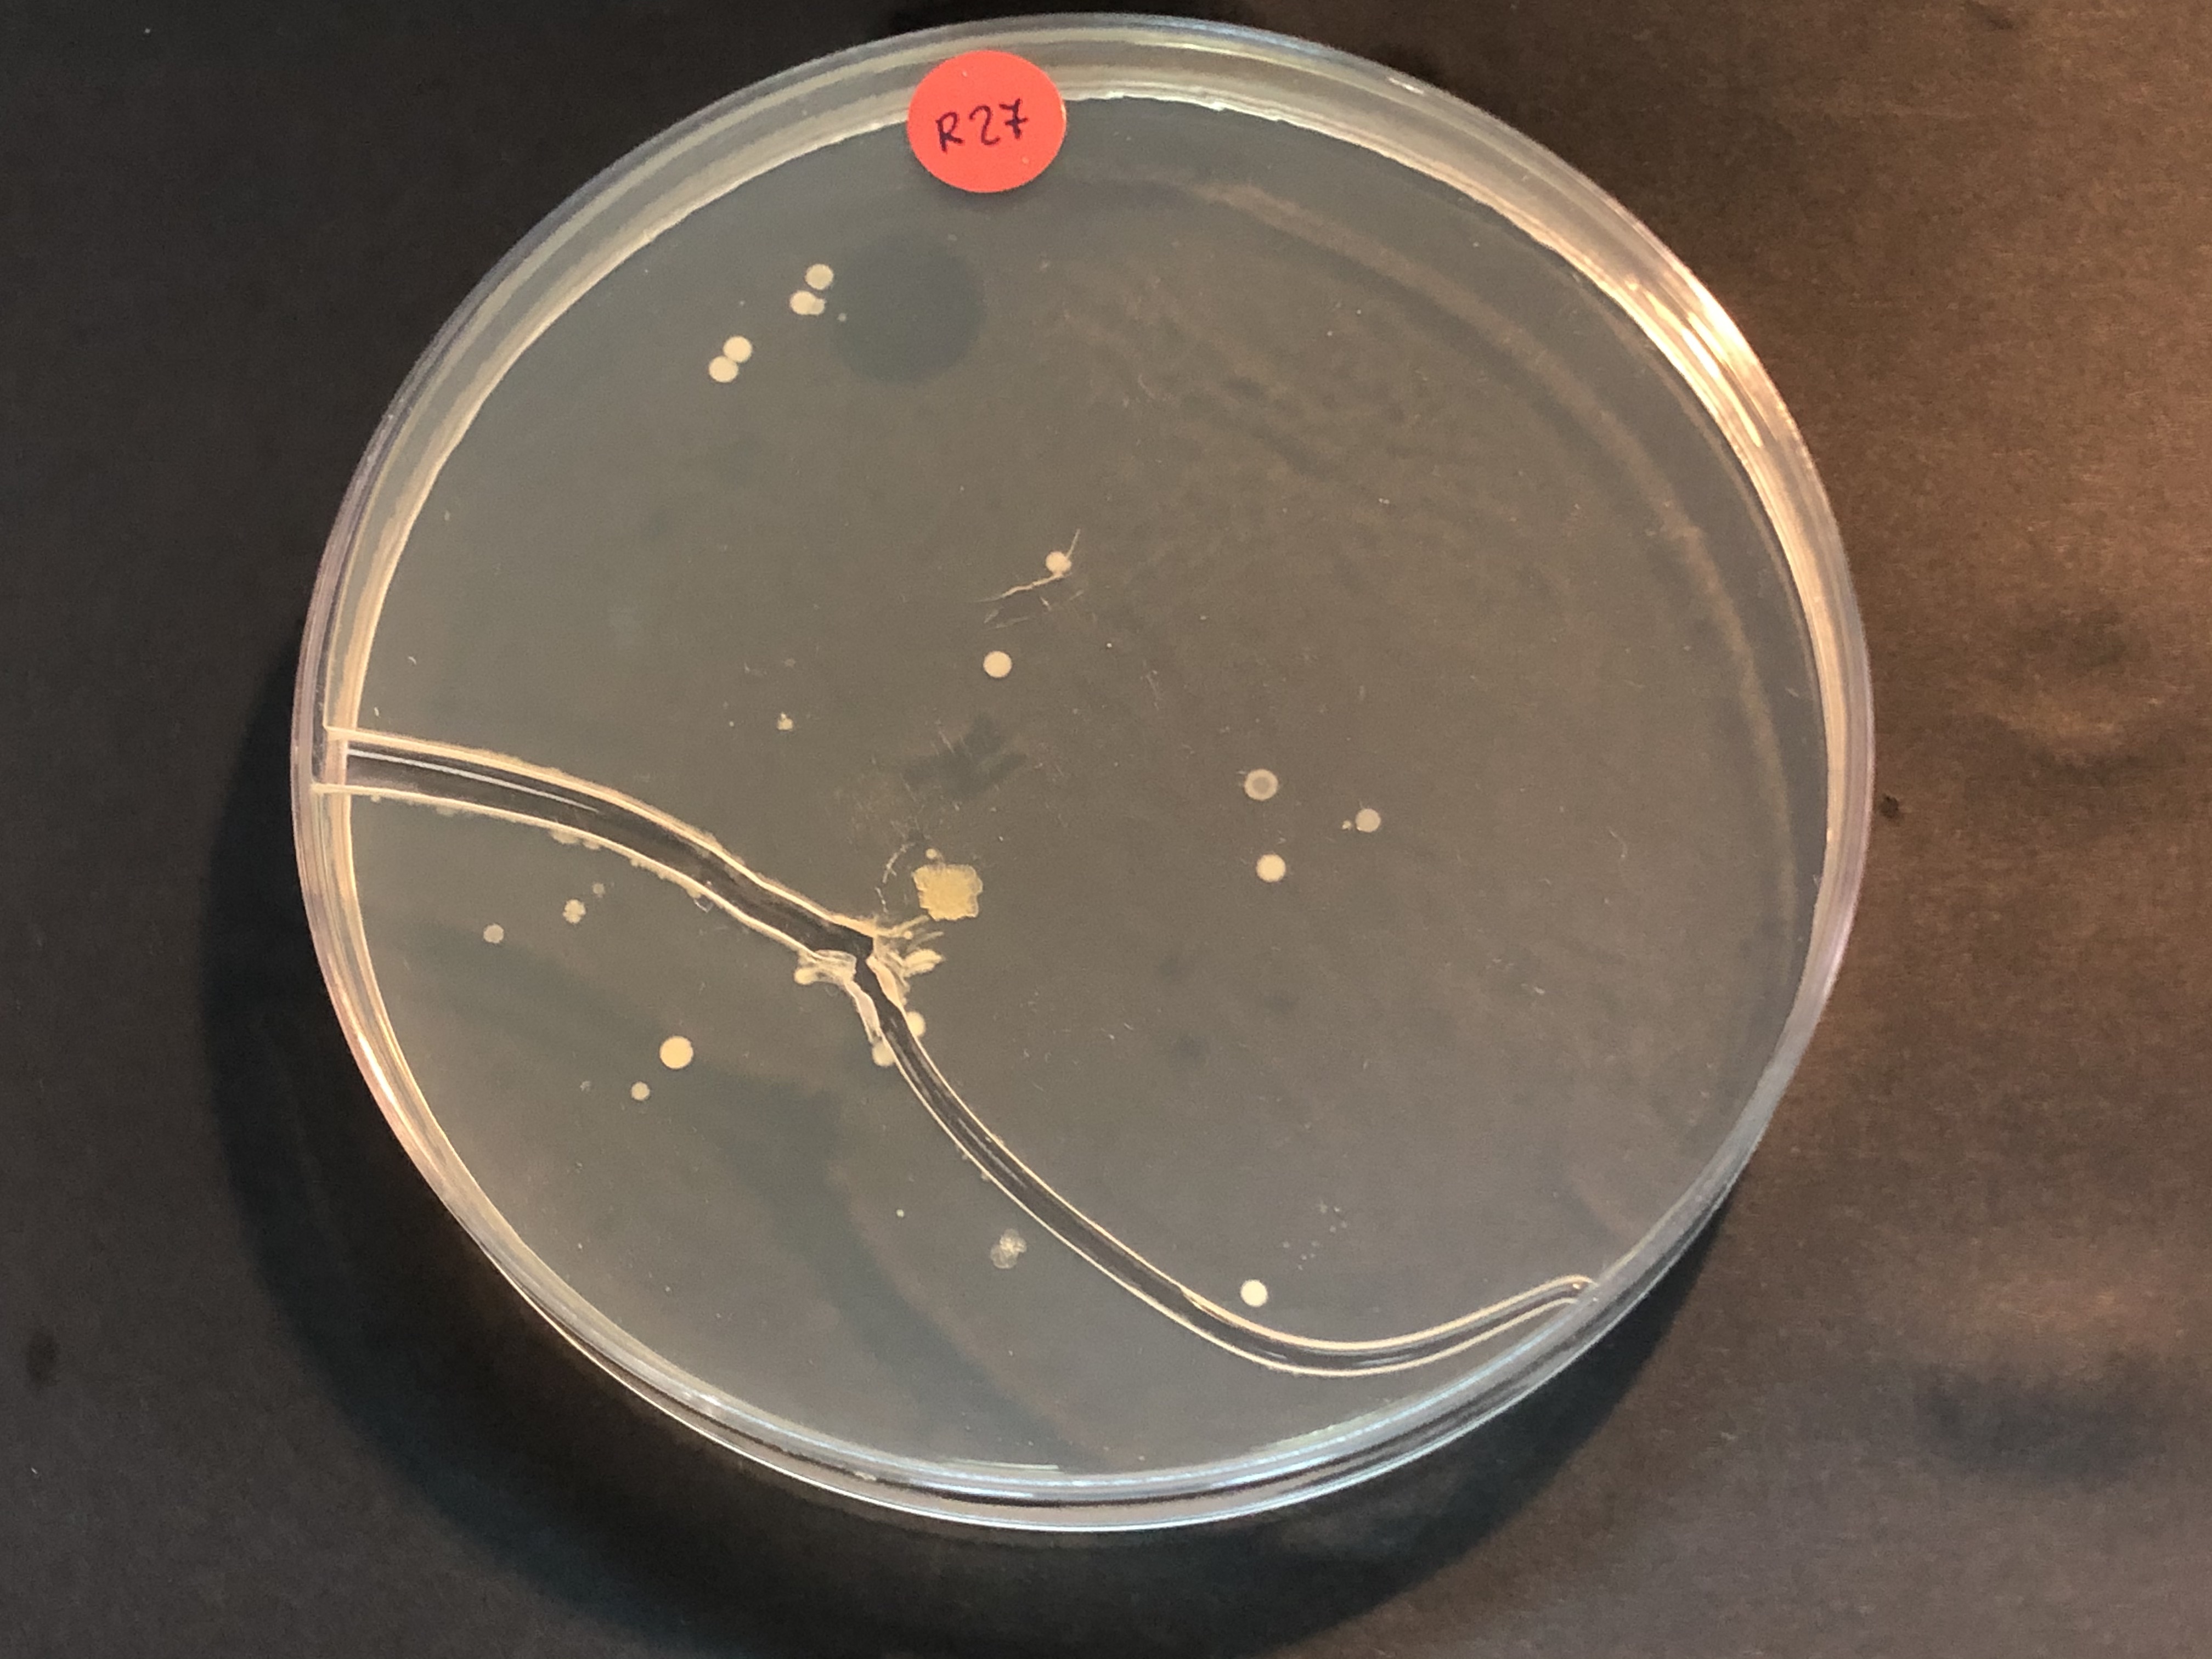
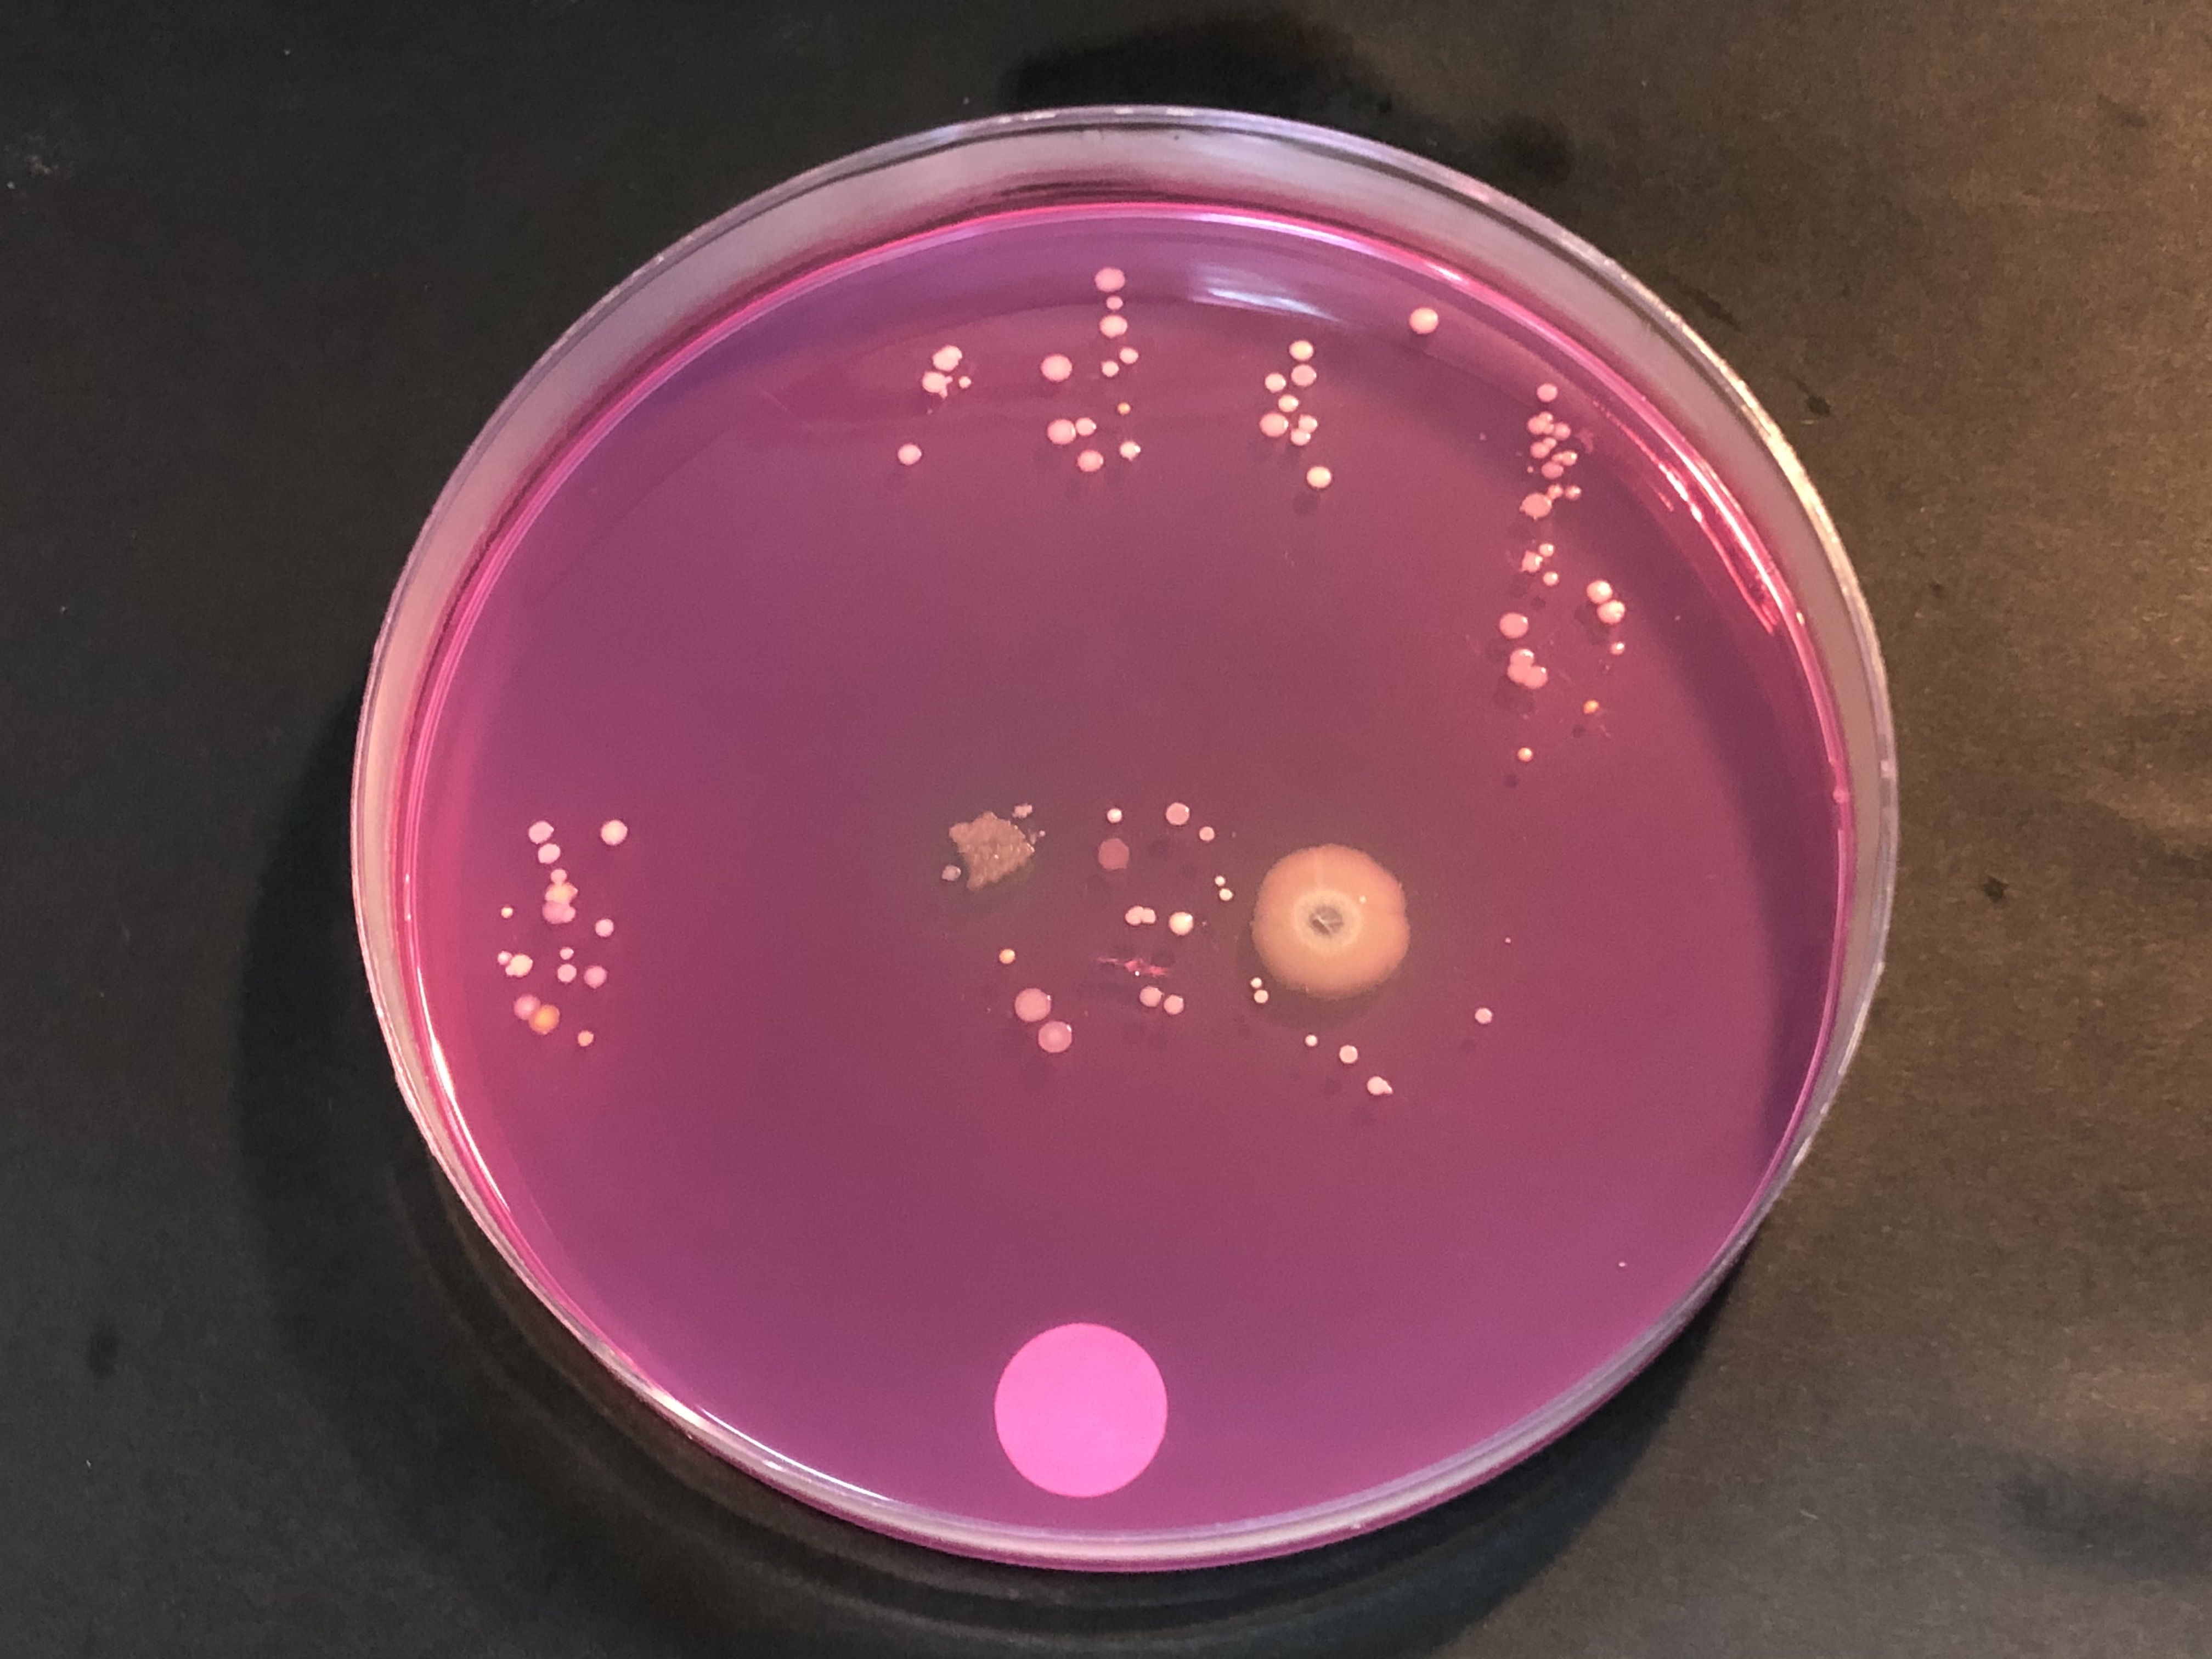
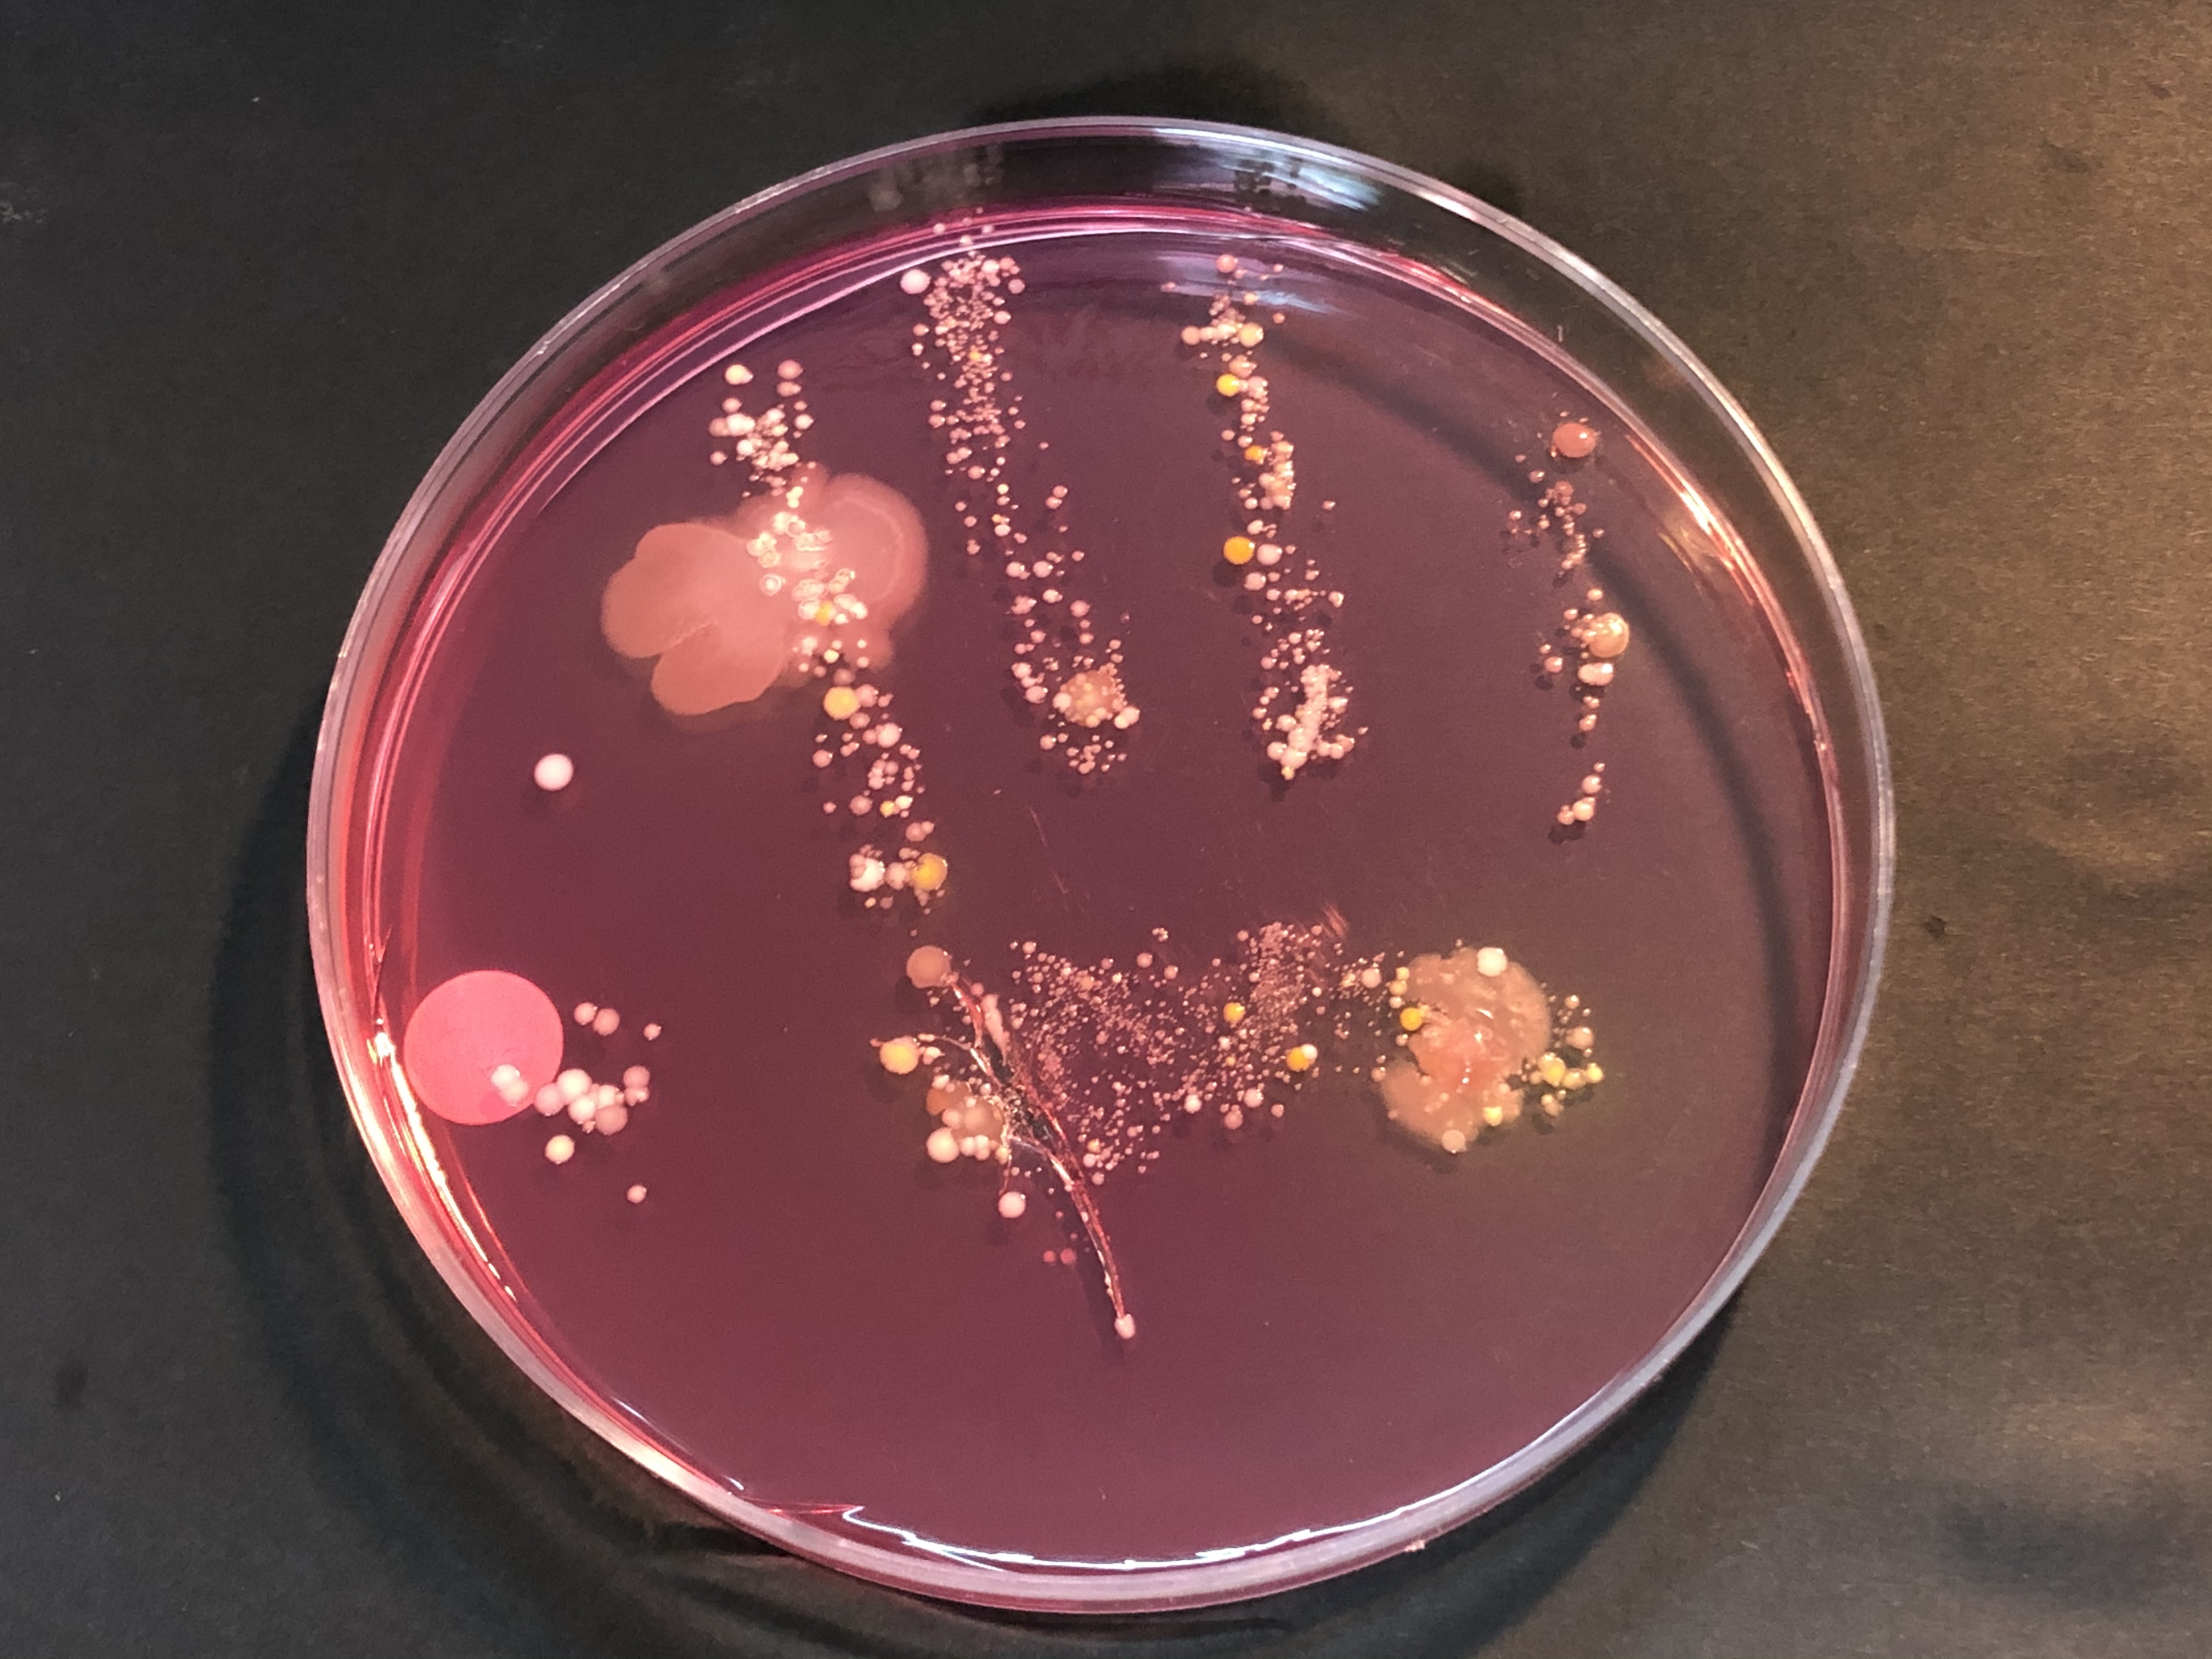
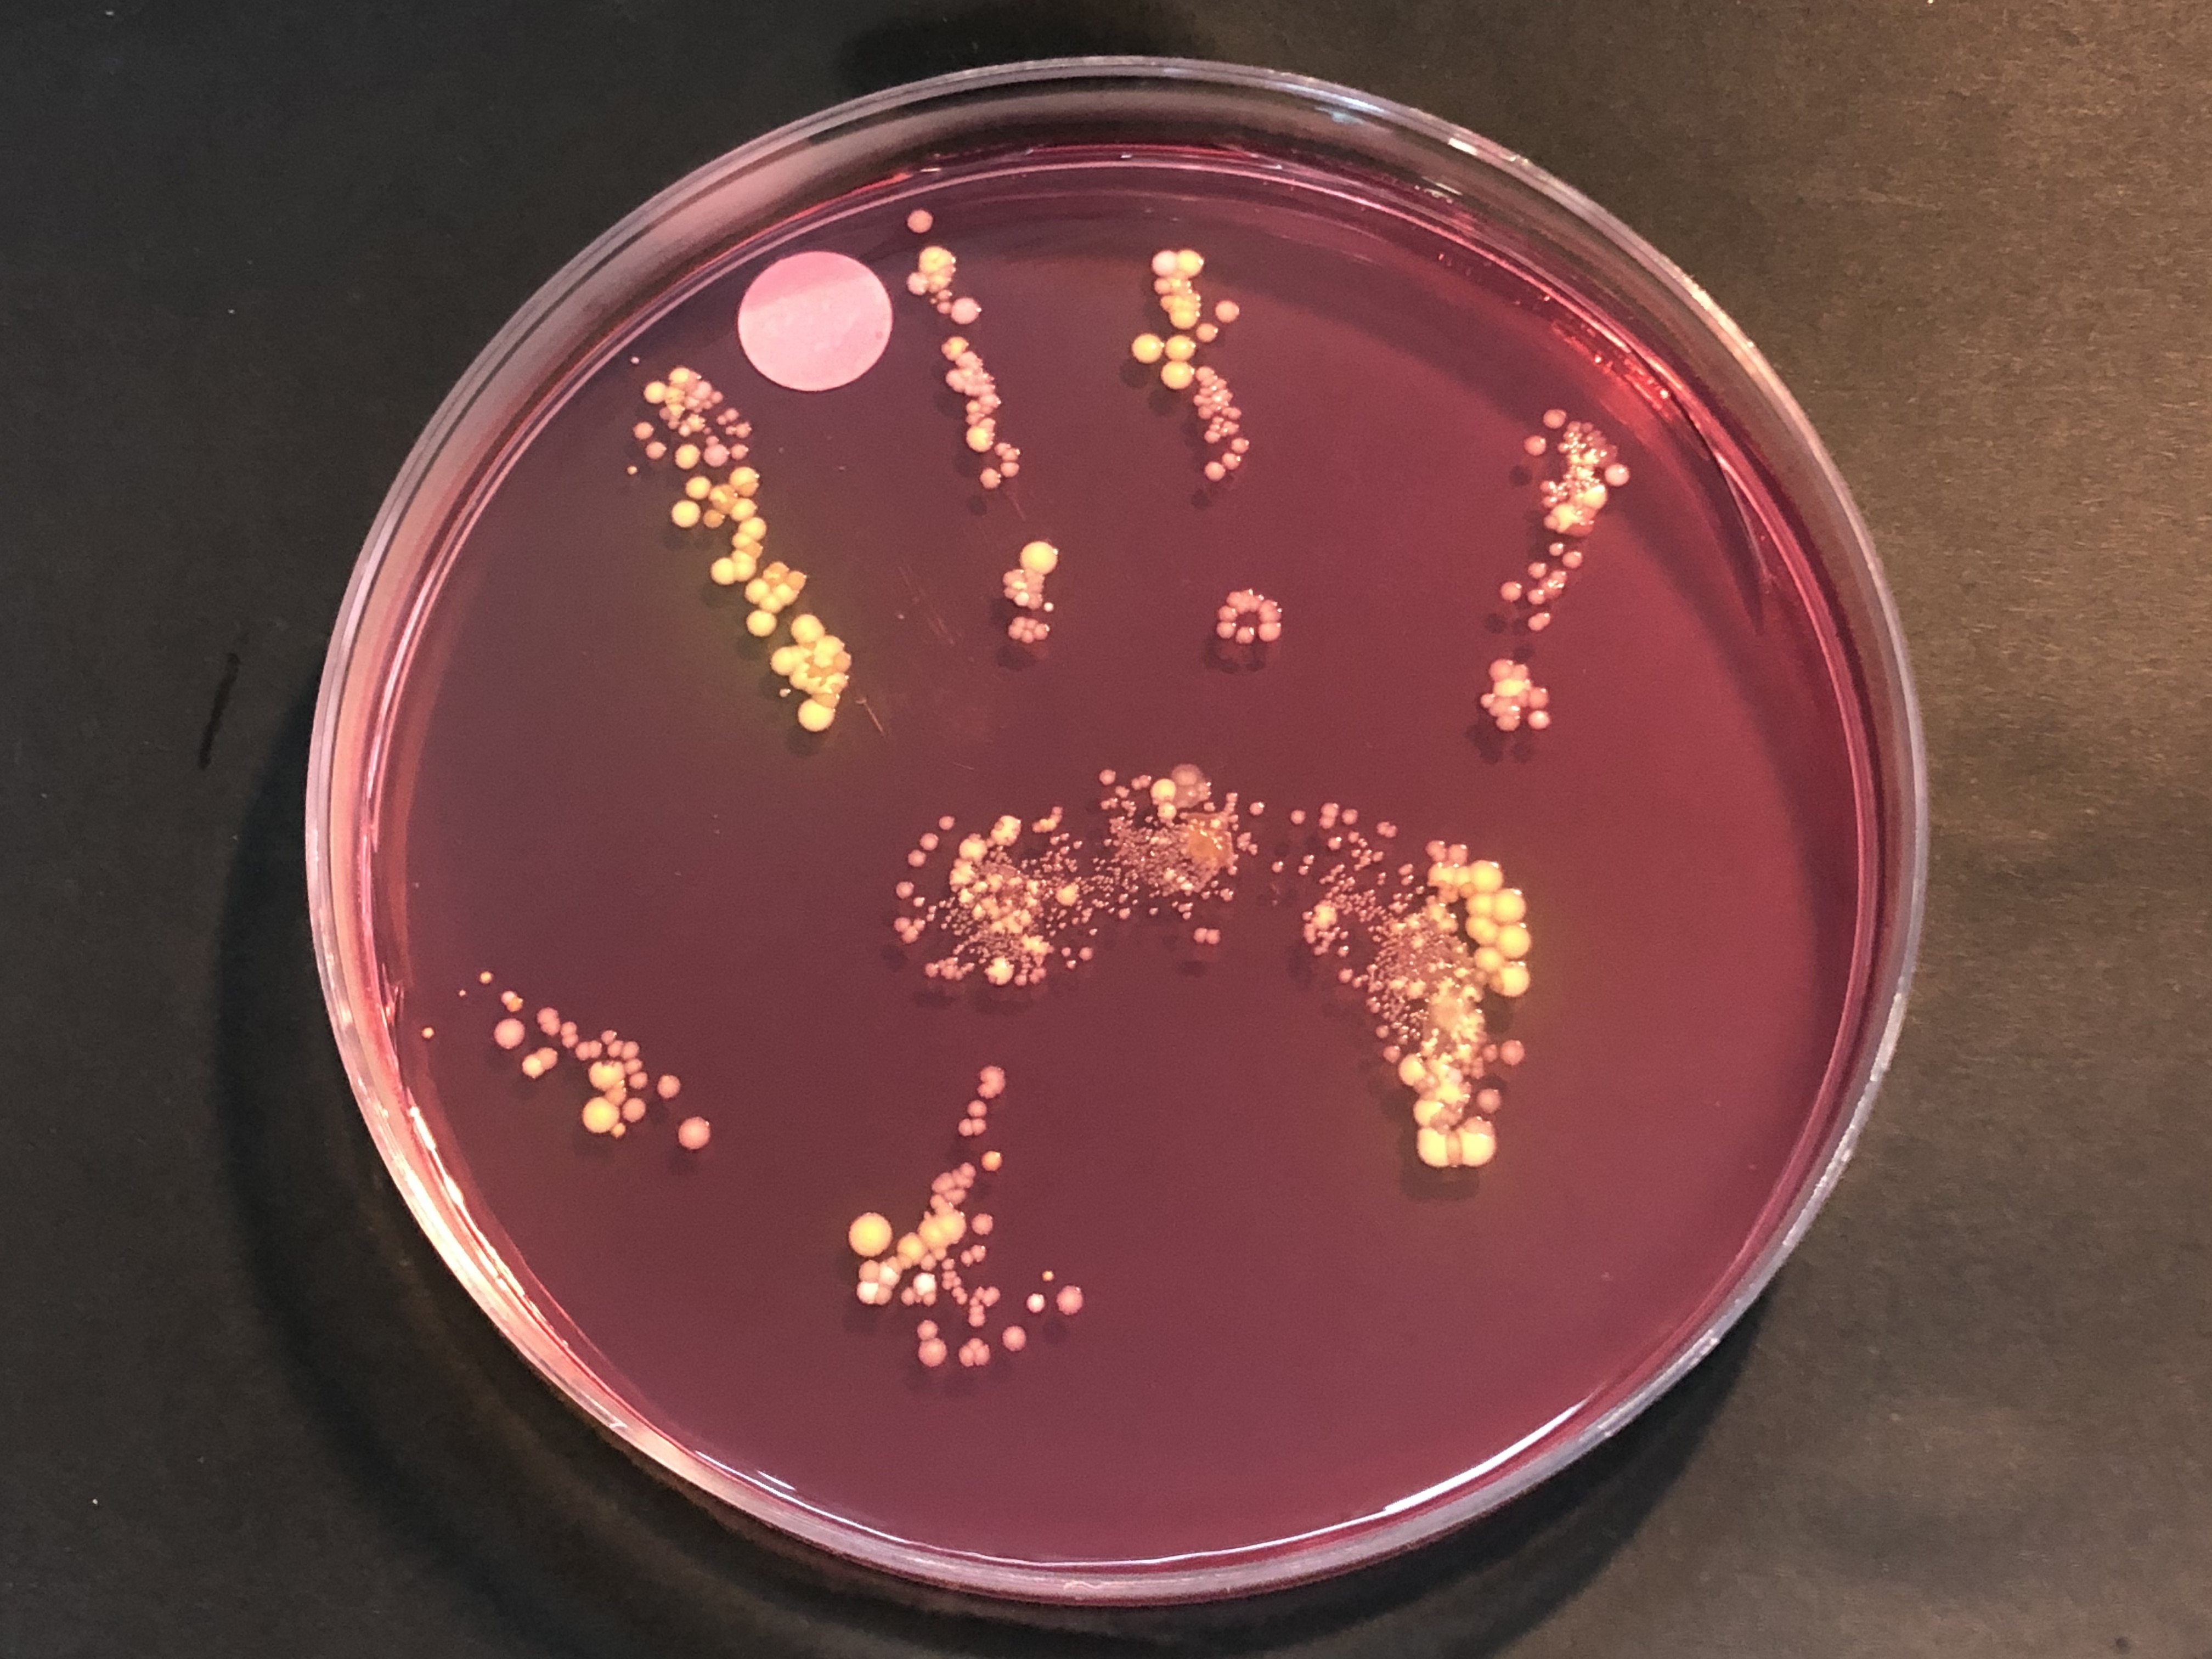
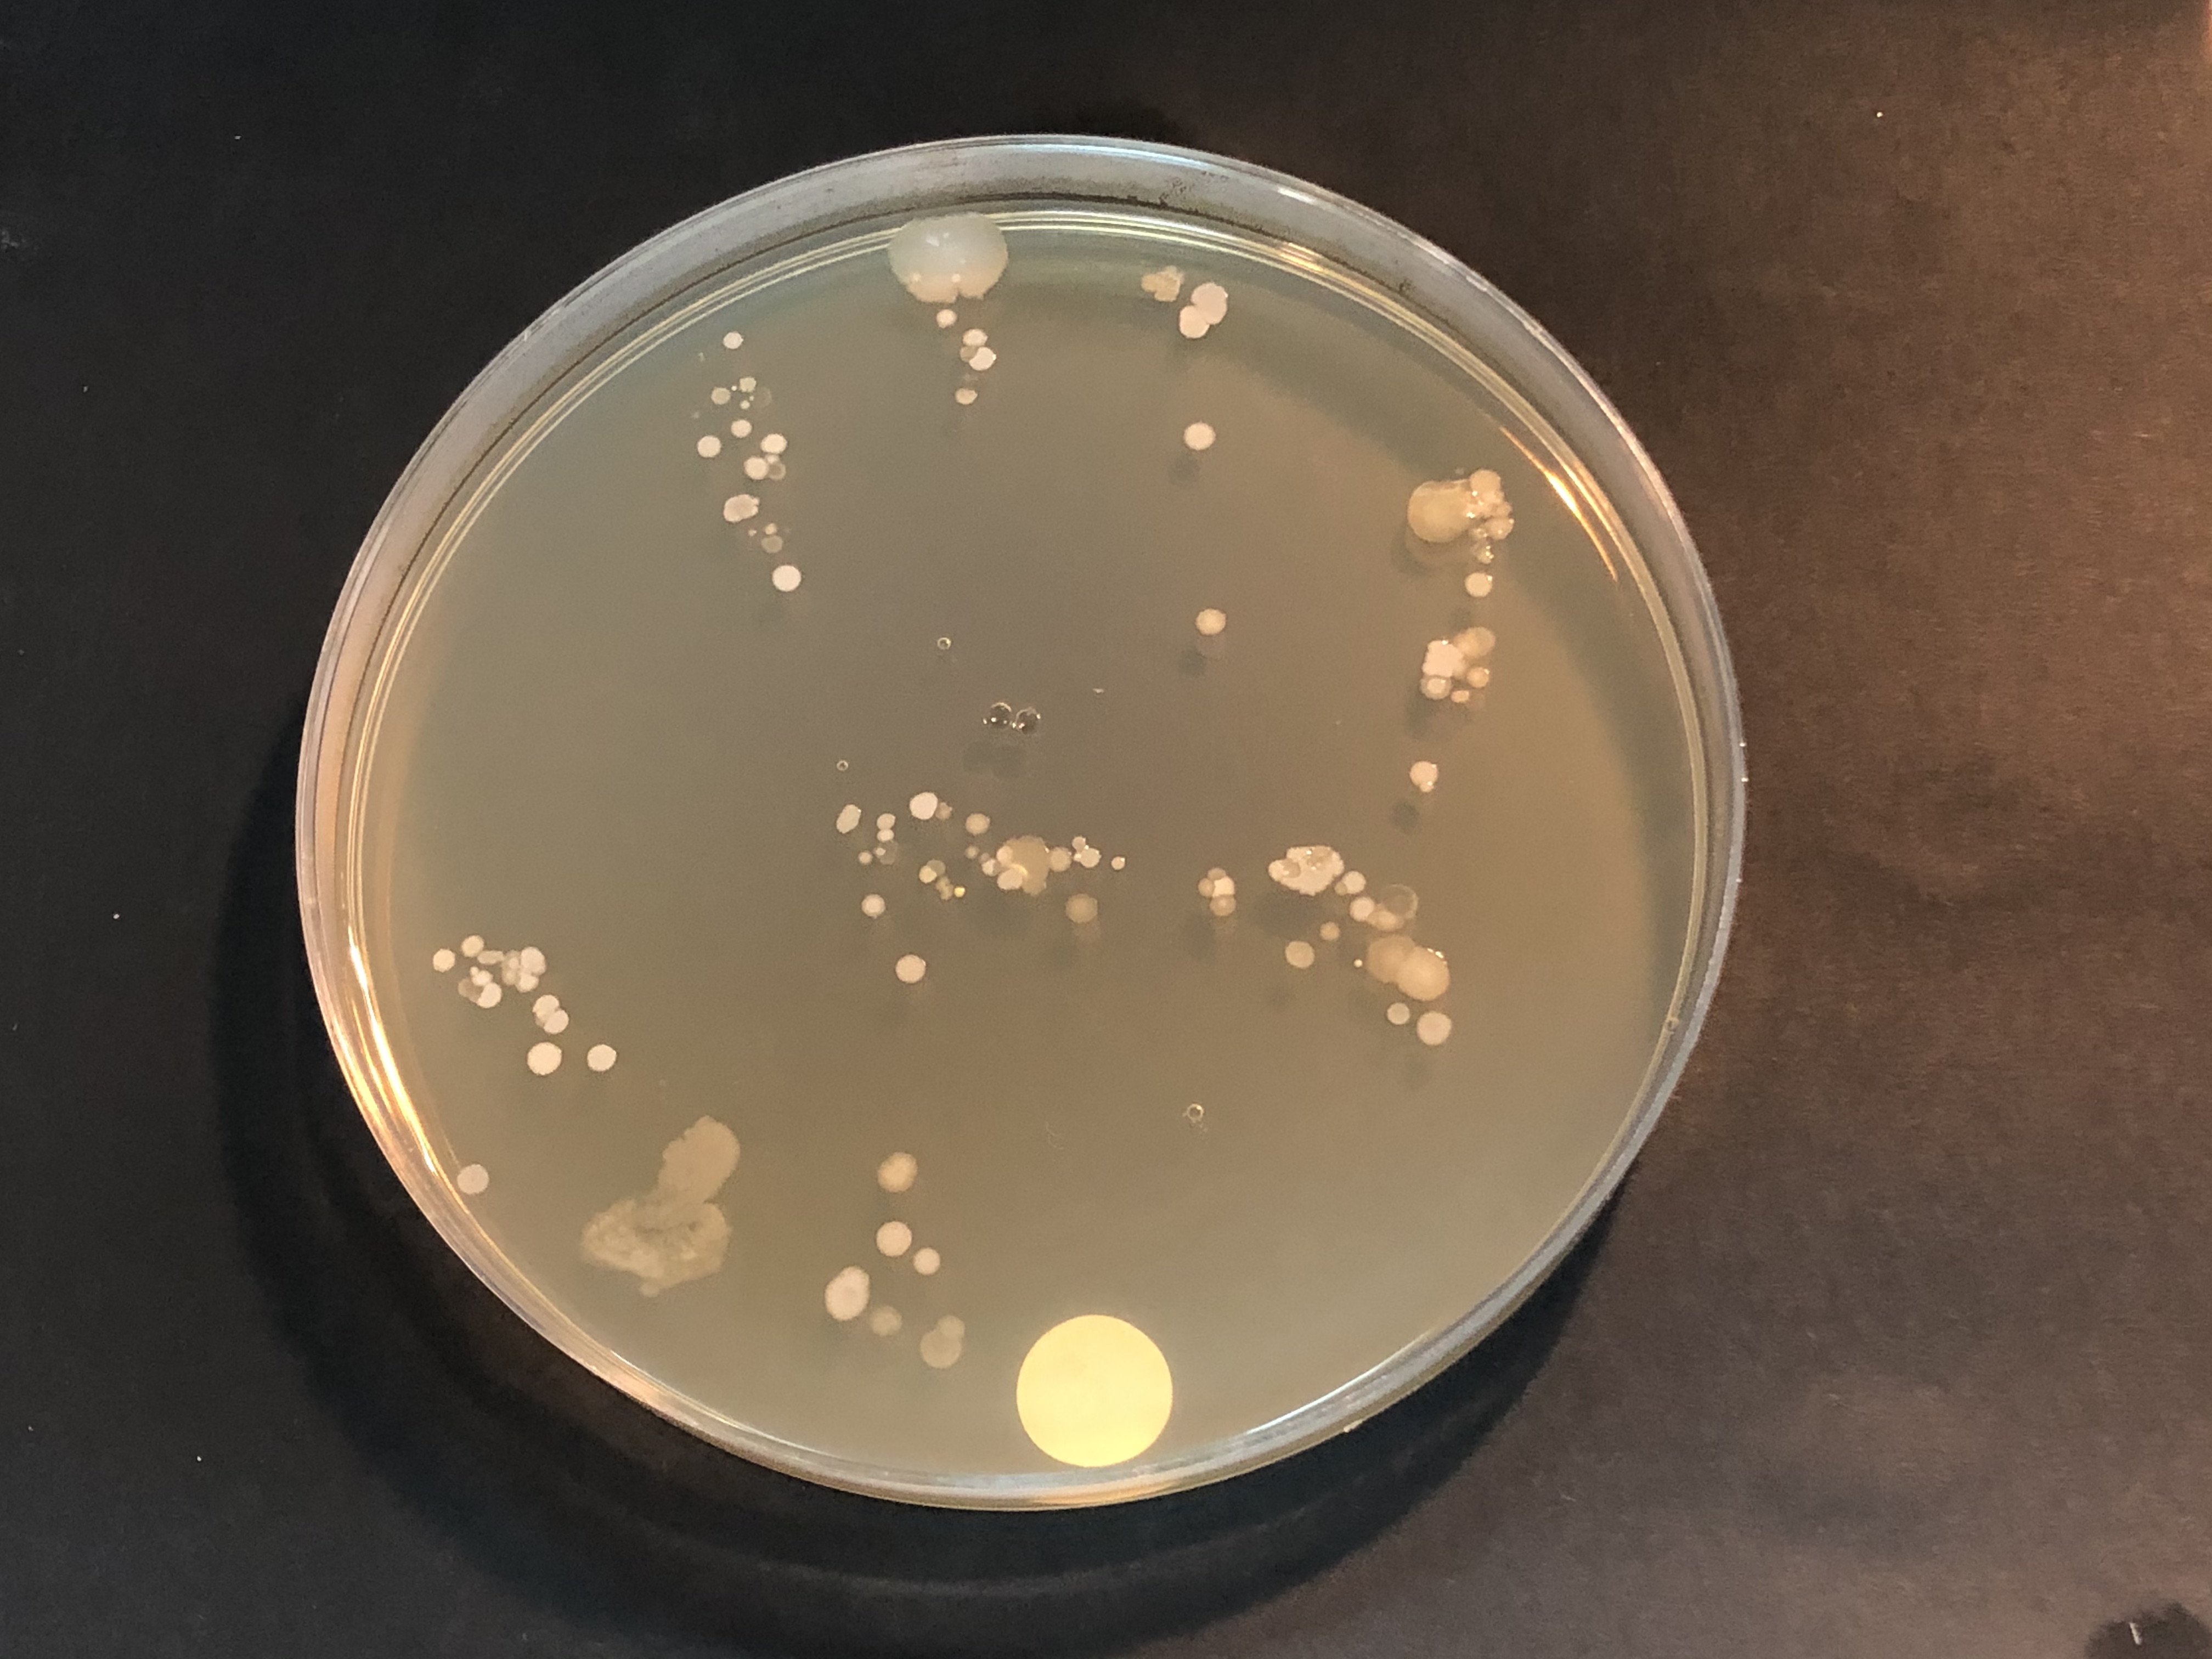
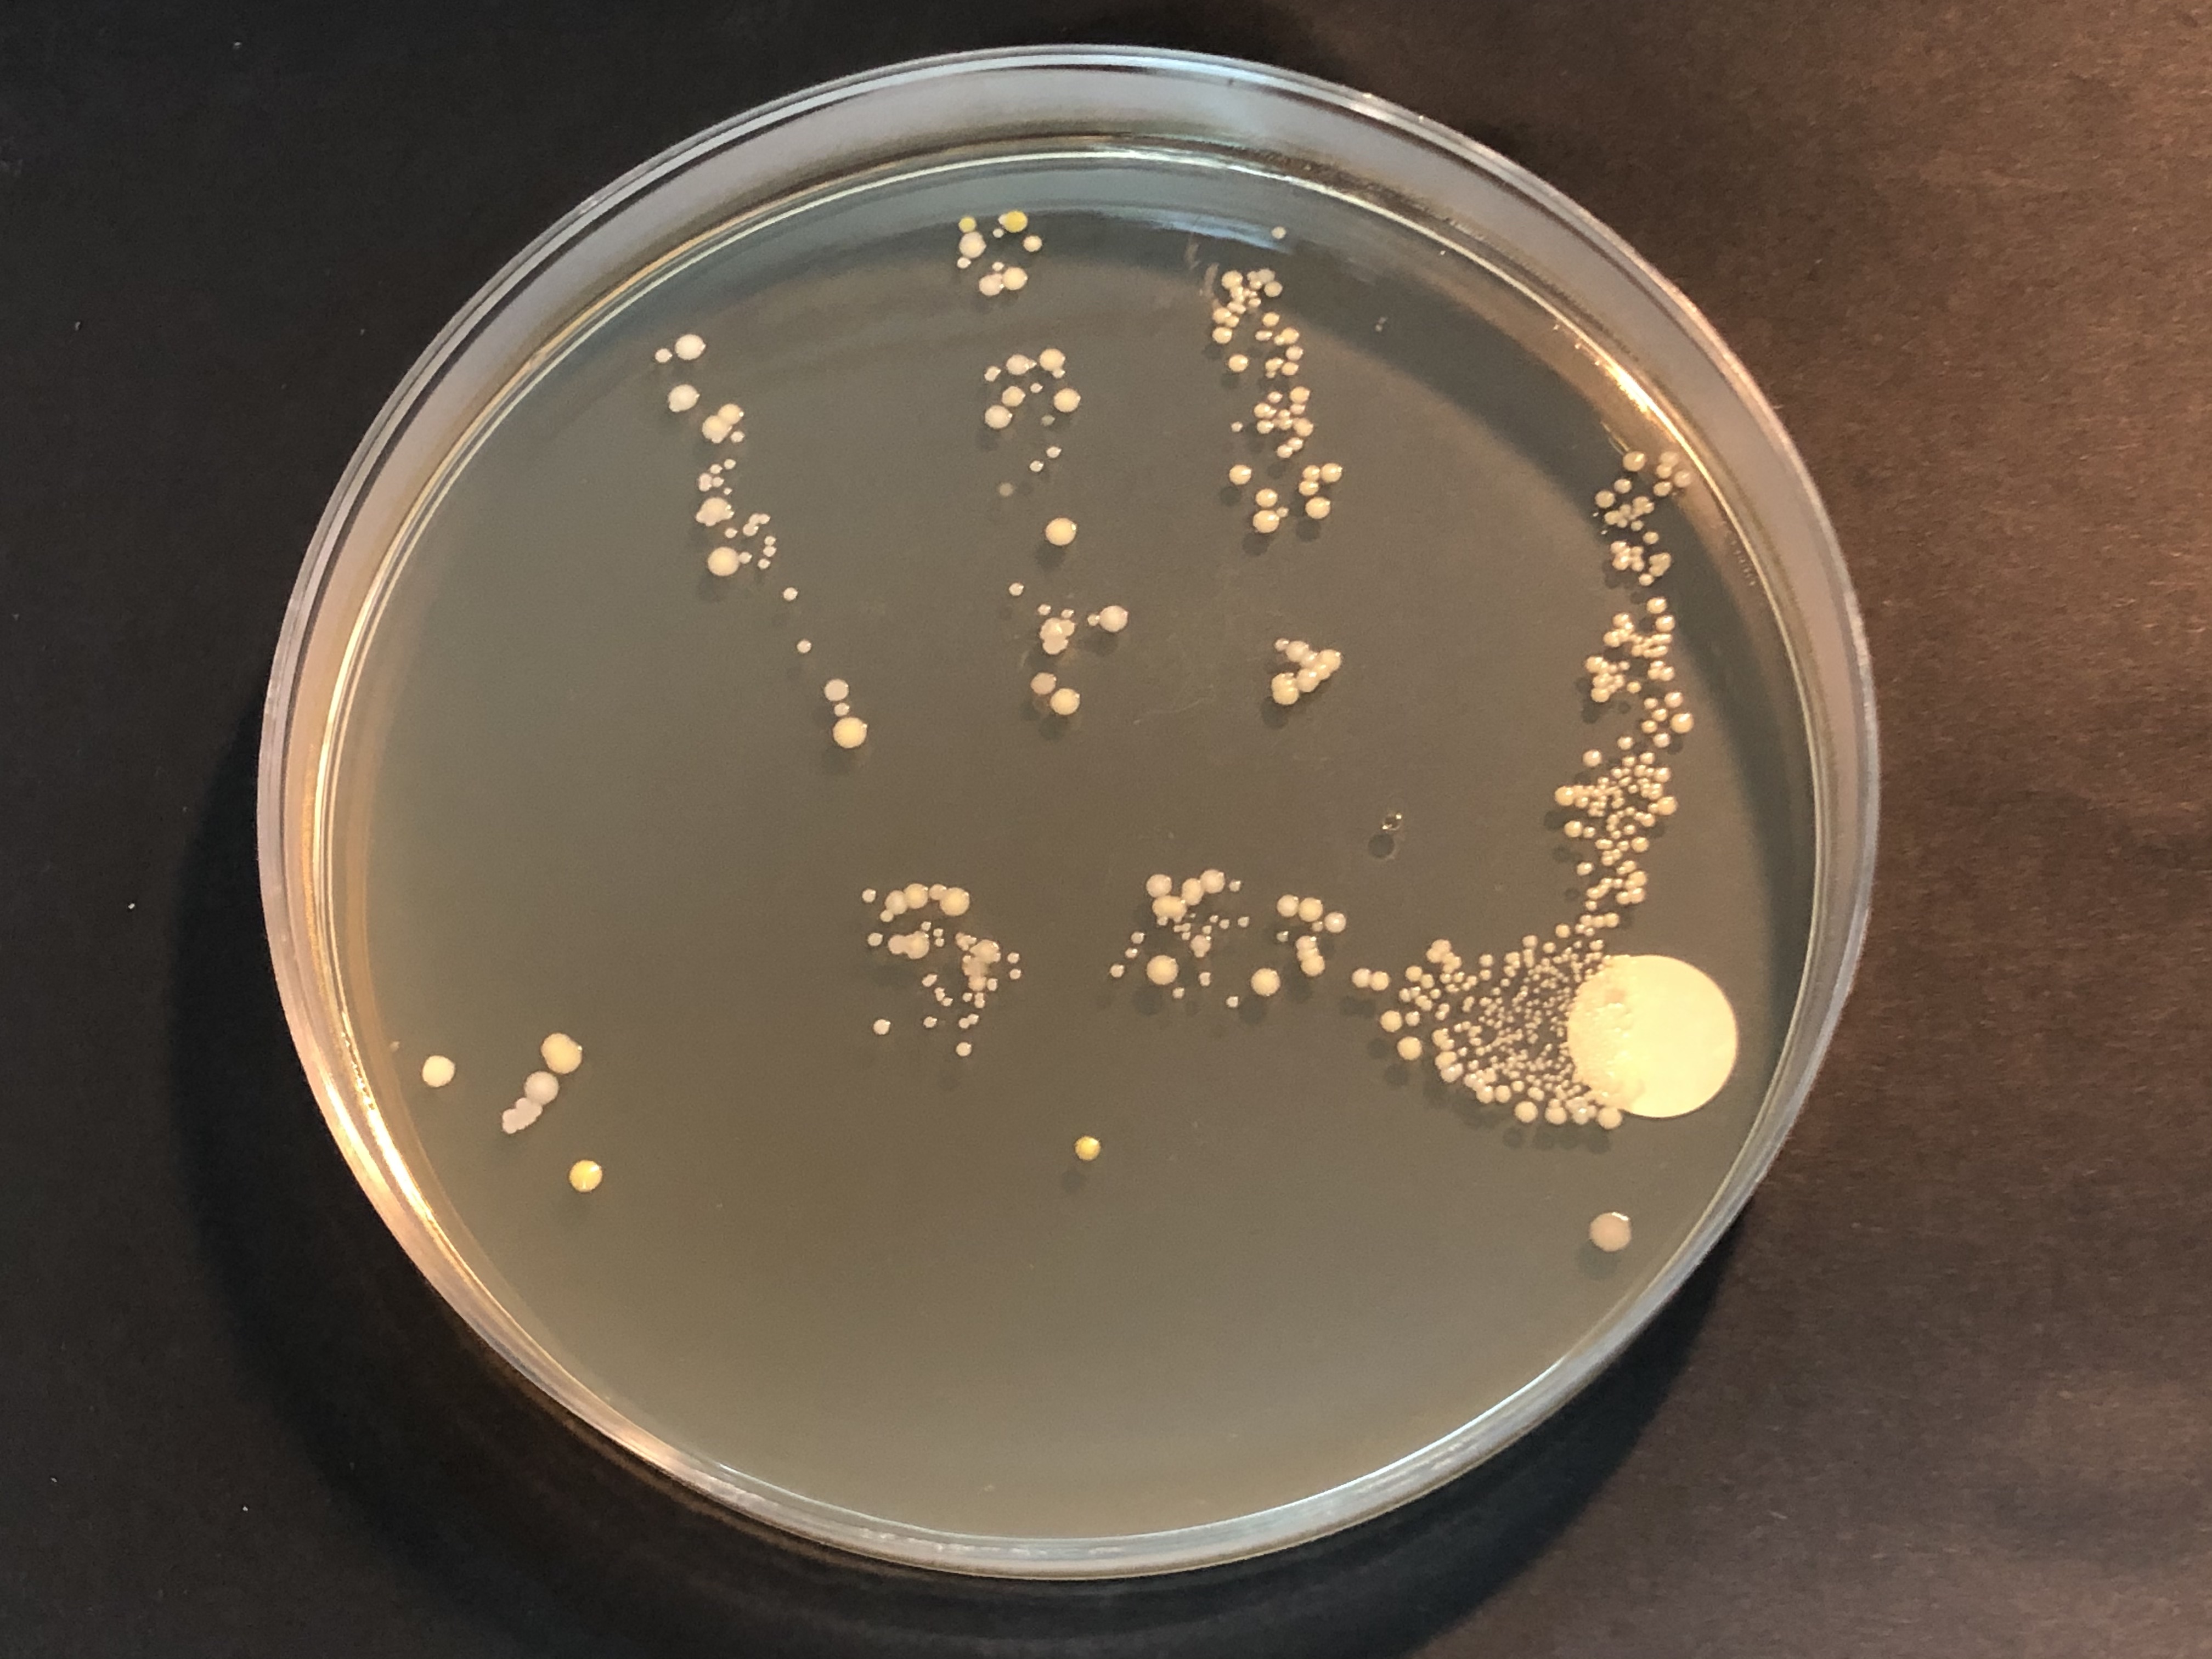
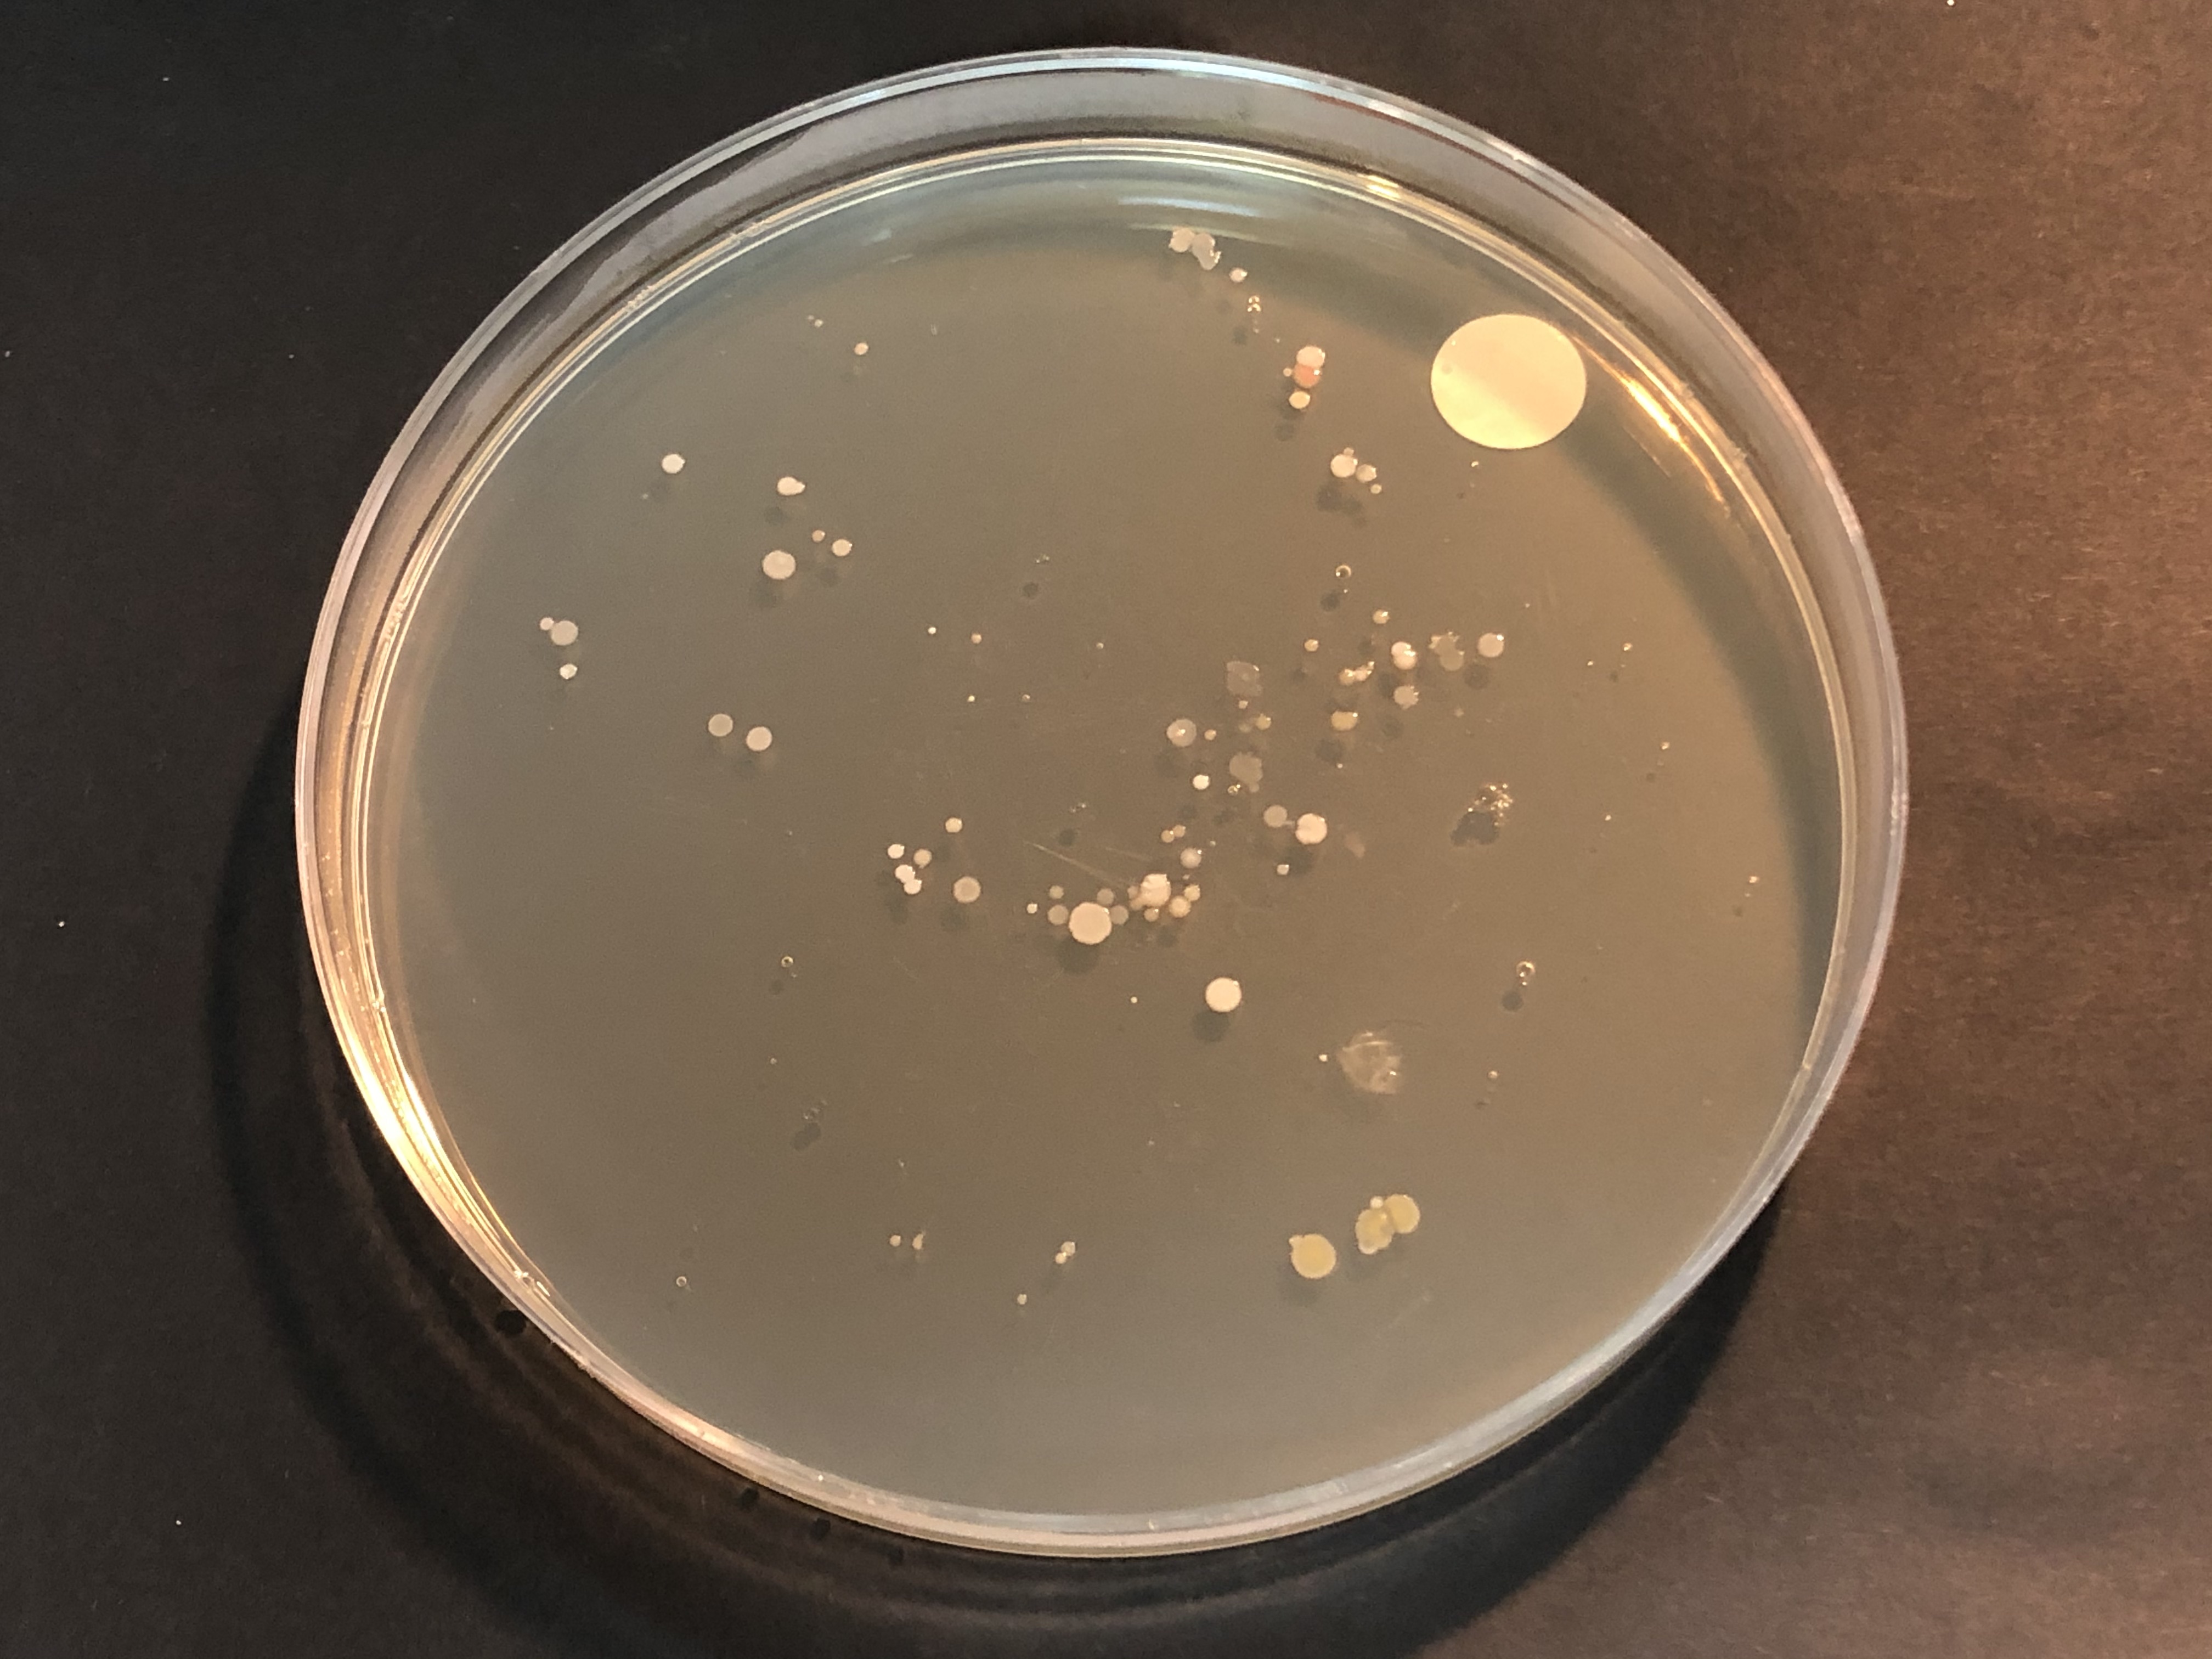
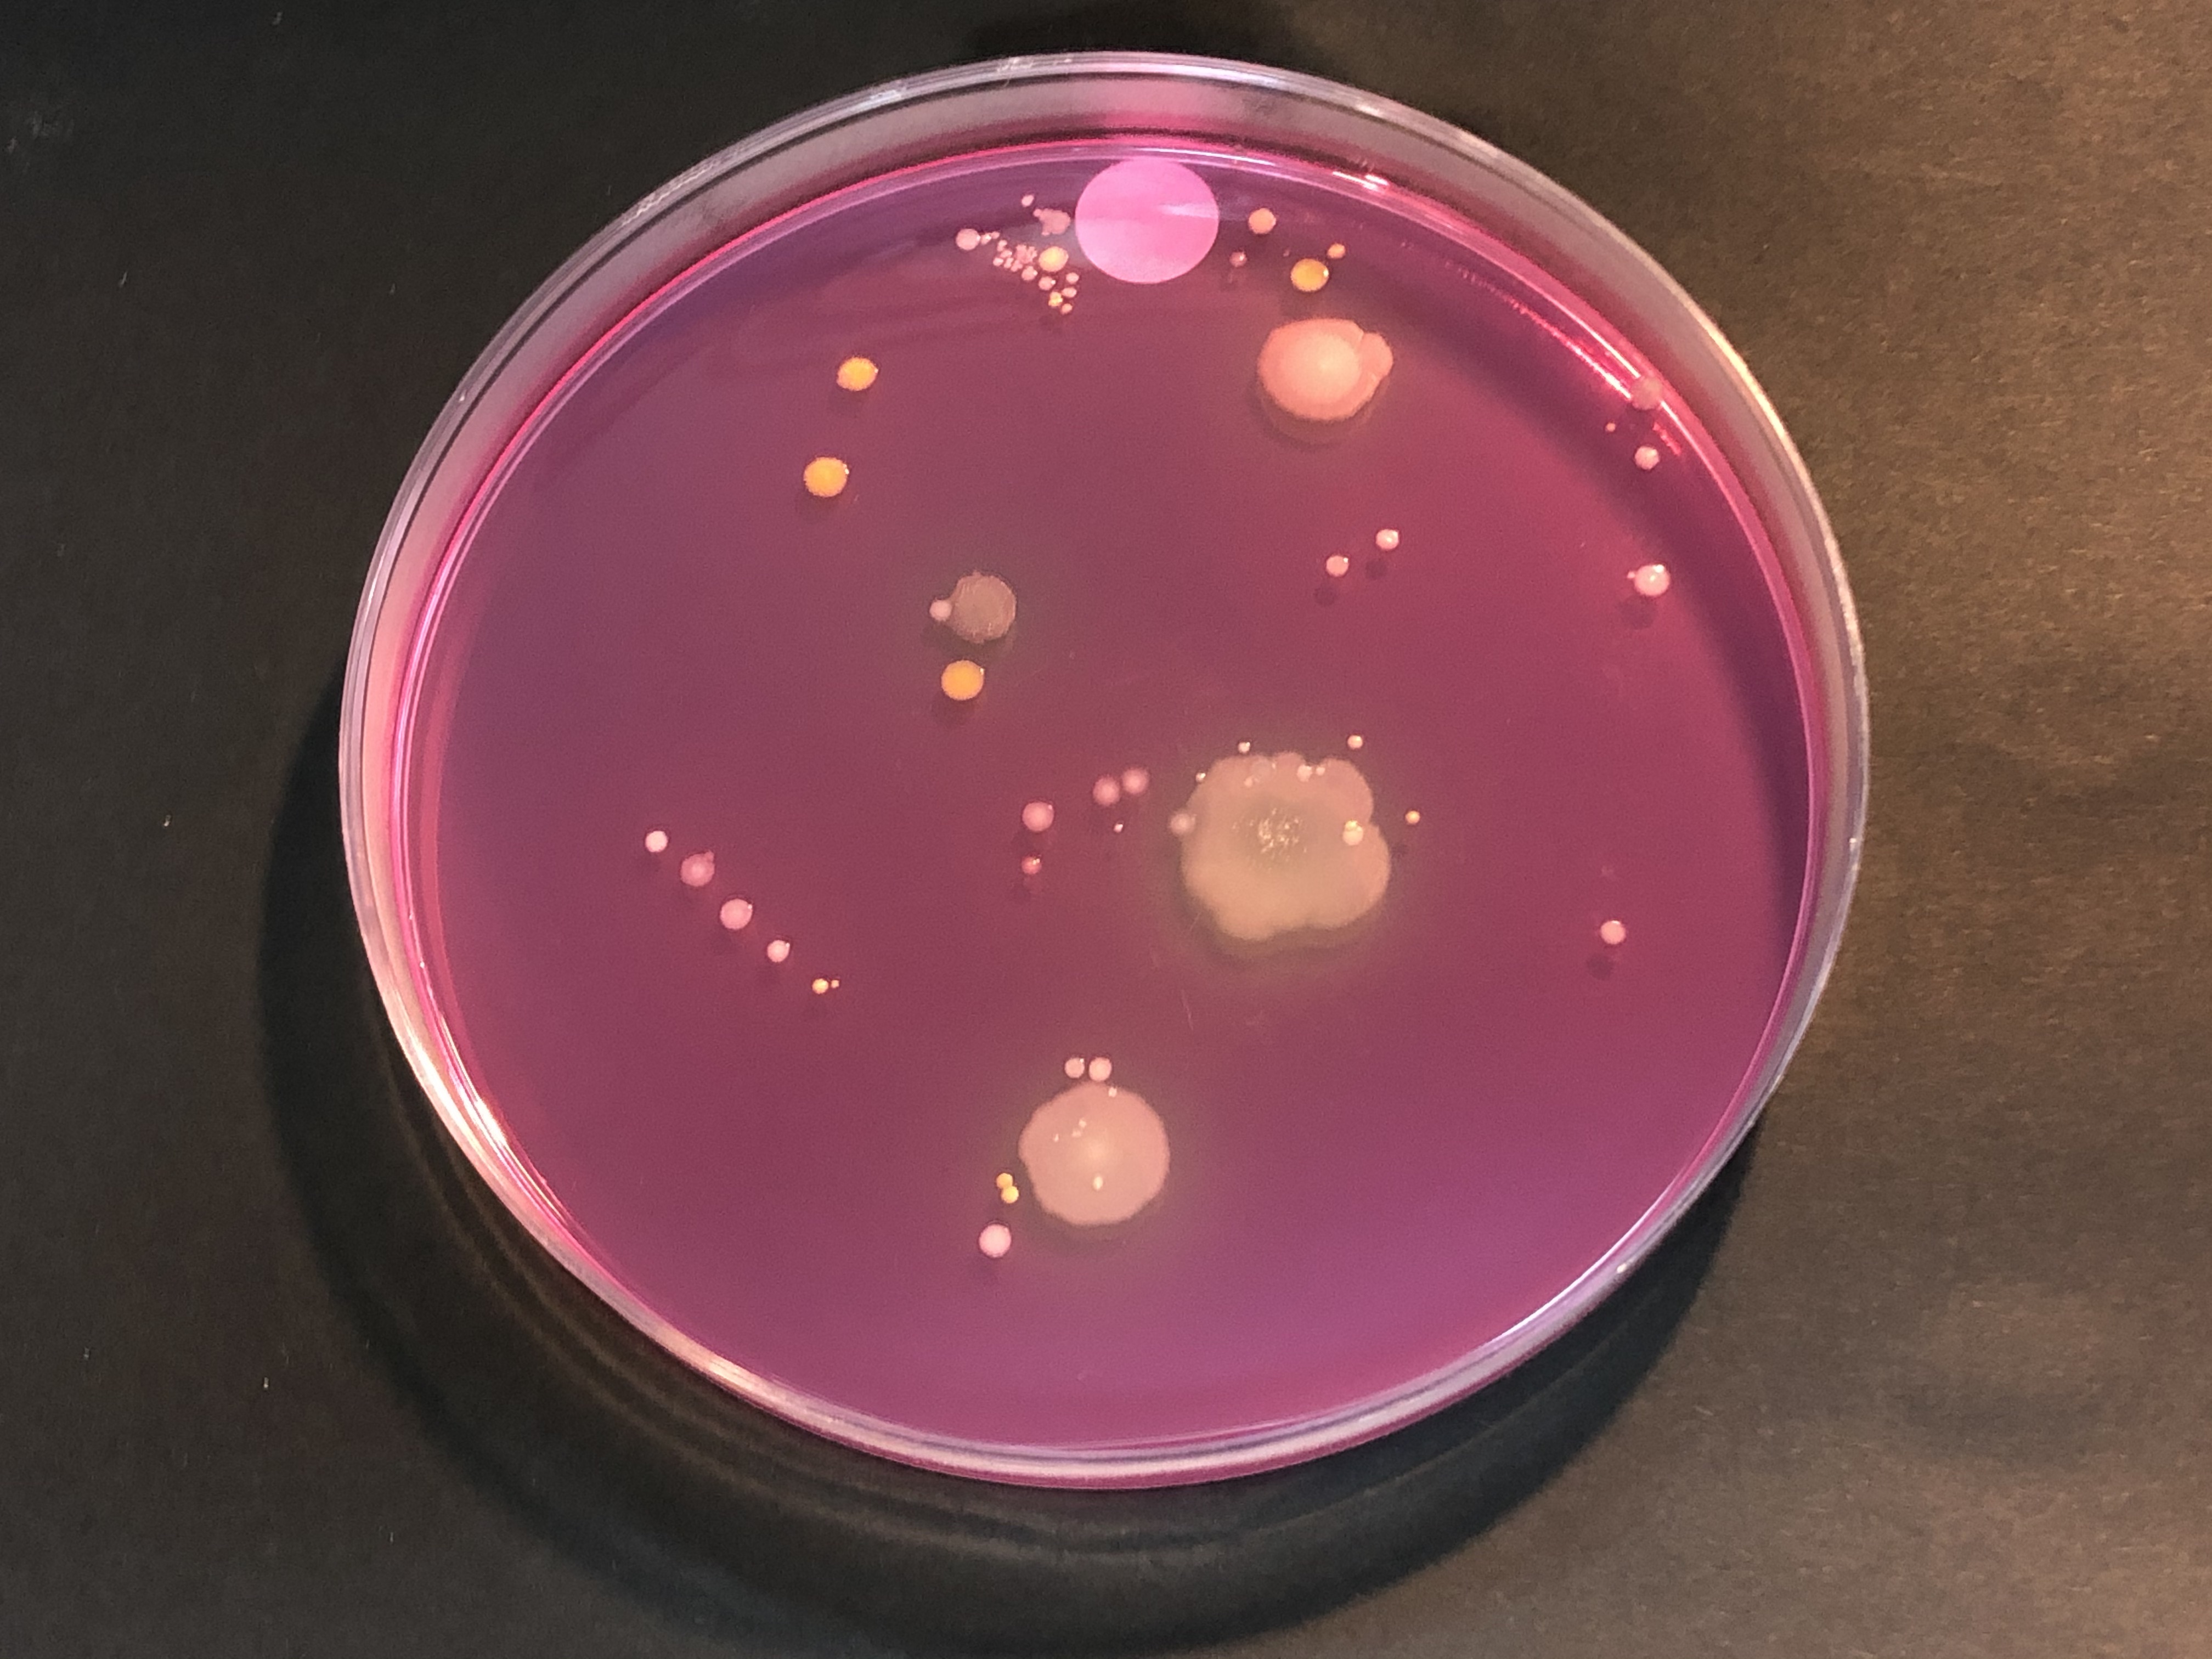
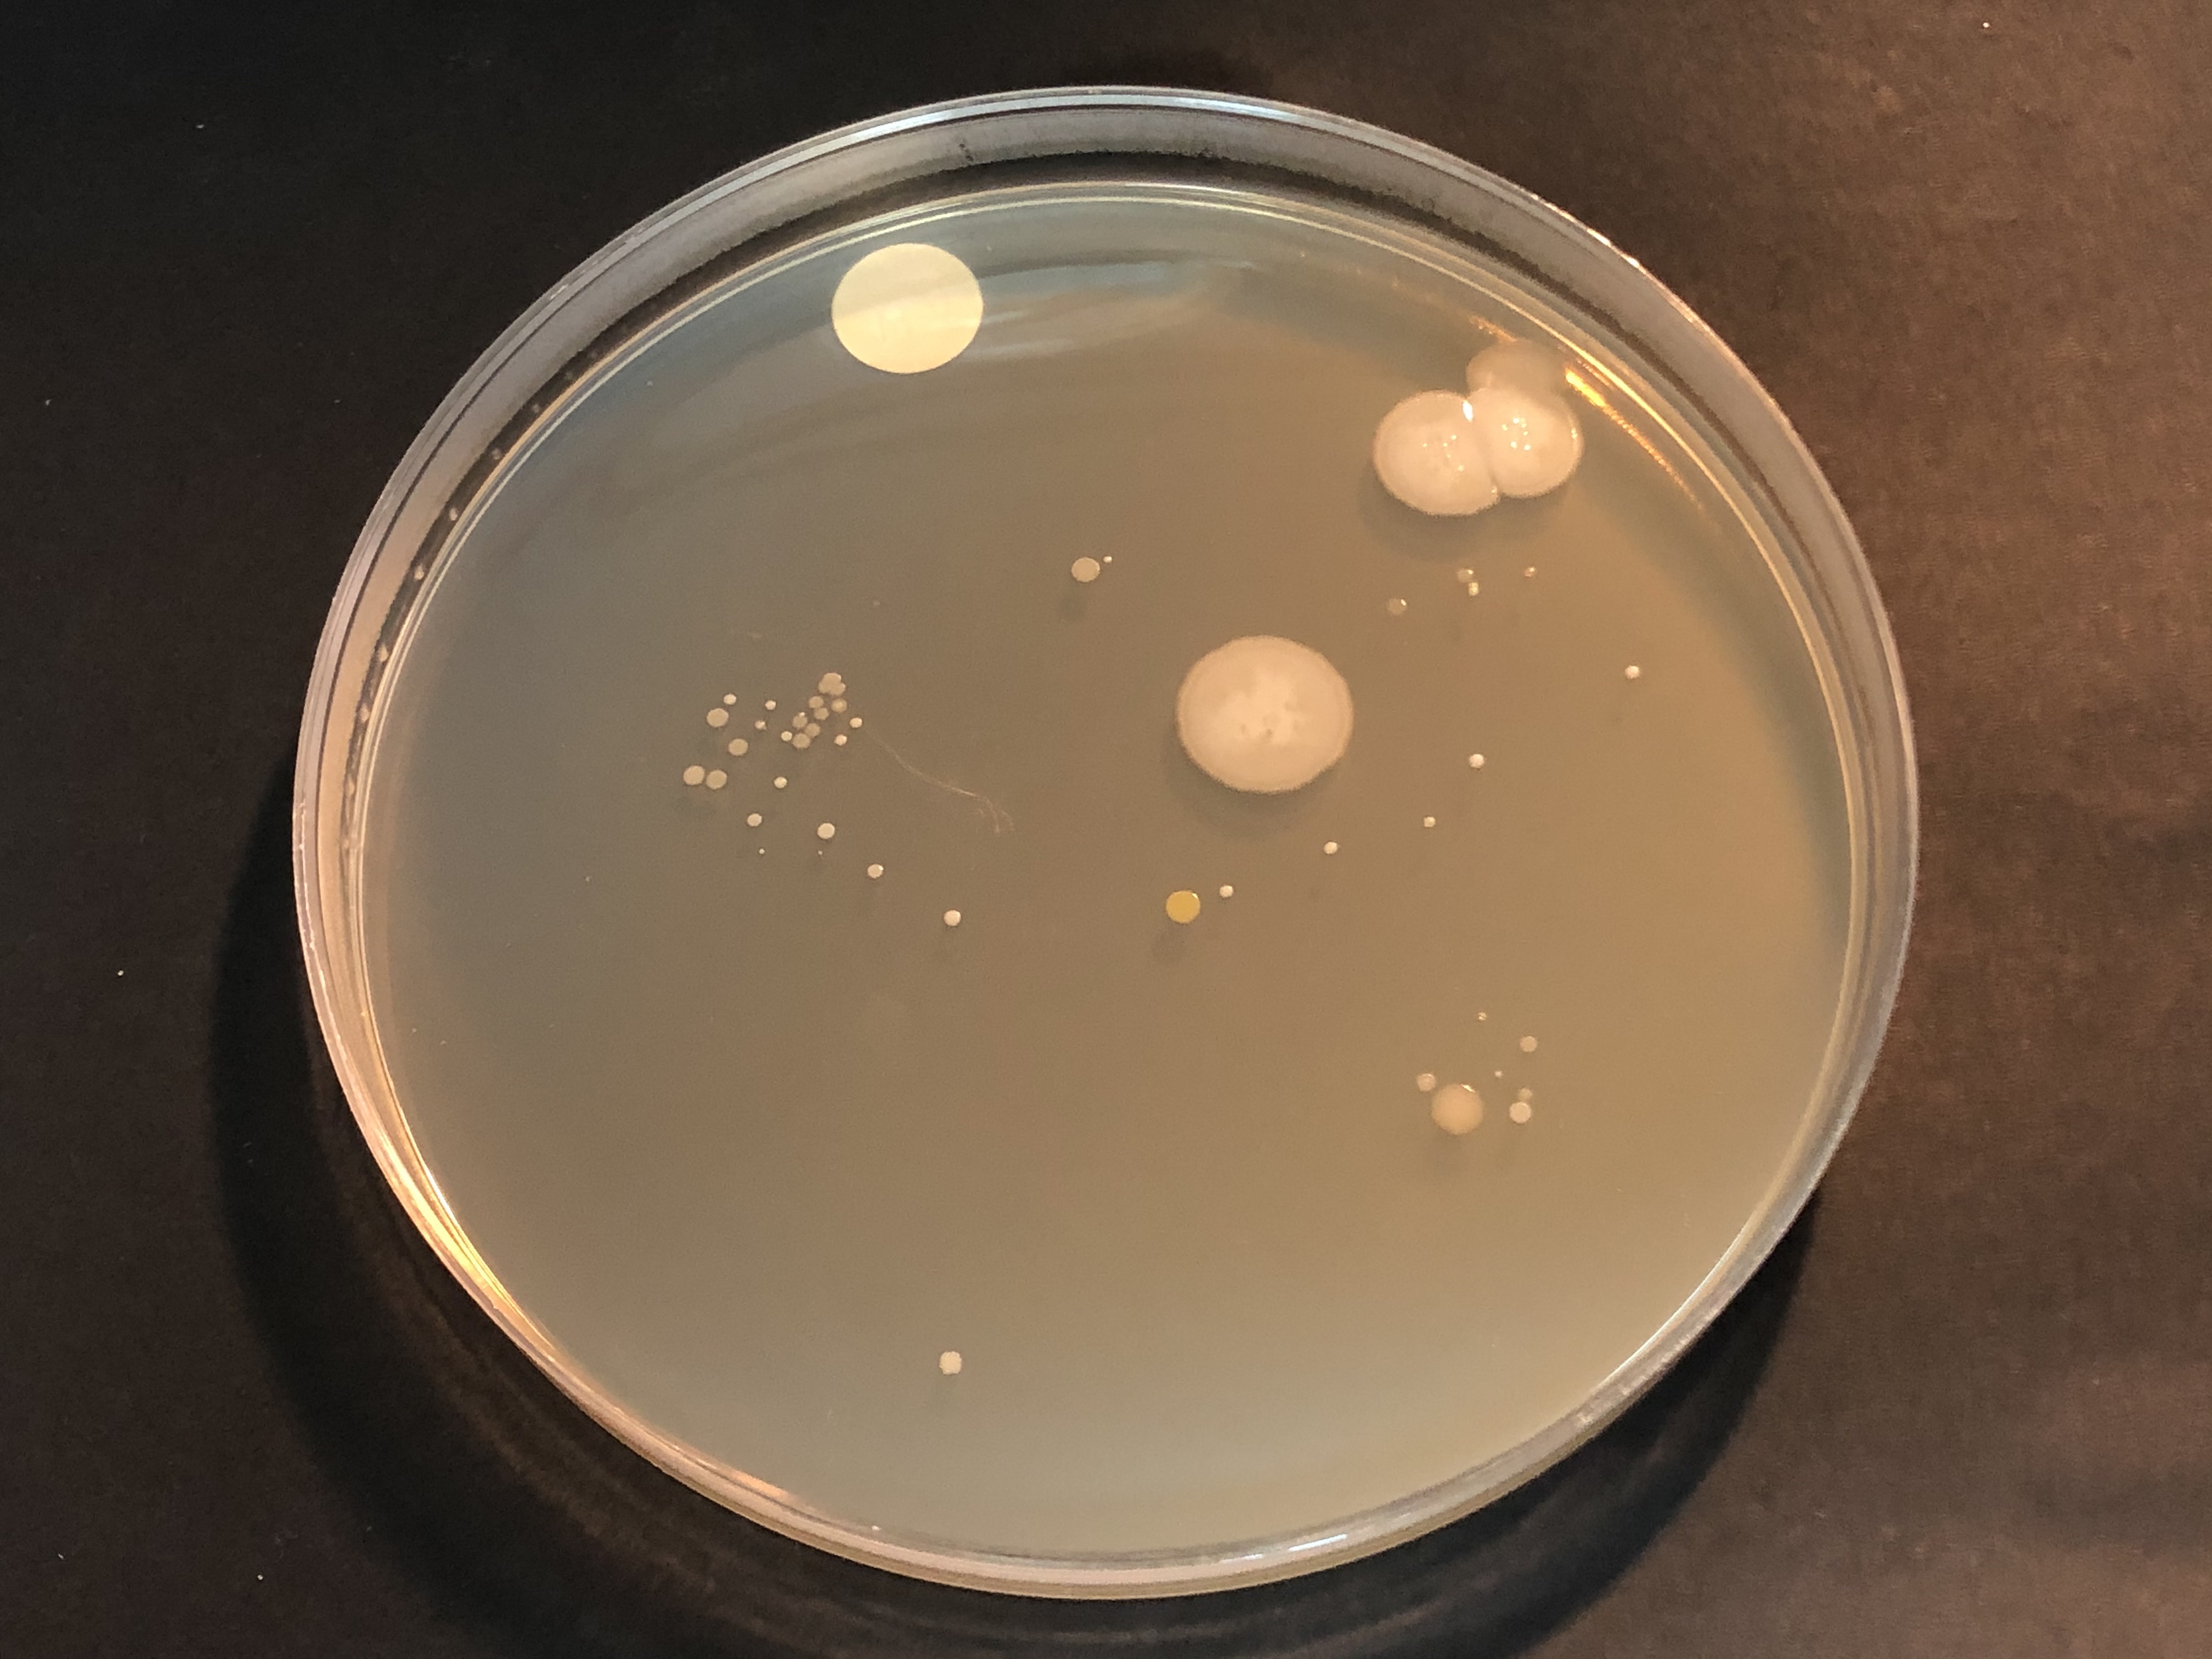
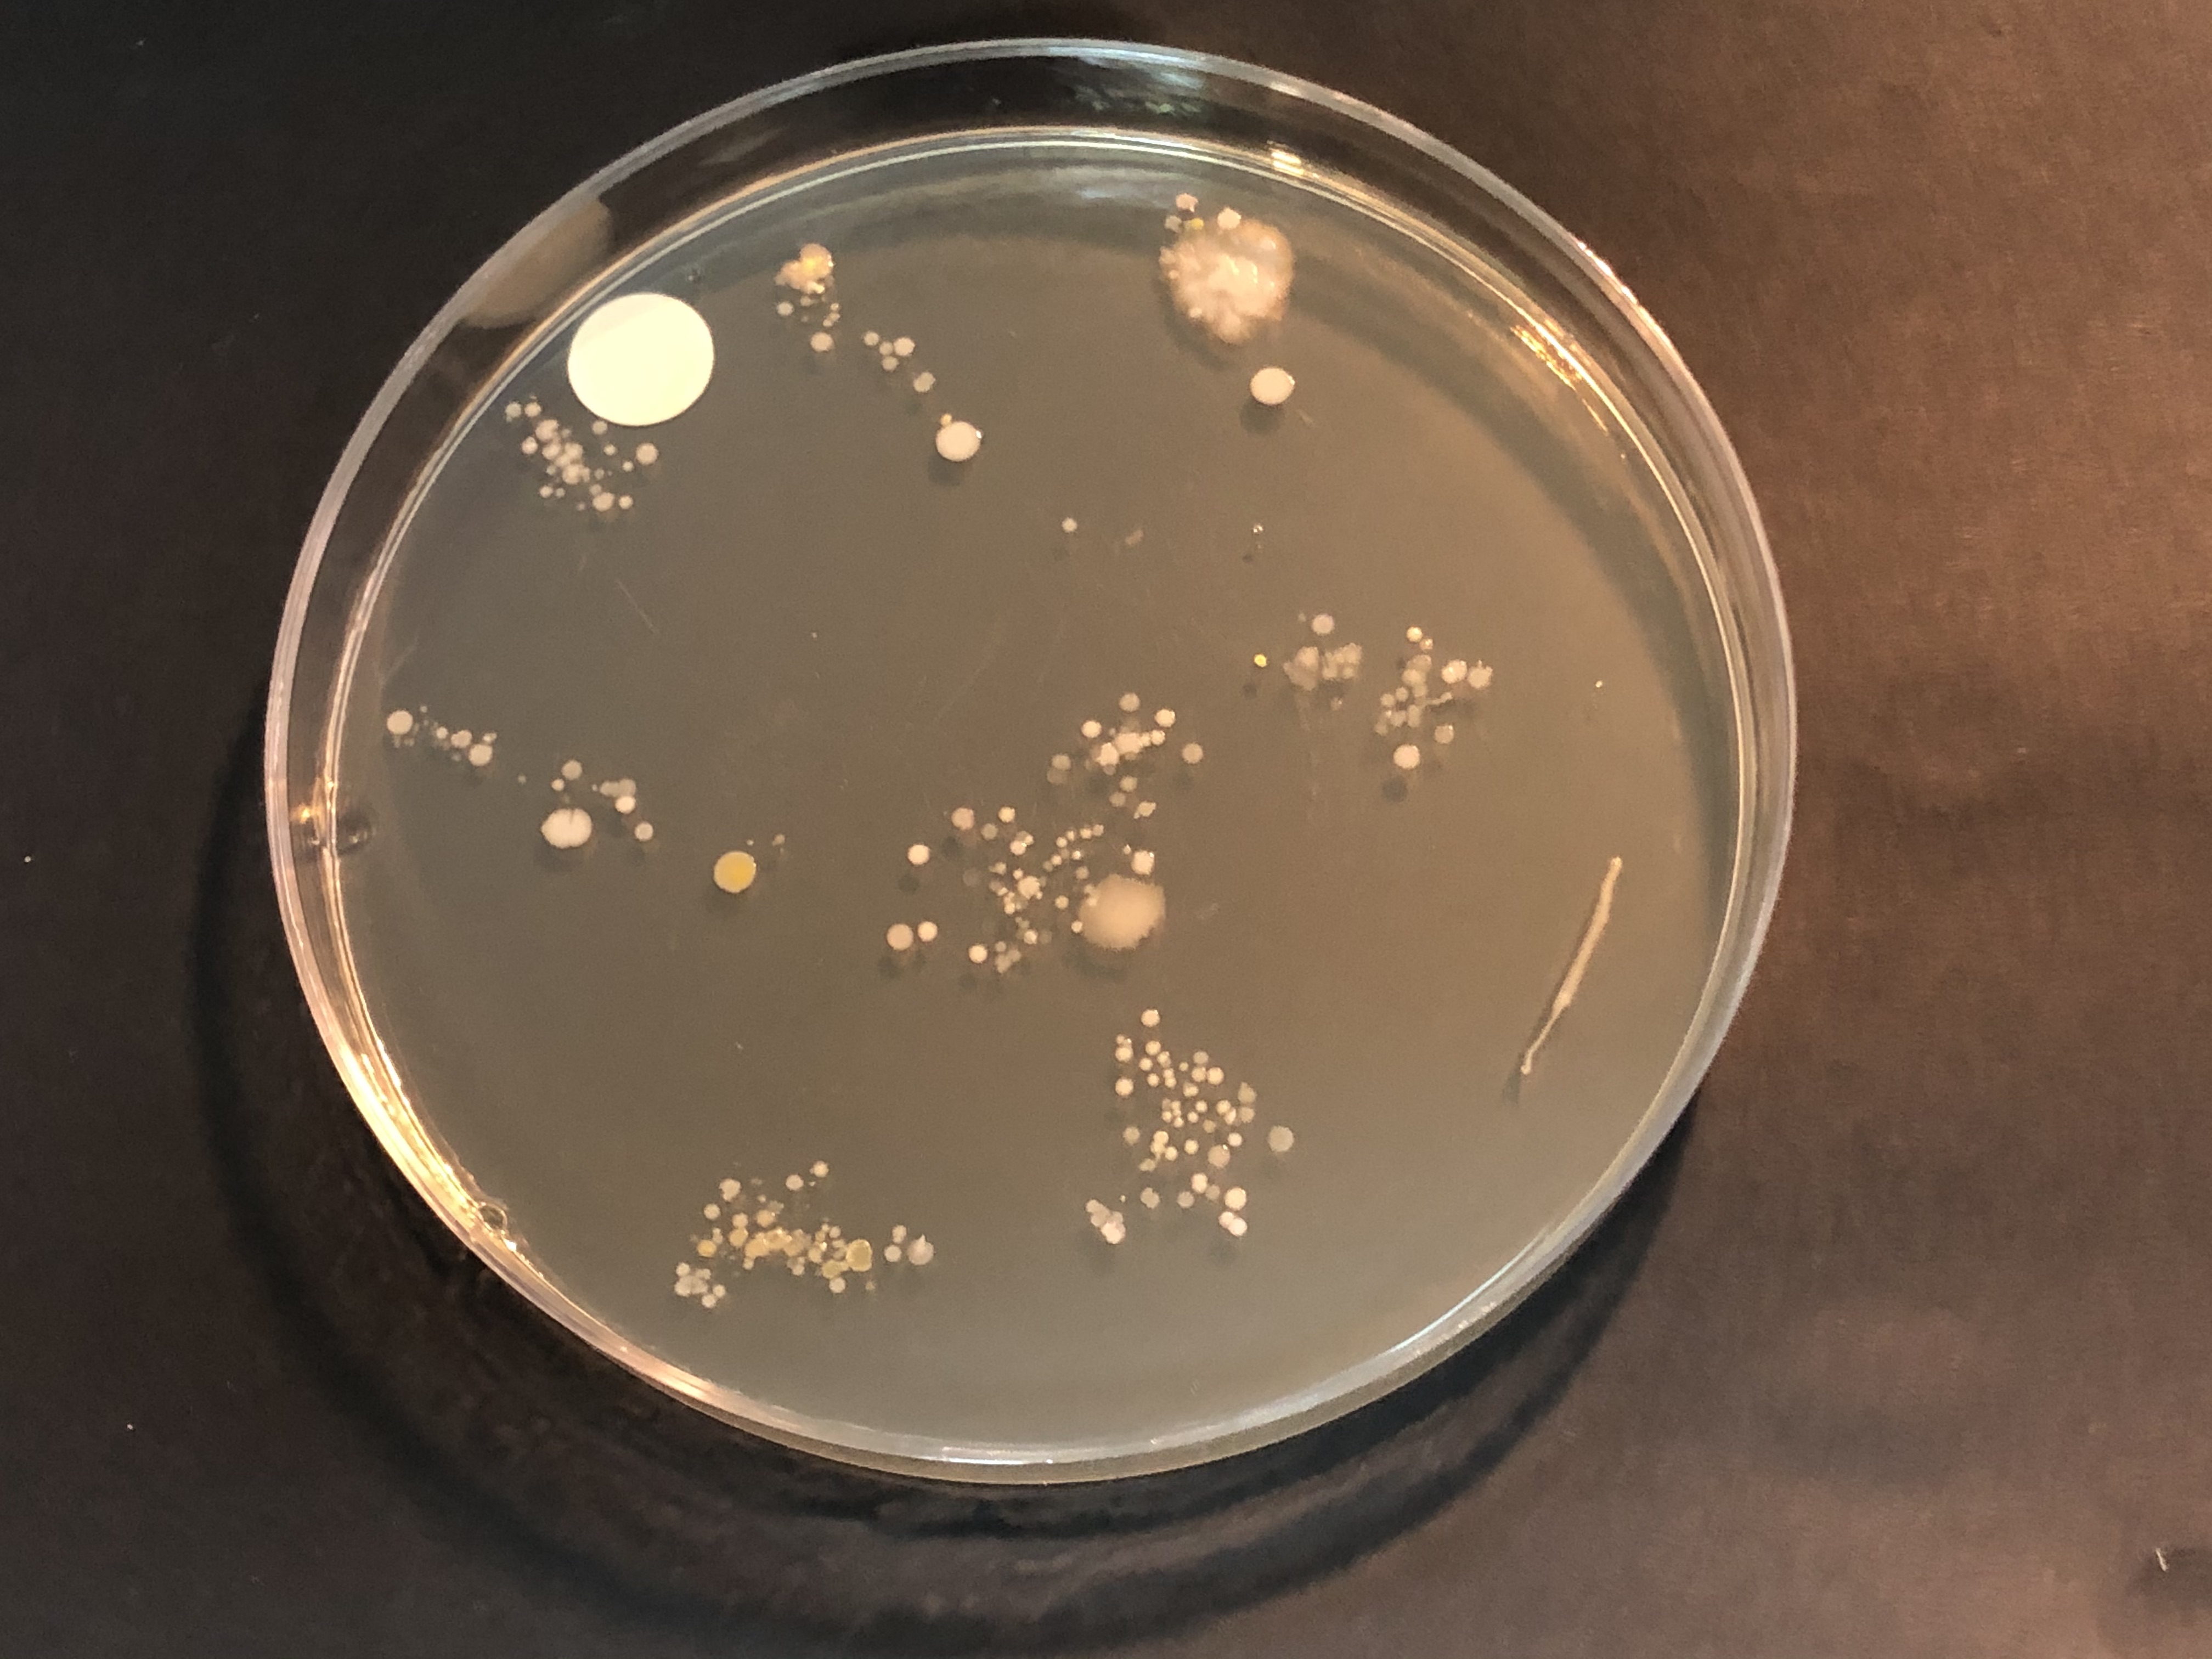
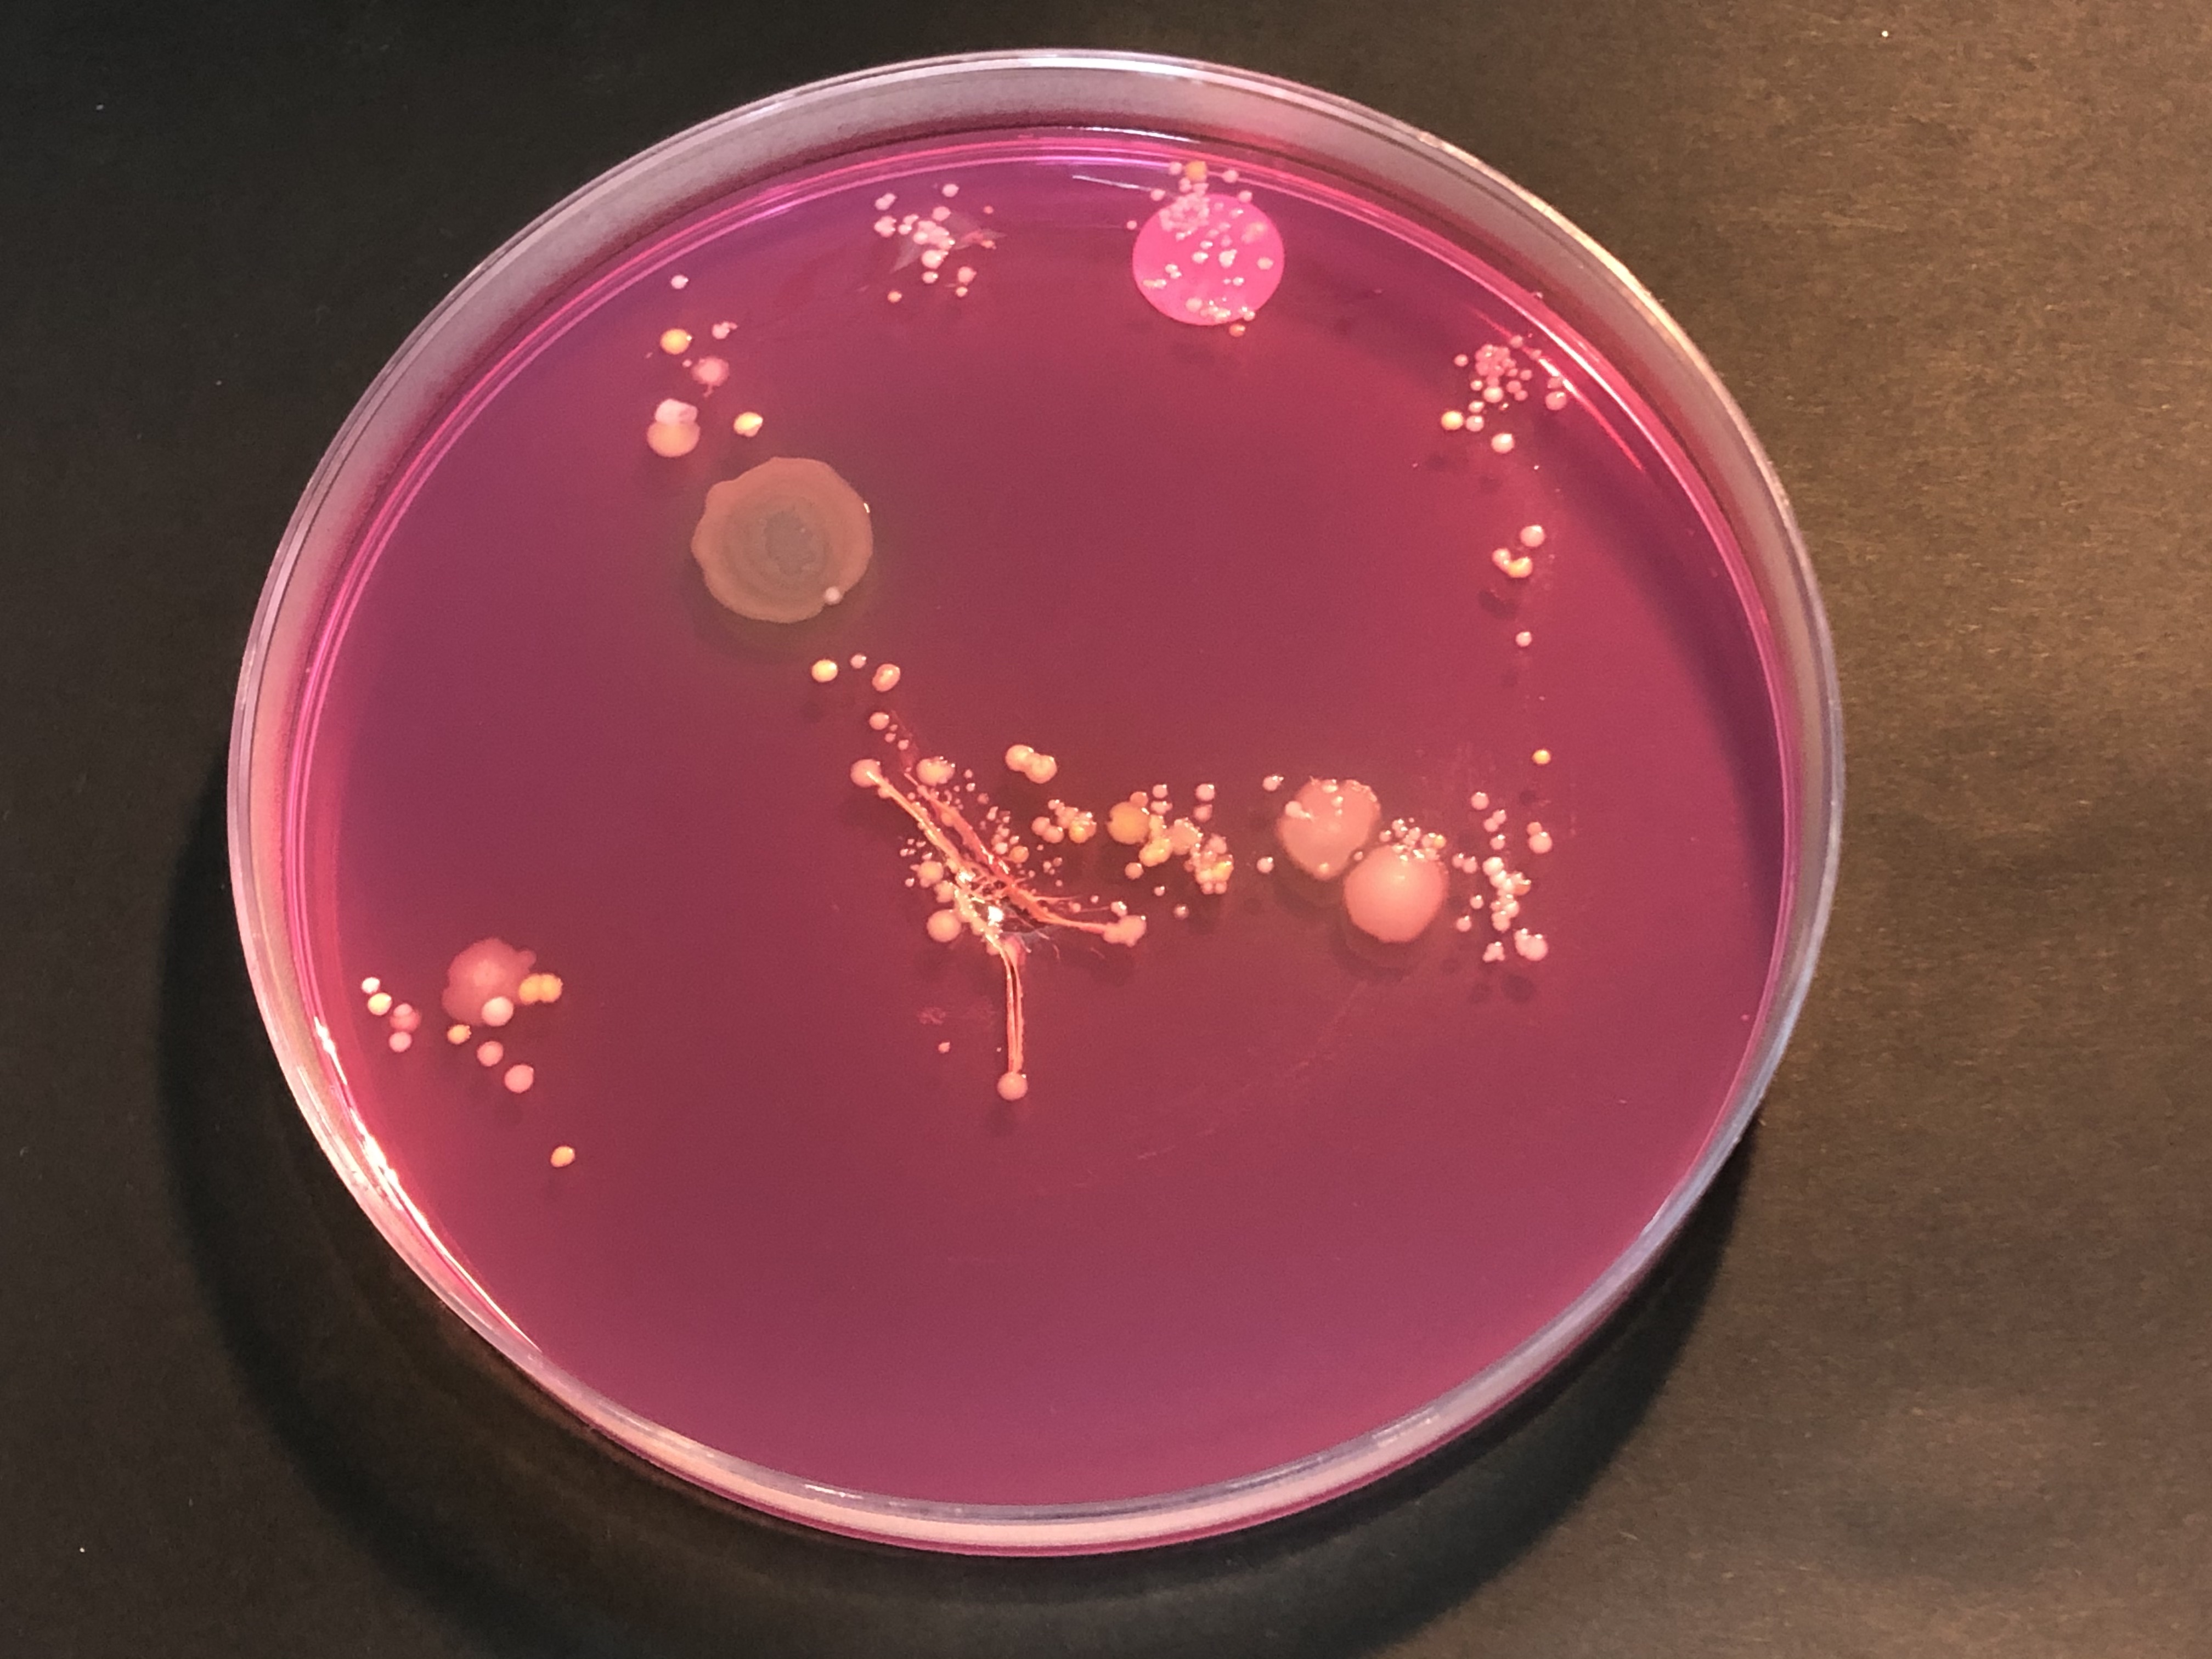
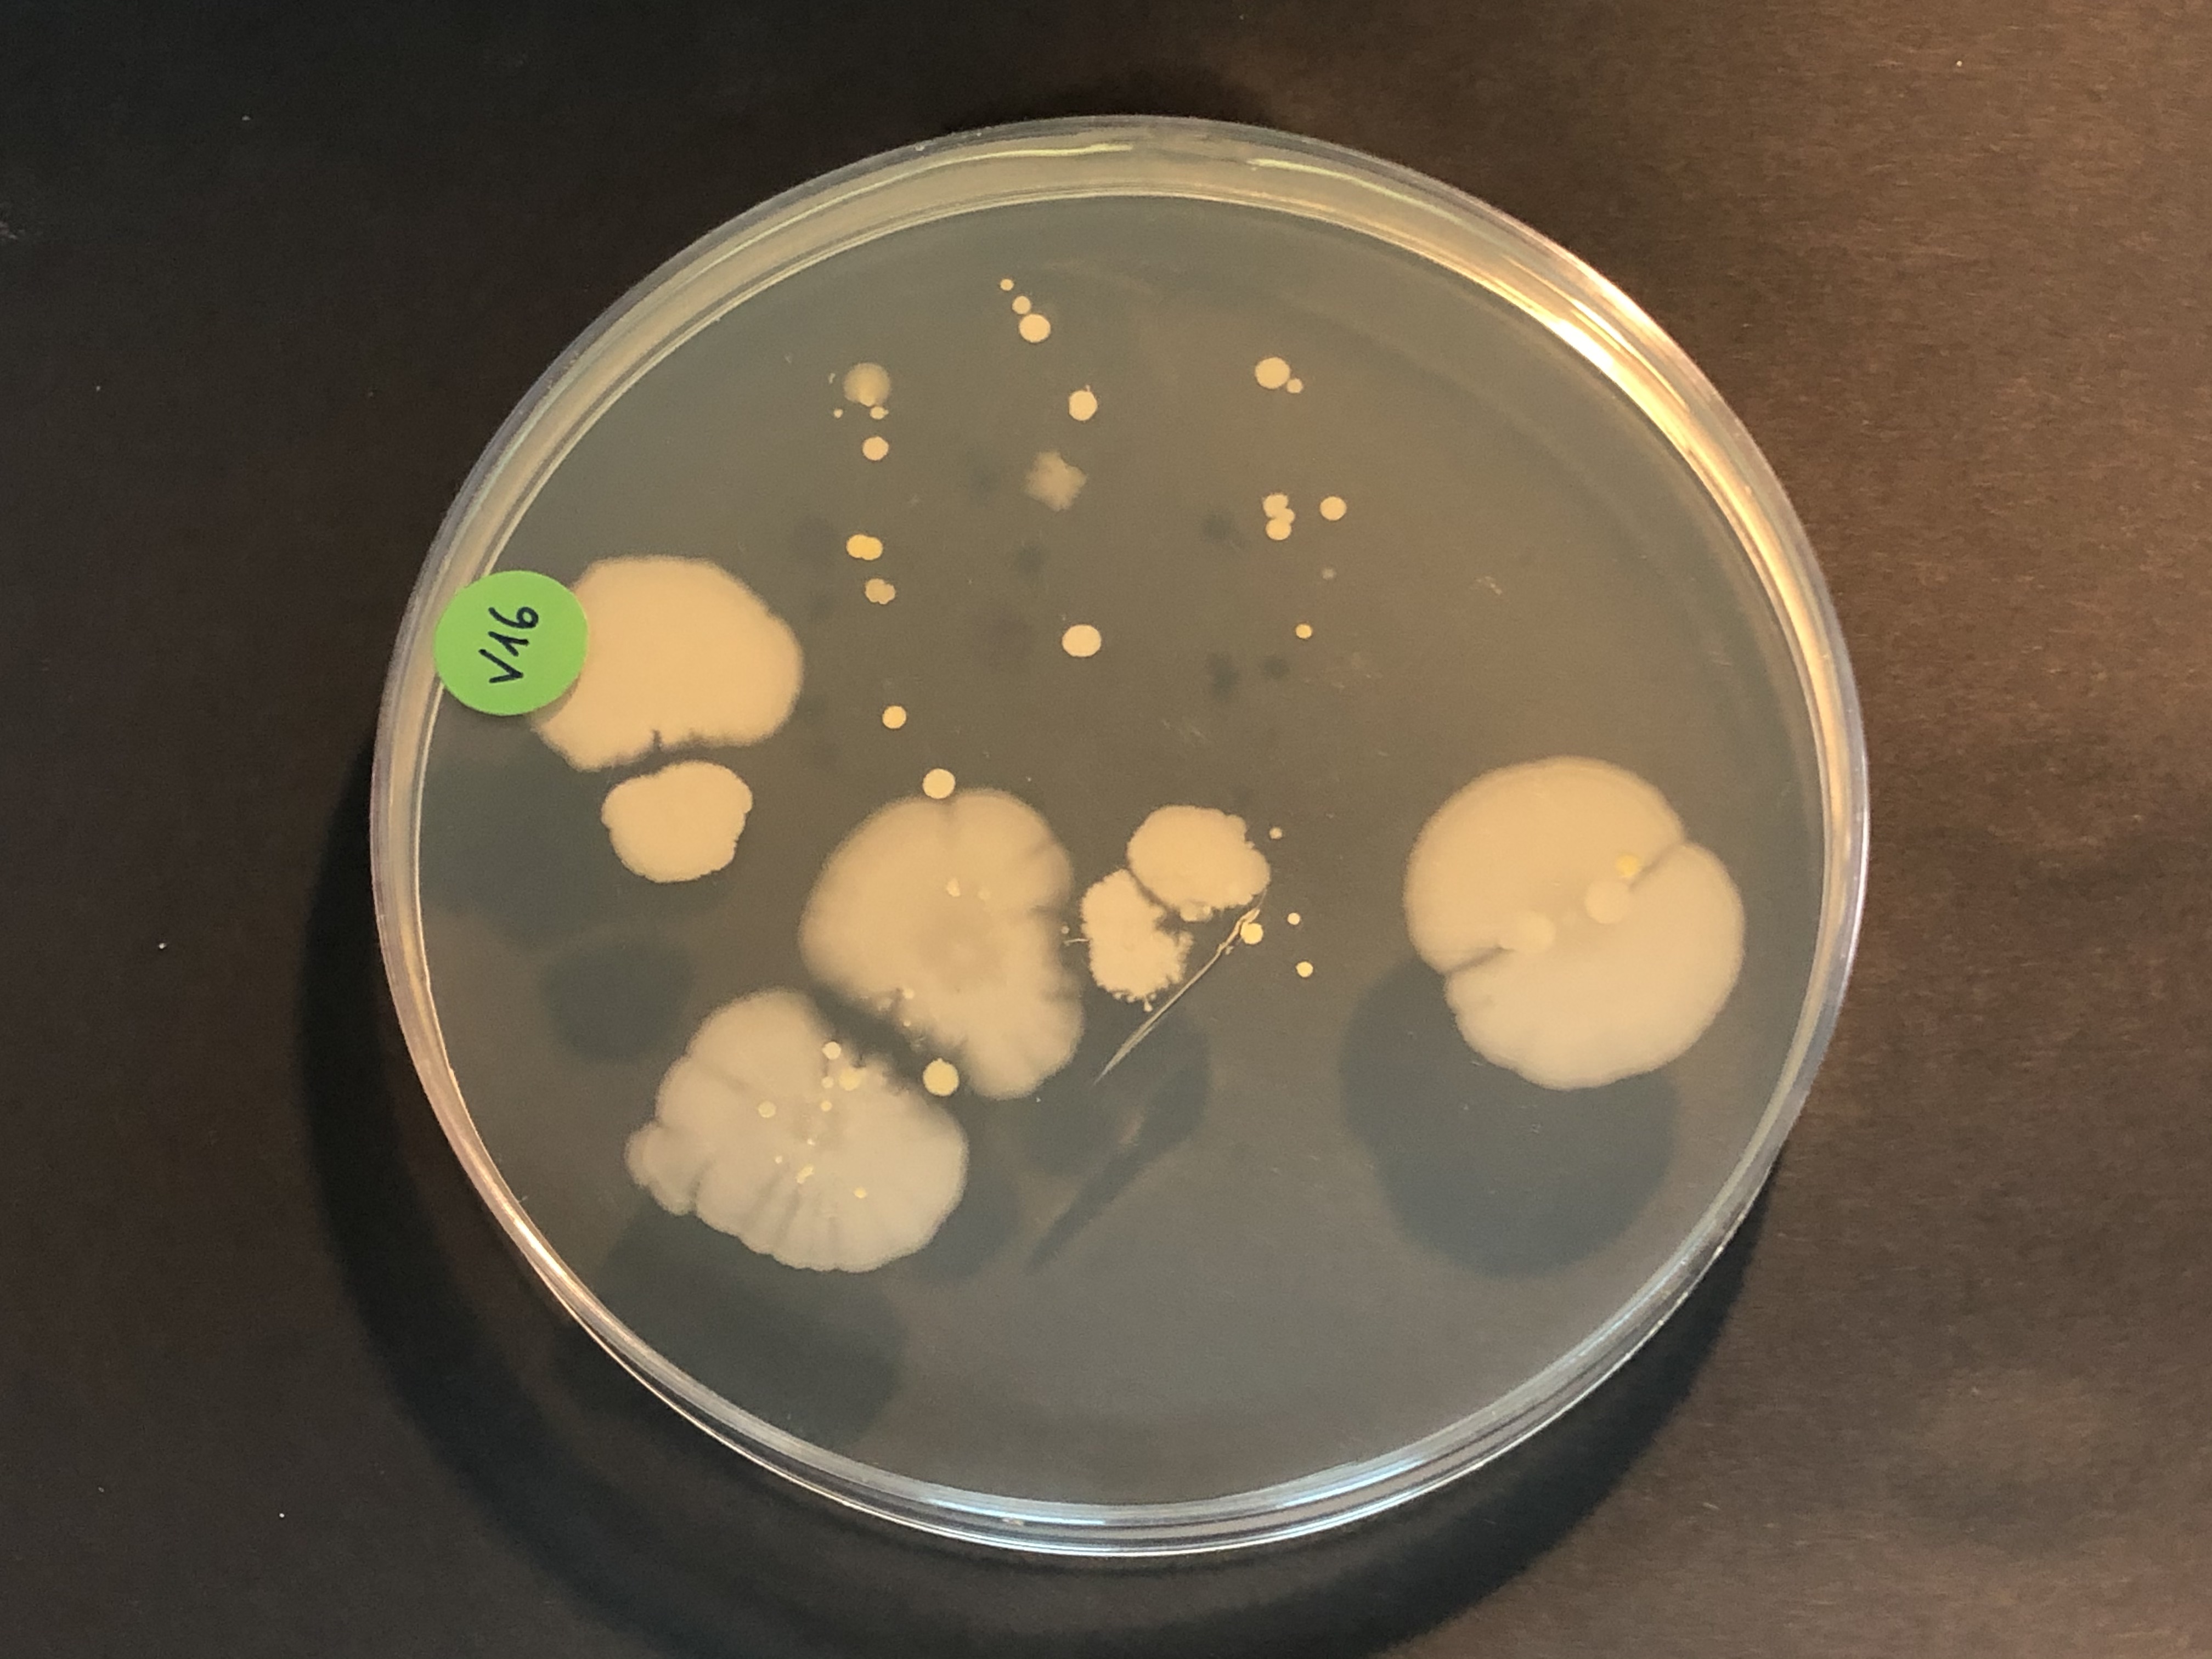
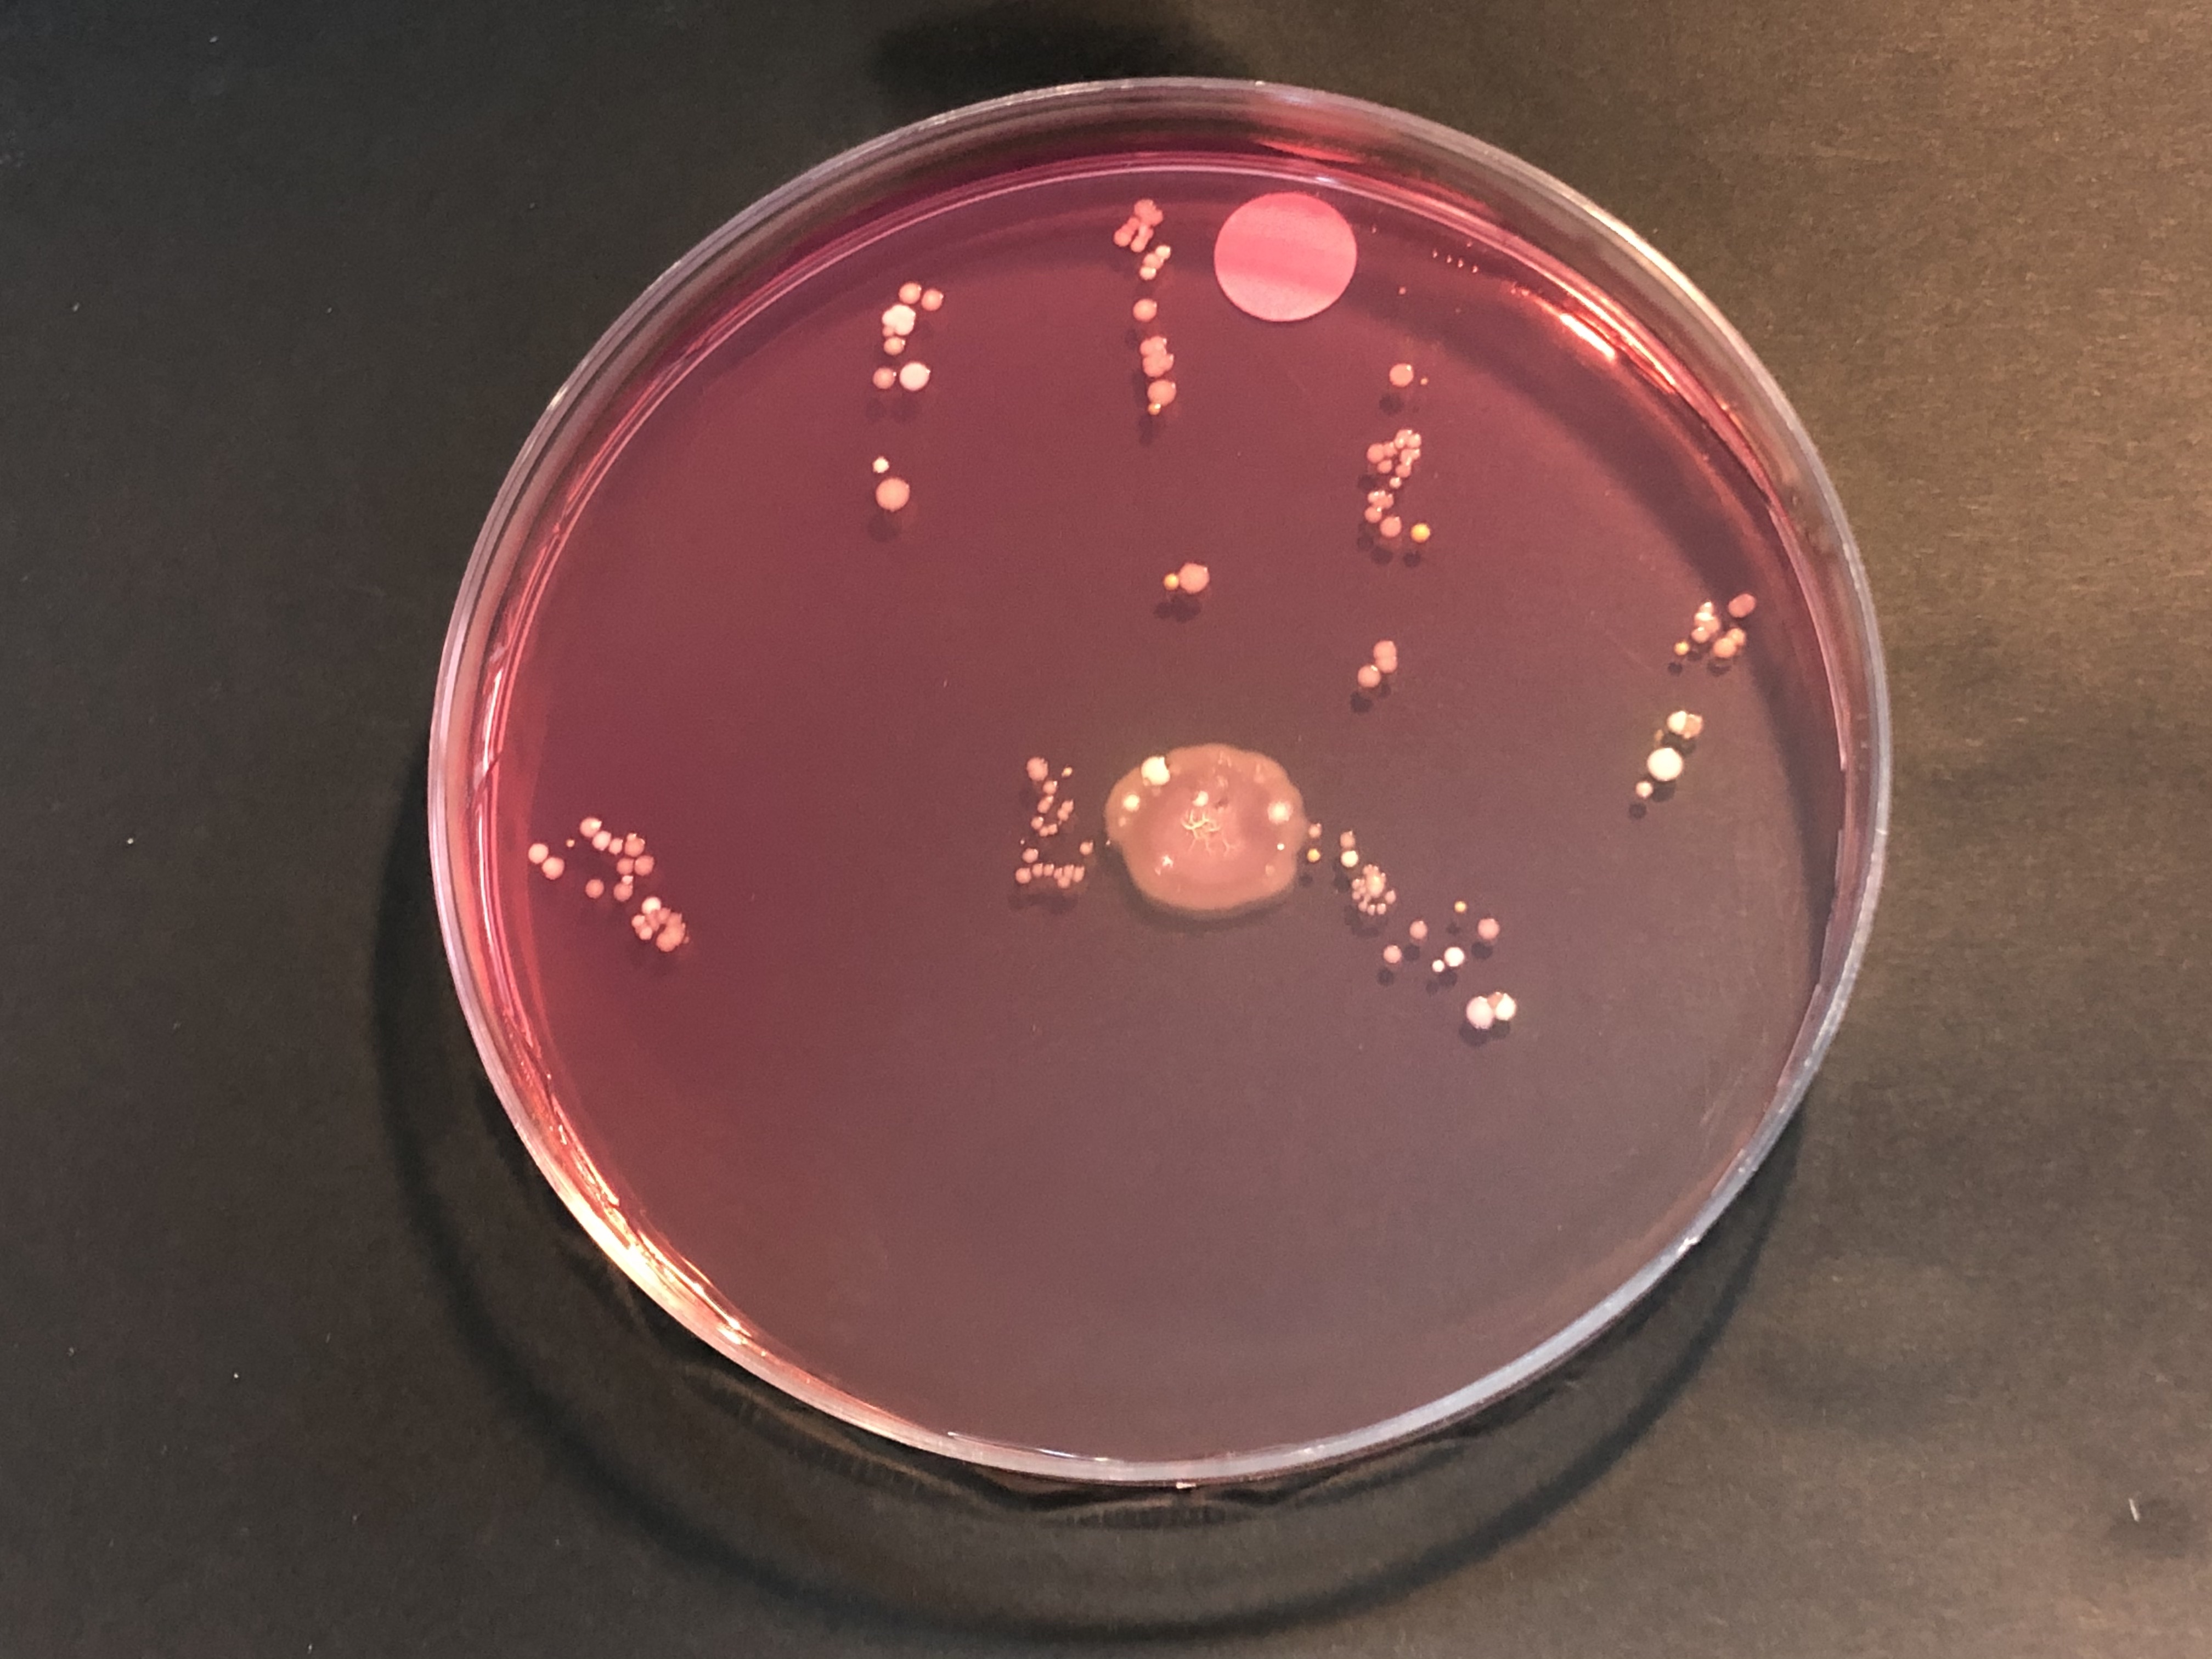
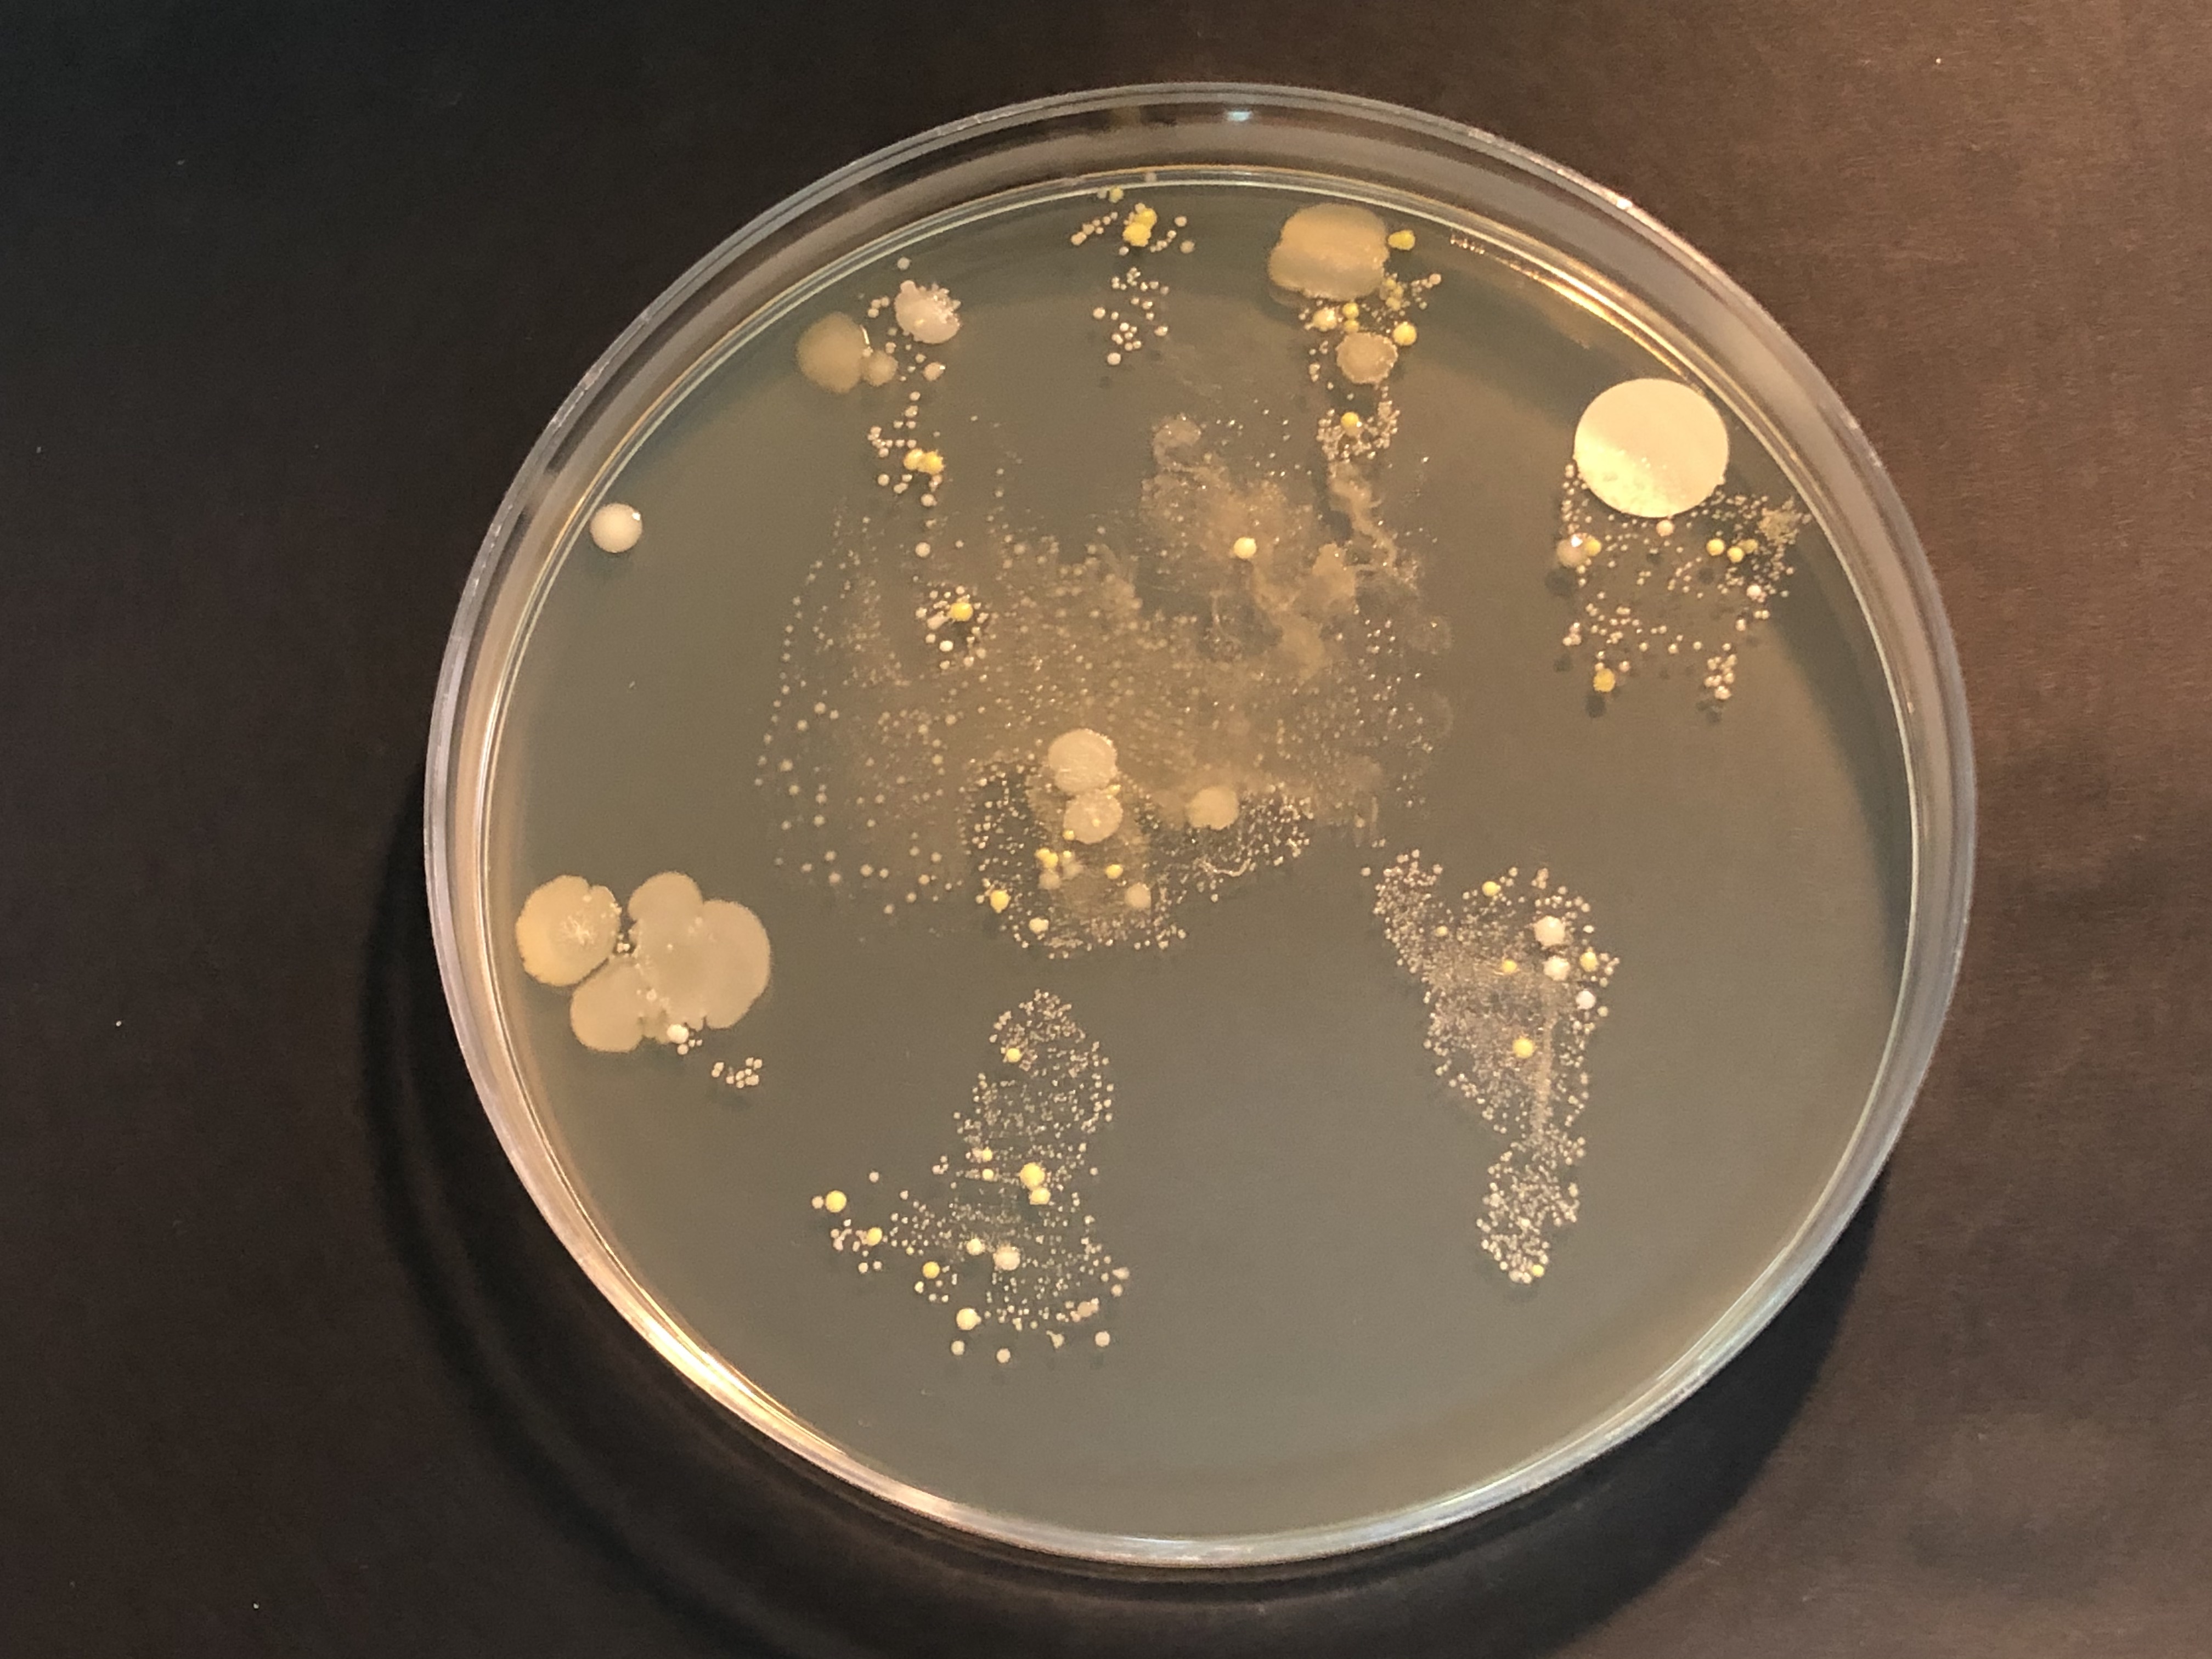
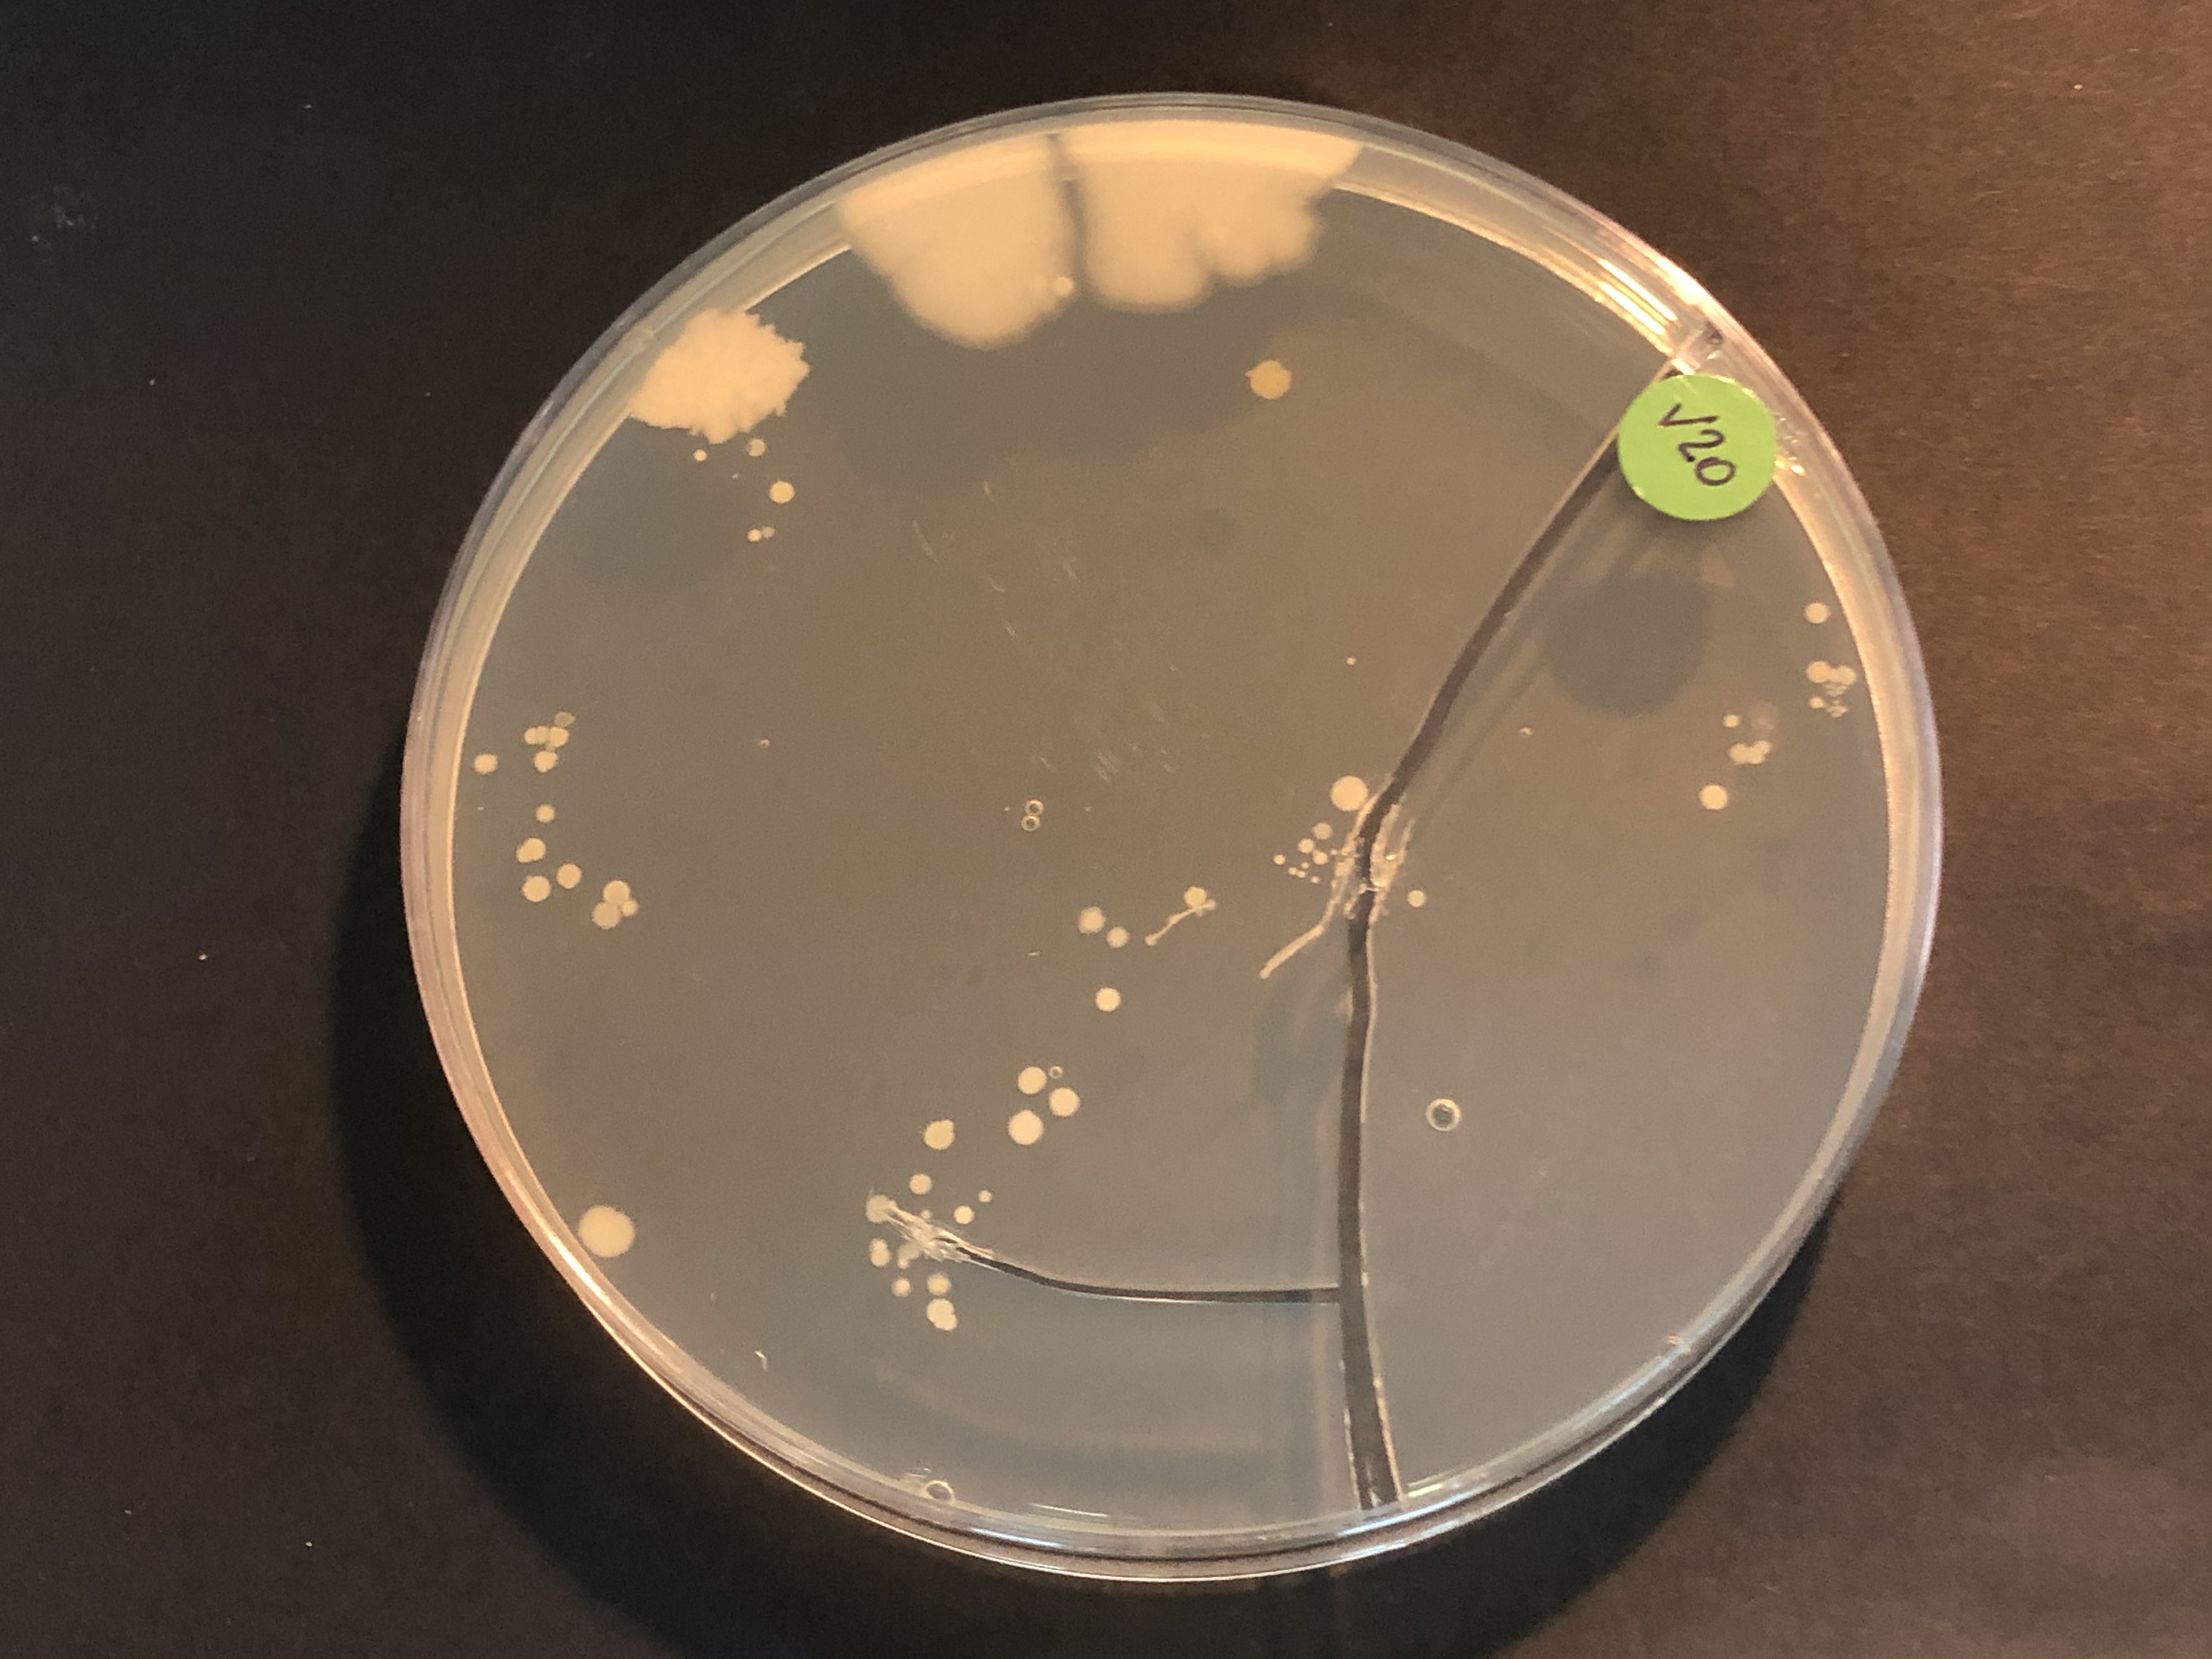
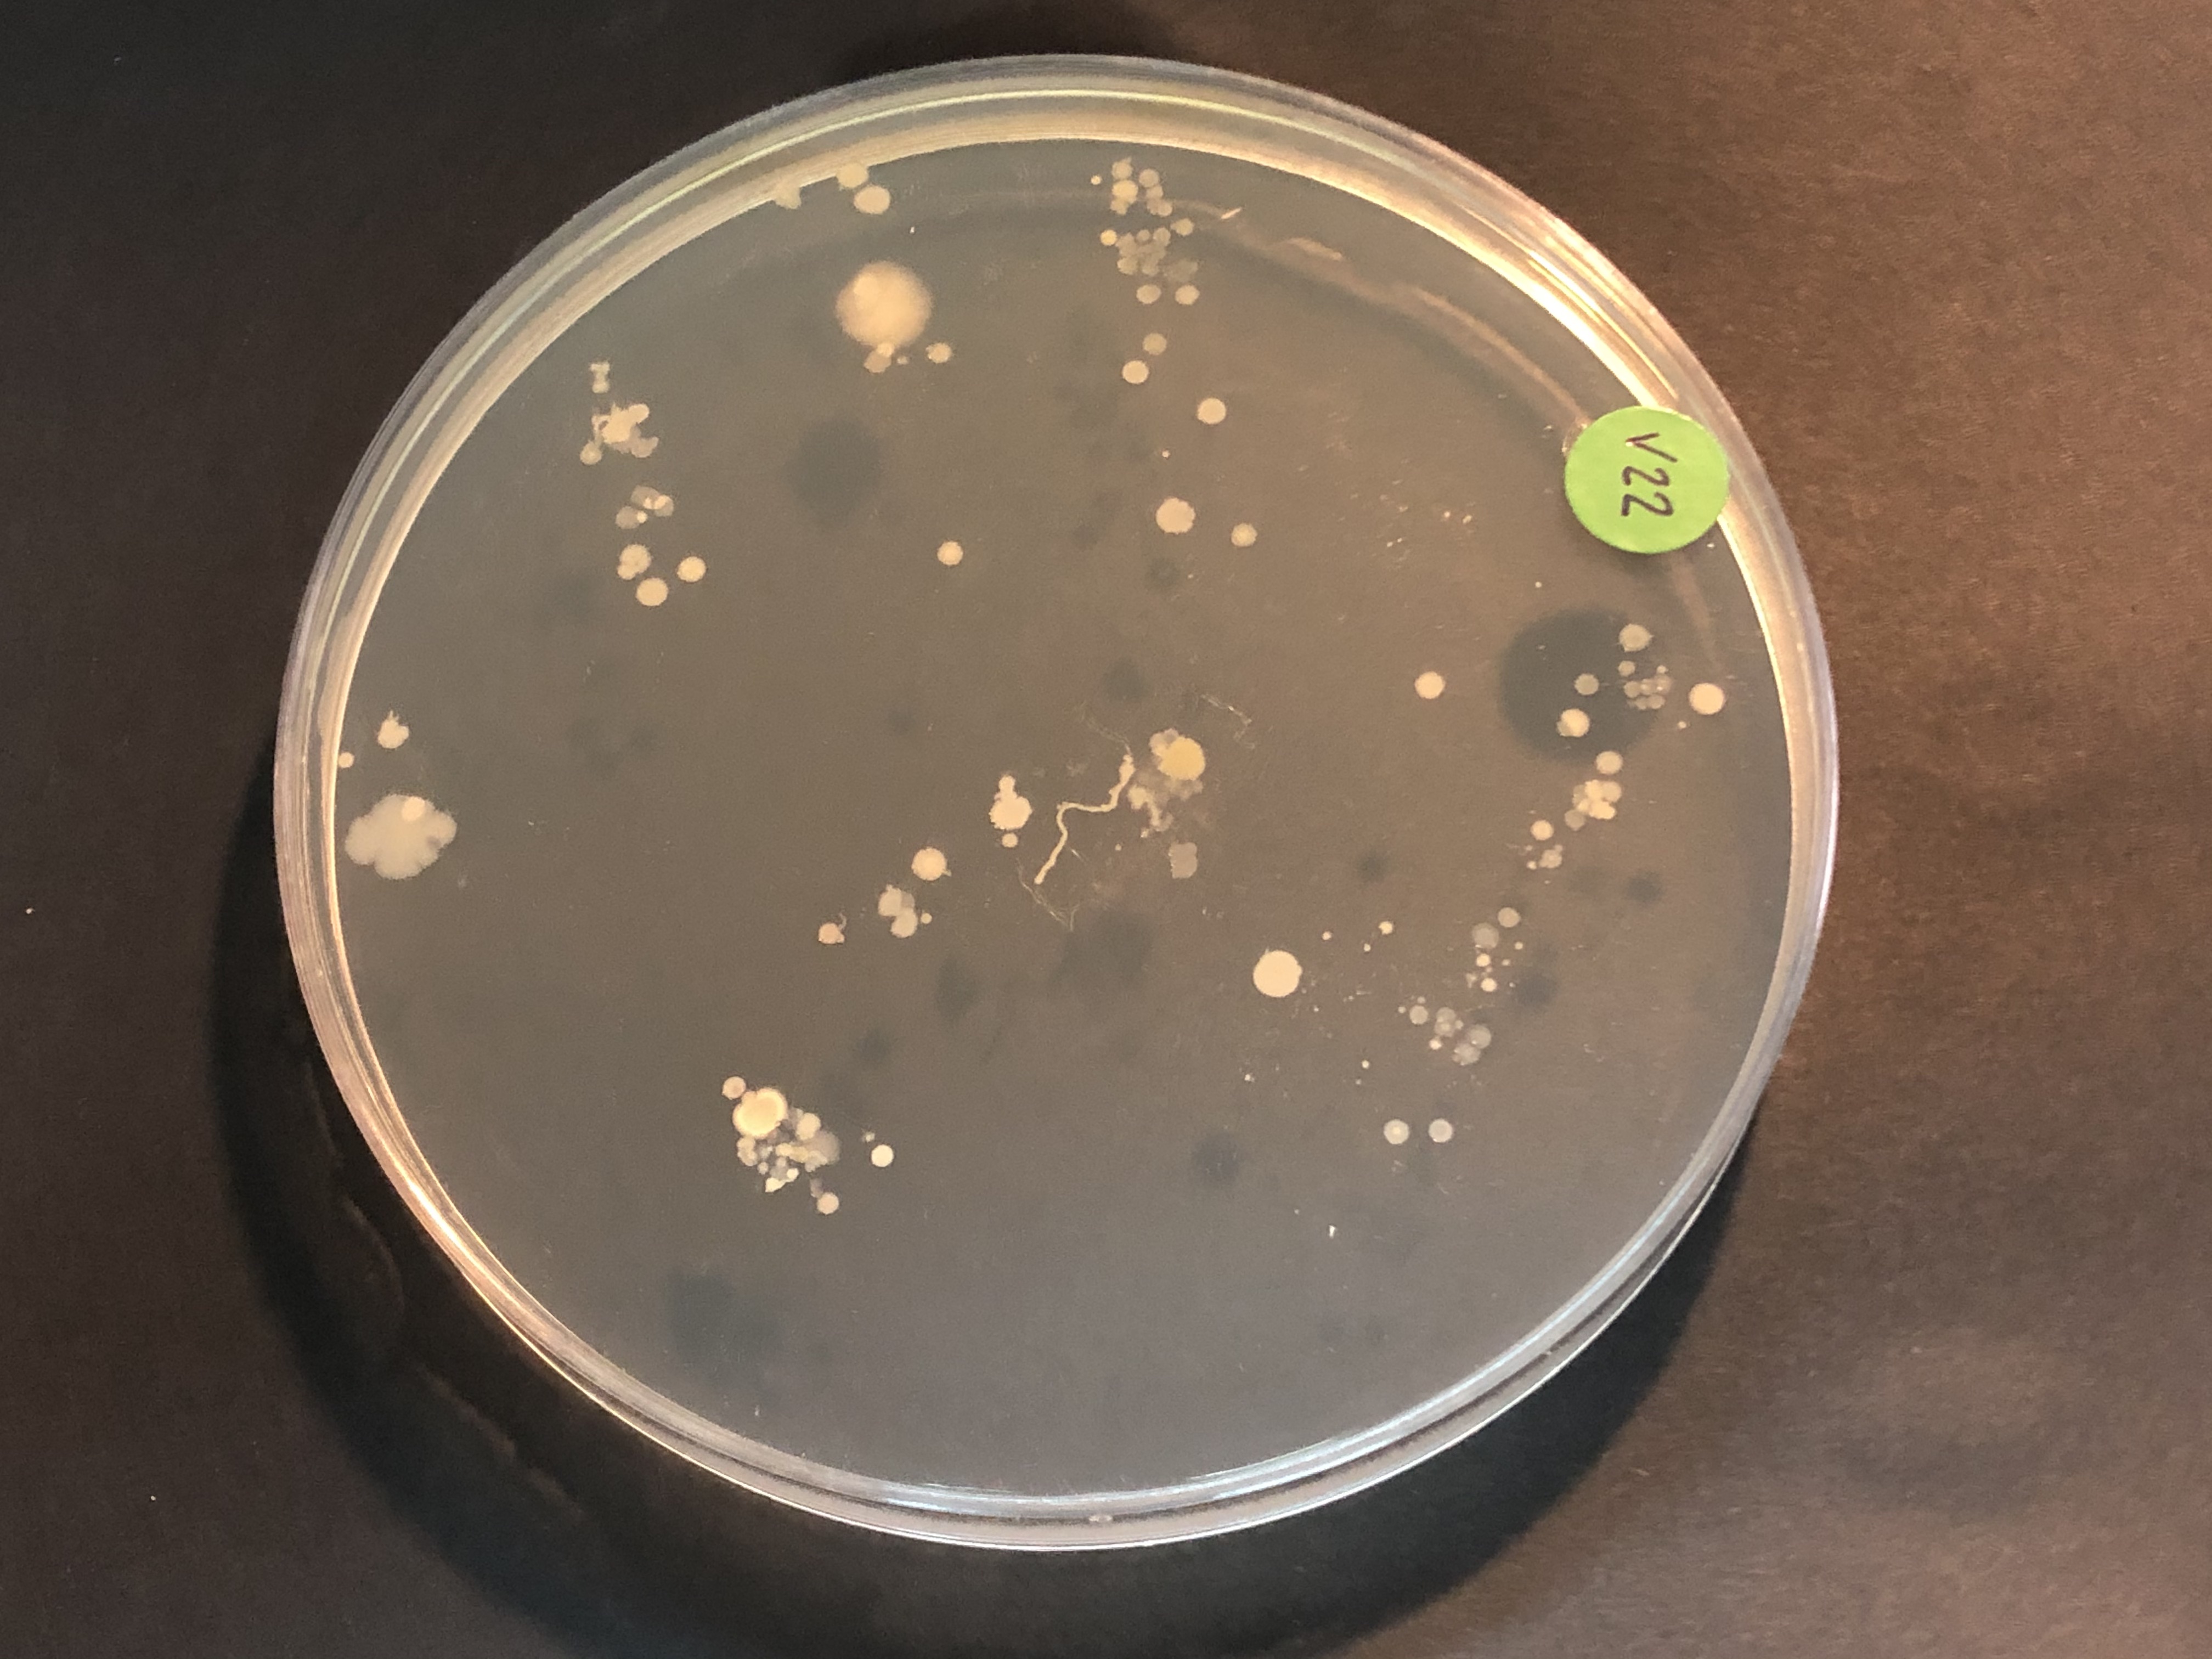
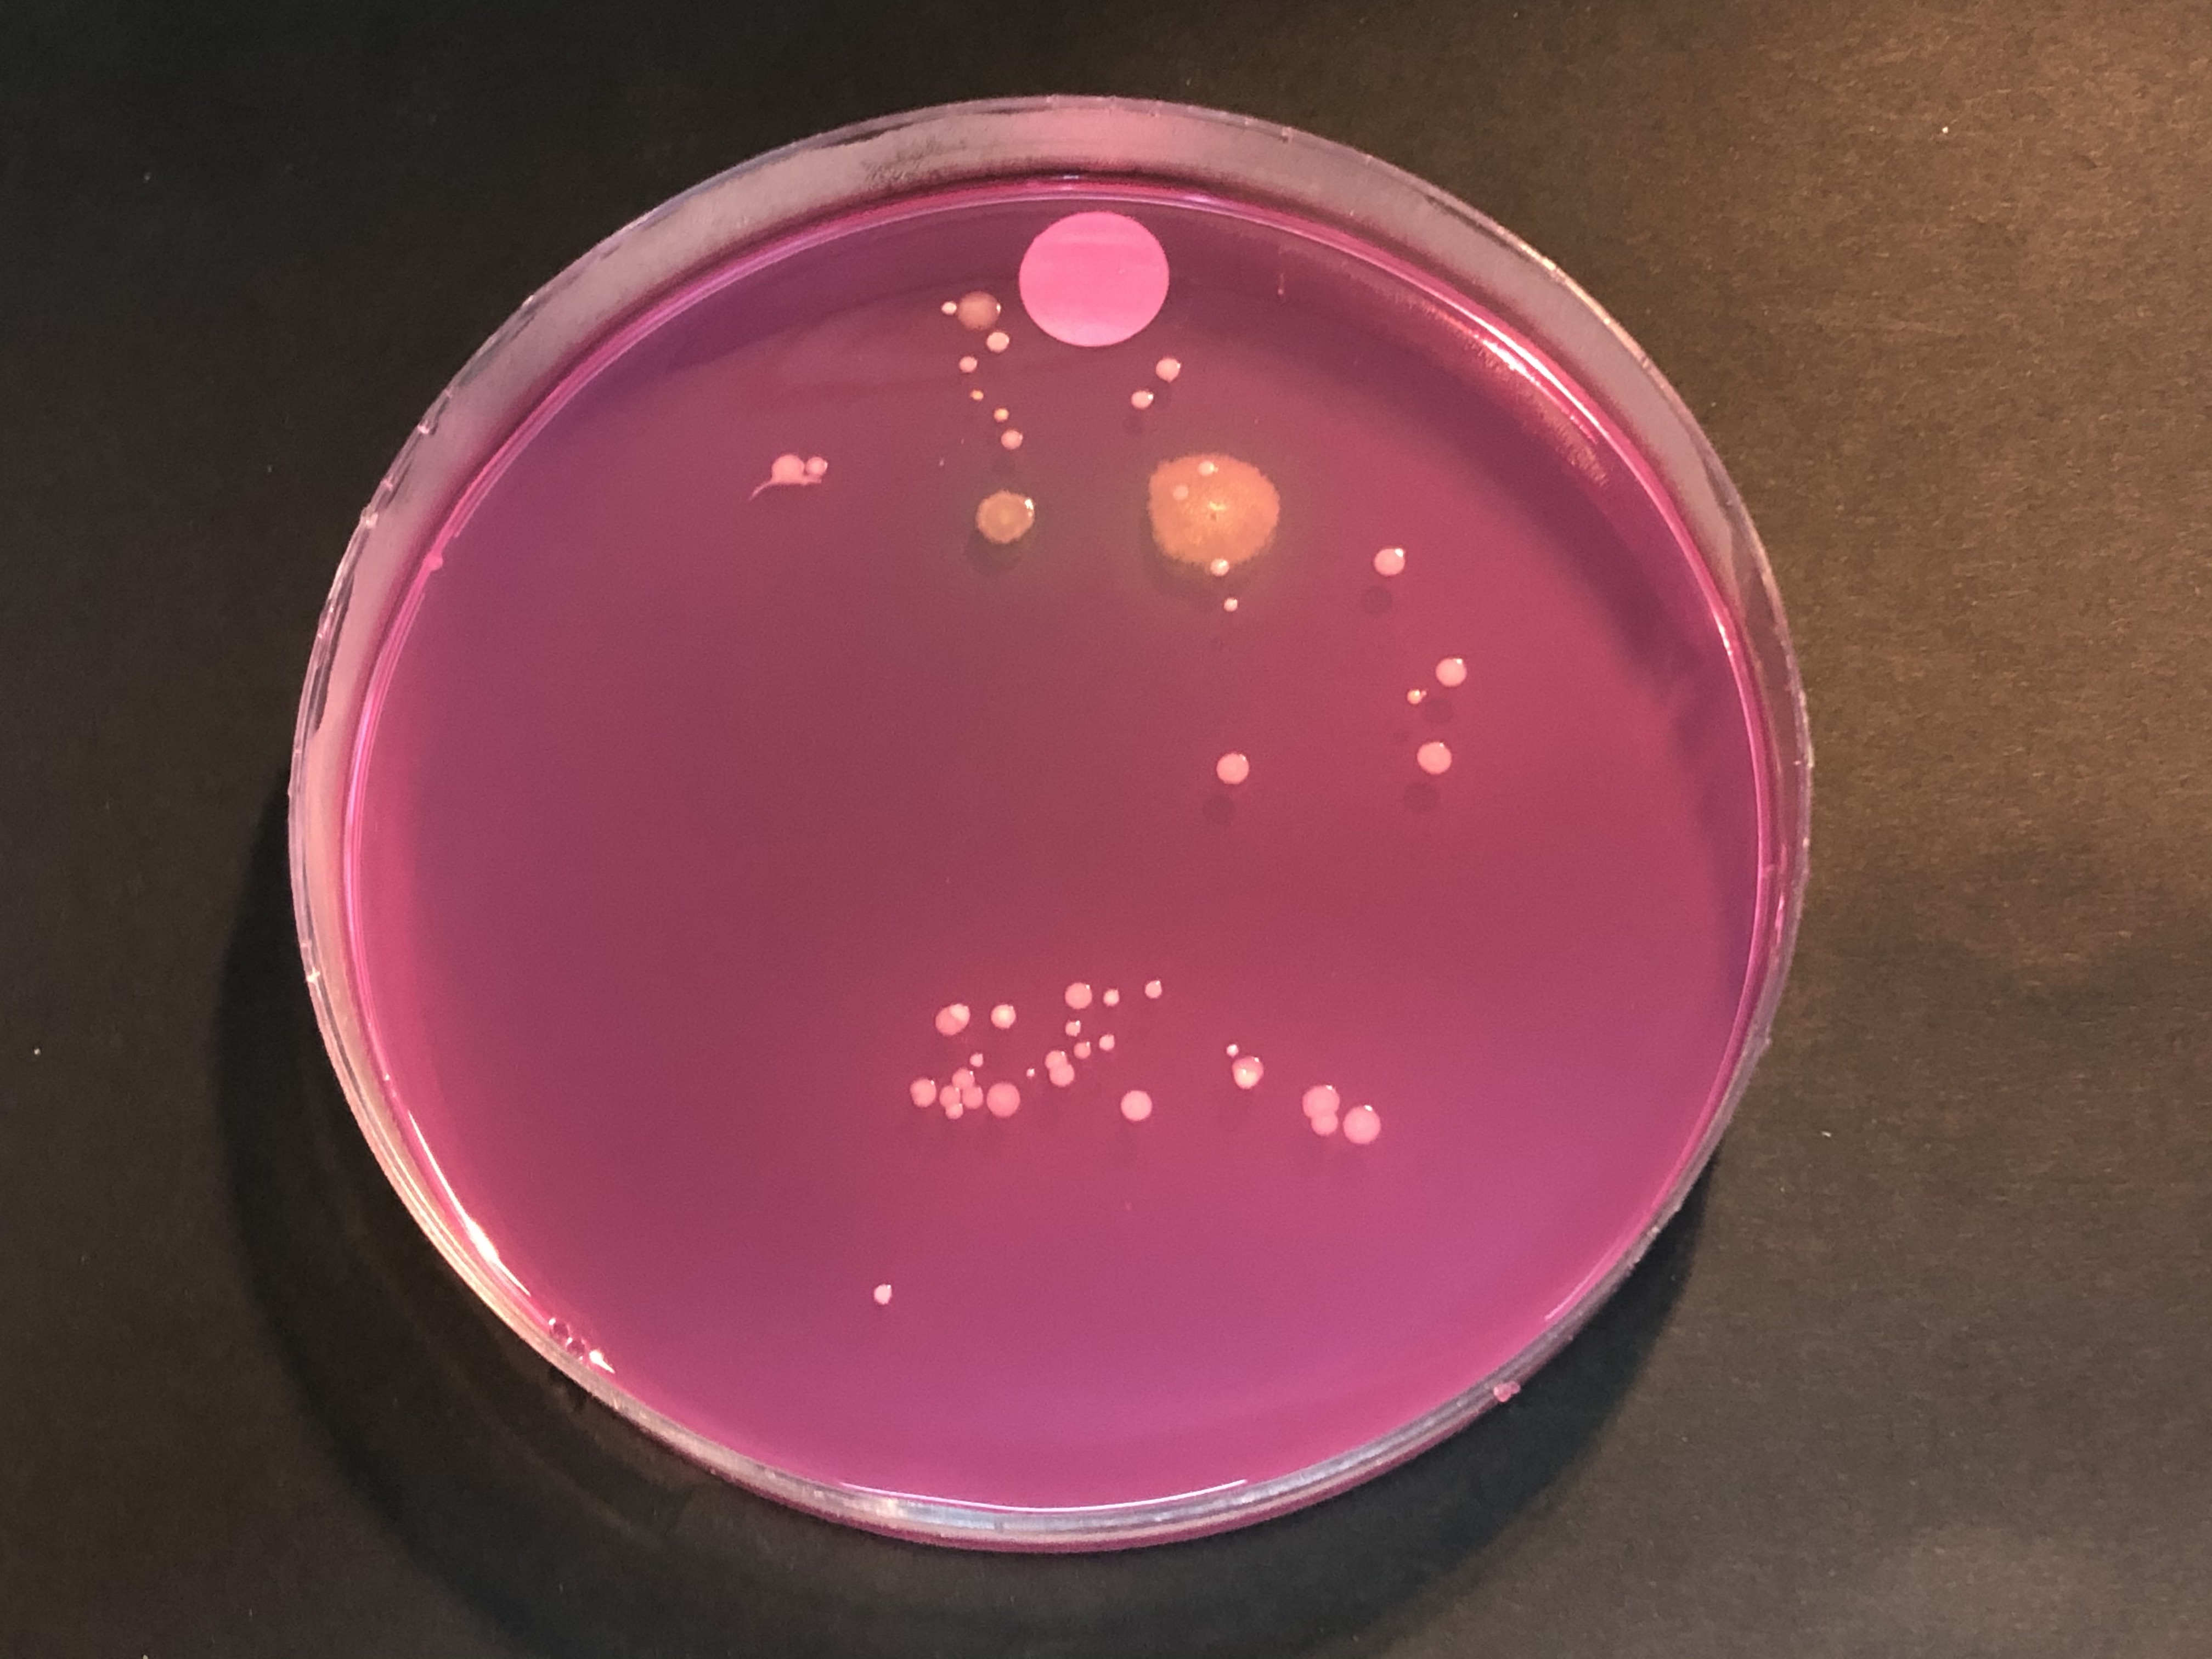
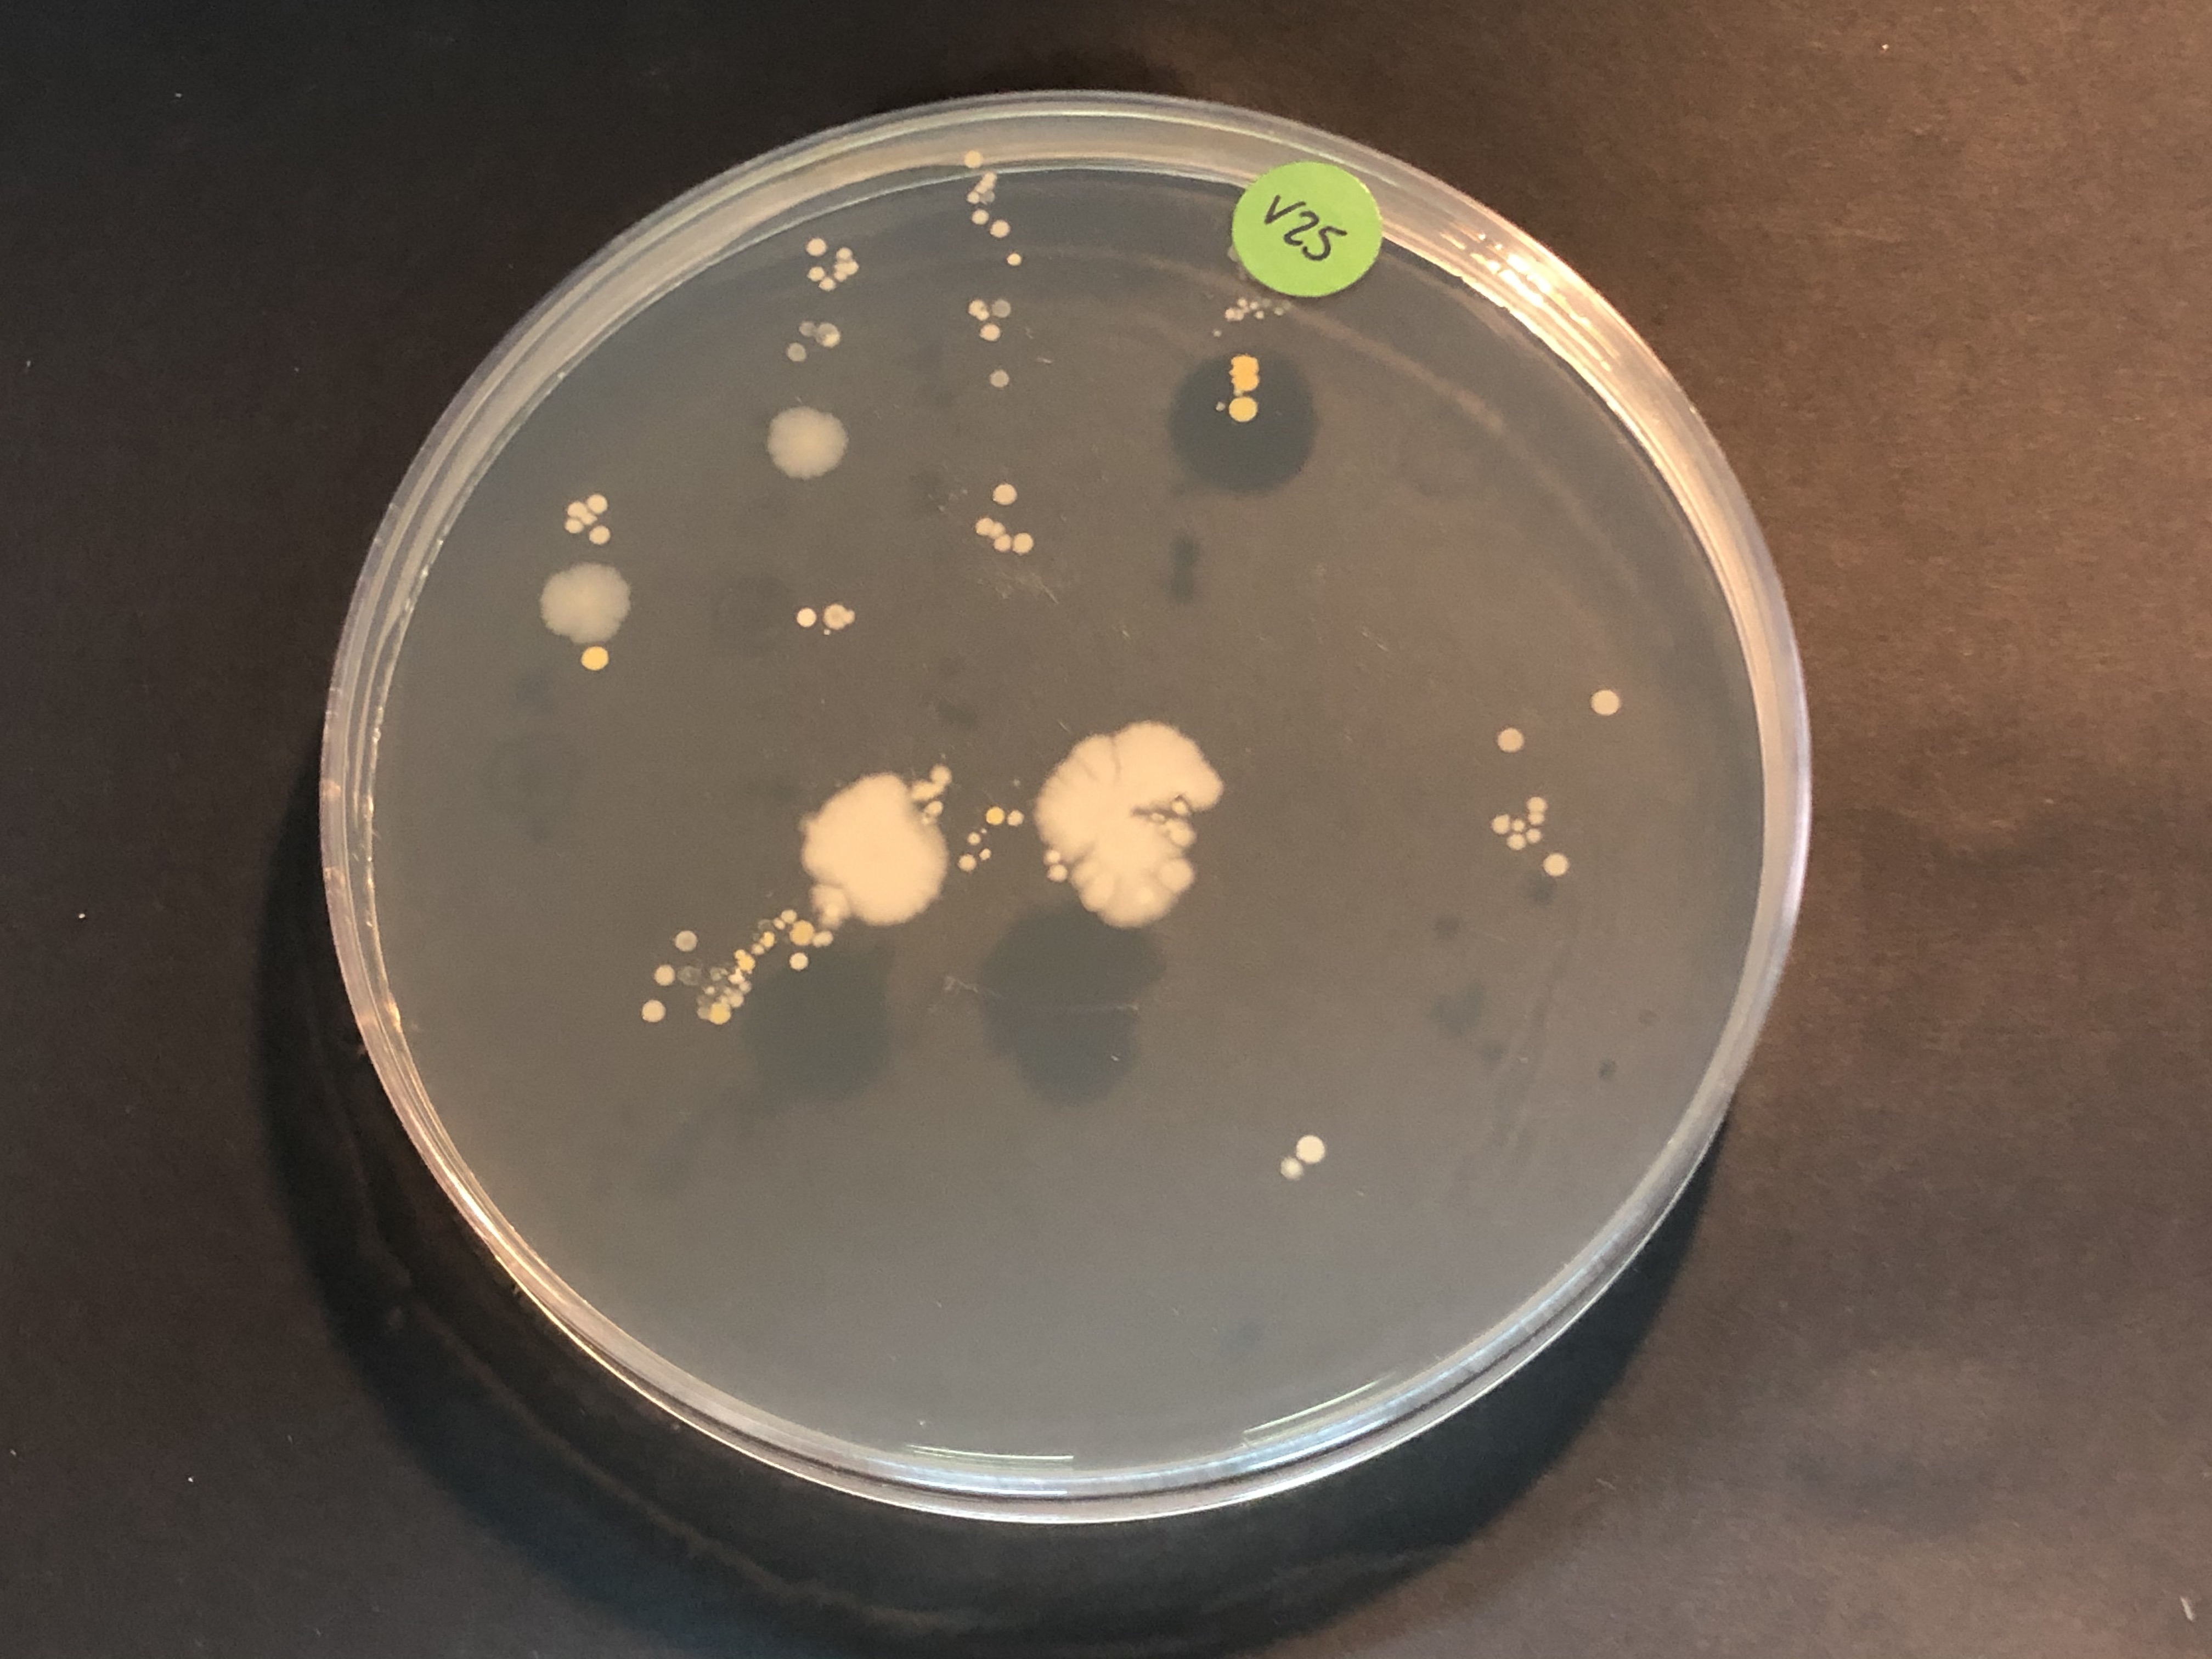
V25
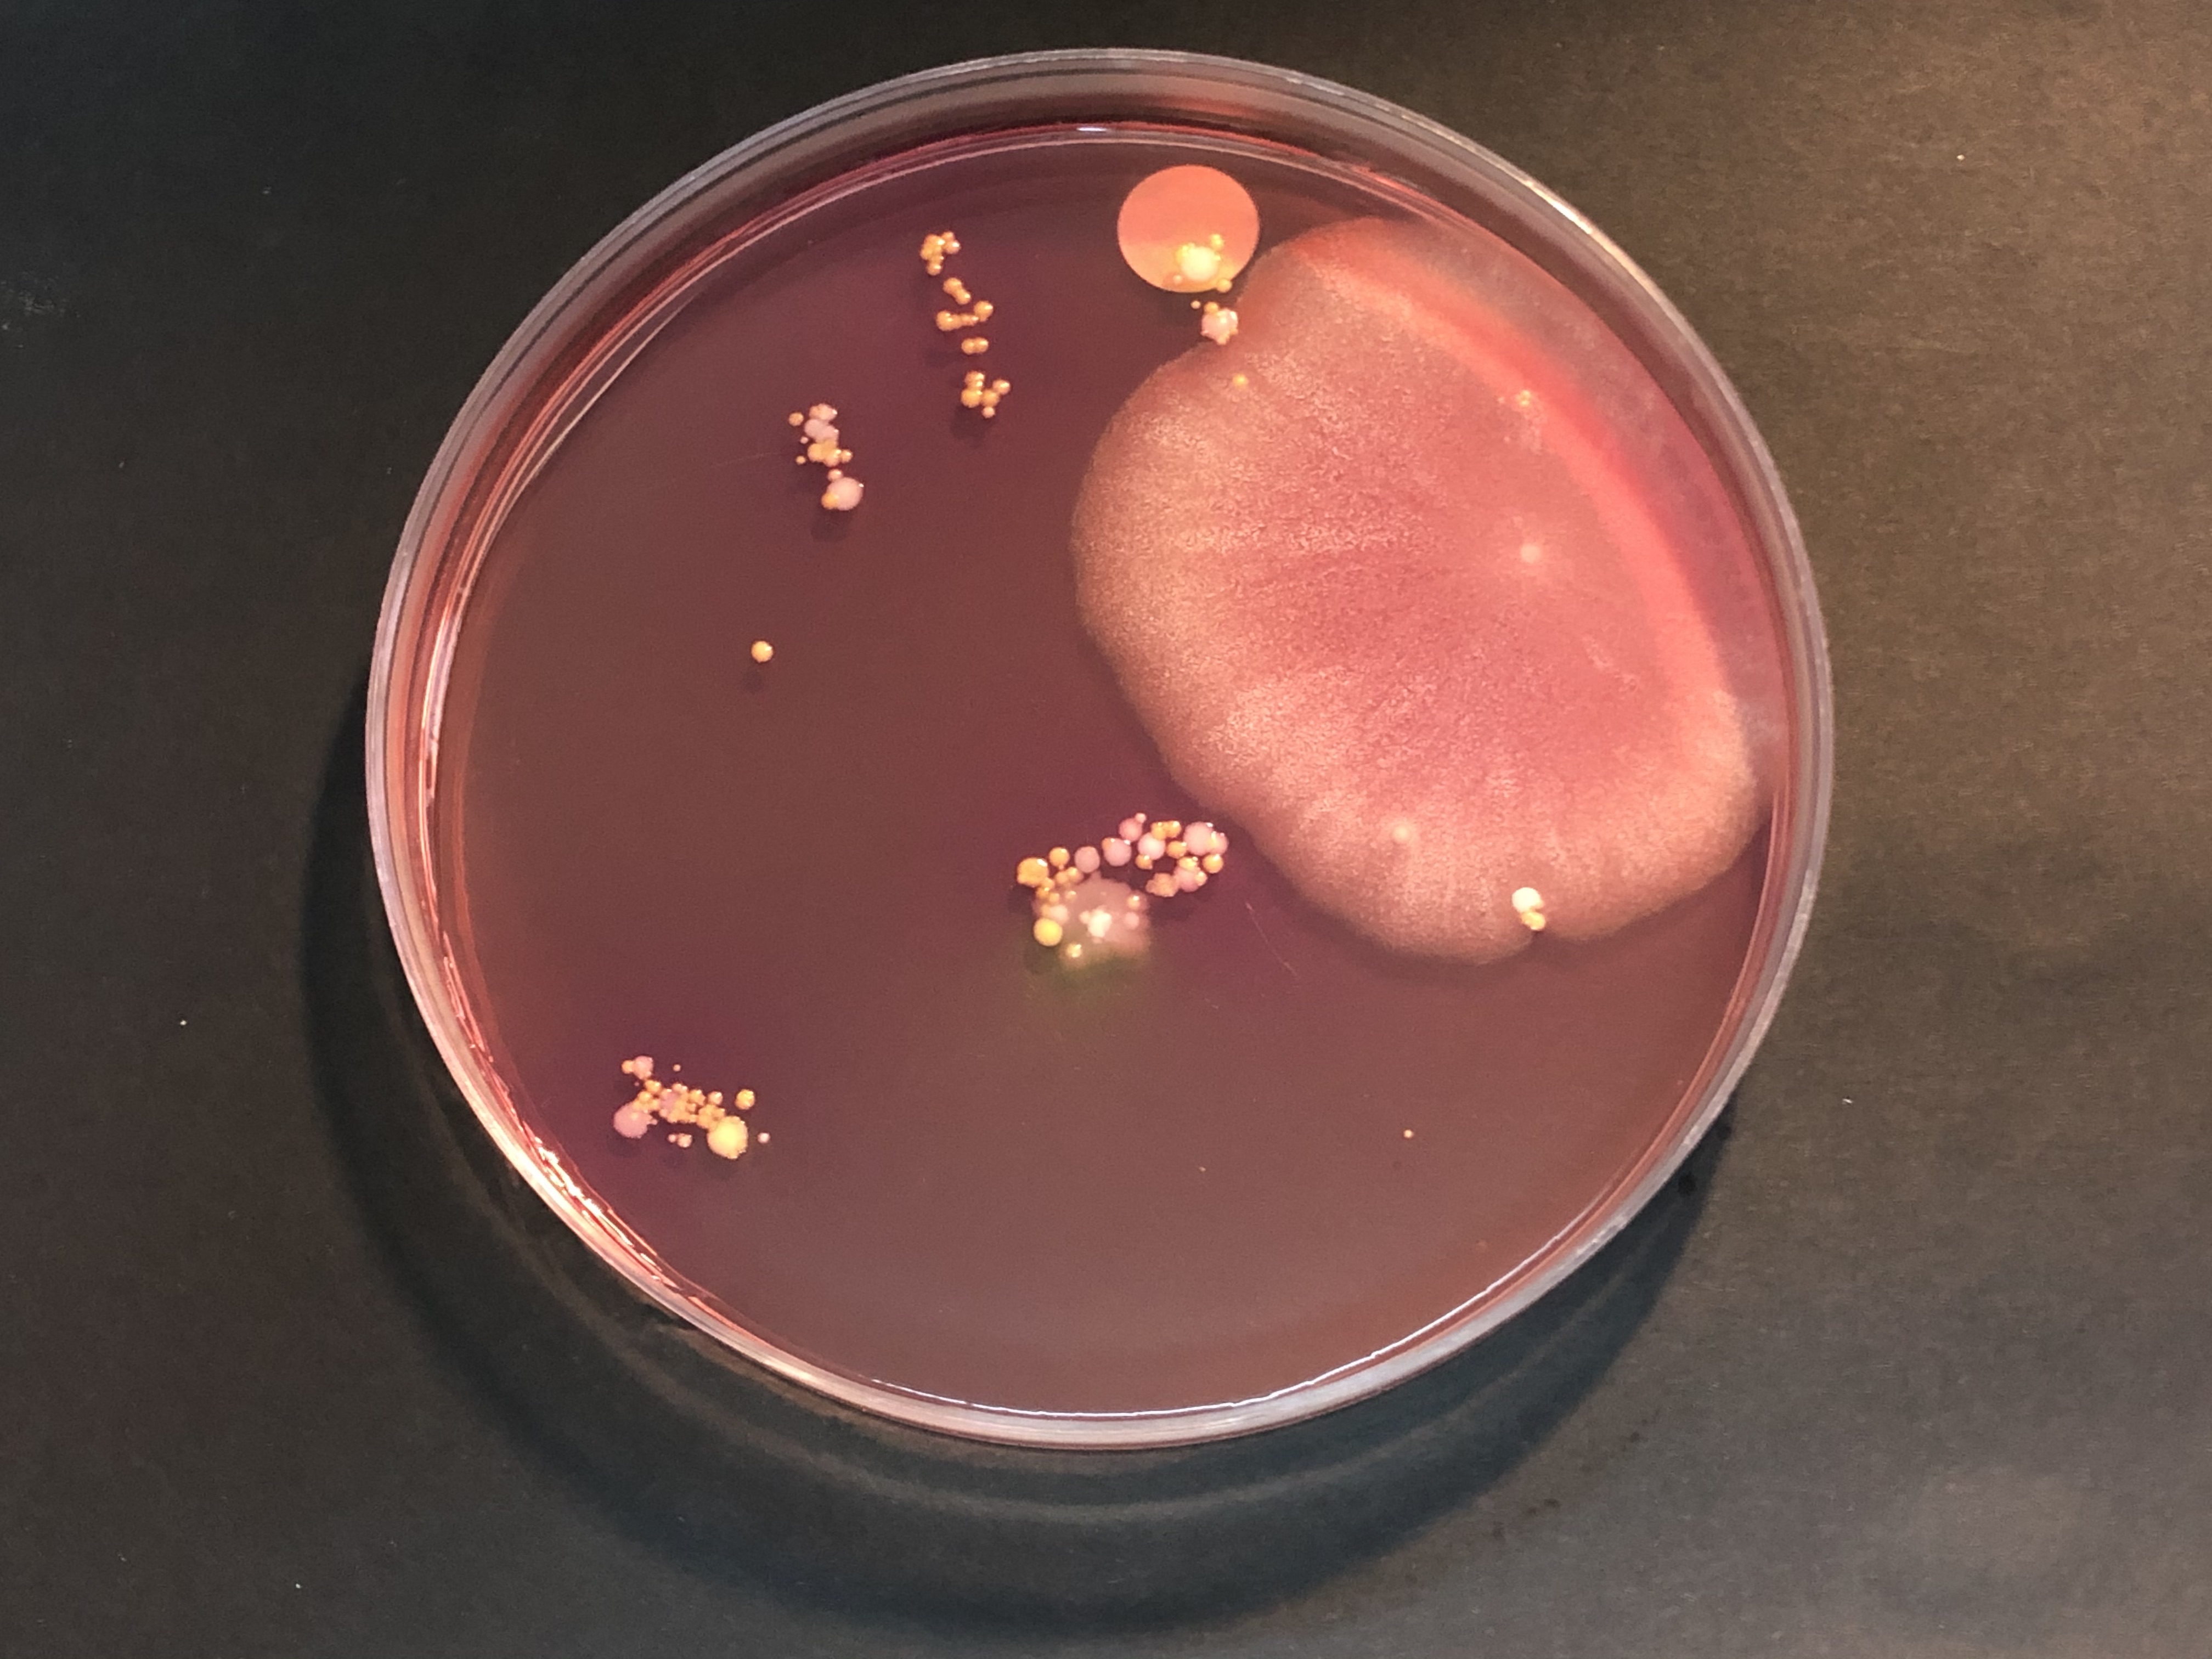
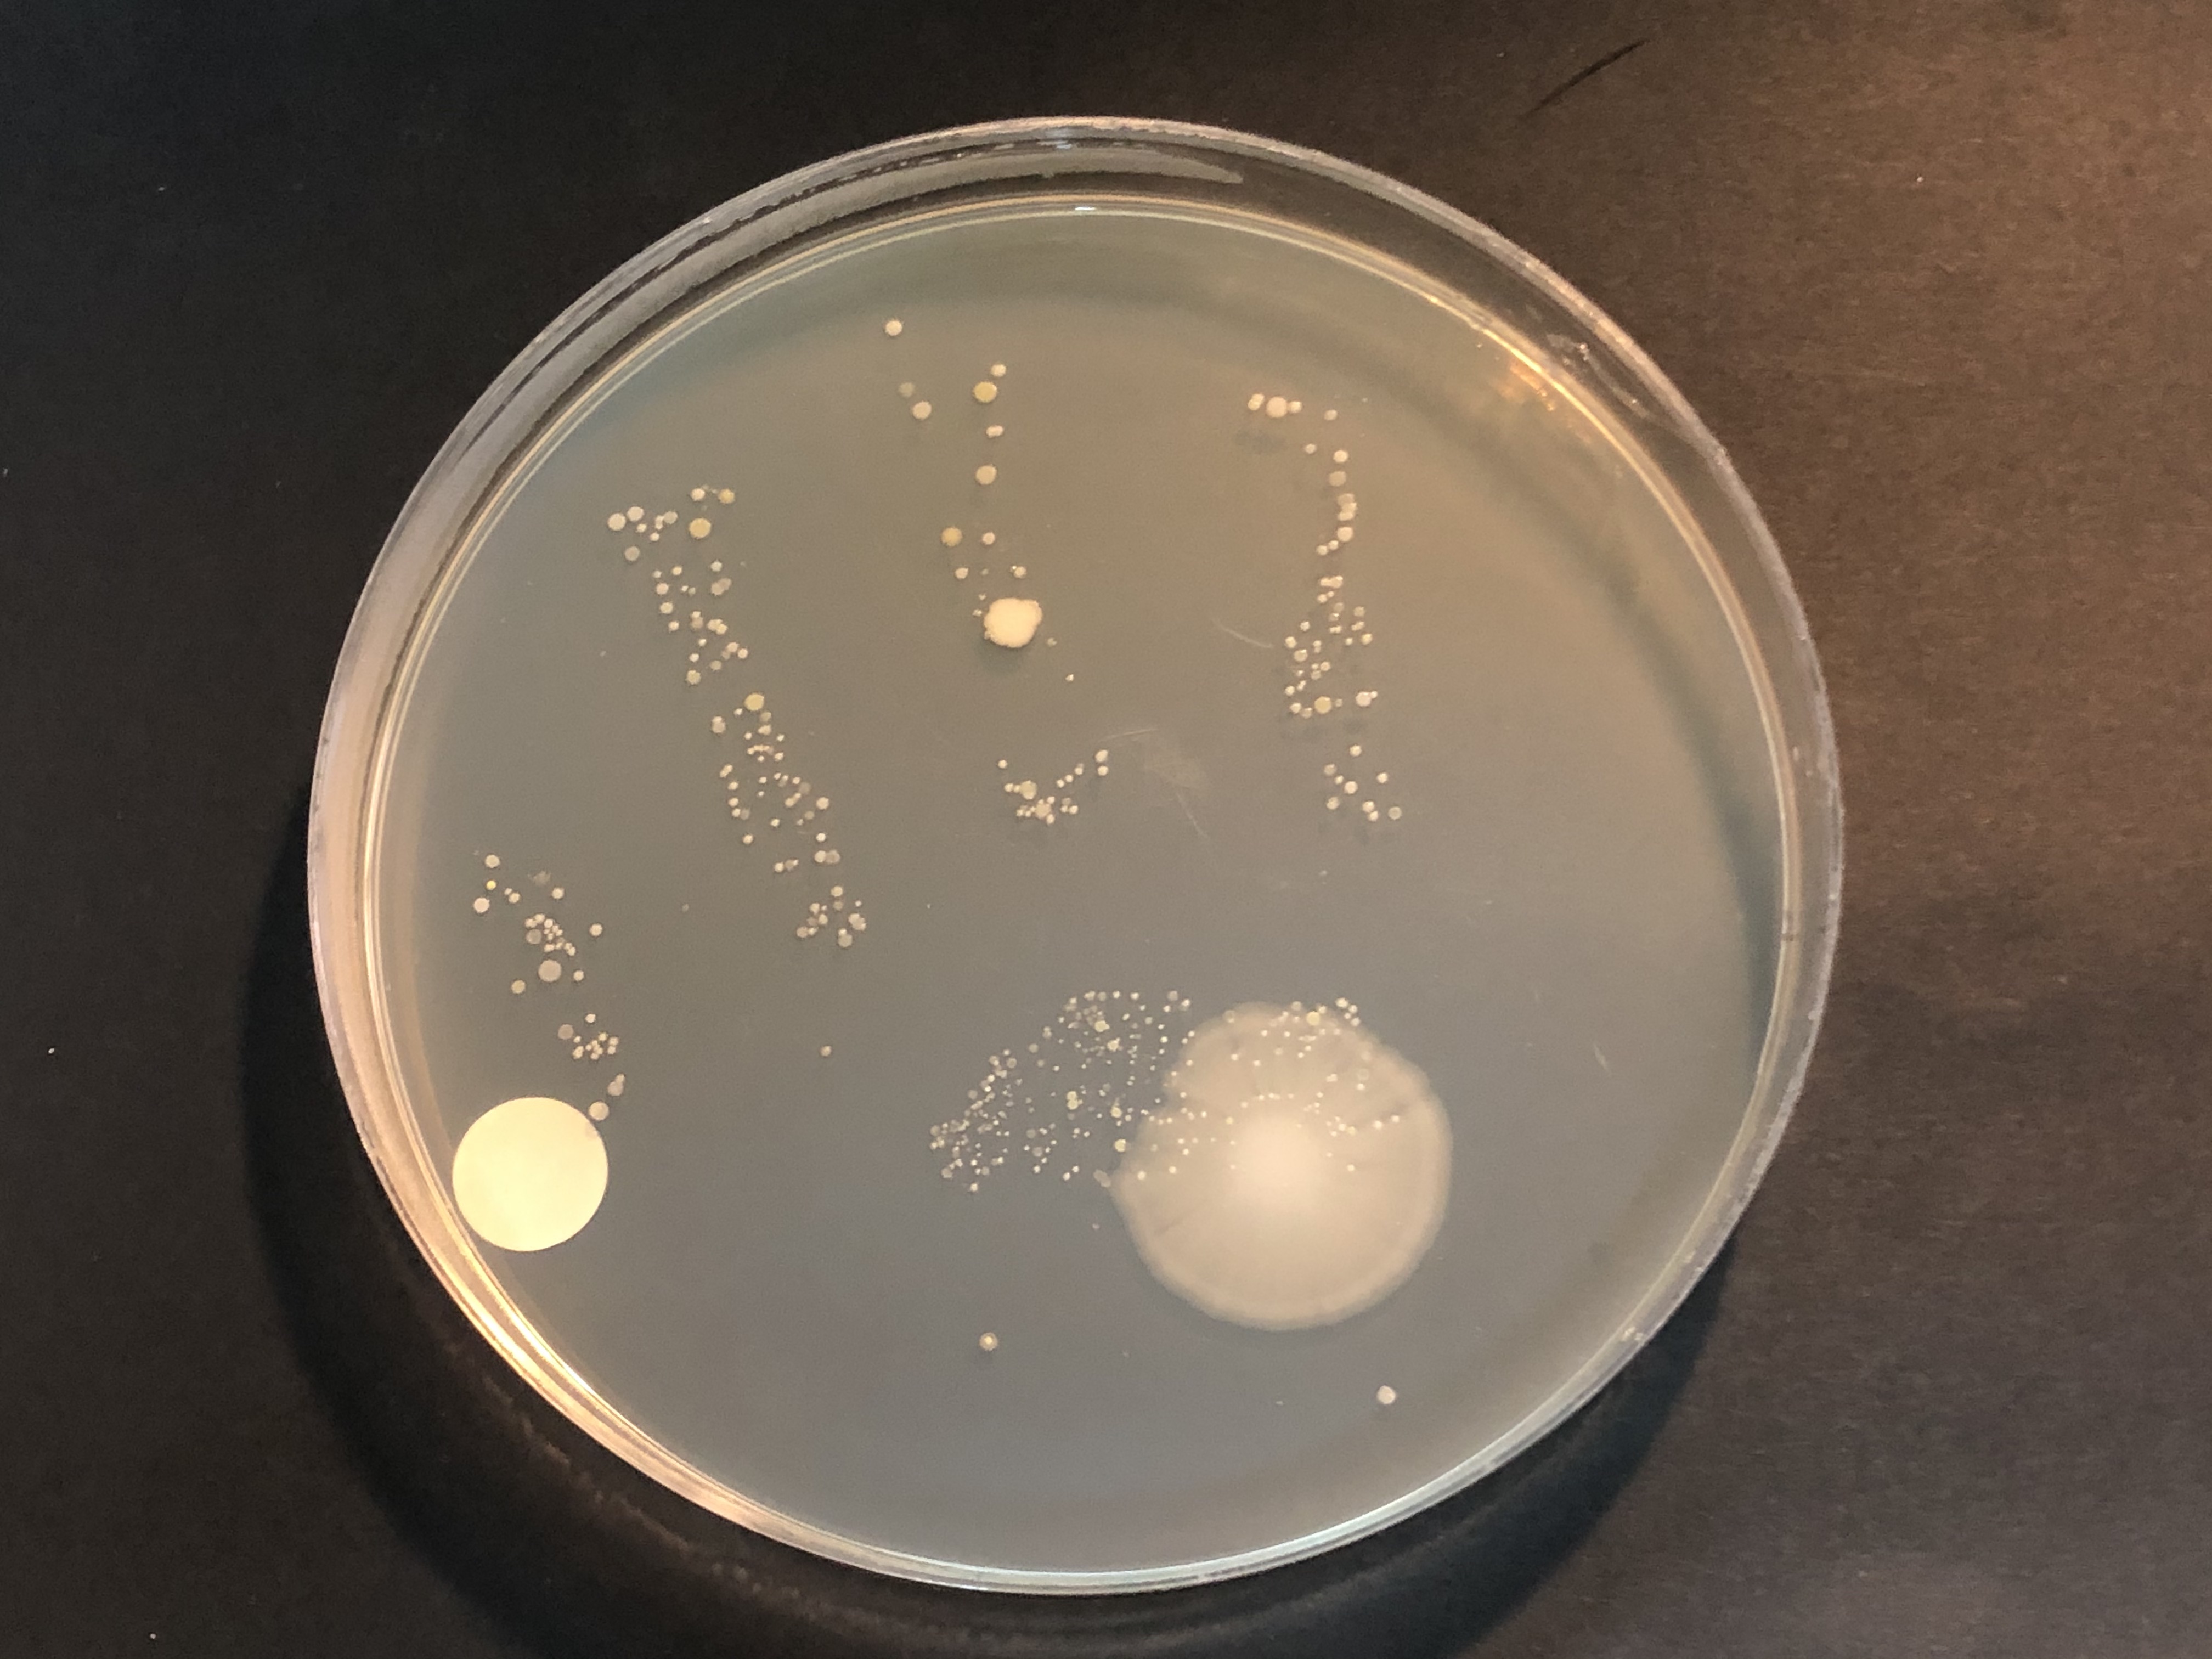
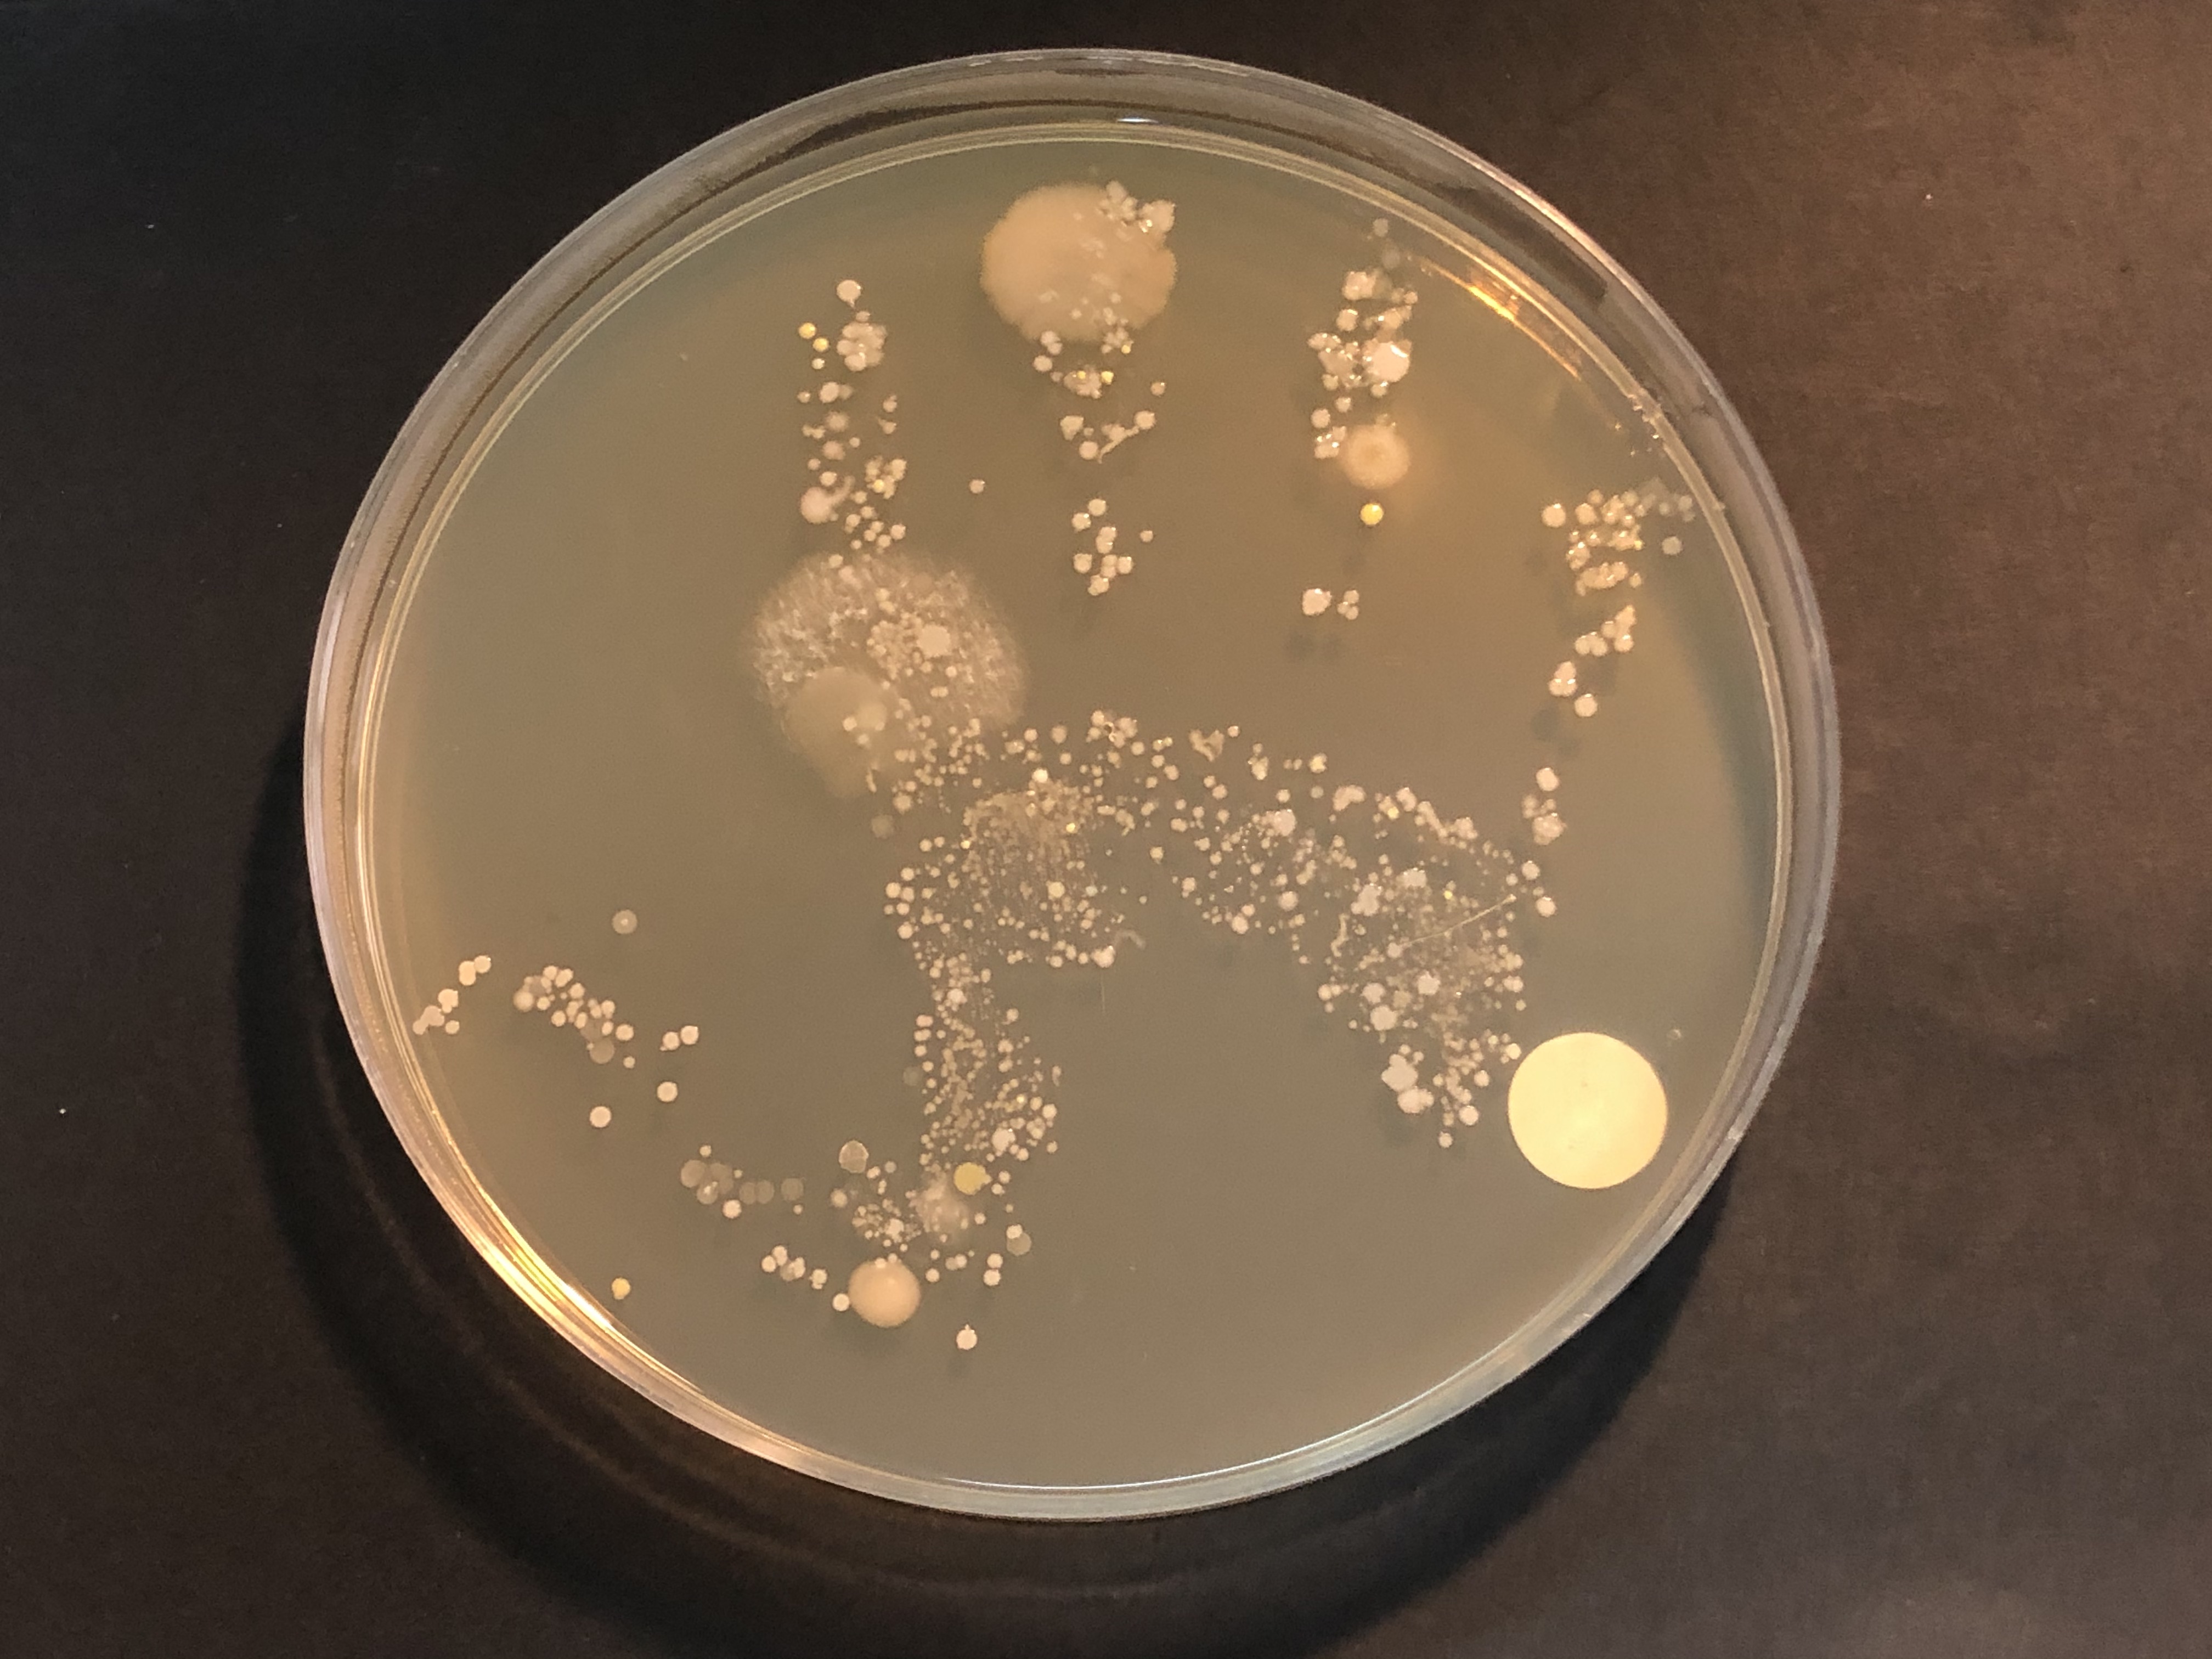

October 19th, 2019 – CIRCLES at UNIJUNOR, Bologna
UNIJUNIOR, 19 Ottobre 2019
UNIJUNIOR (https://www.unijunior.it/) is a brilliant and unique initiative of the four Universities in Emilia Romagna, Italy, in which 8-14 years old kids can live the experience of being academic students for one day and listen to lectures that university professors crafted for them. Prof. Marco Candela, CIRCLES coordinator, was asked to give a lesson about the microbial world in which we live to a hundred of kids at the University of Bologna on October 19th, 2019.
The lesson title, “Did you know we are 90% bacteria?”, attracted more than 100 curious little students and the CIRCLES coordinating team of Bologna had the chance to raise awareness in “the scientists of the future” about the microbial counterpart that populate our planet and allows for our survival.
UNIJUNIOR (https://www.unijunior.it/) è una brillante e unica iniziativa delle quattro Università dell’Emilia Romagna in cui i bambini di 8-14 anni possono vivere l’esperienza di essere studenti universitari per un giorno e ascoltare lezioni che i docenti universitari hanno realizzato appositamente per loro. Il Prof. Marco Candela, coordinatore del progetto CIRCLES, è stato invitato a tenere una lezione sul mondo di batteri in cui viviamo con un centinaio di bambini all’Università di Bologna il 19 ottobre 2019.
Il titolo della lezione, ” Lo sapete che al 90% siamo fatti di batteri?”, ha attirato più di 100 piccoli studenti curiosi e il gruppo di microbiologia di Bologna ha avuto la possibilità di sensibilizzare gli “scienziati del futuro” sulla controparte microbica che popola il nostro pianeta e permette, di fatto, la sopravvivenza degli esseri umani.
At the end of the lecture a practical activity was organized to allow the kids to literally “shake hands with their own microbes”. Big and colourful microbiological agar plates were prepared and each student was asked to lay his/her hand on the plate for a couple of seconds in order to inoculate the plate with the microbes naturally present on their skin, the skin microbiome. Plates were marked with a color-and-number code to be recognizable by each student. We incubated the plates for a couple for days to allow the bacteria to proliferated and form colonies, and now we are pleased to introduce you to all the microbes that populate the hand of primary school kids… don’t be afraid: they’re just our invisible friends!
Alla fine della lezione è stata organizzata un’attività pratica per consentire ai bambini di fare la conoscenza dei propri batteri, con una, letterale, stretta di mano. Sono state preparate grandi e colorate piastre per microbiologia, contenenti terreno solido per la crescita dei batteri. Ad ogni studente è stato chiesto di posare la mano sulla piastra per un paio di secondi, al fine di inoculare la piastra con i microbi presenti naturalmente sulla loro pelle: il microbioma cutaneo. Le piastre sono state contrassegnate con un codice per essere riconoscibili da ogni studente. Abbiamo incubato le piastre per un paio di giorni per consentire ai batteri di proliferare e formare colonie, e ora siamo lieti di presentarvi tutti i microbi che popolano la mano di bambini tra gli 8 e i 14 anni… non abbiate paura, non sono pericolosi: sono solo i nostri amici invisibili!
Small, round colonies are bacterial colonies, whereas bigger and irregular shapes are the results of fungal proliferation. Again, it is completely normal to have fungi on our hands, they’re not pathogens or parasites, they just use us as a sort of public transport service to be transferred from one place to another.
On some of the plates you will see cracks in the gel surface: well, some of kids had heavy hands, but the bacteria developed all the same.
Le colonie piccole e rotonde sono colonie batteriche, mentre forme più grandi e irregolari sono il risultato della proliferazione fungina. Ancora una volta, è del tutto normale avere funghi nelle nostre mani, non sono agenti patogeni o parassiti, ci usano semplicemente come una sorta di servizio di trasporto pubblico per trasferirsi da un luogo a un altro.
Su alcune piastre si notano delle crepe sulla superficie del terreno solido: beh, alcuni bambini avevano mani pesanti, ma i batteri si sono sviluppati lo stesso.
GROUP B – BLUE/BLU
- B01
- B02
- B03
- B04
- B05
- B06
- B07
- B08
- B09
- B10
- B11
- B12
- B13
- B14
- B15
- B16
- B21
- B22
- B23
- B24
- B25
- B26
- B27
GROUP G – YELLOW/GIALLO
- G01
- G02
- G03
- G04
- G05
- G06
- G07
- G08
- G09
- G10
- G11
- G12
- G21
- G22
- G23
- G24
- G25
- G26
- G27
- G28
- G29
- G30
GROUP R – RED/ROSSO
- R01
- R02
- R03
- R04
- R05
- R06
- R07
- R08
- R09
- R10
- R11
- R12
- R13
- R14
- R15
- R16
- R17
- R18
- R19
- R20
- R21
- R22
- R23
- R24
- R25
- R26
- R27
- R28
- R29
GROUP V – GREEN/VERDE
- V01
- V02
- V03
- V04
- V05
- V06
- V07
- V08
- V09
- V10
- V11
- V12
- V13
- V14
- V15
- V16
- V17
- V18
- V19
- V20
- V21
- V22
- V23
- V24
- V25
- V26
- V27
- V28
- V29
- V30